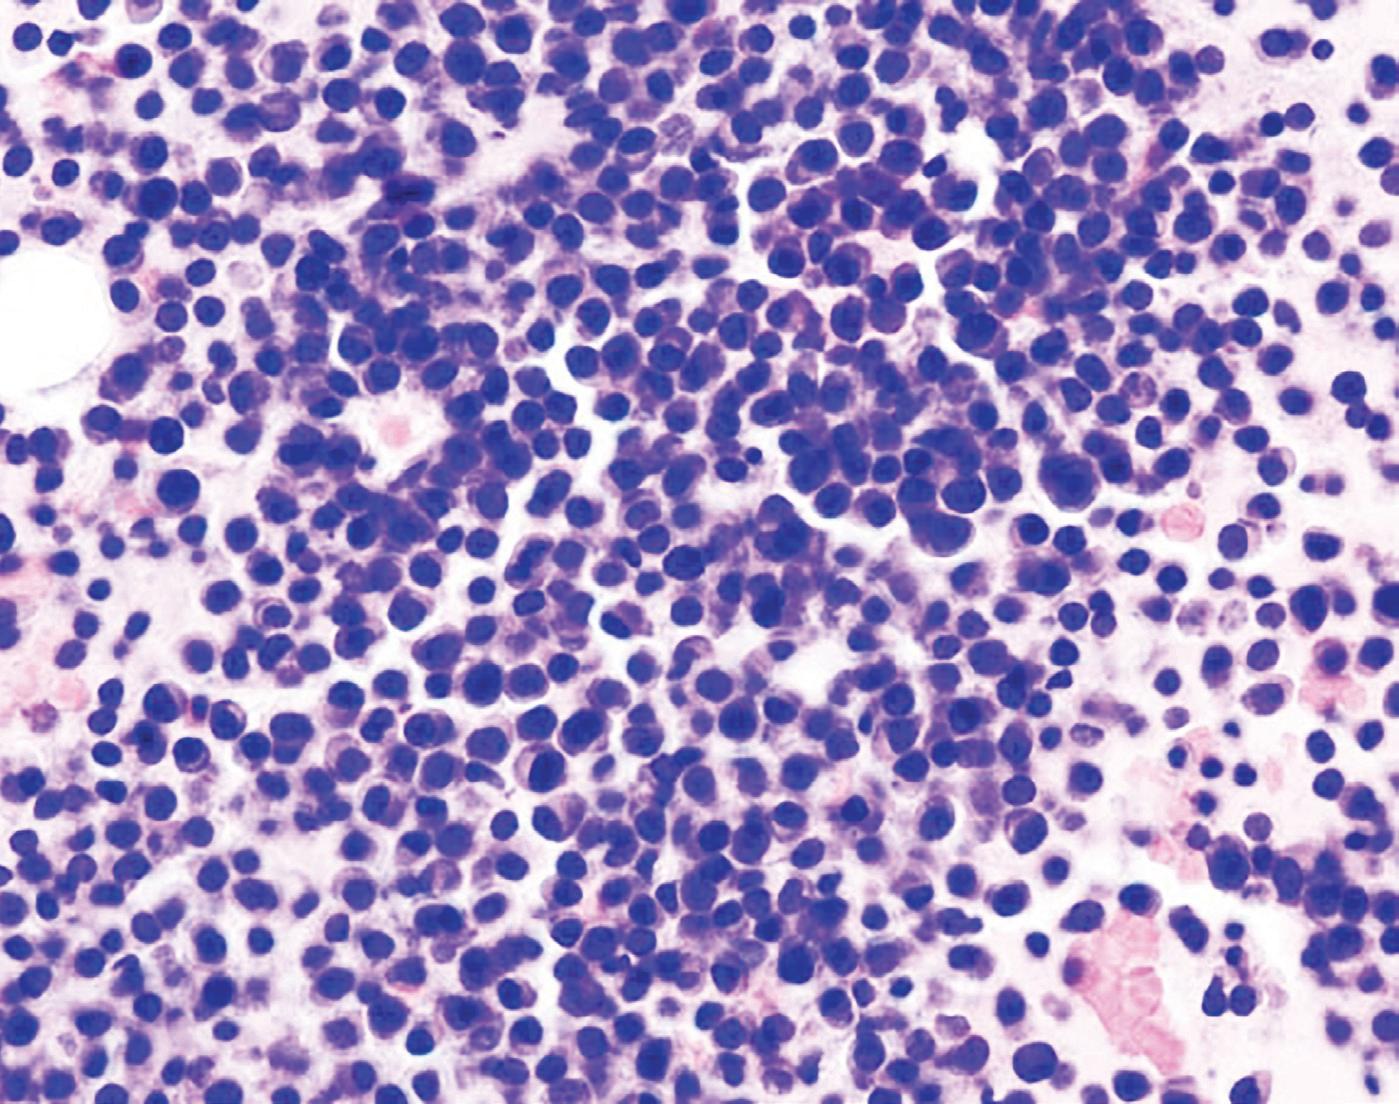

arlementaires de rance
des élus et des acteurs économiques
Recherche et innovation en régions


Sud PACA & Occitanie : deux territoires porteurs d’innovation et de talents


Regional research and innovation
South PACA & Occitania: two territories with a wealth of innovation and talent
MAGAZINE
L’information
MAI / MAY 2023 AVRIL / APRIL 2023
© Pôle SCS © NXP Semiconductors © NXP Semiconductors © Andres Rueda
PIERRE FABRE, 60 ANS À PRENDRE SOIN DE CHACUN

Le 30 mai 1962, Pierre Fabre, jeune pharmacien d’officine, dépose à Castres les statuts de son entreprise, avec pour projet de commercialiser le Cyclo 3, un veinotonique qu’il a mis au point et dont le principe actif provient du petit houx.

Tous les ingrédients qui nous caractérisent 60 ans plus tard sont déjà réunis :


• l’écoute des patients, le jeune pharmacien cherchant à soulager les jambes fatiguées de ses clientes ouvrières des ateliers textiles ;







• l’innovation, tant en médicaments, produits dermo-cosmétiques, qu’en santé familiale ;




• l’ancrage territorial incarné par ce petit houx qui pousse dans les sous-bois du Tarn ;
• le partenariat avec l’officine, le jeune entrepreneur démarchant lui-même ses confrères jusqu’en Alsace ;

• la conviction que, sans respect de la nature, toute création humaine est vaine.
Sans vous, partenaires, consommateurs et patients, la petite entreprise ne serait pas devenue ce qu’elle est aujourd’hui : un Groupe international, engagé en oncologie et dans les soins de la peau, dont le principal actionnaire, la Fondation Pierre Fabre, forme des professionnels de santé et améliore l’accès aux soins dans les pays du Sud, tout en assurant l’indépendance et la stabilité de l’entreprise.


Alors merci, tout simplement.

Rédaction
PUBLICOMM B
Z.A. - route de Châteauroux
F-36320 Villedieu-sur-Indre
Recherche et innovation en régions
Sud PACA & Occitanie : deux territoires porteurs d’innovation et de talents
Regional research and innovation
Coordination éditoriale et journaliste
Carine CHEVAL
South PACA & Occitania: two territories with a wealth of innovation and talent
Soutenir l’innovation et la compétitivité du territoire par la formation et la recherche
Relations institutionnelles Communication
Joëlle ALLALI Publicité Au journal
Un entretien avec M. Georges LEONETTI, Conseiller régional spécial en charge de la santé, de la lutte contre la pandémie, de l’enseignement supérieur et de la recherche 4
Supporting innovation and competitiveness of the territory through training and research
An interview with Mr Georges LEONETTI, Special Regional Councillor in charge of health, the fight against the pandemic, higher education and research 5
Faire de l’Occitanie l’une des premières régions scientifiques et technologiques d’Europe

Un entretien avec Mme Nadia PELLEFIGUE, Vice-Présidente de la Région Occitanie Pyrénées - Méditerranée déléguée à l’Enseignement supérieur, la Recherche, l’Europe et les Relations Internationales 6
Impression
COLOR 36
Z.A., route de Châteauroux
F-36320 Villedieu-sur-Indre
Avril / April 2023
ISSN 1771-0693
Dépôt légal à parution
Making Occitania one of the leading scientific and technological regions in Europe
An interview with Mrs Nadia PELLEFIGUE, Vice-President of the Occitanie Pyrenees-Mediterranean Region in charge of Higher Education, Research, Europe and International Relations 7
Des projets collaboratifs répondant aux défis environnementaux et sociétaux
Un entretien avec M. Xavier LATOUR, Conseiller municipal délégué à l’enseignement supérieur, à la recherche et à la formation continue, Vice-Président de la Métropole Côte d’Azur, Président de l’EPA Nice Ecovallée 8
Collaborative projects addressing environmental and societal challenges
An interview with Mr. Xavier LATOUR, Municipal Councillor in charge of higher education, research and continuing education, Vice-President of the Nice Côte d’Azur Metropolis, President of the Nice Ecovallée EPA 9
Toulouse, un havre de ressourcement technologique pour des secteurs d’excellence
Un entretien avec Mme Agnès PLAGNEUX-BERTRAND, Vice-présidente de Toulouse Métropole chargée de l’industrie et de l’économie productive 10
Toulouse, a haven of technological resources for sectors of excellence
An interview with Mrs Agnès PLAGNEUX-BERTRAND, Vice-president of Toulouse Metropole in charge of industry and the productive economy 11
■ Pierre Fabre
Investir en Occitanie dans les thérapies ciblées contre le cancer
Un entretien avec M. Éric DUCOURNAU, Directeur Général des Laboratoires Pierre Fabre 12
■ Pierre Fabre
Investing in Occitania in targeted cancer therapies
An interview with Mr. Éric DUCOURNAU, CEO of Pierre Fabre Laboratories 13
ANR et Région Sud : une complémentarité de nos modes de soutien à la recherche
Un entretien avec M. Thierry DAMERVAL, Président-directeur général de l’Agence nationale de la recherche (ANR) 14
ANR and the Southern Region: complementarity of our research support methods
An interview with Mr Thierry DAMERVAL, President and CEO of the French National Research Agency (ANR) 15
Retisser le lien entre la recherche universitaire et l’entreprise grâce au doctorat
Un entretien avec M. Hendrik DAVI, Député des Bouches-du-Rhône, Rapporteur de la Mission de suivi de l’évaluation de l’accès à l’enseignement supérieur, Membre de l’OPECST 16
Bridging the gap between university research and business through the PhD
An interview with Mr. Hendrik DAVI, Member of Parliament for Bouches-du-Rhône, Rapporteur of the Follow-up mission on the evaluation of access to higher education, Member of the OPECST 17
1
2023 Toute reproduction, même partielle, des articles publiés dans ce numéro, nécessite explicitement le consentement écrit de l’éditeur. This publication is protected by copyright. Any reproduction, in full or in part, of articles published in this issue requires the explicit written consent of the publisher.
April
- SUMMARY
SOMMAIRE
© Région Sud PACA
Favoriser la culture de l’innovation sous toutes ses formes


Un entretien avec le Pr Éric BERTON, Président d’Aix-Marseille Université 18
Fostering a culture of innovation in all its forms
An interview with Prof. Éric BERTON, President of Aix-Marseille University 19
Faire face ensemble aux grandes transitions liées à l’économie, la réindustrialisation et l’environnement
Un entretien avec le Pr Rostane MEHDI, Président de la Conférence Régionale des Grandes Écoles - PACA, Directeur de Sciences Po Aix 20
Facing together the major transitions linked to the economy, reindustrialisation and the environment
An interview with Prof. MEHDI, President of the Conférence Régionale des Grandes Écoles - PACA, Director of Sciences Po Aix 21
Intelligence artificielle et technologies numériques : les smart techs ont le vent en poupe 22-24

Artificial intelligence and digital technologies: smart techs are on a roll 25-27

L’IA hybride au service de la mobilité et de la robotique
Un entretien avec M. Nicolas VIALLET, Directeur opérationnel du 3IA ANITI Et M. Nicholas ASHER, Directeur scientifique du 3IA ANITI 28
Hybrid AI for mobility and robotics
An interview with Mr. Nicolas VIALLET, Operational Director of 3IA ANITI And Mr. Nicholas ASHER, Scientific Director of 3IA ANITI 29
Pôle Solutions Communicantes Sécurisées
Les technologies numériques au service de la sobriété énergétique
Un entretien avec M. Olivier CHAVRIER, Directeur général du Pôle SCS Solutions Communicantes Sécurisées 32
Secure Communicating Solutions cluster Digital technologies at the service of energy sobriety
An interview with Mr. Olivier CHAVRIER, Managing Director of the SCS Secured Communicating Solutions cluster 33
■ Docaposte
Le référent de la confiance numérique en France
Un entretien avec M. Fabien AILI, Directeur Vérification d’identité, Biométrie & IA à Docaposte, Président du Pôle Solutions Communicantes Sécurisées (SCS), Vice-Président du ClusterIA 34-35
■ Docaposte
The reference for digital trust in France
An interview with Mr. Fabien AILI, Director of Identity Verification, Biometrics & AI at Docaposte, President of the Secured Communicating Solutions (SCS) cluster, Vice President of ClusterIA 36-37
■ Toulouse INP
Les nouveaux partenariats structurants d’un acteur leader des transitions socio-écologiques, environnementales et numériques
■
■ NXP Semiconductors
Des solutions de connectivité sécurisée pour un monde plus intelligent, plus sûr et plus durable 30
■ NXP Semiconductors
Secure connectivity solutions for a smarter, safer and more sustainable world 31
■ Mipih
Des solutions numériques pour un système de santé cohérent, performant et créateur de valeur 38
■ Mipih
Digital solutions for a coherent, efficient and value-creating healthcare system 39
Environnement et développement durable : l’innovation au service des transitions et des besoins de demain 40-42
Environment and sustainable development: innovation to meet the transitions and needs of tomorrow 43-45
Accompagner la transition hydrique des territoires grâce aux solutions innovantes
Un entretien avec M. Sylvain BOUCHER, Président du Pôle Aqua-Valley 46
Supporting the territories Hydric Transition through innovative solutions An interview with Mr. Sylvain BOUCHER, President of the Aqua-Valley Cluster 47
■ Le Pôle Aqua-Valley : un écosystème de spécialité acteur de la transition hydrique des économies et des territoires 48
■ The Aqua-Valley cluster: a specialised ecosystem for the hydric transition of economies and territories 49
2 Avril 2023
50-51
Toulouse
transitions 51-52
École d’Ingénieurs de PURPAN Une recherche appliquée au service de la transition agroécologique 54
PURPAN School of Engineering Applied research for the agro-ecological transition 55 Occitanie : vers une « Région à énergie positive » 56-58 Occitania: towards a “positive energy region” 59-61
École nationale d’ingénieurs de Tarbes - ENIT Une formation pragmatique et une recherche appliquée au service de l’industrie 62 ■ National Engineering School of Tarbes - ENIT Pragmatic training and applied research in the service of industry 63 ■ Institut Carnot Chimie Balard Cirimat 65 ■ Institut Carnot Chimie Balard Cirimat 65 Région Sud PACA : « Gardons une COP d’avance » 66-68 Southern PACA Region: “Let’s keep one COP ahead” 69-71 L’innovation en santé place le patient au cœur des actions Un entretien avec M. Philippe DE MESTER, Directeur général sortant de l’ARS PACA 72 Innovation in health puts the patient at the heart of actions An interview with Mr. Philippe DE MESTER, Outgoing Director General of ARS PACA 73 Santé et biotechs : des thérapies innovantes au service de la médecine de demain 74-76 Health and biotech: innovative therapies for tomorrow’s medicine 77-79 ©
© NXP Semiconductors © Toulouse INP © ENIT
INP The new structuring partnerships of a leading player in socio-ecological, environmental and digital
■
■
■
Aix-Marseille Université
Une recherche translationnelle et pluridisciplinaire au bénéfice des patients
Un entretien avec le Pr Norbert VEY, Professeur d’Hématologie à Aix-Marseille Université, Directeur de la Recherche Clinique de l’Institut Paoli Calmettes (IPC) 80
Translational and multidisciplinary research for the benefit of patients

An interview with Prof. Norbert VEY, Professor of Haematology at Aix-Marseille University, Director of Clinical Research at the Institut Paoli Calmettes 81
■ Centre de Recherche en Cancérologie de Marseille – CRCM
50 ans de recherche pour améliorer le diagnostic et le pronostic des cancers, et leur traitement 82
■ Marseille Cancer Research Centre - CRCM
50 years of research to improve the diagnosis and prognosis of cancers and their treatment 83

■ CHU de Nîmes
Des plateformes dédiées pour répondre aux besoins des chercheurs et des industriels 84-85
■ CHU de Nîmes
Dedicated platforms to meet the needs of researchers and industry 85-86
■ Horus Pharma
Innovation et éthique au service de l’ophtalmologie 87
■ Horus Pharma Innovation and ethics at the service of ophthalmology 87
■ Labex SIGNALIFE
L’excellence niçoise au service de la signalisation cellulaire en sciences du vivant 90
Industrie du futur, villes et mobilités durables : un enjeu de décarbonation et de
Industry of the future, sustainable cities and mobility: a challenge of decarbonization and change of
Valoriser l’attractivité économique d’une région qui fait rêver la terre entière
Un entretien avec M. Bernard KLEYNHOFF, Conseiller régional, Président de la Commission Développement Économique et Digital, Industrie, Export, Attractivité et Cybersécurité de la Région Sud, Président de risingSUD, agence d’attractivité et de développement économique de la région Provence-Alpes-Côte d’Azur 120
Aéronautique et spatial : un vecteur d’excellence industrielle pour l’Occitanie 100-101
Aeronautics and space: a vector of industrial excellence for Occitania 102-103
Occitanie : cap sur l’emploi, la souveraineté et la transformation écologique 104-105
Occitania: focus on employment, sovereignty and ecological transformation 106-107
Innover pour les entreprises
Un entretien avec M. Jean-Denis MULLER, Directeur général de l’AiCarnot 108
Innovating for business
An interview with Mr. Jean-Denis MULLER, Director General of AiCarnot 109
Région Sud PACA : la région industrielle du XXIème siècle 110-113
PACA South Region: the industrial region of the 21st century 114-117
Créer des liens plus forts et durables entre le monde académique et l’industrie
Un entretien avec M. Jean-Luc PARRAIN, Délégué régional académique à la recherche et à l’innovation - région Provence-Alpes-Côte d’Azur, et Mme Fabienne BLAISE, Rectrice déléguée pour l’enseignement supérieur, la recherche et l’innovation de la région académique Provence-Alpes-Côte d’Azur 118
Enhancing the economic attractiveness of a region that is a dream for the whole world
An interview with Mr. Bernard KLEYNHOFF, Regional Councillor, President of the Economic and Digital Development, Industry, Export, Attractiveness and Cybersecurity Commission of the Southern Region, President of risingSUD, the Provence-Alpes-Côte d’Azur region’s attraction and economic development agency 121
■ Institute of Research on Cancer and Aging in Nice - IRCAN
La biologie du vieillissement, un enjeu majeur de santé et d’innovation 88

■ Institute of Research on Cancer and Aging in Nice - IRCAN
The biology of ageing, a major challenge for health and innovation 89

Creating stronger and more sustainable links between the academic world and industry
An interview with Mr. Jean-Luc PARRAIN, Regional Academic Delegate for Research and Innovation - Provence-Alpes-Côte d’Azur region, And Mrs Fabienne BLAISE, Rector Delegate for Higher Education, Research and Innovation of the Provence-Alpes-Côte d’Azur Academic Region 119
Des actions partenariales pour favoriser la détection et l’émulation de projets innovants

Un entretien avec M. Philippe RENAUDI, Président de la CCI Provence-Alpes-Côte d’Azur 122
Partnership actions to encourage the detection and emulation of innovative projects
An interview with Mr. Philippe RENAUDI, President of the Provence-Alpes-Côte d’Azur CCI 123
La société civile, un acteur-clé du territoire
Un entretien avec M. Marc POUZET, Président du CESER Région Sud 124
Civil society, a key player in the territory
An interview with Mr. Marc POUZET, President of CESER Région Sud 125
Index des annonceurs 127-128
Advertisers’ index 127-128
3 April 2023
Therapixel 92
■ Labex SIGNALIFE Excellence in Nice at the service of cell signalling in life sciences 91 ■
■ Therapixel 92
mutation
usages 94-96
des
97-99
use
© IRCAN
© Pegard ISA
© AiCarnot
© CRCM
Soutenir
l’innovation et la compétitivité
du territoire par la formation et la recherche
Un entretien avec M. Georges LEONETTI, Conseiller régional spécial en charge de la santé, de la lutte contre la pandémie, de l’enseignement supérieur et de la recherche
Quels sont les atouts majeurs du paysage régional de l’enseignement supérieur et de la recherche ?
La région Sud occupe le 4ème rang national pour le nombre de chercheurs et les dépenses en R&D et s’appuie sur un réseau très dense composé par les deux universités labellisées IdEx : Aix-Marseille Université, membre du réseau européen Civis, et l’Université de Côte d’Azur, membre du réseau européen Ulysseus, mais aussi les deux universités de proximité de Toulon (avec un axe fort sur la mer) et Avignon (avec une spécialisation sur la culture et les agrosciences), des écoles d’ingénieurs, de sciences politiques, d’art et d’architecture, sans oublier les grands organismes de recherche tels que le CNRS, le CEA, Inria, l’INRAE, l’Inserm, l’Ifremer… Cette densité de maillage explique un taux de réponse très positif aux appels à projets du PIA dans les domaines de la santé, de l’économie, de l’énergie et du numérique. De plus, la Région valorise la recherche en lien avec les filières régionales d’excellence via la SATT Sud-Est, sans oublier les instituts Carnot, InriaTech Sud-Est et CEA Tech, les 8 pôles de compétitivité, plusieurs clusters, 4 Centres Européens d’Entreprises et d’Innovation (CEEI), 3 incubateurs et un réseau de 2 400 start-ups réparties au sein de 4 pôles métropolitains labellisés French Tech.
En quoi la région Sud - PACA se distinguet-elle dans le domaine de la recherche en santé ?
La recherche médicale occupe une place de premier plan avec plus de 3 000 chercheurs en immunologie, oncologie, infectiologie et neurologie. Elle rassemble 170 laboratoires qui représentent près de 8 % de la production scientifique nationale. Elle est dynamisée par les deux CHU de Marseille et Nice, l’IHU Méditerranée Infection, des infrastructures de recherche intégrées dans France-BioImaging, France Génomique et France Life Imaging… Par ailleurs, Marseille constitue la 2ème communauté française en neurosciences et la région bénéficie de 4 projets de recherche hospitalo-universitaire en santé (RHU)
en neurosciences, néphrologie, infectiologie et cancérologie - des projets labellisés dans le cadre du PIA. Autre domaine d’excellence porté par Marseille Immunopôle, l’immunologie s’appuie sur le démonstrateur pré-industriel Mimabs pour optimiser la mise au point de nouveaux médicaments contre le cancer et les maladies infectieuses. Sur le front de l’oncologie, citons les deux centres de lutte contre le cancer de Marseille et Nice ainsi que le Cancéropôle PACA soutenu par l’INCA : ses plus de 650 scientifiques couvrent l’ensemble de la chaîne, depuis la recherche fondamentale jusqu’à la prise en charge thérapeutique ; à ce titre, ils constituent l’un des piliers du Plan Cancer régional labellisé par l’INCA. Enfin, la région Sud a développé un axe d’excellence sur l’IA et la santé avec le 3IA Côte d’Azur, axé sur la santé et les territoires intelligents.

Comment le Conseil régional accompagne-t-il les acteurs de la recherche en santé ?
Ce soutien s’inscrit dans le Schéma régional sur l’enseignement supérieur, la recherche et l’innovation dont la nouvelle mouture 2023-2028 sera adoptée avant la fin 2022. Son objectif est de soutenir l’innovation et la compétitivité du territoire par la formation et la recherche, mais aussi développer l’excellence et le rayonnement des laboratoires avec le soutien des acteurs de la recherche et en phase avec le Plan Climat, le Plan Santé et Environnement, le Plan Cancer et les opérations d’intérêt régional (OIR), dont celle axée sur les thérapies innovantes. De plus, la Région a déterminé des investissements dédiés dans le cadre du CPER (volet recherche), du Plan Cancer (via le Cancéropôle régional), de contrats doctoraux (avec une enveloppe annuelle de 4 M€) et d’appels à projets de recherche annuels sur nos axes privilégiés : les problématiques environnementales et la lutte contre le cancer.
Quels sont selon vous les principaux défis pour l’enseignement supérieur et la recherche en région Sud ?
Le principal défi est sans nul doute de mobiliser encore plus les fonds européens du Feder et d’Horizon Europe afin de démultiplier les financements publics, d’accompagner le développement de la recherche et d’attirer les talents : le co-financement de chaires internationales senior ou junior est justement prévu dans le cadre du Plan Cancer régional en vue de générer un effet de levier dans la recherche sur nos axes stratégiques. Accroître les fonds européens implique de mobiliser les acteurs académiques et de les accompagner dans l’élaboration des réponses aux appels à projets européens pour augmenter leur taux de succès et relever les défis inhérents au développement de l’enseignement supérieur et de la recherche en région. La Région est déjà à pied d’œuvre dans ce domaine : avec une cellule Europe et une représentation à Bruxelles, elle a déjà accru de manière significative la part des crédits européens pour les projets régionaux à la fin de la dernière mandature. Gageons que nous ferons encore mieux ces cinq prochaines années !

4 Avril 2023
© Région Sud PACA © Région Sud PACA
Bâtiment Fight Cancer de l’Inserm / Inserm Fight Cancer Building
Supporting innovation and competitiveness of the territory through training and research
What are the major assets of the regional higher education and research landscape?
The South region ranks 4th in France for the number of researchers and R&D expenditure and relies on a very dense network made up of the two IdEx-labelled universities: Aix-Marseille University, a member of the European Civis network, and the University of Côte d’Azur, a member of the European Ulysseus network, but also the two local universities of Toulon (with a strong focus on the sea) and Avignon (with a specialisation in culture and agrosciences), schools of engineering, political science, art and architecture, not to mention the major research organisations such as the CNRS, CEA, Inria, INRAE, Inserm, Ifremer... This dense network explains the very positive response rate to the PIA calls for projects in the fields of health, the economy, energy and digital technology. In addition, the Region promotes research in connection with the regional sectors of excellence via the SATT Sud-Est, not to mention the Carnot, InriaTech Sud-Est and CEA Tech institutes, the 8 competitiveness clusters, several clusters, 4 European Business and Innovation Centres (CEEI), 3 incubators and a network of 2,400 start-ups spread across 4 metropolitan clusters with the French Tech label.
How does the South PACA region stand out in the field of health research?
Medical research is at the forefront with more than 3,000 researchers in immunology, oncology, infectiology and neurology. It brings together 170 laboratories that represent nearly 8% of national scientific production. It is boosted by the two university hospitals of Marseille and Nice, the IHUMéditerranée Infection, research infrastructures integrated into France-BioImaging, France Genomics and France Life Imaging... Furthermore, Marseille is the 2nd largest French community in neurosciences and the region benefits from 4 university hospital research projects in neurosciences, nephrology, infectiology and cancer - projects labelled within the framework of the PIA. Another field of excellence supported by Marseille Immunopôle, immunology, relies on the Mimabs pre-industrial demonstrator to optimise the development of new drugs against cancer and infectious diseases. On the oncology front, let’s mention the two
cancer centres in Marseille and Nice as well as the PACA Cancéropôle supported by the INCA: its more than 650 scientists cover the entire chain, from fundamental research to therapeutic management; as such, they constitute one of the pillars of the regional Cancer Plan approved by the INCA. Finally, the Southern Region has developed a focus of excellence on AI and health with the 3IA Côte d’Azur, which focuses on health and intelligent territories.
How does the Regional Council support health research players?
This support is part of the regional plan for higher education, research and innovation, the new version of which will be adopted before the end of 2022. Its objective is to support innovation and competitiveness in the region through training and research, but also to develop the excellence and influence of laboratories with the support of research players and in line with the Climate Plan, the Health and Environment Plan, the Cancer Plan and the operations of regional interest (OIR), including the one focused on innovative therapies. In addition, the Region has determined dedicated investments within the framework of the CPER (research section), the Cancer Plan (via the regional Cancéropôle), doctoral
contracts (with an annual envelope of €4M) and annual calls for research projects on our preferred areas: environmental issues and the fight against cancer.

In your opinion, what are the main challenges for higher education and research in the southern region?
The main challenge is undoubtedly to mobilise even more European funds from the ERDF and Horizon Europe in order to increase public funding, to support the development of research and to attract talent: the co-financing of senior or junior international chairs is precisely planned within the framework of the regional Cancer Plan in order to generate a leverage effect in research on our strategic axes. Increasing European funds means mobilising academic players and supporting them in drawing up responses to European calls for projects in order to increase their success rate and meet the challenges inherent in the development of higher education and research in the region. The Region is already hard at work in this field: with a Europe unit and a representation in Brussels, it has already significantly increased the share of European credits for regional projects at the end of the last mandate. Let’s bet that we will do even better in the next five years!
5 April 2023
An interview with Mr Georges LEONETTI, Special Regional Councillor in charge of health, the fight against the pandemic, higher education and research
©
The IHU - Méditerranée Infection in Marseille / Méditerranée Infection à Marseille
Région Sud PACA
Faire de l’Occitanie l’une des premières régions
scientifiques et technologiques d’Europe
Un entretien avec Mme Nadia PELLEFIGUE, Vice-Présidente de la Région Occitanie Pyrénées - Méditerranée déléguée à l’Enseignement supérieur, la Recherche, l’Europe et les Relations Internationales


Quels sont les points forts de l’écosystème régional en matière de recherche et d’innovation ?
Notre premier point fort est celui des effectifs élevés d’étudiants (270 000), de chercheurs et d’établissements d’enseignement supérieur (39). La recherche publique et privée représente 3,5 % du PIB régional, ce qui fait de l’Occitanie la première région française en termes d’intensité de recherche et constitue un levier essentiel pour l’innovation. Par ailleurs, la Région tient à renforcer le maillage de l’enseignement supérieur et de la recherche au-delà des deux métropoles, grâce à 18 villes universitaires d’équilibre (Perpignan, Nîmes, Albi…) qui sont plus accueillantes pour les étudiants d’origine rurale.
Pourriez-vous nous présenter les grands axes de la stratégie régionale de soutien aux acteurs de la recherche et de l’innovation ?
Comme vous le savez, la SRESRI a fait l’objet d’une concertation de grande échelle et défini trois grands défis. Le premier vise à préparer les compétences de demain dans une société en pleine transition – des compétences indispensables pour réduire nos consommations énergétiques et produire de nouvelles énergies telles que l’hydrogène vert. Notre deuxième défi est de faire de l’Occitanie l’une des premières régions scientifiques et technologiques d’Europe. Cela passe notamment par la participation à des projets européens, les collaborations entre laboratoires et entreprises, l’attraction de talents internationaux ou encore l’accroissement de la mobilité des chercheurs et des étudiants. Enfin, le troisième défi concerne la réussite étudiante avec un accompagnement prononcé de la vie étudiante (alimentation, santé, logement) et la création d’un groupe de travail dédié pour faire des étudiants les acteurs des politiques publiques les concernant.
De quels dispositifs disposez-vous pour accompagner les entreprises innovantes ?
La Région propose des outils d’accompagnement au développement et des aides financières. L’agence régionale de développement, AD’OCC, accompagne les TPE et PME qui représentent 93 % des entreprises
du territoire : recherche des bons laboratoires pour développer leurs produits ou leurs solutions, sensibilisation à l’écosystème et à la culture de l’innovation… Toutes les entreprises sont capables d’innover. À titre d’exemple, la maison Pillon a collaboré avec le Cnes pour concocter une mousse comestible à base de pain de Gênes afin d’emballer les instruments servant aux expériences sur l’ISS : une manière gourmande de gagner de la place dans un espace exigu ! De plus, la Région dispose d’I-Démo, un financement de recherche pluriannuelle (jusqu’à 3 ans) qui couvre 50 % du budget total. L’un des projets accompagnés portait sur le remplacement de l’huile de palme dans certains produits alimentaires. La Région soutient aussi les 9 pôles de compétitivité
du territoire, participe au capital des deux SATT (AxLR, Toulouse Tech Transfer) et a entièrement financé le bâtiment du CEA Tech à Toulouse. N’oublions pas, pour finir, l’accompagnement des contrats de recherche des grands organismes qui disposent d’implantations régionales.
Comment les chercheurs et les industriels sont-ils mis à contribution pour mettre en œuvre le Pacte Vert pour l’Occitanie et le « Plan pour le pouvoir de vivre et la souveraineté énergétique » dans le cadre de la stratégie à Énergie positive RéPOS ? Nous avons fixé deux objectifs très ambitieux pour devenir la première région RéPOS de France : réduire de 40 % notre consommation d’énergie et tripler notre production d’énergie renouvelable d’ici 2050. Pour ce faire, nous pouvons compter sur notre excellent positionnement en termes de photovoltaïque, d’hydroélectricité et d’éolien offshore avec les futures fermes commerciales de Qair Group. Nous travaillons aussi avec Schlumberger, basée à Béziers, pour développer des solutions de production d’hydrogène vert. Plus largement, la Région accompagne les filières les plus consommatrices d’énergie telles que l’aviation avec un Plan pour l’aviation durable. Elle finance aussi 30 des 35 M€ nécessaires pour l’ouverture, en 2025, du technocampus dédié à l’hydrogène vert sur le site de Francazal : 50 % de la superficie seront destinés à l’accueil de 120 chercheurs tandis que les 50 % restants permettront aux industriels de tester les applications de l’hydrogène vert pour la mobilité (train, avion et vélo). De même, la Région soutient les initiatives dans le secteur de la construction qui représente 25 % des émissions de CO2 : les matériaux, le bois-énergie, les réseaux de chaleur ou encore le béton inerte font l’objet de toute notre attention. Nous avons même organisé un concours afin de stimuler la recherche sur les immeubles en bois de grande hauteur. Nous accordons aussi des aides aux entreprises pour réduire leur consommation énergétique, implanter des mégafactories ou des champs photovoltaïques avec le concours de l’AREC, l’Agence régionale Énergie Climat. Les chantiers ne manquent pas !
6 Avril 2023
© Nuuk Photographie Adélaïde Maisonlabe
© Marion Herail Région Occitanie
Making Occitania one of the leading scientific and technological regions in Europe
What are the strong points of the regional ecosystem in terms of research and innovation?
Our first strength is the high number of students (270,000), researchers and higher education institutions (39). Public and private research represents 3.5% of the regional GDP, which makes Occitania the leading French region in terms of research intensity and constitutes an essential lever for innovation. Moreover, the Region is keen to strengthen the higher education and research network beyond the two metropolises, thanks to 18 balanced university towns (Perpignan, Nîmes, Albi, etc.) which are more welcoming to students from rural areas.
Could you present to us the main lines of the regional strategy for supporting research and innovation players?

As you know, the SRESRI (Regional plan for higher education, research and innovation) was the subject of a large-scale consultation and defined three major challenges. The first is to prepare the skills of tomorrow in a society in transition - skills that are essential for reducing our energy consumption and producing new energies such as green hydrogen. Our second challenge is to make Occitania one of the leading scientific and technological regions in Europe. This will be achieved through participation in European projects, collaboration between laboratories and companies, attracting international talent and increasing the mobility of researchers and students. Finally, the third challenge concerns student success with a pronounced support for student life (food, health, housing) and the creation of a dedicated working group to make students the actors of public policies concerning them.
What tools do you have to support innovative companies?
The Region offers development support tools and financial aid. The regional development agency, AD’OCC, supports
VSEs and SMEs, which account for 93% of the region’s companies: finding the right laboratories to develop their products or solutions, raising awareness of the ecosystem and the culture of innovation, etc. All companies are capable of innovation. For example, Pillon, the famous Toulouse pastry shop, worked with Cnes to create an edible foam made from Genoa bread to wrap the instruments used for experiments on the ISS: a delicious way to save space in a cramped environment! In addition, the Region has I-Demo, a multi-annual (up to 3 years) research funding that covers 50% of the total budget. One of the projects supported concerned the replacement of palm oil in certain food products. The Region also supports the 9 competitiveness clusters on its territory, participates in the capital of the two SATTs, i.e. Technology Transfer Acceleration Companies (AxLR, Toulouse
Tech Transfer) and has fully financed the CEA Tech building in Toulouse. Finally, let’s not forget the support for research contracts of the major organisations that have regional offices.
How are researchers and industrialists involved in implementing the Green Pact for Occitania and the «Plan for the power of living and energy sovereignty» as part of the RéPOS Positive Energy Strategy?
We have set two very ambitious targets to become France’s leading RéPOS region: to reduce our energy consumption by 40% and to triple our renewable energy production by 2050. To achieve this, we can count on our excellent positioning in terms of photovoltaic, hydroelectricity and offshore wind with the future commercial farms of Qair Group. We are also working with Schlumberger, based in Béziers, to develop green hydrogen production solutions. More broadly, the Region is supporting the most energy-intensive sectors, such as aviation, with a Plan for Sustainable Aviation. It is also financing €30 million of the €35 million needed to open a technocampus dedicated to green hydrogen on the Francazal site in 2025: 50% of the surface area will be used to accommodate 120 researchers, while the remaining 50% will enable manufacturers to test green hydrogen applications for mobility (train, plane and bicycle). Similarly, the Region supports initiatives in the construction sector, which accounts for 25% of CO2 emissions: materials, wood-energy, heating networks and inert concrete are all the focus of our attention. We have even organised a competition to stimulate research into high-rise wooden buildings. We also grant aid to companies to reduce their energy consumption, set up mega-factories or photovoltaic fields with the help of the AREC, the Regional Energy and Climate Agency. There is no shortage of projects!
7 April 2023
An interview with Mrs Nadia PELLEFIGUE, Vice-President of the Occitanie Pyrenees-Mediterranean Region in charge of Higher Education, Research, Europe and International Relations
© Marion Herail Région Occitanie
Des projets collaboratifs répondant aux défis environnementaux et sociétaux
Un entretien avec M. Xavier LATOUR, Conseiller municipal délégué à l’enseignement supérieur, à la recherche et à la formation continue, Vice-Président de la Métropole Nice Côte d’Azur, Président de l’EPA Nice Ecovallée

Côte d’Azur en ont fait leur sujet de recherche comme Université Côte d’Azur et Sorbonne Université soutenues par la Métropole qui collaborent actuellement sur un projet de valorisation des ressources marines et des écosystèmes marins côtiers. Nous décernerons cette année 1 Prix « Entreprise innovante » (dotation de 4 000 euros) récompensant une entreprise modèle sur le territoire métropolitain et 3 Prix « Mon projet entrepreneurial » (dotation de 2 000 euros chacun) au bénéfice de doctorants ou post-doctorants impliqués dans des projets entrepreneuriaux.
Comment la Métropole accompagne-t-elle les entreprises innovantes ?
Quels sont les enjeux économiques du projet d’Eco-Vallée ?
Quels sont les domaines d’excellence de la R&D sur le territoire de Nice Côte d’Azur et comment soutenez-vous les acteurs de la recherche ?
Sur le territoire de la Métropole Nice Côte d’Azur, notamment sur le périmètre de l’Opération d’Intérêt National Nice Ecovallée, Christian Estrosi, Maire de Nice, Président de la Métropole Nice Côte d’Azur, a fixé les thématiques prioritaires d’innovation : le développement durable et la préservation de la biodiversité, la santé, le bien-être et le vieillissement, la mobilité, la gestion des risques, la sécurité et la résilience territoriale. Véritable « Living Lab » de l’innovation, la Métropole définit et met en œuvre des programmes et projets collaboratifs répondant aux défis environnementaux et sociétaux actuels et participe au développement de domaines d’excellence à fort potentiel de création d’emplois. Elle compte aujourd’hui sur son territoire 48 000 étudiants, 130 laboratoires accueillant plus de 2 800 chercheurs, 20 écoles internationales, un campus universitaire « Université Côte d’Azur » réputé et des pôles de compétitivité scientifiques dans des secteurs de pointe. La Métropole soutient et valorise également la recherche par le biais de l’attribution de prix et bourses, accompagne les doctorants vers l’emploi et anime un réseau local d’acteurs investis dans des projets structurants.
En quoi consiste le Prix entrepreneuriat dans la recherche ?
Avec ce Prix, la Métropole souhaite mettre en valeur l’excellence de la recherche azuréenne. Cette année nous avons choisi comme thème les biotechnologies et la préservation des ressources marines, un enjeu majeur de notre territoire. De nombreux laboratoires d’Université
Labellisée « Capitale French Tech », Nice Côte d’Azur est très fière de travailler avec un écosystème de start-ups et d’acteurs de l’innovation qui se renforce quotidiennement. Plusieurs start-ups de cet écosystème ont récemment réalisé d’importantes levées de fonds. Notre pépinière d’entreprises – le Centre Européen d’Entreprises et d’Innovation ou CEEI – implanté au cœur de la technopole urbaine Nice Méridia soutient la croissance de nos jeunes entreprises et futures pépites. 180 start-ups ont été accompagnées par notre incubateur depuis sa création. Nous avons également initié plusieurs programmes d’accélération avec des partenaires et entrepris depuis deux ans le lancement de plusieurs appels à projets innovants dans des filières stratégiques du territoire. Nous poursuivons cette dynamique avec trois nouveaux appels à projets en 2022 dans les domaines des industries culturelles et créatives, de la naturalité et des éco-industries.
Nice Écovallée est l’un des projets moteurs du changement de la métropole Nice Côte d’Azur. Initié il y a plus de 10 ans, il prend vie aujourd’hui dans les écoquartiers du Grand Arénas et de Nice Méridia, un écosystème favorable au développement économique, à la formation et à l’insertion professionnelle où les grands groupes côtoient les start-ups et centres de recherche. À Nice Méridia, start-up et laboratoires R&D proposent des emplois qualifiés et collaborent avec les écoles supérieures et l’Université. Le Grand Arénas, quartier d’affaires et de vie à l’entrée de Nice, bénéficie de la proximité du pôle d’échanges multimodal et du futur parc des congrès et des expositions. Ces quartiers profitent d’une grande accessibilité et accueillent une offre de logements diversifiée favorisant le parcours résidentiel et la mixité sociale, atout important pour les entreprises en quête d’une implantation. Les investissements publics initiés sur notre territoire ont un effet levier significatif : 90 M€ d’argent public vont générer 3,5 milliards d’investissements privés à terme. Nice Écovallée doit accueillir plus de 30 000 emplois et 12 000 logements. La haute qualité environnementale est au cœur de nos opérations et nous avons entrepris un processus de maîtrise de l’urbanisation et de renaturation à grande échelle permettant de mieux prévenir les risques naturels et climatiques. À terme, seuls 2 % du périmètre de Nice Écovallée seront aménagés. En termes d’imperméabilisation, le bilan sera neutre voire positif.

8 Avril 2023
© Ville de Nice
Le bâtiment IMREDD est un Institut Méditerranéen du Développement Durable au cœur de Nice Ecovallée à Méridia. / The IMREDD building is a Mediterranean Institute for Sustainable Development in the heart of Nice Ecovallée in Méridia.
© Antoine Duhamel
Collaborative projects addressing environmental and societal challenges
What are the areas of excellence in R&D in the Nice Côte d’Azur region and how do you support research players?
In the Nice Côte d’Azur metropolitan area, particularly within the perimeter of the Nice Ecovallée National Interest Operation, Christian Estrosi, Mayor of Nice and President of the Nice Côte d’Azur Metropolitan Area, has set the following priority innovation themes: sustainable development and the preservation of biodiversity, health, well-being and ageing, mobility, risk management, security and territorial resilience. As a true «Living Lab» for innovation, the Metropolis defines and implements collaborative programmes and projects that respond to current environmental and societal challenges and participates in the development of areas of excellence with high job creation potential. It currently has 48,000 students, 130 laboratories hosting more than 2,800 researchers, 20 international schools, a renowned «Université Côte d’Azur» university campus and scientific competitiveness clusters in cutting-edge sectors. The Metropolis also supports and promotes research through the awarding of prizes and scholarships, helps doctoral students find employment and leads a local network of players involved in structuring projects.
What is the Entrepreneurship in Research Award?
With this award, the Metropolis wants to highlight the excellence of Côte d’Azur research. This year we have chosen biotechnology and the preservation of marine re-


sources as the theme, as this is a major issue for our region. Many Université Côte d’Azur laboratories have made this their research topic, such as Université Côte d’Azur and Sorbonne University, which are supported by the Metropolis and are currently collaborating on a project to develop marine resources and coastal marine ecosystems. This year, we will be awarding 1 «Innovative Company» prize (4,000 euros) to a model company in the metropolitan area and 3 «My Entrepreneurial Project» prizes (2,000 euros each) to doctoral or post-doctoral students involved in entrepreneurial projects.
How does the Metropolis support innovative companies?
Nice Côte d’Azur has been awarded the «French Tech Capital» label and is very proud to work with an ecosystem of startups and innovation players that is growing stronger every day. Several start-ups in this ecosystem have recently raised significant amounts of money. Our business incubator - the Centre Européen d’Entreprises et d’Innovation or CEEI - located in the heart of the Nice Méridia urban technology park supports the growth of our young companies and future nuggets. 180 start-ups have been supported by our incubator since its creation. We have also initiated several acceleration programmes with partners and, over the past two years, have launched several calls for innovative projects in strategic sectors of the region. We are continuing this dynamic with three new calls for projects in 2022 in the fields of cultural and creative industries, naturalness and eco-industries.
What are the economic challenges of the Eco-Valley project?
Nice Eco-Valley is one of the driving projects for change in the Nice Côte d’Azur metropolis. Initiated more than 10 years ago, it is now coming to life in the Grand Arénas and Nice Méridia eco-neighbourhoods, an ecosystem favourable to economic development, training and professional integration where large groups rub shoulders with startups and research centres. In Nice Méridia, start-up and R&D laboratories offer qualified jobs and collaborate with colleges and universities. The Grand Arénas, a business and lifestyle district at the entrance to Nice, benefits from the proximity of the multimodal exchange hub and the future convention and exhibition centre. These districts benefit from great accessibility and offer a diversified range of housing that favours the residential and social mix, an important asset for companies looking to set up in the area. The public investments initiated in our territory have a significant leverage effect: €90 million of public money will eventually generate €3.5 billion of private investment. Nice Ecovallée is to accommodate more than 30,000 jobs and 12,000 homes. High environmental quality is at the heart of our operations and we have undertaken a large-scale urbanisation and renaturation process to better prevent natural and climatic risks. Eventually, only 2% of the Nice Ecovallée perimeter will be developed. In terms of waterproofing, the balance will be neutral or even positive.
9 April 2023
An interview with Mr. Xavier LATOUR, Municipal Councillor in charge of higher education, research and continuing education, Vice-President of the Nice Côte d’Azur Metropolis, President of the Nice Ecovallée EPA
© Ville de Nice
Xavier Latour at the «Comité Doyen Lépine» and «Victoires de la Recherche» awards in Nice / Xavier Latour lors de la remise des prix à Nice « Comité Doyen Lépine » et « Victoires de la Recherche »
© Ville de Nice
Toulouse, un havre de ressourcement technologique pour des secteurs d’excellence
Quels sont les principaux atouts du tissu économique métropolitain ?
La métropole est reconnue mondialement pour ses secteurs d’excellence que sont l’aéronautique (avec le siège d’Airbus et de nombreux sous-traitants), le spatial (avec plus de 12 000 emplois) et la santé (avec plusieurs centres de recherche de pointe sur le cancer notamment). Moins connu, le secteur du numérique est également très actif grâce à plusieurs acteurs de l’intelligence artificielle et du big data comme tous les acteurs du spatial qui collectent les données provenant des satellites dont fait partie Mercator Océan, un organisme intergouvernemental délégataire du traitement des données de Copernicus, Airbus, qui assure le suivi des données de tous les avions Airbus dans le monde, le siège de Météo-France, en partenariat avec le CNES mais aussi l’entreprise Continental qui a créé un centre de recherche sur les véhicules connectés et autonomes.
Comment Toulouse Métropole accompagne-t-elle les entreprises innovantes sur son territoire ?

Comme vous le savez, sur le volet économique, la loi NOTRe a attribué la compétence d’aménagement aux métropoles. Mais nous allons plus loin en cofinançant des centres de recherche via le CPER et des pépinières pour accueillir les entreprises en phase de création. De plus, nous co-finançons un incubateur régional avec la Région. N’oublions pas que la recherche toulousaine est de très haut niveau dans de nombreux domaines (j’en veux pour preuve le Prix Nobel d’économie attribué à Jean Tirole en 2014) et qu’elle entretient historiquement de bonnes relations avec l’industrie : en témoigne l’IRT Saint Exupéry piloté par des industriels de l’aérospatial qui entendent élargir leur activité aux applications de l’IA pour la santé. Par ailleurs, la métropole a défini une feuille de route dans laquelle figurent ses priorités pour accompagner ses secteurs d’excellence : la décarbonation de l’aéronautique, le spatial pour le climat, la défense (avec l’accueil du commandement de l’espace et d’un organisme de l’OTAN), l’exploration planétaire (avec l’IRAP qui a contribué à la
réalisation du robot Persévérance chargé de prélever les échantillons de sol martien) et la fabrication de satellites (des nanosatellites aux mégaconstellations), mais aussi la santé et plus spécifiquement le cancer, l’IA pour la santé, la bioproduction de molécules et le vieillissement.
Comment les politiques d’aménagement contribuent-elles à cette action d’accompagnement ?
Plusieurs secteurs de la métropole offrent un lieu dédié aux développements de ses secteurs d’excellence : l’Oncopôle, Toulouse Aerospace et le site de l’ancien aérodrome de Francazal dont les 37 ha abriteront des activités de R&D autour de la décarbonation des transports, de l’hydrogène et de la pile à combustible. En parallèle, la métropole a lancé la refonte complète du quartier de la gare de Matabiau avec

l’arrivée attendue de la LGV en provenance de Paris via Bordeaux. Dans le cadre de la refonte importante de ce quartier il est prévu de le dédier aux activités numériques. Sa situation géographique et sa bonne desserte en transports seront des arguments de poids pour attirer les jeunes salariés des entreprises high-tech.
Comment Toulouse Métropole soutient-elle la souveraineté industrielle de son territoire ?
L’aéronautique et le spatial sont porteurs d’enjeux élevés d’autonomie technologique et donc de souveraineté nationale. Reste à maintenir la capacité de vol des avions dans le contexte climatique actuel. Ce défi me tient particulièrement à cœur puisque j’ai été responsable du programme « Avion électrique » d’Airbus. Dans cette optique, nous préparons un MoU avec les industriels afin d’identifier leurs priorités pour mettre en œuvre la décarbonation de l’aéronautique. Cela nous permettra de soutenir financièrement les axes de recherche correspondant à ces enjeux : l’hydrogène et la pile à combustible, l’allègement des matériaux, les SAF (biocarburant, e-carburant), l’électronique de puissance mais aussi les bancs d’essai pour tester des systèmes de motorisation hybride ou électrique à destination des petits avions. Comme vous le voyez, nous sommes bien décidés à donner aux industriels les moyens dont ils ont besoin !
10 Avril 2023
Un entretien avec Mme Agnès PLAGNEUX-BERTRAND, Vice-présidente de Toulouse Métropole chargée de l’industrie et de l’économie productive
B612, le centre d’innovation de Toulouse Aerospace / B612, the Toulouse Aerospace innovation centre
© Ville de Toulouse
© Ville de Toulouse
Toulouse, a haven of technological resources for sectors of excellence
What are the main assets of the metropolitan economic fabric?
The metropolis is recognised worldwide for its sectors of excellence, which are aeronautics (with the headquarters of Airbus and numerous subcontractors), space (with more than 12,000 jobs) and health (with several cutting-edge research centres, particularly on cancer). Less well known, the digital sector is also very active thanks to several players in artificial intelligence and big data, such as all the space players who collect data from satellites, including Mercator Ocean, an intergovernmental organisation that delegates the processing of Copernicus data, Airbus, which monitors the data from all the Airbus planes in the world, the headquarters of Météo-France, in partnership with the CNES, and also the company Continental, which has created a research centre on connected and autonomous vehicles.
How does Toulouse Metropole support innovative companies on its territory?

As you know, on the economic side, the NOTRe law has attributed the competence of development to the metropolises. But we go further by co-financing research centres via the CPER and incubators to welcome companies in the creation phase. In addition, we co-finance a regional incubator with the Regional Council. Let’s not forget that Toulouse’s research is of a very high level in many fields (as proof, the Nobel Prize in Economics awarded to Jean Tirole in 2014) and that it has historically maintained good relations with industry: witness the IRT
Saint Exupéry, piloted by aerospace industrialists who intend to expand their activity to AI applications for health. In addition, the metropolis has defined a roadmap with its priorities to support its sectors of excellence: decarbonisation of aeronautics, space for climate, defence (with the hosting of the space command and a NATO body), planetary exploration (with IRAP, which contributed to the creation of the Perseverance robot in charge of taking Martian soil samples) and satellite manufacturing (from nanosatellites to megaconstellations), but also health and more specifically cancer, AI for health, bioproduction of molecules and ageing.
How do planning policies contribute to this accompanying action?
Several sectors of the metropolis offer a place dedicated to the development of its sectors
of excellence: the Oncopôle, Toulouse Aerospace and the site of the former Francazal airfield, whose 37 hectares will house R&D activities around the decarbonisation of transport, hydrogen and the fuel cell. At the same time, the metropolis has launched a complete overhaul of the Matabiau station area with the expected arrival of the highspeed train from Paris via Bordeaux. As part of the major overhaul of this district, it is planned to dedicate it to digital activities. Its geographical location and good transport links will be strong arguments for attracting young employees of high-tech companies.

How does Toulouse Metropole support the industrial sovereignty of its territory?
The aeronautics and space industries are a major source of technological autonomy and therefore of national sovereignty. The challenge is to maintain the flight capacity of aircraft in the context of climate change. This challenge is particularly close to my heart as I was responsible for the Airbus «Electric Aircraft» programme. With this in mind, we are preparing an MoU with manufacturers to identify their priorities for implementing decarbonisation in aeronautics. This will allow us to financially support the research areas corresponding to these challenges: hydrogen and fuel cells, lightening of materials, jet fuel (biofuel, e-fuel), power electronics, but also test benches to test hybrid or electric motorisation systems for small aircraft. As you can see, we are determined to give manufacturers the resources they need!
11 April 2023
An interview with Mrs Agnès PLAGNEUX-BERTRAND, Vice-president of Toulouse Metropole in charge of industry and the productive economy
Invest in Toulouse supports companies wishing to set up in Toulouse / InvestinToulouse accompagne les entreprises désireuses de s’implanter à Toulouse.
The site of the former Francazal airfield will soon house R&D activities on the decarbonisation of transport, hydrogen and fuel cells. / Le site de l’ancien aérodrome de Francazal abritera bientôt des activités de R&D autour de la décarbonation des transports, de l’hydrogène et de la pile à combustible.
© Ville de Toulouse
© Ville de Toulouse
Pierre Fabre Investir en Occitanie

dans les thérapies ciblées contre le cancer
Un entretien avec M. Éric DUCOURNAU, Directeur Général des Laboratoires Pierre Fabre
Quels sont les chiffres-clés de Pierre Fabre dans le domaine de l’oncologie ?
Nous nous appuyons sur une expérience de 40 ans dans ce domaine thérapeutique qui connait aujourd’hui des avancées scientifiques considérables au bénéfice des patients. Fin 2018, nous lancions en Europe notre première thérapie ciblée pour traiter une forme particulière de mélanome métastatique. Deux autres thérapies ont suivi depuis, l’une dans le cancer colorectal et l’autre dans la prévention de la récidive du cancer du sein. Portés par ces innovations, nos revenus en oncologie ont dépassé la barre des 400 M€ en 2022, soit un doublement en l’espace de 3 ans. L’activité oncologique devrait représenter près du quart des revenus globaux du Groupe d’ici 2026.
Quels sont vos projets en cours en oncologie ?
Nous lançons actuellement une thérapie cellulaire pour le traitement de patients adultes et pédiatriques atteints d’un lymphome très rare survenant après une transplantation d’organe ou de moelle osseuse. Ce traitement a été découvert par notre partenaire américain Atara Biotherapeutics et nous en avons obtenu la licence exclusive pour l’Europe. Dans son dernier rapport annuel, l’Agence européenne des médicaments (EMA) l’a placé sur la liste des nouvelles thérapies les plus utiles en matière de santé publique. Par ailleurs, nous menons actuellement trois études cliniques de phase 3. Deux se déroulent en Chine chez des patients porteurs de la mutation BRAF dans le cancer colorectal et dans celui du poumon non à petites cellules. La troisième étude est menée en Europe et concerne la prévention de la récidive du mélanome dans cette même mutation BRAF. Les mises sur le marché dans ces nouvelles indications pourraient intervenir entre 2026 et 2028.
Quelle est votre stratégie en matière de recherche dans le médicament ?
Nous nous focalisons désormais sur les thérapies ciblées en oncologie, c’est-àdire des molécules capables d’inhiber des
mutations entrainant des dérèglements tumoraux au niveau de la cellule. La même mutation peut se retrouver sur différents organes, ce qui permet de développer une même molécule dans plusieurs indications. Nous avons beaucoup appris dans ce domaine depuis 2015 à travers nos efforts de recherche et développement sur la mutation BRAF.
Pourquoi les thérapies ciblées en particulier ?
Cet axe d’innovation est particulièrement bien adapté à un laboratoire de notre taille. Le temps de développement d’une thérapie ciblée est en effet inférieur à celui d’une immunothérapie, avec des taux d’attrition plus faibles et la possibilité de lancer des traitements « best-in-class », voire « firstin-class », dans des indications de niche qui n’intéressent pas forcément les plus gros laboratoires. Cette stratégie requiert de développer en interne des expertises scientifiques et médicales de pointe, ainsi qu’une forte capacité à bâtir des partenariats avec des biotechs innovantes Nous venons justement de conclure un accord avec Scorpion Therapeutics, une biotech américaine installée à Boston, en vue de développer deux nouvelles molécules dans la prise en charge d’une mutation particulière du cancer du poumon non à petites cellules. Nous avons l’ambition de conclure d’autres partenariats
de même nature dans les prochaines années, en oncologie mais aussi dans les maladies rares et en dermatologie, et nous l’espérons avec des biotechs françaises.
Est-ce toujours en région Occitanie que vous prévoyez d’investir demain en R&D ?
Nous concentrons la plus grande partie de nos efforts de recherche dans le médicament et la dermo-cosmétique sur le campus de l’Oncopole à Toulouse. Celui-ci figure aujourd’hui parmi les places fortes en Europe en matière d’essais cliniques en oncologie. Depuis 10 ans, nous développons des projets en partenariat avec l’IUCT (Institut Universitaire du Cancer de Toulouse) et plusieurs laboratoires du CRCT (Centre de Recherche sur le Cancer de Toulouse). Nous espérons faire monter en puissance ces coopérations dans les prochaines années. Il y a 20 ans, notre fondateur joua un rôle déterminant dans la genèse du projet de l’Oncopole imaginé pour redonner un sens à un territoire dévasté par l’explosion de l’usine AZF. Nous avons à cœur de perpétuer sa vision, et nous nous réjouissons que la Région Occitanie et la Métropole de Toulouse aient placé l’oncologie parmi leurs priorités en matière d’innovation.
- 9 600 collaborateurs dont 38 % basés en Occitanie et 600 dans le Centre d’Innovation Pierre Fabre à l’Oncopole de Toulouse
- 2,7 Mds€ de chiffre d’affaires en 2022, réalisé dans 120 pays
- 2 activités : Dermo-cosmétique (55 % du chiffre d’affaires) et Médicaments (45 %)
- 90 % de la production réalisée en France sur 6 sites (dont 5 en Occitanie)
Publireportage 12 Avril 2023
© Laboratoires
Pierre Fabre
Pierre Fabre : les chiffres-clés
Pierre Fabre Investing in Occitania in targeted cancer therapies
An interview with Mr. Éric DUCOURNAU, CEO of Pierre Fabre Laboratories

What are Pierre Fabre’s key figures in the field of oncology?
We have 40 years of experience in this therapeutic area, which is currently experiencing considerable scientific advances for the benefit of patients. At the end of 2018, we launched our first targeted therapy in Europe to treat a particular form of metastatic melanoma. Two other therapies have since followed, one in colorectal cancer and the other in the prevention of breast cancer relapse. Driven by these innovations, our oncology revenues have exceeded €400m in 2022, doubling in the space of three years. The oncology business is expected to account for nearly a quarter of the Group’s total revenues by 2026.
What are your current projects in oncology?
We are currently launching a cell therapy for the treatment of adult and paediatric patients with a very rare lymphoma that occurs after organ or bone marrow transplantation. This treatment was discovered by our US partner Atara Biotherapeutics and we have obtained the exclusive licence for Europe. In its latest annual report, the European Medicines Agency (EMA) listed it as one of the most useful new therapies for public health. In addition, we are currently conducting three Phase 3 clinical trials. Two are being conducted in China in patients with BRAF mutations in colorectal cancer and non-small cell lung cancer. The third study is being conducted in Europe and concerns the prevention of melanoma relapse in the same BRAF mutation. These new indications could be marketed between 2026 and 2028.
What is your drug research strategy?
We are now focusing on targeted therapies in oncology, i.e. molecules capable of inhibiting mutations that cause tumour disorders at the cellular level. The same mutation can be found in different organs, which makes it possible to develop the same molecule for several indications. We have learned a lot in this area since 2015 through our research and development efforts on the BRAF mutation.
Why targeted therapies in particular?
This area of innovation is particularly well suited to a laboratory of our size. The development time for a targeted therapy is indeed shorter than for an immunotherapy, with lower attrition rates and the possibility of launching «best-in-class» or even «first-in-class» treatments in niche indications that do not necessarily interest the largest laboratories. This strategy requires developing in-house cutting-edge scientific and medical expertise, as well as a strong capacity to build partnerships with innovative biotechs. We have just signed an agreement with Scorpion Therapeutics, an American biotech based in Boston, with a view to developing two new molecules for the treatment of a particular mutation in non-small cell lung cancer. Our ambition is to develop other similar partnerships in the coming years, not only in oncology but also in rare diseases and dermatology, and we hope with French biotechs.
Are you still planning to invest in R&D in the Occitania region in the future?
We are concentrating most of our research efforts in drugs and dermocosmetics on the
Oncopole campus in Toulouse. This campus is now one of Europe’s leading centres for clinical trials in oncology. For the past 10 years, we have been developing projects in partnership with the IUCT (Toulouse University Cancer Institute) and several laboratories of the CRCT (Toulouse Cancer Research Centre). We hope to increase this cooperation in the coming years. Twenty years ago, our founder was one of the main instigators of the Oncopole project, which was imagined to give a new meaning to an area devastated by the explosion of the AZF factory. We are committed to perpetuating his vision, and we are delighted that the Occitania Region and the Toulouse Metropolitan Area have made oncology one of their priorities for innovation.
Pierre Fabre: key figures
- 9,600 employees, 38% of whom are based in Occitania and 600 in the Pierre Fabre Innovation Centre at the Oncopole in Toulouse

- 2.7 billion euros in sales by 2022, in 120 countries
- 2 activities: Dermo-cosmetics (55% of sales) and Medicines (45%)
- 90% of production carried out in France on 6 sites (5 of which are in Occitania)
Publireportage 13 April 2023
© Laboratoires Pierre Fabre
1 avenue d’Albi -
Castres https://www.pierre-fabre.com
Pierre Fabre site on the Oncopole campus in Toulouse / Site de Pierre Fabre sur le campus de l’Oncopole à Toulouse Laboratoires Pierre Fabre
F-81100
ANR et Région Sud : une complémentarité de nos modes de soutien à la recherche
Un entretien avec M. Thierry DAMERVAL, Président-directeur général de l’Agence nationale de la recherche (ANR)

équipe de recherche. Tous les domaines scientifiques sont représentés, illustrant l’intensité et la qualité de la recherche dans l’une des premières régions scientifiques françaises. Les financements apportés par l’ANR aux projets de la région, au travers de son plan d’action et des programmes de France 2030, ont représenté plus d’1 milliard d’euros.
En termes d’impact, les projets financés dans le cadre de France 2030 ont permis de soutenir près de 800 thèses, environ 30 000 publications, le dépôt de plus de 1 100 brevets et la création de 280 start-ups.
En 2022, l’ANR a célébré 15 ans de coopération franco-allemande, en quoi consiste-t-elle ?
Quel bilan d’étape dressez-vous des appels à projets génériques, spécifiques et de France 2030 pour 2022 ?
Notre objectif, pour l’année 2022, était d’atteindre un taux de succès de 23 % sur l’Appel à projets générique, nous l’avons dépassé puisqu’il s’élève aujourd’hui à 24 %. Il faut rappeler qu’il était tombé à moins de 10 % il y a quelques années. La loi de programmation de la recherche a fixé un objectif de 30 % de taux de succès et les budgets qu’elle nous accorde nous ont permis de franchir cette première étape importante pour les communautés scientifiques. La recherche partenariale constitue une autre priorité : croissance des Labcoms (laboratoire commun entre une PME ou ETI et un laboratoire académique) et des Chaires industrielles avec les grands groupes, et progression du budget du programme Carnot qui est passé de 62 M€ à 82 M€ en 2021, 92 M€ en 2022 avant une nouvelle augmentation à 107 M€ en 2023. Nous avons également mis en place des appels ciblés, pour répondre à des problématiques de recherche spécifiques, comme l’illustre le programme sur le chlordécone, en partenariat avec la Région Guadeloupe et la Collectivité territoriale de Martinique. D’autres initiatives s’inscrivent dans le volet « Science avec et pour la société » conformément à la loi qui prévoit que nous consacrions 1 % du budget de soutien à la recherche aux actions de diffusion de la culture scientifique.
Concernant France 2030, de nombreuses actions ont été mises en place, tant sur le volet « structurel » avec par exemple les appels Excellences, dont Aix-Marseille Université a été lauréate dès la première vague, que sur le
volet « dirigé » avec la mise en place des PEPR (programmes et équipements prioritaires de recherche) avec la sélection de la deuxième vague des PEPR exploratoires, portant à 17 le nombre de ces grands programmes lancés depuis la mise en place de cette action.
Pourriez-vous nous parler de votre partenariat avec la Région Sud ?
Nous sommes très heureux de nous engager dans un partenariat pluriannuel avec la Région Sud. Cette coopération s’articule autour d’objectifs communs : soutenir et renforcer les capacités de recherche et d’innovation sur le territoire de la région Provence-Alpes-Côte d’Azur en vue de conforter l’excellence de la recherche et de favoriser son rayonnement à l’échelle nationale et internationale. Concrètement, il permet à la Région de disposer de données sur les projets financés par l’ANR, l’évolution des thématiques, la nature des actions, afin de contribuer, notamment, à la préparation du Schéma régional de l’enseignement supérieur, de la recherche et de l’innovation (SRESRI 2023-2028). Il vise à assurer une complémentarité de nos modes de soutien à la recherche, à en donner une meilleure visibilité aux laboratoires, aux entreprises, et à leur simplifier la recherche de financements.
Il est difficile de sélectionner des exemples de projets financés vu le nombre et la qualité des recherches : de 2014 à 2021, on compte plus de 2 200 participations des équipes de la région à des projets financés dans les différents appels du plan d’action de l’ANR (hors France 2030), dont près de 1 000 coordinations. Plus de 170 jeunes chercheurs et jeunes chercheuses ont été soutenus pour mettre en place leur
Le programme FRAL, appel à projets franco-allemand en sciences humaines et sociales, a été mis en place en 2007 par l’ANR et son homologue allemand, la DFG (Deutsche Forschungsgemeinschaft). Le colloque, organisé, dans le cadre de la Présidence française de l’Union européenne, les 14 et 15 juin 2022 à Paris, a permis de dresser un bilan de ces quinze années de coopération et d’inscrire ce partenariat dans une perspective européenne, comme l’illustrait bien le titre de cet événement « Pour une Europe des sciences humaines et sociales ».
Ce programme soutient depuis 15 ans l’excellence de la recherche en sciences humaines et sociales en France et en Allemagne; plus de 230 projets de recherche réalisés en coopération ont été soutenus, ils couvrent tous les domaines des sciences humaines et sociales, soutenant aussi bien l’interdisciplinarité que les disciplines rares. Ces projets ont souvent été la base de coopérations plus larges, étendues à d’autres pays, trouvant des financements au niveau européen ou dans le cadre d’initiatives internationales.
Ce colloque a montré la diversité des projets soutenus depuis 15 ans, qui dépassent largement un champ d’études franco-allemand, leurs apports à notre compréhension de problématiques telles que, par exemple, l’environnement et les ressources naturelles, les humanités numériques, la démocratie et la représentativité, les inégalités et les discriminations.
Autant de questions qui prennent aujourd’hui, dans le contexte de crises que traverse notre monde, une acuité toute particulière.
14 Avril 2023
© Myr Muratet, ANR
ANR and the Southern Region: complementarity of our research support methods
What is your assessment of the generic, specific and France 2030 calls for projects for
2022?
Our objective for the year 2022 was to reach a success rate of 23% on the generic call for projects, and we have exceeded it, since it now stands at 24%. It should be remembered that it had fallen to less than 10% a few years ago. The research programming law has set an objective of a 30% success rate and the budgets it grants us have enabled us to take this first important step for the scientific communities. Partnership research is another priority: growth of Labcoms (joint laboratory between an SME or ETI and an academic laboratory) and Industrial Chairs with large groups, and an increase in the budget of the Carnot programme from €62 million to €82 million in 2021, €92 million in 2022 before a further increase to €107 million in 2023. We have also set up targeted calls to respond to specific research problems, as illustrated by the chlordecone programme, in partnership with the Guadeloupe Region and the Martinique Territorial Authority. Other initiatives are part of the «Science with and for society» componentin accordance with the law, which stipulates that we devote 1% of the research support budget to actions to disseminate scientific culture.
Concerning France 2030, many actions have been implemented, both on the ‘structural’ side with, for example, the Excellence calls, of which Aix-Marseille University was the winner in the first wave, and on the ‘directed’ side with the implementation of the PEPRs (priority research programmes and equipment) with the selection of the second wave of exploratory PEPRs, bringing to 17 the number of such major programmes launched since the inception of this action.
Could you tell us about your partnership with the Southern Region?
We are very pleased to enter into a multi-year partnership with the South Region. This cooperation is based on common objectives: to support and strengthen research and innovation capacities in the Provence-Alpes-Côte d’Azur region in order to consolidate research excellence and promote its influence on a

national and international scale. In concrete terms, it provides the Region with data on the projects financed by the ANR, the evolution of the themes, the nature of the actions, in order to contribute, in particular, to the preparation of the Regional Plan for Higher Education, Research and Innovation (SRESRI 2023-2028). It aims to ensure the complementarity of our research support methods, to give laboratories and companies better visibility and to simplify the search for funding.
It is difficult to select examples of funded projects given the number and quality of the research: from 2014 to 2021, there were more than 2,200 participations by the region’s teams in projects funded under the various calls of the ANR’s action plan (excluding France 2030), including nearly 1,000 coordinations. More than 170 young researchers were supported to set up their research team. All scientific fields are represented, illustrating the intensity and quality of research in one of France’s leading scien-
tific regions. The funding provided by the ANR to the region’s projects, through its action plan and the France 2030 programmes, represented more than 1 billion euros.
In terms of impact, the projects funded under France 2030 have supported nearly 800 theses, around 30,000 publications, the filing of over 1,100 patents and the creation of 280 start-ups.
In 2022, the ANR celebrated 15 years of Franco-German cooperation, what does it involve?
The FRAL programme, a call for Franco-German projects in the humanities and social sciences, was set up in 2007 by the ANR and its German counterpart, the DFG (Deutsche Forschungsgemeinschaft).
The conference, organised in the framework of the French Presidency of the European Union, on 14 and 15 June 2022 in Paris, provided an opportunity to take stock of these fifteen years of cooperation and to place this partnership in a European perspective, as the title of this event «For a Europe of Humanities and Social Sciences» clearly illustrates.
For 15 years, this programme has been supporting research excellence in the humanities and social sciences in France and Germany; more than 230 cooperative research projects have been supported, covering all areas of the humanities and social sciences, supporting both interdisciplinarity and rare disciplines. These projects have often been the basis for broader cooperation, extended to other countries, finding funding at European level or in the framework of international initiatives.
This colloquium showed the diversity of the projects supported over the past 15 years, which go far beyond a Franco-German field of study, and their contribution to our understanding of issues such as, for example, the environment and natural resources, digital humanities, democracy and representativeness, inequalities and discrimination.
These are all issues that are particularly relevant today in the context of the crises our world is going through.
15 April 2023
© ANR
An interview with Mr Thierry DAMERVAL, President and CEO of the French National Research Agency (ANR)
Retisser le lien entre la recherche universitaire et l’entreprise grâce au doctorat
Un entretien avec M. Hendrik DAVI, Député des Bouches-du-Rhône, Rapporteur de la Mission de suivi de l’évaluation de l’accès à l’enseignement supérieur, Membre de l’OPECST

Quelles sont les spécificités et les priorités de recherche de la Région Sud PACA ?
Notre région bénéficie d’un climat et de ressources hydriques alpines très favorables à l’agriculture, ce qui justifie les implantations de l’INRAE à Avignon et Antibes. La région doit devenir un pilier de la recherche en agriculture écologique en renforçant ses pôles en génétique et en lutte biologique. De plus, l’ensoleillement et le vent devraient permettre à notre région d’être à la pointe dans le développement des énergies renouvelables. Il faudrait favoriser la recherche finalisée à Aix-Marseille Université et sur le site du CEA de Cadarache. La région PACA, c’est aussi une façade maritime très importante : nous devrions donc être moteurs dans le développement de tous les métiers d’avenir en lien avec la mer, la gestion durable des ressources halieutiques et les moyens de préserver les écosystèmes marins. Le passé et le présent industriels à Fos-sur-Mer devraient aussi nous aider à développer une industrie propre et décarbonée pour le XXIème siècle. Grâce à ses centres hospitalo-universitaires, la région PACA peut enfin être à la pointe dans tous les sujets relatifs au « One Health », avec un continuum entre la recherche fondamentale, la recherche finalisée et le transfert technologique.
Pourriez-vous nous parler de votre action dans le cadre de la Mission de suivi de l’évaluation de l’accès à l’enseignement supérieur ?
Ma mission d’évaluation comportait deux parties. La première était une analyse du projet de loi de finance concernant l’université et la vie étudiante. J’ai montré dans mon rapport que les augmentations de budget en trompe-l’œil étaient insuffisantes au vu des enjeux. En effet, une fois déduites l’inflation et l’augmentation du point d’indice des fonctionnaires, le budget décroît en réalité de plus de 2 % alors que la population étudiante augmente. Or, avec la crise écologique et sanitaire, nous avons plus que jamais besoin d’investissements dans la produc-
tion de connaissances scientifiques et dans la qualification de tous nos jeunes, du CAP au doctorat. Nous ne rénoverons pas nos bâtiments sans innovation dans le secteur de la construction et sans jeunes ingénieurs ou ouvriers qualifiés. Dans la seconde partie du rapport, j’ai dressé un bilan de l’autonomie des universités 15 ans après le lancement du processus. Nous avons auditionné des dizaines d’acteurs et de chercheurs et le bilan n’est guère brillant. Nos universités se sont appauvries, avec une baisse de près de 10 % de la dépense par étudiant. Les conditions d’études se sont dégradées et la réussite en licence n’a pas progressé malgré la sélection de plus en plus forte avec Parcoursup et la sélection en Master. La sélection n’est donc pas la solution, elle laisse trop d’étudiants au bord du chemin. En 2022, aucune formation n’a été proposée à 125 000 étudiants et près de 300 000 n’ont pas obtenu la formation de leur choix. Enfin, les conditions de travail des enseignants-chercheurs se sont aussi dégradées avec près de 20 % de perte de valeur de leurs salaires. Un chercheur accède en moyenne à 36 ans à un poste fixe avec un salaire de 1 800€ nets. De
plus, le recours exclusif aux appels d’offres pour trouver des financements a fait exploser les logiques bureaucratiques et accru la souffrance au travail.
Pourriez-vous nous présenter les travaux en cours au sein de l’OPECST ?
L’office parlementaire d’évaluation des choix scientifiques et technologiques propose des auditions et des notes scientifiques pour éclairer les parlementaires sur certains sujets. En pleine période de COP27 pour le climat et de COP15 pour la biodiversité, j’ai été en charge d’une note scientifique sur les espèces exotiques invasives. Dans cette note, nous avons expliqué pourquoi la mondialisation des échanges, multipliés par 40 depuis 1945, a fait exploser le nombre d’espèces introduites. Or ces espèces peuvent avoir des effets négatifs sur la biodiversité, la santé de nos écosystèmes (le frelon asiatique menaçant les abeilles) ou notre propre santé (l’ambroisie qui provoque des allergies). Nous avons aussi donné des pistes pour lutter contre ce risque.
Quels selon vous les principaux défis à relever pour encourager la recherche, la technologie et l’innovation ? Nous devons d’abord redonner confiance aux jeunes chercheurs avec plus de moyens à la recherche et l’université. J’ai proposé fin janvier un certain nombre de pistes en ce sens dans une proposition de loi sur l’enseignement supérieur et la recherche : revenir à des crédits récurrents, en finir avec la bureaucratie de la gestion par projets, revaloriser les salaires, accroître les ressources des étudiants (allocation d’autonomie, construction de logements étudiants). Ensuite, il faut retisser le lien entre la recherche universitaire et l’entreprise. Or cela passe par le doctorat. Alors que tout le monde survend l’apprentissage, il est surprenant de constater le manque de recours au doctorat, qui est justement un mode de formation par la recherche. L’embauche de docteurs dans les entreprises est un puissant moyen de développer le transfert entre la recherche et l’entreprise. Une piste à explorer absolument !
16 Avril 2023
© D.R.
Bridging the gap between university research and business through the PhD
What are the specificities and research priorities of the Southern PACA region?
Our region benefits from a climate and alpine water resources that are very favourable to agriculture, which justifies the establishment of INRAE in Avignon and Antibes. The region must become a pillar of research in ecological agriculture by strengthening its genetic and biological control centres. Moreover, the sunshine and wind should enable our region to be at the forefront of the development of renewable energies. It would be necessary to encourage research at Aix-Marseille University and at the CEA site in Cadarache. The PACA region also has a very important maritime coastline: we should therefore be a driving force in the development of all the future professions linked to the sea, the sustainable management of fishing resources and the means to preserve marine ecosystems. The industrial past and present in Fos-sur-Mer should also help us to develop a clean, low-carbon industry for the 21st century. Thanks to its university hospital centres, the PACA region can finally be at the forefront of all subjects relating to «One Health», with a continuum between fundamental research, finalised research and technology transfer.

Could you tell us about your work as part of the Follow-up mission on the evaluation of access to higher education?
My evaluation mission had two parts. The first was an analysis of the finance bill concerning universities and student life. I showed in my report that the deceptive budget increases were insufficient in view of the stakes. Indeed, once inflation and the increase in the index point for civil servants are deducted, the budget actually decreases by more than 2% while the student population increases. With the ecological and health crisis, we need more than ever to invest in the production of scientific knowledge and in the qualification of all our young people, from the CAP (certificate of professional competence) to the PhD. We
will not renovate our buildings without innovation in the building sector and without young engineers and skilled workers. In the second part of the report, I drew up an assessment of university autonomy 15 years after the process was launched. We have heard from dozens of actors and researchers and the results are not very good. Our universities have become poorer, with a drop of almost 10% in expenditure per student. Study conditions have deteriorated and success in the bachelor’s degree has not improved despite the increasingly strong selection
Could you tell us about the work in progress within the OPECST?
The Parliamentary Office for the Evaluation of Scientific and Technological Choices (OPECST) proposes hearings and scientific notes to enlighten parliamentarians on certain subjects. In the middle of COP27 for climate and COP15 for biodiversity, I was in charge of a scientific note on invasive alien species. In this note, we explained why the globalisation of trade, which has increased 40-fold since 1945, has led to an explosion in the number of introduced species. These species can have negative effects on biodiversity, the health of our ecosystems (the Asian hornet threatening bees) or our own health (ragweed causing allergies). We have also given some ideas on how to fight against this risk.
What do you think are the main challenges to encourage research, technology and innovation?
process with Parcoursup and selection for the Master’s degree. Selection is therefore not the solution; it leaves too many students by the wayside. In 2022, 125,000 students were not offered any training and nearly 300,000 did not obtain the training of their choice. Finally, the working conditions of teacher-researchers have also deteriorated, with a loss of almost 20% in the value of their salaries. On average, a researcher at the age of 36 has access to a permanent position with a salary of €1,800 net. Moreover, the exclusive recourse to calls for tender to find funding has led to an explosion in bureaucratic logic and increased suffering at work.
First of all, we must restore the confidence of young researchers by providing more resources to research and universities. At the end of January I tabled a bill on higher education and research with a number of proposals along these lines: return to recurrent credits, put an end to the bureaucracy of project-based management, revalue salaries, increase student resources (autonomy allowance, construction of student accommodation): return to recurrent credits, put an end to the bureaucracy of project-based management, revalue salaries, increase student resources (autonomy allowance, construction of student accommodation). Secondly, the link between university research and business must be reestablished. This requires the doctorate. While everyone is overselling apprenticeships, it is surprising to note the lack of recourse to the doctorate, which is precisely a mode of training through research. Hiring PhDs in companies is a powerful way of developing the transfer between research and business. This is an avenue that must be explored!
17 April 2023
An interview with Mr. Hendrik DAVI, Member of Parliament for Bouches-du-Rhône, Rapporteur of the Follow-up mission on the evaluation of access to higher education, Member of the OPECST © D.R.
Favoriser la culture de l’innovation
sous toutes ses formes
Un entretien avec le Pr Éric BERTON, Président d’Aix-Marseille Université
Pourriez-vous nous donner quelques exemples de projets de recherche en cours ?
Marseille 2030 dans le cadre d’un comité de prospective stratégique.
Quels sont les chiffres-clés et les domaines d’excellence de la recherche à Aix-Marseille Université (AMU) ?
AMU totalise 80 000 étudiants dont 10 000 étudiants étrangers, 8 000 membres du personnel, 800 M€ de budget et 800 000 m² de surfaces bâties. Elle est présente sur 4 départements (Alpes de Haute-Provence, Hautes-Alpes, Bouches-du-Rhône, Vaucluse) et bien plus de villes : Aix-en-Provence et Marseille bien sûr, mais aussi Digne-lesBains, Gap, Aubagne, La Ciotat, Salon de Provence… Les activités de recherche sont portées par 4 500 enseignants-chercheurs et 3 500 personnels de support répartis au sein de 122 structures de recherches et 18 instituts d’établissements très axés sur l’interdisciplinarité. Parmi les champs disciplinaires les plus dynamiques j’aimerais citer les SHS (sciences humaines et sociales), les sciences de l’environnement, le droit et l’économie, la santé (maladies émergentes, neurosciences, immunologie, oncologie), la chimie, la mécanique, les sciences du numérique ou encore les mathématiques… AMU est une université de recherche intensive qui a reçu d’un jury international le label de l’Initiative d’Excellence (IdEx). Cette reconnaissance nous a donné l’idée de lancer un appel à projets blanc doté de 10 M€ pour recueillir des propositions de projets de recherche, de formation ou d’animation. Cet appel a dépassé nos espérances puisque nous avons déjà reçu 350 lettres d’intention. Les projets devraient être sélectionnés en décembre prochain. Et puis, nous n’oublions pas l’importance de la qualité de vie pour les étudiants et le personnel : notre logo, « socialement engagée », se traduit notamment par des cours multilingues (anglais, arabe…) et une approche innovante de la lutte contre le harcèlement sous toutes ses formes.
AMU a récemment proposé deux réponses dans le cadre de l’appel à projets national « Biocluster » : l’une avec Gustave Roussy (elle apporte son expertise en immuno-oncologie), l’autre axée sur l’immunologie au sens large avec des industriels régionaux et des start-ups à fort potentiel d’innovation. Par ailleurs nos chercheurs sont très impliqués dans des projets liés à la chimie et la virologie, comme en témoignent les travaux de Xavier de Lamballerie, Directeur de l’Unité des Virus Emergents. AMU est également très active en Europe : elle est la deuxième université française à avoir reçu le plus de financements (40 M€) dans le cadre du programme H2020 et la seule à avoir un représentant permanent à Bruxelles. Elle est aussi très impliquée dans CIVIS - l’université civique européenne, une alliance de 10 universités européennes dont AMU est cheffe de file. Au-delà de l’Union européenne, Aix-Marseille Université a développé des relations avec les États-Unis, les pays de l’aire méditerranéenne, l’Afrique subsaharienne, le Moyen-Orient mais aussi la Chine avec un institut franco-chinois à Wuhan : spécialisé dans la formation en biologie, cet établissement a très récemment célébré sa première promotion de co-diplômés AMU sur le niveau licence le 22 juin 2022.


Comment favorisez-vous la valorisation de la recherche et le transfert de technologies ? Quatre structures y sont dédiées : la direction Recherche et valorisation (gestion des contrats avec l’ANR), la filiale Protisvalor (gestion des contrats avec les industriels et des contrats européens), l’actionnariat dans la SATT Sud-Est (maturation des inventions pour les transformer en innovations) et 2 incubateurs de start-up : Impulse (généraliste et local) et Belle de Mai (axé sur les multimédias avec un rayonnement national). S’y ajoute le programme PEPITE de promotion de l’entreprenariat étudiant. AMU est aussi dotée d’une fondation qui lui permet de recevoir des dons d’industriels et de mettre sur pied des chaires industrielles. Récemment, un partenariat avec la CMA-CGM a permis de créer la première Chaire universitaire du territoire dédiée à la santé. AMU est toujours en dialogue avec les acteurs socioéconomiques régionaux et élabore avec eux la vision de
Pourriez-vous nous présenter les activités de la Cité de l’Innovation et des Savoirs d’Aix-Marseille (CISAM) ?
La CISAM a été créée en 2016 pour former massivement les étudiants à la culture de l’entreprenariat et de l’innovation avec le concours d’industriels (CMA-CGM et l’Occitane), de la Métropole Aix-Marseille-Provence, du Conseil régional et de la Ville de Marseille. Lauréat de l’appel à projets « Excellence » lancé dans le cadre du PIA (Programme d’Investissement d’Avenir désormais nommé « France 2030 »), le projet « CISAM+ » porté par AMU a bénéficié d’un financement de 40 M€. Cela permettra à la CISAM de prendre une ampleur considérable et ainsi favoriser les champs de la création artistique, culturelle et technologique. Elle est aussi lauréate d’un contrat européen portant sur les industries culturelles et créatives. Son ambition est de développer des innovations sur des thématiques préférentielles en fonction des villes en partenariat avec le CNRS, l’Inserm et l’IRD. In fine, nous promouvons l’innovation sous toutes ses formes : technologique, pédagogique et managériale. Une innovation au bénéfice des étudiants.
18 Avril 2023
©
© Jean Fondacci
Aix-Marseille Université
Fostering a culture of innovation in all its forms
An interview with Prof. Éric BERTON, President of Aix-Marseille University
What are the key figures and areas of research excellence at Aix-Marseille University (AMU)?
AMU has a total of 80,000 students, including 10,000 foreign students, 8,000 staff members, a budget of €800 million and 800,000 m² of building space. It is present in 4 departments (Alpes de Haute-Provence, Hautes-Alpes, Bouches-du-Rhône, Vaucluse) and many more towns: Aix-en-Provence and Marseille of course, but also Digneles-Bains, Gap, Aubagne, La Ciotat, Salon de Provence, etc. Research activities are carried out by 4,500 teacher-researchers and 3,500 support staff spread out over 122 research structures and 18 institutes of establishments that are very much geared to interdisciplinarity. Among the most dynamic disciplinary fields, I would like to mention human and social sciences, environmental sciences, law and economics, health (emerging diseases, neurosciences, immunology, oncology), chemistry, mechanics, digital sciences and mathematics...
AMU is a research-intensive university that has been awarded the label of the Initiative of Excellence (IdEx) by an international jury. This recognition gave us the idea of launching a white call for projects with a budget of €10 million to gather proposals for research, training and animation projects. This call has exceeded our expectations since we have already received 350 letters of intent. The projects should be selected next December. And we have not forgotten the importance of quality of life for students and staff: our ‘socially committed’ logo is reflected in multilingual courses (English, Arabic, etc.) and an innovative approach to the fight against harassment in all its forms.
Could you give us some examples of current research projects?

AMU recently proposed two responses to the national call for projects «Biocluster»: one with Gustave Roussy (it brings its expertise in immuno-oncology), the other focused on immunology in the broadest sense with regional industrialists and start-ups with high innovation potential. In addition, our researchers are very involved in projects related to chemistry and virology, as shown by the work of Xavier de Lamballerie, Director of the Emerging Viruses Unit. AMU is also very active in Europe: it is the second French university to have received the most funding (€40M) under the H2020 programme and the only one to have a permanent representative in Brussels. It is also very involved in CIVIS - the European Civic University, an alliance of 10 European universities for which AMU is the lead university. Beyond the European Union, Aix-Marseille University has developed relations with the United States, the countries of the Mediterranean area, sub-Saharan Africa, the Middle East and also China with a Franco-Chinese institute in Wuhan: specialised in biology training, this establishment very recently celebrated its first class of AMU co-graduates at Bachelor’s level on 22 June 2022.
How do you promote the development of research and technology transfer?

Four structures are dedicated to this: the Research and Technology Transfer Department (management of contracts with the ANR), the subsidiary Protisvalor (management of contracts with industrialists and European contracts), the shareholding in the SATT Sud-Est (maturation of inventions to transform them into innovations) and two start-up incubators: Impulse (generalist and
local) and Belle de Mai (focused on multimedia with a national influence). There is also the PEPITE programme for promoting student entrepreneurship. AMU also has a foundation that allows it to receive donations from industrialists and to set up industrial chairs. Recently, a partnership with CMACGM has enabled the creation of the first university chair in the region dedicated to health. AMU is always in dialogue with regional socio-economic players and works with them to develop the vision of Marseille 2030 within the framework of a strategic foresight committee.
Could you present the activities of the Cité de l’Innovation et des Savoirs d’Aix-Marseille (CISAM)?
CISAM was created in 2016 to train students on a massive scale in the culture of entrepreneurship and innovation with the help of industrialists (CMA-CGM and l’Occitane), the Aix-Marseille-Provence Metropolis, the Regional Council and the City of Marseille. Winner of the «Excellence» call for projects launched within the framework of the PIA (Programme d’Investissement d’Avenir, now called «France 2030»), the «CISAM+» project led by AMU has received €40 million in funding. This will enable CISAM to expand considerably and thus promote the fields of artistic, cultural and technological creation. It is also the winner of a European contract on cultural and creative industries. Its ambition is to develop innovations on preferential themes according to the cities in partnership with the CNRS, Inserm and IRD. Ultimately, we promote innovation in all its forms: technological, educational and managerial. Innovation for the benefit of students.
19 April 2023
© Aix-Marseille
© Aix-Marseille
Université
Université
Faire face ensemble aux grandes transitions liées à l’économie, la réindustrialisation et l’environnement
Un entretien avec le Pr Rostane MEHDI, Président de la Conférence Régionale des Grandes Écoles - PACA, Directeur de Sciences Po Aix

phase avec sa politique scientifique et pédagogique. L’École de l’Air de Salon de Provence est en pointe sur les drones et l’IA (interactions homme-machine dans les combats du futur). SKEMA Business School développe un projet de recherche sur le démantèlement des infrastructures nucléaires en collaboration avec des ingénieurs et travaille sur la gestion des données de santé avec l’Université de Nice. Pour sa part, Sciences Po Aix s’est associé il y a deux ans avec l’Académie du renseignement afin de créer un mastère spécialisé qui sera intégré à une chaire partenariale dont le principal objectif sera de favoriser l’émergence d’une culture française du renseignement.
Comment les actions de la CRGE PACA s’articulent-elles avec les politiques de site sur le territoire ?
Quels sont les domaines d’excellence parmi les membres de la Conférence Régionale des Grandes Écoles - PACA (CRGE PACA) ?
La CRGE PACA s’inscrit dans une dynamique de développement permanent avec 18 écoles membres contre 15 en 2020. Résolument pluridisciplinaire (sciences de l’ingénieur, commerce, sciences politiques, art et design, architecture…), elle est identifiée comme ressource d’expertise crédible et ses membres forment des « praticiens des systèmes complexes » qui pourront appréhender les défis sociétaux majeurs que sont le développement durable, les transitions économique et écologique, les risques géopolitiques et environnementaux, les enjeux numériques et l’intelligence artificielle… Mais les grandes écoles ne dispensent pas uniquement des savoirs : elles transmettent aussi un savoir-être, une éthique de la responsabilité, un goût du service à la communauté.
Pourriez-vous nous donner quelques exemples de projets de recherche en cours dans les établissements membres ?
KEDGE Business School a ouvert une chaire humanitaire dans le but de mettre en place un certificat de logistique humanitaire en
Notre principale préoccupation est de renforcer le niveau d’interconnaissance entre les différents acteurs du territoire. Troisième acteur de l’enseignement supérieur régional avec près de 20 000 étudiants, la CRGE PACA a été associée aux travaux d’élaboration du Schéma régional de l’enseignement supérieur, de la recherche et de l’innovation (SRESRI). Par ailleurs, Sciences Po Aix et Centrale Marseille sont membres fondateurs de l’IdEx Aix-Marseille Université (AMU) et participent à ce titre pleinement au fonctionnement du site. La CRGE PACA a également offert un lieu d’échange privilégié avec le rectorat, les universités et les pouvoirs publics pour affronter l’épreuve pandémique en valorisant certaines innovations pédagogiques comme les plateformes numériques, devenues depuis des campus numériques performants. Enfin, la CRGE PACA encourage les partenariats renforcés entre ses membres comme le parcours commun entre Sciences Po Aix et l’École de l’Air, le partenariat sur la cybersécurité et l’accueil mutuel d’étudiants entre Sciences Po Aix et Centrale Marseille… Ces initiatives contribuent au dynamisme et au rayonnement du territoire.
Comment la CRGE PACA contribue-t-elle à relever les défis liés aux mutations de l’enseignement supérieur et de la recherche- ? Nous organisons le 5 juin 2023 un grand événement pour rassembler les écoles membres
ainsi que les grands acteurs publics et privés du territoire. Notre objectif est de mieux nous faire connaître et de clarifier ce que nous pouvons proposer au territoire. Notre fil conducteur : comment faire face ensemble aux grandes transitions liées à l’économie, la réindustrialisation et aux défis environnementaux ? Nous pouvons y apporter une réponse par ce qui singularise notre modèle : la formation à la pratique et l’animation de systèmes complexes en conjuguant compétences disciplinaires, soft skills, leadership, créativité, ouverture d’esprit pour jeter des ponts entre différentes disciplines, mise en perspective historique et culturelle… In fine, la CRGE PACA fonde sa mission sur trois préoccupations : la pertinence de la formation au regard de nos objectifs (former les cadres dirigeants des secteurs publics et privé de demain), l’innovation (faire évoluer les outils d’enseignement au service d’une transmission des savoirs toujours plus performante) et la démocratisation de l’accès à l’enseignement supérieur en conciliant ouverture et sélectivité. Nous veillons de longue date à créer les conditions d’accès aux élèves socialement ou économiquement plus fragiles et sommes fiers de nos 30 à 35 % de boursiers ! Nos membres ont aussi noué des partenariats avec des lycées situés en REP ou REP+ pour préparer leurs élèves à l’enseignement supérieur. Cette politique a fait ses preuves : nous formons certes une « élite » mais sans jamais cultiver un esprit de caste que nous avons en horreur. Il en va de notre responsabilité vis-à-vis de la société.

20 Avril 2023
© Sciences Po Aix © Sciences Po Aix
Facing together the major transitions linked to the economy, reindustrialisation and the environment
What are the areas of excellence among the members of the Conférence Régionale des Grandes Écoles - PACA (CRGE PACA)?
The CRGE PACA is part of a permanent development dynamic with 18 member schools, compared to 15 in 2020. Resolutely multidisciplinary (engineering sciences, business, political sciences, art and design, architecture...), it is identified as a credible resource of expertise and its members train «practitioners of complex systems» who will be able to apprehend the major societal challenges such as sustainable development, economic and ecological transitions, geopolitical and environmental risks, digital issues and artificial intelligence... But the grandes écoles do not only provide knowledge: they also transmit interpersonal skills, an ethic of responsibility and a taste for community service.
Could you give us some examples of research projects underway in member institutions?
KEDGE Business School has opened a humanitarian chair with the aim of setting up a certificate in humanitarian logistics in line with its scientific and educational policy. The École de l’Air de Salon de Provence is at the forefront of research into drones and AI (human-machine interaction in future combat). SKEMA Business School is developing a research project on the dismantling of nuclear infrastructures in collaboration with engineers and is working on health data management with the University of Nice. Two years ago, Sciences Po Aix joined forces with the Académie du renseignement to create a specialised master’s degree that will be integrated into a partnership chair whose main objective will be to promote the emergence of a French intelligence culture.
How do the actions of the CRGE PACA fit in with the site policies in the region?
Our main concern is to strengthen the level of inter-knowledge between the various players in the region. As the third largest player in regional higher education, with nearly 20,000 students, the CRGE PACA was involved in the work of drawing
up the Regional Plan for Higher Education, Research and Innovation (SRESRI). In addition, Sciences Po Aix and Centrale Marseille are founding members of the IdEx Aix-Marseille University (AMU) and as such participate fully in the operation of the site. The CRGE PACA has also provided a privileged forum for exchange with the rectorate, the universities and the public authorities in order to face the pandemic ordeal by promoting certain pedagogical innovations such as the digital platforms, which have since become efficient digital campuses. Finally, the CRGE PACA encourages stronger partnerships between its members, such as the common path between Sciences Po Aix and the École de l’Air, the partnership on cybersecurity and the mutual hosting of students between Sciences Po Aix and Centrale Marseille... These initiatives contribute to the dynamism and influence of the region.

How is the CRGE PACA helping to meet the challenges of the changes in higher education and research?
We are organising a major event on 5 June 2023 to bring together our member schools and the major public and private players in the region. Our objective is to make ourselves better known and to clarify what
we can offer the region. Our guiding principle: how can we face together the major transitions linked to the economy, reindustrialisation and environmental challenges? We can provide an answer through what makes our model unique: training in the practice and animation of complex systems by combining disciplinary skills, soft skills, leadership, creativity, open-mindedness to build bridges between different disciplines, historical and cultural perspective... In fine, the CRGE PACA bases its mission on three concerns: the relevance of the training to our objectives (training tomorrow’s public and private sector executives), innovation (developing teaching tools for an ever more effective transmission of knowledge) and the democratisation of access to higher education by reconciling openness and selectivity. For a long time, we have been working to create conditions of access for socially or economically vulnerable students and we are proud of our 30 to 35% of scholarship holders! Our members have also established partnerships with secondary schools located in REP (priority education networks) or REP+ to prepare their students for higher education. This policy has proved its worth: we certainly train an «elite» but without ever cultivating a caste mentality that we abhor. Our responsibility to society is at stake.
21 April 2023
© Sciences Po Aix
An interview with Prof. MEHDI, President of the Conférence Régionale des Grandes Écoles - PACA, Director of Sciences Po Aix
Intelligence artificielle et technologies numériques : les smart techs ont le vent en poupe
Big data et puissance de calcul, cybersécurité, microélectronique, 5G, technologies quantiques et même jeux vidéo : les applications de l’intelligence artificielle et du numérique ne manquent pas. Une expertise plurielle que les acteurs des régions Sud et Occitanie déploient avec brio.

Située dans le top 3 des régions sur le « numérique » avec près de 2 200 établissements privés (Orange, NXP, Schneider, STMicroelectronics, IBM, Infineon…) et plus de 70 000 emplois, la région Sud dispose de 4 territoires labélisés French Tech et le campus SophiaTech est une référence mondiale. La recherche y est également riche avec la présence forte d’Inria. La région Sud se différentie sur les segments de la filière microélectronique avec des applications fortes sur les smart cities, l’agriculture de précision, la santé, les smart grids, l’industrie 4.0, le véhicule autonome, l’e-tourisme, la silver économie, etc.

Première région de France en volume de production de composants électroniques, la région Sud est également positionnée sur les objets connectés et affiche une position de leader européen en matière d’IA notamment grâce au 3IA Côte d’Azur. Enfin, elle a dédié une feuille de route à la cybersécurité et souhaite se positionner sur le quantique et la 5G industrielle. L’ensemble de ces filières et technologies-clés est appuyé par le Pôle Solutions Communicantes Sécurisées. Consciente du caractère indispensable du numérique pour la résilience et la compétitivité de ses filières économiques, la Région Sud soutient le développement d’une offre territoriale d’accompagnement à la transformation digitale en lien avec les stratégies européennes et nationales (France 2030) sur les stratégies d’accélération Cybersécurité, Technologies quantiques, Intelligence artificielle, 5G et futures technologies de réseaux de télécommunications et verdissement du numérique.
Entre 2021 et 2026, l’OIR (opération d’intérêt national) Smart tech a priorisé son développement sur la cybersécurité avec l’appui d’une feuille de route transversale dédiée et la consolidation de 3 écosystèmes territoriaux et d’expertise complémentaires : le Pôle IA azuréen, le pôle toulonnais autour de la défense et du maritime et le pôle IoT (Internet
des Objets) / communications sécurisées autour d’Aix-Marseille. Douze projets ont fait l’objet d’une accélération par le plateau OIR et 10 ont été présentés en Comité d’ingénierie financière. Parmi les succès, on peut citer la Plateforme, L’épopée, Théodora ou encore le tiers-lieu « Le 15 » à Marseille. Plusieurs projets ont été
accompagnés au croisement de la tech et d’autres filières stratégiques : Agridata (agriculture 4.0), Solarcamp (mobilité intelligente et durable), PUMA (gestion des risques) et Comptoir (renforcement des collaborations entre grands donneurs d’ordre et acteurs de l’innovation numérique). En outre, le dispositif « Parcours Sud
22 Avril 2023
© Rfma23
L’École polytechnique universitaire de l’université de Nice (Polytech Nice-Sophia), membre du campus SophiaTech / The University Polytechnic School of the University of Nice (Polytech Nice-Sophia), member of the SophiaTech campus.
Smart Territoires » porté par la Région a aidé les intercommunalités à tirer parti des solutions numériques pour délivrer à leurs usagers des services innovants répondant aux enjeux de développement économique durable. Enfin, les filières du numérique ont pu compter sur l’appui du Pôle Solutions Communicantes Sécurisées qui rassemble 300 entreprises et laboratoires de recherche travaillant sur les thématiques-clés telles que la microélectronique, la sécurité numérique, l’intelligence artificielle et les données massives ainsi que l’IoT.
Priorité à l’IA, la cybersécurité et la microélectronique
D’ici 2028 les acteurs de la filière smart tech ambitionnent de conforter le leadership numérique régional autour de technologies-clés et résilientes, en priorité sur l’IA, la cybersécurité et la microélectronique, en accélérant la montée en compétences des acteurs et le déploiement d’une offre régionale différenciante par l’intégration de ces technologies, le déploiement de démonstrateurs et de « smart territoires » et le développement de « tech champions ». Quatre axes prioritaires d’action et d’investissement ont été définis à cette fin.
Premier axe : positionner la région Sud comme leader sur les technologies-clés de l’IA, de la cybersécurité et de la microélectronique et consolider son positionnement sur les filières en émergence de la 5G et du quantique (« Computer Security Incident Response Team » (CSIRT), projet de campus cyber, projet Innov’Micro (Campus des métiers et qualifications Industrie du futur), développement d’une « Electronic Valley » autour du cœur historique de Rousset, développement des usages industriels de la 5G via des démonstrateurs).
Deuxième axe : accélérer la montée en compétences pour amplifier la transition numérique (développement de l’offre de formation « socle » avec des projets tels que l’Epopée, la Plateforme ou encore Théodora, déploiement d’une offre de formations de pointe via le 3IA Côte d’Azur, développement de formations sur le sujet du quantique, renforcement des collaborations entre les acteurs académiques et le monde entrepreneurial, accompagnement de la transformation digitale des entreprises par la formation et la mise à disposition de ressources - Coach digital, Parcours Sud Industrie 4.0, PRACCIIS, projet de eDIH régional « Move2Digital »).
Troisième axe : faire de la région Sud un territoire pilote dans le déploiement de cas d’usages innovants en renforçant les liens entre acteurs publics et privés (promotion de l’open innovation avec la plateforme « Sud Place », Data Sud et les initiatives du Pôle SCS et du cluster SAFE, accélération et développement de projets « smart cities / smart territoires » avec le Parcours Sud Smart Territoires et les appels à projets de France 2030, expérimentations et démonstrateurs favorisant les collaborations territoires / entreprises, développement de tiers-lieux d’innovation ou industriels au service du développement des filières stratégiques).
Quatrième axe : renforcer l’attractivité de la région en matière numérique en favorisant les modèles écoresponsables (priorité donnée à l’écosystème industriel de la microélectronique pour renforcer l’attractivité de la région Sud comme terre du numérique et des technologies-clés, action sur le foncier économique stratégique pour l’industrie, développement des approches numériques écoresponsables, transition vers la sobriété numérique de type « low tech » et « tech for good »).
Autant de défis à relever pour les acteurs régionaux au service de la filière : les pôles SCS et Optitec, le cluster SAFE, Telecom Valley (l’animateur azuréen du numérique), Medinsoft (Digital transformation cluster) et bien sûr les quatre territoires labellisés French Tech, à savoir Toulon Région Sud, Grande Provence Région Sud, Côte d’Azur et Aix-Marseille. Ils sont soutenus par les acteurs de l’enseignement supérieur, de la recherche et de l’innovation mais aussi les acteurs institutionnels et d’appui à la filière1 Avec de belles synergies en perspective.
IA hybride et acteurs du numérique en Occitanie Associer de façon intégrée des techniques d’apprentissage automatique à partir de données et des modèles permettant d’exprimer des contraintes et d’effectuer des raisonnements logiques : c’est l’apanage de l’IA hybride. C’est aussi l’angle retenu par le 3IA ANITI : porté par l’Université de Toulouse dans le cadre du programme d’investissements d’avenir PIA3, il cible deux secteurs d’application stratégiques : la mobilité et les transports et la robotique / cobotique pour l’industrie du futur. Pour ce faire, ANITI s’appuie sur plus de 200 chercheurs, 3 programmes
intégratifs, 24 chaires scientifiques, une graduate school, plus de 50 partenaires et un lieu dédié : B612. Son budget de 80 M€ (contributions académiques, industrielles et PIA3) incluent 24 M€ de la Région Occitanie et 4 M€ de Toulouse Métropole.
Le projet scientifique d’ANITI s’articule autour de trois grands programmes de recherche : IA acceptable, IA certifiable et IA collaborative. Le programme « IA acceptable » englobe les enjeux suivants : IA et société, apprentissage avec peu de données ou des données complexes, fair learning et explicabilité. Développement sûr et embarquabilité, explicabilité, fair learning, IA et modèles physiques, optimisation et théorie des jeux pour l’IA, raisonnement automatique et décision sont au menu du programme « IA certifiable ». Enfin, le programme « IA collaborative » aborde le raisonnement automatique et la décision, les données et les anomalies, le langage, la robotique & l’IA, les neurosciences et l’IA.
Chaque programme de recherche réunit plusieurs chaires : AI for physical models with geometric tools (Fabrice Gamboa), Augmented society (Cesar A.Hidalgo), Empowering Data-driven AI by Argumentation and Persuasion (Leïla Amgoud), Fair & Robust Learning (Jean-Michel Loubès), Fusion-based inference from heterogeneous data (Nicolas Dobigeon), Law, Accountability and Social Trust in AI (Céline Castets-Renard), Moral AI (Jean-François Bonnefon) et The effects of AI on competition in the marketplace (Bruno Jullien) pour « IA acceptable ». AI for air traffic management and large scale urban mobility (Daniel Delahaye), Data Assimilation and Machine Learning (Serge Gratton), Deep learner explanation & verification (Joao Marquès Silva), Fair & Robust Learning (Jean-Michel Loubès), Game Theory and Artificial Intelligence (Jérôme Renault), Large Scale Optimization for AI (Jérôme Bolte), CertifAI – Towards the certification of ML-based systems (Claire Pagetti) et Polynomial Optimization for Machine Learning and data analysis (Jean-Bernard Lasserre) pour “IA certifiable”. Quant au programme « IA collaborative », il regroupe les chaires Reverse-engineering the visual system (Thomas Serre), Cognitive and interactive robotics (Rachid Alami), Deep Learning with semantic, cognitive and biological constraints (Rufin van Rullen), Design
23 April 2023
using intuition and logic (Thomas Schiex), Knowledge compilation, uncertainty, preferences (Hélène Fargier), Artificial and Natural movement (Nicolas Mansard), Neuroadaptive technology for Human Machine Teaming (Fréderic Dehais) et Synergistic transformations in model based and data based diagnosis (Louise Travé-Massuyes). Concrètement, les chaires scientifiques accueillent des projets de recherche qui contribuent à des thèmes directement issus des cas d’usage amenés par les industriels.
Montée en compétences et développement en réseau
ANITI permet à ses partenaires industriels l’acquisition accélérée de compétences en IA grâce à plusieurs leviers : la participation aux co-encadrements de thèses (CIFRE par exemple) ou de post-doc, la mise à disposition de données ou de cas d’usages qui serviront de support pour valider des résultats issus des travaux d’ANITI ou de benchmarks pour comparer des algorithmes existants, le doublement d’étudiants formés en IA au travers d’une filière d’excellence qui permettra aux membres de recruter les meilleures compétences, le programme de formation continue, les séminaires scientifiques et le programme de diffusion scientifique et technique. Outre les apports des partenaires industriels, le programme

ANITI dans ses 3 volets (recherche, formation et développement économique) est soutenu financièrement par le PIA géré par l’Agence Nationale de la Recherche, les établissements de recherche, la Région Occitanie, Toulouse Métropole ainsi que Toulouse Tech Transfert.





De plus, ANITI se développe en lien avec d’autres acteurs économiques, institutionnels ou académiques impliqués dans l’IA : les membres d’ANITI et leur propre réseau bien sûr, les autres 3IA et les partenaires internationaux, le réseau CLAIRE (Confederation of Laboratories for Artificial Intelligence Research in Europe), les acteurs institutionnels (Région, Toulouse Métropole, BPIfrance), les acteurs du transfert de technologie comme Toulouse Tech Transfer, les clusters ou associations numériques dont Aerospace Valley, Digital113 et Occitanie
Data, les structures d’accompagnement aux petites entreprises dont Ad’OCC, At’home ou encore Nubbo ainsi que des acteurs impliqués spécifiquement en IA tels que Toulouse Is AI ou Toulouse Data Science.
Des attentes opérationnelles, stratégiques et citoyennes
Ce riche écosystème est complété par le Club des Partenaires qui regroupe les membres industriels d’ANITI. Il porte une double ambition : tenir informés les partenaires sur la vie de l’institut et être un lieu d’échange. Dans cette optique, il rassemble les attentes opérationnelles ou plus stratégiques des partenaires industriels et les fait remonter à ANITI, informe les partenaires de ce qui se passe dans ANITI (orientations, vie opérationnelle et résultats), se fait l’écho des retours d’expériences, des visions sur la filière et de la maturation en amont des partenaires industriels.
Au travers de ses différentes activités, le 3IA ANITI montre bien la complexité des enjeux liés à l’IA. Expliquer ses usages, rappeler quels sont ses socles (mathématiques et informatique), s’appuyer sur le droit pour servir de garde-fou et emporter l’adhésion du grand public : autant de défis reflétés par la grande enquête publique sur l’IA lancée en octobre 2022 par ANITI et Ekitia avec le soutien de la Région Occitanie et de l’Académie de Toulouse. Cette consultation citoyenne sur les connaissances, l’acceptabilité et les enjeux éthiques autour des technologies émergentes reliées au big data et à l’IA est ouverte à tous. L’occasion de répondre aux trois catégories de questions posées : comment vivre avec ? Comment en faire le meilleur allié de l’humain ? Comment éviter les dérives ? Cette consultation a une triple utilité : faire un état des lieux des connaissances et des opinions du plus grand nombre sur l’IA ; définir des actions de sensibilisation pertinentes par rapport aux besoins et aux attentes des citoyens ; accompagner les décideurs économiques et politiques pour mettre l’IA au service des citoyens2. Une belle opportunité de rassembler scientifiques, citoyens et décideurs politiques pour s’assurer que l’IA est et restera au service de l’humain. Et non l’inverse.
ISART Digital : une Game Business School au cœur de la ville de Nice
À la pointe de l’innovation, ISART a choisi la métropole niçoise pour son écosystème favorable au développement économique. Labellisée « Capitale French Tech », Nice peut se prévaloir d’un secteur numérique dynamique (start-up, grands groupes, entreprises technologiques) et d’un cadre exceptionnel au cœur de l’Eco-Vallée. ISART prépare ainsi l’ouverture, en 2025, d’un nouveau campus éco-responsable comprenant un incubateur d’entreprises et une résidence étudiante. À la rentrée 2023, les étudiants feront leur rentrée dans des locaux Premium avec pour voisin l’incubateur CEEI qui accompagne les entreprises innovantes du territoire.

ISART entend contribuer au dynamisme Business, Créatif & Tech de l’arc méditerranéen. L’école compte aussi consolider ses liens avec l’UCA (Université Côte d’Azur) pour développer les interactions sur l’enseignement et la recherche. Elle s’appuie en outre sur le soutien de la Métropole de Nice Côte d’Azur qui a œuvré avec enthousiasme pour son implantation sur son territoire. ISART propose un BBA Game & Creative Management (admission bac) et un MSc Game & Creative Strategy (admission bac+3) qui combinent créativité et business. Au programme : les fondamentaux du marketing dans le contexte du jeu vidéo, la création d’entreprise et les modèles économiques des jeux vidéo et applications, l’exploitation des données des joueurs et utilisateurs en ligne pour augmenter leur rétention et consommation in app des jeux vidéo ou produits digitaux3. Gare à l’addiction !


1 Source : Région Sud PACA.
2 Source : 3IA ANITI.
3 Source : ISART Digital.
24 Avril 2023
Artificial intelligence and digital technologies: smart techs are on a roll
Big data and computing power, cybersecurity, microelectronics, 5G, quantum technologies and even video games: there is no shortage of applications for artificial intelligence and digital technologies. The players in the South and Occitania regions are brilliantly deploying this multi-faceted expertise.
Located in the top 3 regions for « digital » with nearly 2,200 private establishments (Orange, NXP, Schneider, STMicroelectronics, IBM, Infineon, etc.) and more than 70,000 jobs, the South region has 4 territories labelled French Tech and the SophiaTech campus is a world reference. Research is also rich with the strong presence of Inria. The South region makes a difference in the microelectronics sector with strong applications in smart cities, precision agriculture, health, smart grids, industry 4.0, autonomous vehicles, e-tourism, the silver economy, etc.
As the leading region in France in terms of the volume of electronic components produced, the South of France is also positioned in the field of connected objects and is a European leader in the field of AI, thanks to the 3IA Côte d’Azur. Finally, it has dedicated a roadmap to cybersecurity and wishes to position itself on quantum technologies and industrial 5G. All of these sectors and key technologies are supported by the Secured Communicating Solutions cluster (Pole SCS). Aware of the indispensable nature of digital technology for the resilience and competitiveness of its economic sectors, the South Region supports the development of a territorial offer of support for digital transformation in line with European and national strategies (France 2030) on the acceleration strategies of Cybersecurity, Quantum Technologies, Artificial Intelligence, 5G and future telecommunication network technologies and the greening of digital technology.


Between 2021 and 2026, the Smart tech OIR (operation of national interest) has prioritised its development on cybersecurity
with the support of a dedicated transversal roadmap and the consolidation of 3 complementary territorial ecosystems and expertise: the Côte d’Azur AI cluster, the Toulon cluster around defence and maritime and the IoT (Internet of Things) / secure communications cluster around Aix-Marseille. Twelve projects were accelerated by the OIR platform and 10 were presented to the Financial Engineering Committee. Among the successes, we can mention the Platform, L’épopée, Théodora and the third place «Le 15» in Marseille. Several projects were supported at the crossroads of tech and other strategic sectors: Agridata (agriculture 4.0), Solarcamp (intelligent and sustainable mobility), PUMA (risk management) and Comptoir (strengthening of collaborations between major principals and digital innovation players). In addition, the
«Parcours Sud Smart Territoires» scheme supported by the Region has helped intercommunities to take advantage of digital solutions to provide their users with innovative services that meet the challenges of sustainable economic development. Finally, the digital sectors have been able to count on the support of the Pole SCS, which brings together 300 companies and research laboratories working on key themes such as microelectronics, digital security, artificial intelligence and massive data as well as IoT.
Priority to AI, cybersecurity and microelectronics
Between now and 2028, the players in the smart tech sector aim to consolidate the region’s digital leadership around key and resilient technologies, with priority given to AI, cybersecurity and microelectronics,
25 April 2023
©
Diagram showing the positioning of the concepts of AI, machine learning and deep learning intertwined / Schéma montrant le positionnement des notions d’IA, machine learning et deep learning imbriquées les unes aux autres
Bouliech
by accelerating the rise in skills of the players and the deployment of a differentiating regional offer through the integration of these technologies, the deployment of demonstrators and «smart territories» and the development of «tech champions». Four priority areas of action and investment have been defined for this purpose.
First axis: position the South region as a leader in the key technologies of AI, cybersecurity and microelectronics and consolidate its position in the emerging fields of 5G and quantum («Computer Security Incident Response Team» (CSIRT), cyber campus project, Innov’Micro project (Campus of trades and qualifications Industry of the Future), development of an «Electronic Valley» around the historic heart of Rousset, development of industrial uses of 5G via demonstrators).
Second axis: accelerate the rise in skills to amplify the digital transition (development of the «core» training offer with projects such as Epopée, the Platform or Théodora, deployment of a cutting-edge training offer via the 3IA Côte d’Azur, development of training on the subject of quantum technology, reinforcement of collaborations between academic actors and the entrepreneurial world, support for the digital transformation of companies through training and the provision of resources - Digital Coach, Parcours Sud Industrie 4. 0 course, PRACCIIS, regional eDIH project «Move2Digital»).
Third axis: to make the South region a pilot territory in the deployment of innovative uses by strengthening the links between public and private actors (promotion of open innovation with the «Sud Place» platform, Data Sud and the initiatives of the Pole SCS and the SAFE cluster, acceleration and development of «smart cities / smart territories» projects with the Parcours Sud Smart Territoires and the France 2030 calls for projects, experiments and demonstrators favouring collaboration between territories and companies, development of third-party innovation or industrial places to support the development of strategic sectors).
Fourth axis: reinforce the attractiveness of the region in terms of digital technology by promoting eco-responsible models (priority given to the microelectronics industrial ecosystem to reinforce the attractiveness of the South region as a land of digital
technology and key technologies, action on strategic economic land for industry, development of eco-responsible digital approaches, transition towards digital sobriety of the «low tech» and «tech for good» type).
These are just some of the challenges facing regional players in the sector: the SCS and Optitec clusters, the SAFE cluster, Telecom Valley (the Côte d’Azur’s leading digital cluster), Medinsoft (Digital Transformation Cluster) and, of course, the four territories that have been awarded the French Tech label, namely Toulon Région Sud, Grande Provence Région Sud, Côte d’Azur and Aix-Marseille. They are supported by the actors of higher education, research and innovation but also the institutional actors and those in support to the sector. With great synergies in prospect.
Hybrid AI and digital actors in Occitania
Combining in an integrated way machine learning techniques from data and models allowing constraints to be expressed and logical reasoning to be carried out: this is the prerogative of hybrid AI. This is also the angle chosen by the 3IA ANITI: supported by the University of Toulouse within the framework of the PIA3 future investment programme, it targets two strategic application sectors: mobility and transport and robotics / cobotics for the industry of the future. To achieve this, ANITI relies on more than 200 researchers, 3 integrative programmes, 24 scientific chairs, a graduate school, more than 50 partners and a dedicated location: B612. Its €80M budget (academic, industrial and PIA3 contributions) includes €24M from the Occitanie Region and €4M from Toulouse Métropole.
ANITI’s scientific project is articulated around three major research programmes: acceptable AI, certifiable AI and collaborative
AI. The «Acceptable AI» programme encompasses the following issues: AI and society, learning with little or complex data, fair learning and explainability. Safe development and embeddability, explainability, fair learning, AI and physical models, optimisation and game theory for AI, automatic reasoning and decision making are on the menu of the ‘Certifiable AI’ programme. Finally, the ‘Collaborative AI’ programme addresses automatic reasoning and decision, data and anomalies, language, robotics & AI, neuroscience & AI.
Each research programme brings together several chairs: AI for physical models with geometric tools (Fabrice Gamboa), Augmented society (Cesar A. Hidalgo), Empowering Data-driven AI by Argumentation and Persuasion (Leïla Amgoud), Fair & Robust Learning (Jean-Michel Loubès), Fusion-based inference from heterogeneous data (Nicolas Dobigeon), Law, Accountability and Social Trust in AI (Céline Castets-Renard), Moral AI (Jean-François Bonnefon), and The effects of AI on competition in the marketplace (Bruno Jullien) for ‘Acceptable AI’. AI for air traffic management and large scale urban mobility (Daniel Delahaye), Data Assimilation and Machine Learning (Serge Gratton), Deep learner explanation & verification (Joao Marquès Silva), Fair & Robust Learning (Jean-Michel Loubès), Game Theory and Artificial Intelligence (Jérôme Renault), Large Scale Optimization for AI (Jérôme Bolte), CertifAI - Towards the certification of ML-based systems (Claire Pagetti) and Polynomial Optimization for Machine Learning and data analysis (Jean-Bernard Lasserre) for «Certifiable AI». As for the «AI collaborative» programme, it includes Reverse-engineering the visual system (Thomas Serre), Cognitive and interactive robotics (Rachid Alami), Deep Learning with semantic, cognitive and biological constraints (Rufin van Rullen), Design using

26 Avril 2023
Different aspects of the Internet of Things / Différents aspects de l’Internet des objets © Martin Bodin
intuition and logic (Thomas Schiex), Knowledge compilation, uncertainty, preferences (Hélène Fargier), Artificial and Natural movement (Nicolas Mansard), Neuroadaptive technology for Human Machine Teaming (Fréderic Dehais) and Synergistic transformations in model based and data based diagnosis (Louise Travé-Massuyes). In concrete terms, the Scientific Chairs host research projects that contribute to themes directly resulting from use cases submitted by industry.
Skill building and network development

ANITI enables its industrial partners to acquire AI skills at an accelerated pace thanks to several levers: participation in the co-supervision of theses (CIFRE for example) or post-docs, the provision of data or use cases which will be used to validate results from ANITI’s work or benchmarks to compare existing algorithms, the doubling of students trained in AI through a pathway of excellence which will enable members to recruit the best skills, the continuing education programme, scientific seminars and the scientific and technical dissemination programme. In addition to the contributions of the industrial partners, the ANITI programme in its 3 components (research, training and economic development) is financially supported by the PIA managed by the Agence Nationale de la Recherche, research establishments, the Occitanie Region, Toulouse Métropole and Toulouse Tech Transfert.

In addition, ANITI is developing in conjunction with other economic, institutional or academic actors involved in AI: ANITI members and their own network of course, other 3IA and international partners, the CLAIRE network (Confederation of Laboratories for Artificial Intelligence Research in Europe), institutional players (Region, Toulouse Métropole, BPIfrance), technology transfer players such as Toulouse Tech Transfer, digital clusters or associations such as Aerospace Valley, Digital113 and Occitanie Data, support structures for small


businesses such as Ad’OCC, At’home or Nubbo, as well as players specifically involved in AI such as Toulouse Is AI or Toulouse Data Science.



Operational, strategic and citizen expectations
This rich ecosystem is completed by the Partners’ Club which brings together ANITI’s industrial members. It has a double ambition: to keep the partners informed about the life of the institute and to be a place for exchange. To this end, it gathers the operational or more strategic expectations of the industrial partners and brings them to ANITI, informs the partners of what is happening in ANITI (orientations, operational life and results), and echoes the feedback, visions on the sector and the upstream maturation of the industrial partners.

Through its various activities, the 3IA ANITI clearly shows the complexity of the issues related to AI. Explaining its uses, recalling its foundations (mathematics and computer science), relying on the law to serve as a safeguard and win the support of the general public: these are all challenges reflected in the major public survey on AI launched in October 2022 by ANITI and Ekitia with the support of the Occitanie Region and the Toulouse Academy. This citizen consultation on knowledge, acceptability and ethical issues around emerging technologies related to big data and AI is open to all. It is an opportunity to answer the three categories of questions asked: How to live with it? How to make it the best ally of humans? How can we avoid abuses? This consultation has a triple purpose: to take stock of the knowledge and opinions of the largest number of people on AI; to define awareness-raising actions relevant to the needs and expectations of citizens; to support economic and political decision-makers in putting AI at the service of citizens. A great opportunity to bring together scientists, citizens and policy makers to ensure that AI is and will remain at the service of humans. And not the other way around.
ISART Digital: a Game Business School in the heart of Nice

At the cutting edge of innovation, ISART chose the city of Nice for its ecosystem that favours economic development. Labelled «French Tech Capital», Nice can boast a dynamic digital sector (start-ups, large groups, technological companies) and an exceptional setting in the heart of the Eco-Valley. ISART is thus preparing for the opening, in 2025, of a new eco-responsible campus including a business incubator and a student residence. At the start of the 2023 academic year, students will start their studies in Premium premises with the CEEI incubator, which supports innovative companies in the region, as a neighbour.
ISART intends to contribute to the Business, Creative & Tech dynamism of the Mediterranean arc. The school also intends to consolidate its links with the UCA (Université Côte d’Azur) in order to develop interactions on teaching and research. It also relies on the support of the Nice Côte d’Azur Metropolis, which has worked enthusiastically to establish the school on its territory. ISART offers a BBA Game & Creative Management (baccalaureate admission) and an MSc Game & Creative Strategy (baccalaureate+3 admission) which combine creativity and business. The programme includes the fundamentals of marketing in the context of video games, business creation and economic models for video games and applications, and the use of player and online user data to increase retention and in-app consumption of video games or digital products. Beware of addiction!
27 April 2023
L’IA hybride au service de la mobilité et de la robotique
Un entretien avec M. Nicolas VIALLET, Directeur opérationnel du 3IA ANITI Et M. Nicholas ASHER, Directeur scientifique du 3IA ANITI


Quels sont les chiffres-clés du 3IA ANITI ?
Nicolas Viallet (N.V.). ANITI s’appuie sur près de 110 chercheurs, 90 thésards et post-doctorants, une trentaine d’ingénieurs mis à disposition par nos 30 partenaires industriels et une vingtaine de partenaires académiques. Depuis son lancement en 2019 il a produit quelque 650 publications scientifiques dont un tiers dans des journaux de très haut niveau. De plus, 4 000 étudiants ont suivi des formations en intelligence artificielle (IA) labellisées par nos soins en 2021 (soit le double du chiffre de 2018) et plus de 100 entreprises ont participé à nos différents événements dédiés en 2022.
Nicholas Asher (N.A.). Au-delà des chiffres, ANITI a permis de traverser les barrières entre les disciplines : mathématiques et informatique, modèles physiques complexes et IA, neurosciences et IA…
Pourriez-vous nous présenter les secteurs stratégiques d’application, les programmes intégratifs et les chaires scientifiques d’ANITI ?
N.A. Parmi les secteurs stratégiques d’application étudiés dans les 3IA, ANITI s’est concentré sur deux : la mobilité intelligente et l’industrie 4.0. Ces secteurs se nourrissent de recherches fondamentales sur l’explicabilité, la robustesse vis-à-vis des perturbations dans les données, la gestion des biais des données et l’efficacité du raisonnement inductif dans les systèmes d’IA pour optimiser leurs nombreux paramètres et les rendre plus performants. La mobilité intelligente exige aussi des recherches sur les problèmes de certification de l’IA dans les systèmes critiques. Mais ANITI a des chaires dont les recherches concernent d’autres secteurs stratégiques. Par exemple, une chaire scientifique est dédiée à la télédétection, un sujet d’intérêt majeur pour l’industrie spatiale mais aussi pour le climat, l’agriculture et l’agronomie. En parallèle, ANITI a 3 programmes intégratifs qui portent sur l’IA acceptable (pour la société et les citoyens), l’IA certifiable et l’IA collaborative.
N.V. Ces 3 programmes se veulent complémentaires. Le premier vise à étudier les conséquences sociétales de l’utilisation de
l’IA, le second traite de l’implémentation de l’IA dans les produits ou services critiques (avion, voiture, hôpital…), enfin le troisième est dédié à l’usage de l’IA pour optimiser les processus collaboratifs homme / machine.
N.A. La recherche fondamentale sur les outils d’optimisation mathématique et la recherche appliquée sur les modèles analytiques se nourrissent mutuellement. L’IA hybride permet d’injecter des connaissances mathématiques ou physiques dans ces modèles afin de les rendre plus « sages ». Ces travaux sont essentiels pour l’IA certifiable et contribuent à l’élaboration de directives par la European Aviation Safety Agency. Enfin, l’IA collaborative porte sur les interactions entre humains et robots avec des travaux sur la science du mouvement, la linguistique, le traitement automatique des langues et la vision par ordinateur ou inspirée des neurosciences. Une chaire scientifique est dédiée au design de nouvelles molécules à partir de molécules de déchets plastiques réduites à leurs composantes primaires. L’optimisation des processus par l’IA s’applique aussi à la planification des systèmes industriels complexes afin de leur permettre de s’adapter aux aléas, de détecter d’éventuelles anomalies…
Quels partenariats avez-vous développés ?
N.A. ANITI s’implique dans le partenariat européen COALA qui utilise l’IA pour améliorer les processus de construction en usine grâce à la détection et la prédiction explicable d’anomalies. Une PoC a été atteinte dans ce cadre. Deux autres projets, COCOBOT porte sur le développement d’un cobot (robot conversationnel) tandis que COCOPIL vise la conception d’un modèle multimodal pour
un robot assistant dans un contexte industriel ou commercial (un partenariat avec la PME Linagora et Airbus).
N.V. Ce dernier projet illustre parfaitement ce que nous souhaitons développer au sein d’ANITI, une grande force interdisciplinaire mais aussi une capacité à faire travailler ensemble des industriels de tailles et de secteurs différents. J’aimerais également citer le projet DEEL (DEpendable and Explainable Learning) qui rassemble des acteurs français et québécois de l’aéronautique et de la mobilité qui partagent les mêmes enjeux de certification de systèmes critiques intégrant de l’IA.
Quels sont selon vous les défis à relever pour faire progresser l’IA hybride ?
N.A. Le premier défi, technologique, est de créer une IA hybride plus frugale, plus économe en données, plus explicable et plus robuste qui bénéficiera de l’application de l’IA dans divers domaines et dans nos secteurs stratégiques applicatifs.
N.V. La formation est un autre enjeu majeur pour permettre aux entreprises de se saisir des avancées d’ANITI et de les transformer en solutions réelles et concrètes. Ce défi humain et organisationnel est au cœur du volet formation de la phase 2 de la stratégie nationale pour l’IA. C’est dans ce cadre que les 4 3IAs français ont lancé l’initiative EFELIA qui va permettre de massifier la formation en IA en mettant en commun notamment nos ressources pédagogiques et méthodologiques.
N.A. Au-delà de sa dimension symbolique première, l’IA hybride intègre des connaissances dans diverses sciences (y compris les SHS) ainsi que du machine learning et deep learning. C’est un défi et un atout pour la formation des futurs ingénieurs et des industriels qui les recruteront. Notre master en informatique et mathématiques y contribue déjà.
N.V. Cette approche hybride se distingue des approches tout machine learning et correspond bien aux problématiques concrètes posées aux acteurs des secteurs applicatifs auxquels la stratégie nationale s’adresse. En ce sens elle peut contribuer à relever le défi de la souveraineté économique nationale.
28 Avril 2023
M. Nicholas Asher
M. Nicolas Viallet
©Université de Toulouse Artigas Films © D.R.
Hybrid AI for mobility and robotics
What
are the key figures of 3IA ANITI?
Nicolas Viallet (N.V.). ANITI relies on nearly 110 researchers, 90 PhD students and post-doctoral fellows, around 30 engineers made available by our 30 industrial partners and around 20 academic partners. Since its launch in 2019, it has produced some 650 scientific publications, a third of which are in very high-level journals. In addition, 4,000 students have followed training courses in artificial intelligence (AI) labelled by us in 2021 (i.e. double the figure for 2018) and more than 100 companies have participated in our various dedicated events in 2022.
Nicholas Asher (N.A.). Beyond the numbers, ANITI has helped cross the barriers between disciplines: mathematics and computer science, complex physical models and AI, neuroscience and AI...

Could you present the strategic application sectors, the integrative programmes and the scientific chairs of ANITI?
N.A. Among the strategic application sectors studied in the 3IAs, ANITI has focused on two: smart mobility and industry 4.0. These areas are fuelled by fundamental research on explainability, robustness to perturbations in the data, management of data biases and the effectiveness of inductive reasoning in AI systems to optimise their many parameters and make them more efficient. Smart mobility also requires research on certification issues of AI in critical systems. But ANITI has chairs whose research concerns other strategic sectors. For example, a scientific chair is dedicated to remote sensing, a subject of major interest for the space industry but also for climate, agriculture and agronomy. In parallel, ANITI has 3 integrative programmes which focus on acceptable AI (for society and citizens), certifiable AI and collaborative AI.
N.V. These 3 programmes are intended to be complementary. The first one aims at studying the societal consequences of the use of AI, the second one deals with the implementation of AI in critical products or services (aeroplane, car, hospital...), and the third one is dedicated
to the use of AI to optimize man/machine collaborative processes.
N.A. Fundamental research on mathematical optimisation tools and applied research on analytical models feed each other. Hybrid AI allows mathematical or physical knowledge to be injected into these models to make them wiser. This work is essential for certifiable AI and contributes to the development of guidelines by the European Aviation Safety Agency. Finally, collaborative AI focuses on human-robot interactions with work on motion science, linguistics, automatic language processing and computer or neuroscience-inspired vision. A scientific chair is dedicated to the design of new molecules from plastic waste molecules reduced to their primary components. The optimisation of processes by AI also applies to the planning of complex industrial systems to enable them to adapt to hazards, to detect possible anomalies, etc.
What partnerships have you developed?
N.A. ANITI is involved in the European partnership COALA which uses AI to improve factory construction processes through the detection and prediction of anomalies. A PoC has been achieved in this framework. Two other projects, COCOBOT focuses on the development of a cobot (conversational robot) while COCOPIL aims to design a multimodal model for an assistant robot in an industrial or commercial context (a partnership with the SME Linagora and Airbus).
N.V. This last project perfectly illustrates what we wish to develop within ANITI, a great interdisciplinary strength but also a capacity to make industrialists of different sizes and sectors work together. I would also like to mention the DEEL (DEpendable and Explainable Learning) project which brings together French and Quebec players in the aeronautics and mobility sectors who share the same challenges of certification of critical systems integrating AI.
In your opinion, what are the challenges to be met in order to advance hybrid AI?
N.A. The first, technological challenge is to create a hybrid AI that is more frugal, more data-efficient, more explainable and more robust, which will benefit from the application of AI in various fields and in our strategic application sectors.
N.V. Training is another major challenge to enable companies to grasp ANITI’s advances and transform them into real and concrete solutions. This human and organisational challenge is at the heart of the training component of phase 2 of the national strategy for AI. It is in this context that the 4 French 3IAs have launched the EFELIA initiative, which will enable the massification of AI training by pooling our pedagogical and methodological resources.
N.A. Beyond its primary symbolic dimension, hybrid AI integrates knowledge from various sciences (including humanities and social sciences) as well as machine learning and deep learning. This is a challenge and an asset for the training of future engineers and the industrialists who will recruit them. Our master’s degree in computer science and mathematics is already contributing to this.
N.V. This hybrid approach differs from all-machine learning approaches and corresponds well to the concrete problems faced by players in the application sectors to which the national strategy is addressed. In this sense, it can contribute to meeting the challenge of national economic sovereignty.
29 April 2023
© 3IA ANITI
An interview with Mr. Nicolas VIALLET, Operational Director of 3IA ANITI And Mr. Nicholas ASHER, Scientific Director of 3IA ANITI
Inauguration evening for ANITI’s new premises in June 2022 / Soirée d’inauguration des nouveaux locaux d’ANITI en juin 2022
NXP Semiconductors
Des solutions de connectivité sécurisée pour un monde plus intelligent, plus sûr et plus durable
Avec plus de 26 000 clients dans le monde, une présence dans plus de 30 pays, 300 employés de 30 nationalités différentes pour le seul site de Sophia Antipolis et 9 500 familles de brevets, NXP Semiconductors offre des solutions de connectivité sécurisées pour les marchés industriels, automobile et IoT.
Faire communiquer des machines entre elles, garantir la sûreté de fonctionnement des systèmes et la sécurité des connexions : c’est le quotidien de NXP Semiconductors. Son credo : innovation, exécution et collaboration. À Sophia Antipolis, l’innovation est portée par les 97 % d’ingénieurs R&D. Le site est spécialisé dans le design hardware et software des processeurs multiapplications et multimarchés auxquels il ajoute des couches logicielles pour une intégration aisée dans divers systèmes. Après le PC et le smartphone, l’IoT est le nouvel horizon technologique. L’enjeu : fournir des composants connectés et sécurisés pour protéger les applications des clients.


Les solutions de NXP se divisent en 4 grandes catégories. Sense : capteurs d’accélération, de pression, gyroscopes et autres qui moissonnent les données. Think : prendre les bonnes décisions à partir desdites données. Connect : relier les objets par divers protocoles et moyens de connexion sécurisée tels que l’ultra-wideband. Act : agir sur l’environnement avec des interfaces physiques et des outils de power management, de contrôle ou de monitoring tels que la recharge de batteries pour véhicules électriques.
NXP Sophia fournit les outils pour assurer l’intégrité de l’image logicielle sur les processeurs afin d’éviter tout risque de
piratage. Au monde « normal », lieu de fonctionnement des applications, s’ajoute un monde « sécurisé » où sont encapsulées les données et des applications critiques. Les ingénieurs R&D collaborent même avec des spécialistes de la sécurité pour le compte du gouvernement américain (NIST) en vue de développer des algorithmes de cryptographie encore plus robustes, à même de résister aux éventuelles attaques par des processeurs quantiques.
Le site est aussi investi dans l’écosystème local à travers diverses collaborations avec les laboratoires de recherche, les écoles d’ingénieurs et les universités. Par exemple, NXP Sophia collabore avec Inria : une équipe conjointe a accompli la prouesse
d’arriver 4ème d’une compétition mondiale organisée par Google sur la reconnaissance multimodale (faciale et vocale). La collaboration avec Inria inclue aussi des startups comme Ezako, spécialisée dans le nettoyage et la labellisation de données : l’objectif est d’entraîner des modèles d’IA à reconnaître les anomalies de fonctionnement d’objets ou de machines connectés, de sélectionner les modèles atteignant un taux de succès bien supérieur à 95 % et de réduire le nombre de leurs paramètres pour les rendre compatibles avec des applications fonctionnant dans le monde de l’embarqué. La détection des anomalies permet la maintenance prédictive des systèmes : une option précieuse pour éviter, par exemple, qu’une ligne d’assemblage s’arrête par surprise.
Aujourd’hui, NXP Sophia est un acteur majeur de l’écosystème régional de l’innovation aux côtés du pôle de compétitivité SCS, de Sophia Club Entreprises, ainsi que Team Côte d’Azur. Toujours à l’affût de start-ups d’envergure internationale, l’entreprise affiche une ouverture maximale en étroite collaboration avec des sites de NXP Semiconductors aux US, en Inde, Chine, Corée du Sud, au Japon, en Allemagne, aux Pays-Bas, en Europe de l’Est ou encore au Danemark. Elle mise sur sa diversité, sa résilience, son ouverture et sa culture de l’entraide pour attirer les talents et favoriser l’innovation au service de l’avantage compétitif de ses clients.
Publireportage 30 Avril 2023
© NXP Semiconductors
© NXP
Jean-Christophe Bodet, Senior Director, Software R&DIndustrial & IoT, Sophia-Antipolis
Semiconductors
NXP Semiconductors

Secure connectivity solutions for a smarter, safer and more sustainable world

With more than 26,000 customers worldwide, a presence in over 30 countries, 300 employees of 30 different nationalities at the Sophia Antipolis site alone and 9,500 patent families, NXP Semiconductors offers secure connectivity solutions for the industrial, automotive and IoT markets.

NXP Semiconductors’ day-to-day business is to make machines communicate with each other, to guarantee the reliability of systems and the security of connections. Its credo: innovation, execution and collaboration. At Sophia Antipolis, 97% of the site population is R&D engineers, driving innovation. The site specializes in the hardware and software design of multi-application and multi-market processors to which it adds software layers for easy integration into various systems. After the PC and the smartphone, the IoT is the new technological horizon. The challenge is to provide connected and secure components to protect customers’ applications.
NXP’s solutions are divided into 4 main categories. Sense: acceleration, pressure, gyroscopes and other sensors that collect data. Think: making the right decisions based on this data. Connect: linking objects through various protocols and secure connection methods such as ultra-wideband. Act: act on the environment with physical interfaces and power management, control or monitoring tools such as battery charging for electric vehicles.
NXP Sophia provides the tools to ensure the integrity of the software image on the processors to avoid any risk of hacking. In addition to the «normal» world, where applications run, there is a «secure» world where data and critical applications are encapsulated. R&D engineers are even working with security specialists on behalf of the U.S. government (NIST) to develop even more robust cryptographic algorithms that can withstand potential attacks by quantum processors.
The site is also invested in the local ecosystem through various collaborations with research laboratories, engineering schools and universities. For example, NXP Sophia collaborates with Inria: a joint team achieved the feat of coming 4th in a worldwide competition organized by Google on multimodal recognition (facial and vocal). The collaboration with Inria also includes start-ups such as Ezako, which specializes in data cleaning and labeling: the objective is to train AI models to recognize anomalies in the operation of connected objects or machines, to select models that achieve a success rate of well over 95% and to reduce the number of their parameters to make them compatible with applications operating in the embedded world.
Anomaly detection enables predictive maintenance of systems: a valuable option to avoid, for example, an assembly line stopping by surprise.
Today, NXP Sophia is a major player in the regional innovation ecosystem alongside the SCS competitiveness cluster, Sophia Club Entreprises and Team Côte d’Azur. Always on the lookout for international start-ups, the company is very open and works closely with NXP Semiconductors sites in the US, India, China, South Korea, Japan, Germany, the Netherlands, Eastern Europe and Denmark. It leverages its diversity, resilience, openness and culture of mutual support to attract talent and foster innovation for the competitive advantage of its customers.
Publireportage 31 April 2023
© NXP Semiconductors NXP Semiconductors 45, allée des Ormes F-06250 Mougins Tél. : +33 (0)4 92 98 86 15 E-mail : davina.moore@nxp.com https://www.nxp.com © NXP Semiconductors
Pôle Solutions Communicantes Sécurisées
Les technologies numériques au service de la sobriété énergétique
Un entretien avec M. Olivier CHAVRIER, Directeur général du Pôle SCS Solutions Communicantes Sécurisées

Quels sont les chiffres-clés de SCS ?
Basé en région PACA et spécialisé dans les technologies du numérique, SCS rassemble 310 membres dont 72 % de PME et start-up. S’y ajoutent de grands groupes industriels ainsi que des laboratoires de recherche issus d’Inria, du CEA, d’Aix-Marseille Université… Depuis sa création, SCS a accompagné et labellisé plus de 600 projets innovants dont plus de 300 ont été sélectionnés pour un financement cumulé dépassant le milliard d’euros (400 M€ de fonds publics). Nous organisons aussi chaque année une soixantaine d’animations axées sur des technologies ou des marchés-clés. Elles rencontrent d’ailleurs un franc succès avec plus de 2 000 participants chaque année. Nous réalisons aussi chaque année entre 50 et 70 accompagnements individuels de PME et start-up (levée de fonds, internationalisation, mise en relation avec de grands comptes, stratégie marketing…). Rappelons, pour finir, que nous évoluons au sein de la deuxième région de France pour l’activité electronique et que nous fédérons le deuxième écosystème national en termes de semi-conducteurs.
Pourriez-vous nous présenter vos technologies-clés et les marchés auxquels elles s’adressent ?
Nous avons identifié 4 technologies-clés en rapport avec les points forts de notre écosystème : la microélectronique, la cybersécurité, l’intelligence artificielle et l’internet des objets. Ces technologies sont conçues pour répondre aux besoins de 4 marchés jugés particulièrement porteurs, à savoir l’industrie du futur (4.0 et bientôt 5.0), la santé et le bien-être, les villes intelligentes et la mobilité intelligente.

Quel accompagnement proposez-vous à vos membres en matière d’innovation produits et services ? Pourriez-vous nous en donner quelques exemples ? SCS propose un accompagnement pour le montage de projets innovants et l’obtention de financements publics (dispositifs régionaux mais aussi nationaux - France 2030 - et européens - Horizon Europe). Cet accompagnement englobe la réalisation de plans technologiques, de plans financiers et de plans d’affaires pour anticiper la commercialisation de l’innovation. Il a une durée moyenne de 2 mois. Il mobilise une commission d’experts qui auditionne les projets et décide de la labellisation. Cette offre est particulièrement prisée des entreprises et nous nous félicitons de l’excellent taux de financement des projets accompagnés : près de 50 %. À titre d’exemple, le projet de l’entreprise Eyco a été labellisé en 2021 avec un financement obtenu dans le cadre du plan France Relance. Les 2,3M€ reçus
vont lui permettre de construire une usine de production de nouveaux composants de connectique électronique pour les cartes à puce et l’internet des objets. Plus de 100 emplois devraient être créés d’ici 5 ans. Autre exemple dans la cybersécurité, SCS a labellisé le projet de la PME Trusted Objects pour financer un projet de R&D de 36 mois en vue de mettre en œuvre une plate-forme pour la détection d’intrusions dans les réseaux d’objets connectés de l’internet des objets. Cette plate-forme servira à mettre en place des contre-mesures et pourrait générer 5 M€ de chiffres d’affaires supplémentaires dans les quatre prochaines années. J’aimerais aussi citer le projet de la start-up Aiway : la réalisation d’un logiciel à partir de l’intelligence artificielle pour modéliser des prothèses dentaires imprimables en 3D dans le cabinet même d’un dentiste. 200 000 € ont été alloués à cette recherche qui a duré 9 mois.
Quels sont selon vous les principaux défis à relever pour assurer la transition écologique des entreprises membres de l’écosystème du pôle ?
Notre premier défi est de sensibiliser nos membres à l’importance d’entreprendre une démarche de sobriété énergétique et de transition écologique. Une démarche permise par deux leviers : l’élaboration de nouveaux modèles économiques (avec la création d’objets plus facilement réparables et donc moins rapidement obsolètes) et le développement de logiciels à partir de technologies plus sobres en énergie. Mais notre action s’étend bien au-delà du périmètre du Pôle et des acteurs du numérique. En effet, nous comptons bien aider les acteurs des autres secteurs industriels (aérien, agricole, énergie, mer…) à utiliser les technologies numériques afin de gagner en sobriété énergétique. Safran a déjà pu le constater : l’utilisation de l’Intelligence artificielle et la modélisation de moteurs d’avions et d’hélicoptères a permis de réduire leur consommation de kérosène. De même, les technologies numériques facilitent la détection d’objets ou de machines consommant trop d’énergie et permettent le monitoring de la consommation énergétique dans un double objectif : réduire l’empreinte carbone et améliorer l’efficacité. Éviter des accidents qui pourraient déclencher une pollution, mettre un terme à la surconsommation énergétique, mieux anticiper les pannes : autant d’enjeux cruciaux auxquels les membres de SCS peuvent apporter des solutions innovantes !
32 Avril 2023
© Pôle SCS © Pôle SCS
Secure Communicating Solutions cluster
Digital technologies at the service of energy sobriety
What are the key figures for the SCS cluster?
Based in the PACA region and specialised in digital technologies, SCS cluster has 310 members, 72% of which are SMEs and start-ups. In addition, there are major industrial groups as well as research laboratories from Inria, the CEA, Aix-Marseille University, etc. Since its creation, SCS has supported and approved more than 600 innovative projects, of which more than 300 have been selected for cumulative funding of more than €1 billion (€400 million in public funds). We also organise sixty events each year focusing on key technologies or markets. These are very successful, with over 2,000 participants each year. We also provide each year between 50 and 70 individual coaching sessions for SMEs and start-ups (fundraising, internationalisation, contacts with major accounts, marketing strategy, etc.). Finally, we are located in the second largest electronic region in France and we are the second largest semiconductor ecosystem in the country.

Could you present your key technologies and the markets they address?
We have identified 4 key technologies related to the strengths of our ecosystem: microelectronics, cybersecurity, artificial intelligence and the Internet of Things. These technologies are designed to meet the needs of 4 markets considered particularly promising, namely industry of the future (4.0 and soon 5.0), health and well-being, smart cities and intelligent mobility.
What support do you offer to your members in terms of product and service innovation? Could you give us some examples?
SCS offers support in setting up innovative projects and obtaining public funding (regional, national - France 2030 - and European - Horizon Europe). This support includes the creation of technological plans, financial plans and business plans to anticipate the commercialisation of the innovation. It lasts 2 months in average. It mobilises a committee of experts who hear the projects and decide on labelling. This offer is particularly popular with companies and we are pleased with the excellent financing rate of the projects supported: nearly 50%. As an example, the Eyco company’s project was approved
in 2021 with financing obtained within the framework of the France Relance plan. The €2,3m received will enable it to build a factory for the production of new electronic connector components for smart cards and the Internet of Things. More than 100 jobs should be created within 5 years. Another example in cybersecurity, SCS has approved the project of the SME Trusted Objects to finance a 36-month R&D project to implement a platform for detecting intrusions in the networks of connected objects of the Internet of Things. This platform will be used to implement countermeasures and could generate €5 million in additional revenue over the next four years. I would also like to mention the project of the start-up Aiway: the development of software based on artificial intelligence to model 3D printable dental prostheses in a dentist’s office. 200,000 € were allocated to this research which lasted 9 months.

In your opinion, what are the main challenges to be met to ensure the ecological transition of the companies in the cluster’s ecosystem?
Our first challenge is to raise awareness of the importance of undertaking an approach to energy sobriety and ecological transition. This approach is made
possible by two levers: the development of new economic models (with the creation of objects that are more easily repairable and therefore less quickly obsolete) and the development of software based on more energy-efficient technologies. But our action extends well beyond the perimeter of the cluster and the digital players. Indeed, we intend to help players in other industrial sectors (aviation, agriculture, energy, the sea, etc.) to use digital technologies to improve energy efficiency. Safran has already been able to see this: the use of Artifical Intelligence and modeling of aeroplane and helicopter engines has made it possible to reduce their paraffin consumption. Similarly, digital technologies make it easier to detect objects or machines that consume too much energy and to monitor energy consumption, with a dual objective of reducing the carbon footprint and improving efficiency. Avoiding pollution-related accidents, putting an end to over-consumption of energy: these are crucial issues to which SCS members can provide innovative solutions!
33 April 2023
© Pôle SCS
An interview with Mr. Olivier CHAVRIER, Managing Director of the SCS Secured Communicating Solutions cluster
Le référent de la confiance numérique en France
Un entretien avec M. Fabien AILI, Directeur Vérification d’identité, Biométrie & IA à Docaposte, Président du Pôle Solutions Communicantes Sécurisées (SCS), Vice-Président du ClusterIA

Quelle expertise avez-vous développée pour accompagner vos clients ?
Docaposte s’appuie sur une organisation matricielle composée de trois grands domaines d’activités : l’expertise et le conseil (conseil métier, accompagnement de la transformation numérique des entreprises, développement informatique), le développement de solutions et la délégation de prestations (produits packagés, business process outsourcing), et les plates-formes numériques (conception, mise en œuvre, exploitation). Ces trois domaines s’adressent à cinq grands marchés, à savoir la banque, la finance et l’assurance ; le secteur public ; la santé ; les PME ; et les grands comptes, tous secteurs confondus. À chaque marché correspond une offre de moyens dédiés.
À quoi attribuez-vous votre deuxième place du Top des éditeurs horizontaux de la 12ème édition du Top 250 des éditeurs de logiciels français (EY France / Numeum) ?
Je l’attribue principalement au positionnement de Docaposte en tant que référent de la confiance numérique en France. Expert dans le traitement de données sensibles, Docaposte bénéficie d’un positionnement unique sur le marché qui lui permet de répondre de bout en bout à l’intégralité d’un besoin client, en lui offrant un niveau de sécurité compatible avec ses enjeux et le niveau de risque de son activité. Nous sommes certifiés sur l’ensemble de la chaîne des services numériques de confiance : identification et authentification, conformité, gestion de flux sortants et entrants, lettre recommandée électronique, signature électronique, paiement digital, archivage numérique, sauvegarde de données et vote électronique. Par ailleurs, en tant que premier opérateur de données de santé en France avec plus de 45 millions de dossiers pharmaceutiques, Docaposte apporte son expertise dans la conception et la gestion de plateformes numériques sur mesure. Ses savoir-faire industriels et de délégation de gestion lui permettent de répondre à tous les besoins de ses clients.
Quel est votre positionnement sur le marché de la cybersécurité ?
Notre positionnement est intimement lié à notre statut de référent de la confiance numérique. Notre volonté est de sécuriser les communications de bout en bout et de garantir que les informations ne sont ni altérées, ni interceptées. D’où les nombreuses solutions que nous proposons : la signature électronique et la lettre recommandée électronique précédemment citées, mais aussi le coffre-fort citoyen Digiposte, l’Identité Numérique La Poste ou encore ID360, notre plateforme de vérification d’identité et d’entrée en relation. Mais nous voulons aller plus loin avec l’acquisition de Boomkr, une jeune pousse de la cyber-tech française spécialisée dans la cyber-sauvegarde. Enfin, l’arrivée début janvier de Guillaume Poupard, ancien Directeur de l’ANSSI, marque notre ambition de devenir d’ici 2030 l’acteur référent des services de confiance et de sécurité numériques en France et en Europe.
Quelle est la spécificité du site de Docaposte à Sophia Antipolis ?
Ce site concentre 440 personnes dédiées à des activités d’ingénierie pour le développement de nos solutions dans le domaine
de la confiance numérique. Son activité se partage entre le développement et la maintenance de plates-formes numériques (dont infogreffe.fr et jedeclare.com) d’une part, les prestations à destination de la banque-assurance, de la santé et des professions réglementées d’autre part. Ses deux domaines d’expertise sont la signature électronique et la biométrie couplée à l’intelligence artificielle : dans ce cadre, il cherche à améliorer les technologies de vérification de l’identité afin de lutter contre la fraude et d’optimiser les processus de manière sécurisée en collaboration avec les acteurs de l’écosystème dont le Pôle SCS, le 3IA Côte d’Azur, des laboratoires et grandes écoles.
Pourriez-vous nous présenter les projets de recherche en cours sur ce site ? Nous avons trois principaux projets de recherche en cours. Le premier concerne la reconnaissance de visages et la détection de deepfakes pour fiabiliser l’identification de personnes dans des processus d’entrée en relation digitale et lutter contre l’usurpation d’identité. Les services bancaires en ligne sont les premiers concernés et la technologie de comparaison faciale peut contribuer à bloquer l’accès aux pirates. Ce projet fait l’objet d’une collaboration avec un laboratoire d’EURECOM et s’inscrit dans le cadre du 3IA Côte d’Azur.
Le deuxième projet de recherche concerne le domaine de la santé. Il utilise l’intelligence artificielle pour évaluer automatiquement le niveau de douleur ressenti par un patient en se basant sur un enregistrement vidéo de son visage, capturé dans une situation spécifique (avant et après une intervention chirurgicale par exemple). Des algorithmes sont utilisés pour analyser certains éléments (micro-expressions faciales, changement de couleur du visage…), permettre une évaluation plus objective que l’échelle de 1 à 10 et adapter ainsi les traitements antidouleur. Ce projet vise aussi à accroître l’exploitabilité des captures vidéo et adjoindra des paramètres complémentaires (fréquence cardiaque, tension artérielle…) pour conforter les résultats initiaux.
Publireportage 34 Avril 2023
Docaposte
© Docaposte
Enfin, le troisième projet vise à faciliter le parcours d’entrée en relation digitale entre un utilisateur et un service métier avec l’objectif de fiabiliser la reconnaissance automatique d’informations dans des documents grâce à l’intelligence artificielle. À titre d’exemple, le traitement du langage naturel peut être utilisé pour interpréter correctement les informations d’un compromis de vente dans le cadre de l’octroi dématérialisé d’un crédit immobilier à un particulier.
Pourriez-vous nous présenter les activités du ClusterIA ?
Fondé en mars 2018 par trois startups (Synchronext, MyDataModels et 360&1), Docaposte, l’Université de Nice Côte d’Azur, l’association EducAzur et le Pôle SCS dont je suis par ailleurs le Président, le ClusterIA vise à fédérer les acteurs de l’intelligence artificielle, créer des synergies entre eux et promouvoir l’écosystème sur le plan national et international. Plusieurs actions ont été lancées dans cette optique : des meetups labellisés qui réunissent une fois par mois les membres, une startup, un grand groupe et un chercheur autour d’une thématique spécifique (IA et cybersécurité, IA et territoires intelligents…), des cas d’étude pour favoriser la construction de solutions d’IA dans l’agriculture, la 5G et la santé (médecine prédictive), la création du collectif technologique IA du Village Francophone, l’adhésion au comité
des écosystèmes aux côtés du Hub France IA, la participation au World IA Cannes Festival en avril...
Quels sont selon vous les principaux enjeux de recherche pour garantir un numérique de confiance et un numérique responsable ?
Désireux de développer un usage des technologies numériques qui soit démocratisé, fiable, sécurisé et respectueux de l’environnement, Docaposte se concentre notamment sur trois axes : agir en faveur de l’inclusion, maîtriser son impact environnemental et placer l’éthique au cœur de chacune de ses actions. La recherche doit donc permettre de relever les principaux défis que sont la réduction de l’impact de
nos activités (optimisation de la performance énergétique de nos bâtiments), le développement de services numériques plus « sobres » en énergie et la capacité à garantir l’éthique dans l’utilisation et le traitement des données, la gestion des données personnelles et l’utilisation de l’IA. En outre, le groupe La Poste s’est doté sous l’impulsion de Docaposte d’un comité et d’une charte éthiques en vue d’identifier les problèmes potentiels soulevés notamment par la comparaison faciale (biais, discrimination ethnique ou de genre…). Reste aussi l’enjeu de l’explicabilité des comportements d’une machine donnée : il en va de la transparence des processus vis-à-vis du client et de l’utilisateur final. In fine, c’est une question de crédibilité et d’acceptabilité sociale.


Publireportage 35 April 2023
©
© Docaposte
Docaposte
Docaposte
The reference for digital trust in France
An interview with Mr. Fabien AILI, Director of Identity Verification, Biometrics & AI at Docaposte, President of the Secured Communicating Solutions (SCS) cluster, Vice President of ClusterIA
What expertise have you developed to support your customers?
Docaposte is based on a matrix organisation made up of three main areas of activity: expertise and consulting (business consulting, support for the digital transformation of companies, IT development), development of solutions and delegation of services (packaged products, business process outsourcing), and digital platforms (design, implementation, operation). These three areas are aimed at five major markets, namely banking, finance and insurance; the public sector; healthcare; SMEs; and major accounts, all sectors combined. Each market has its own dedicated resources.
To what do you attribute your second place in the Top horizontal publishers of the 12th edition of the Top 250 French software publishers (EY France / Numeum)?
I attribute it mainly to Docaposte’s positioning as the benchmark for digital trust in France. As an expert in the processing of sensitive data, Docaposte is uniquely positioned on the market to meet all of its customers’ needs from start to finish, offering them a level of security that is compatible with their challenges and the level of risk involved in their business. We are certified for the entire chain of digital trust services: identification
and authentication, compliance, management of outgoing and incoming flows, electronic registered letters, electronic signatures, digital payments, digital archiving, data backup and electronic voting. In addition, as the leading operator of health data in France with more than 45 million pharmaceutical records, Docaposte brings its expertise in the design and management of customised digital platforms. Its industrial and management delegation know-how enables it to meet all its clients’ needs.
What is your positioning in the cybersecurity market?
Our positioning is closely linked to our status as a benchmark for digital trust. Our aim is to secure communications from end to end and to guarantee that information is neither altered nor intercepted. Hence the many solutions we offer: the electronic signature and the electronic registered letter mentioned above, but also the Digiposte citizen’s safe, La Poste Digital Identity and ID360, our identity verification and contact entry platform. But we want to go further with the acquisition of Boomkr, a French cyber-tech startup specialising in cyber-backup. Finally, the arrival in early January of Guillaume Poupard, former Director of ANSSI (the French National Cybersecurity Agency), marks our ambition to become the leading
player in digital trust and security services in France and Europe by 2030.
What is special about the Docaposte site in Sophia Antipolis?

This site employs 440 people dedicated to engineering activities for the development of our solutions in the field of digital trust. Its activity is divided between the development and maintenance of digital platforms (including infogreffe.fr and jedeclare.com) on the one hand, and services for banking and insurance, health and regulated professions on the other. Its two areas of expertise are electronic signatures and biometrics coupled with artificial intelligence: in this context, it seeks to improve identity verification technologies in order to combat fraud and optimise processes in a secure manner in collaboration with the players in the ecosystem, including the SCS cluster, the 3IA Côte d’Azur (Interdisciplinary Institute for Artificial Intelligence), laboratories and grandes écoles.
Could you tell us about the research projects underway on this site?
We have three main research projects underway. The first concerns face recognition and the detection of deepfakes to make the identification of people in digital entry processes more reliable and to combat identity theft. Online banking
Publireportage 36 Avril 2023
© Docaposte
services are the first to be affected and facial comparison technology can help block access to hackers. This project is being carried out in collaboration with a EURECOM laboratory and is part of the 3IA Côte d’Azur.
The second research project concerns the health sector. It uses artificial intelligence to automatically assess the level of pain felt by a patient based on a video recording of his or her face, captured in a specific situation (before and after a surgical operation, for example). Algorithms are used to analyse certain elements (facial micro-expressions, changes in facial colour, etc.), allowing a more objective assessment than the 1 to 10 scale and thus adapting pain relief treatments. This project also aims to increase the usability of video captures and will add complementary parameters (heart rate, blood pressure, etc.) to support the initial results.
Finally, the third project aims at facilitating the entry into a digital relationship between a user and a business service with the objective of making the automatic recognition of information in documents more reliable thanks to artificial intelligence. For example, natural language processing can be used to correctly interpret the information in a sales agreement in the context of the dematerialised granting
of a mortgage to an individual.
Could you introduce us to the activities of ClusterIA?
Founded in March 2018 by three startups (Synchronext, MyDataModels and 360&1), Docaposte, the University of Nice Côte d’Azur, the EducAzur association and the SCS cluster, of which I am also the President, the ClusterIA aims to federate the players in artificial intelligence, create synergies between them and promote the ecosystem on a national and international level. Several actions have been launched with this in mind: labelled meetups that bring together members, a startup, a large group and a researcher once a month around a specific theme (AI and cybersecurity, AI and smart territories, etc.), case studies to promote the construction of AI solutions in agriculture, 5G and health (predictive medicine), the creation of the Village Francophone AI technology group, membership of the ecosystem committee alongside the Hub France IA, participation in the World IA Cannes Festival in April, etc.
In your opinion, what are the main research challenges to ensure a trusted and responsible digital environment?
Docaposte is keen to develop a use of digital technologies that is democratised, reliable, secure and environmentally friendly, and is focusing in particular on three areas: acting

in favour of inclusion, controlling its environmental impact and placing ethics at the heart of all its actions. Research must therefore address the main challenges of reducing the impact of our activities (optimising the energy performance of our buildings), developing more energy-efficient digital services and ensuring ethical use and processing of data, personal data management and the use of AI. In addition, the La Poste group, under the impetus of Docaposte, has set up an ethics committee and charter to identify potential problems raised by facial comparison in particular (bias, ethnic or gender discrimination, etc.). There is also the issue of the explicability of the behaviour of a given machine: the transparency of the processes vis-à-vis the client and the end user is at stake. Ultimately, it is a question of credibility and social acceptability.

Publireportage 37 April 2023
Docaposte 2229, route des Crêtes - Site Arcole F-06560 Sophia Antipolis Tél. : +33 (0)4 93 95 69 99 E-mail : fabien.aili@docaposte.fr http://www.docaposte.com
© Docaposte
Quelle est l’expertise du Mipih en matière de systèmes d’information hospitaliers (SIH) ?
Groupement d’Intérêt Public dédié aux GHT, établissements sanitaires ou médico-sociaux et professionnels de santé libéraux, le Mipih est le 1er hébergeur public français certifié HDS avec 2 data centers en propre et 5 implantations à Toulouse, Amiens, Bordeaux, Reims et PariSanté Campus. Grâce à nos 900 collaborateurs, nous concevons, hébergeons, intégrons et diffusons des solutions pensées par, et pour les professionnels de santé, en relation avec leur territoire. 725 adhérents et clients sont équipés de solutions Mipih et nous évoluons aujourd’hui vers l’accompagnement des acteurs de santé dans leur digitalisation autour de 4 axes majeurs : la prise en charge du patient, le renforcement de la coordination des parcours de soins, la relation Ville-Hôpital et la protection des données de santé.

Pourriez-vous nous parler de la création du portail digihosp Patient dédié à l’hôpital et de son application ?
La digitalisation de la relation patient est un puissant levier d’amélioration du parcours de soins du patient et de son expérience. Accessible depuis un PC, une tablette ou un portable, l’assistant digihosp Patient réinvente la relation patient-hôpital à travers une solution unique de digitalisation du parcours patient pour tous les établissements de santé publics. Cette solution permet de maîtriser le parcours de soins, de renforcer l’attractivité
Mipih
Un entretien avec M. Mostapha LASSIK, Directeur du Mipih
et d’optimiser les organisations. Du côté du patient, elle leur permet ainsi qu’aux aidants d’organiser sereinement la prise en charge à l’hôpital, de la préparation de la venue au retour à domicile. Avec ce portail, le patient devient acteur de sa santé : il est mieux informé, mieux préparé, plus serein. digihosp Patient est déjà disponible auprès de plus de 30 établissements pour l’admission administrative en ligne et le parcours enrichi des étapes médicales personnalisées selon la pathologie est actuellement en expérimentation au CHU de Montpelier. Cette solution est référencée dans Mon Espace Santé depuis décembre 2022 et le Mipih continue de la faire évoluer en lien avec les nouveaux services de Mon Espace Santé, notamment avec les échanges de données.
Pourriez-vous nous donner quelques exemples de partenariats en cours dans la région ?
Dans le cadre de notre offre digihosp Patient - évoquée plus haut - nous avons, en mai dernier, signé un partenariat avec la startup toulousaine Yooli, qui est venue enrichir notre portail d’admission avec un parcours médico-soignant personnalisé selon le type de pathologies.

Dès février 2020, au tout début de la crise sanitaire, nous avons mis en place Medicam avec l’Union Régionale des Professionnels de Santé (URPS) Occitanie : il s’agit de la première plateforme de téléconsultation sécurisée publique, accessible à l’ensemble des professionnels de santé de France.
Lancée le 10 mars, elle totalisait deux mois plus tard plus de 50 000 téléconsultations, soit plus de 70 % des téléconsultations en région Occitanie.
Au niveau territorial le Mipih s’investit, aussi, auprès des associations et clusters tels que Ekitia, Ad’Occ ou Digital 113 afin de soutenir les initiatives entrepreneuriales locales et de mettre en place un mécénat de compétences au profit des secteurs sanitaire et numérique.
Quels sont les enjeux à venir qui vous mobilisent ?
Le premier enjeu est celui de la transformation numérique afin d’améliorer le parcours de soins et d’aller vers une expérience patient plus inclusive. Notre offre digihosp Patient va donc continuer d’évoluer avec de nouvelles fonctionnalités. Un autre défi est de redonner du temps aux personnels soignants et d’optimiser les processus de décision en capitalisant sur les nouvelles technologies comme l’IA ou le Big Data. Le traitement et la sécurité des données de santé représentent également un enjeu majeur, tout comme la construction d’un écosystème de données souverain, éthique et performant. Nous avons aussi à cœur de promouvoir la dimension RSE autour du numérique en santé (le Mipih est le 1er acteur de santé à intégrer l’Institut du Numérique Responsable), d’être un acteur de la nouvelle feuille de route 2023-2027 du Ségur du numérique en santé et de faciliter sa mise en œuvre.
Publireportage 38 Avril 2023
Des solutions numériques pour un système de santé cohérent, performant et créateur de valeur
© Mipih ©
Mipih
Mipih
Digital solutions for a coherent, efficient and value-creating healthcare system

An interview with Mr. Mostapha LASSIK, Director of Mipih
What is Mipih’s expertise in hospital information systems (HIS)?
A public interest group dedicated to GHTs, health and medico-social establishments and private healthcare professionals, Mipih is the leading French public-sector HDS-certified host, with two of its own data centres and five sites in Toulouse, Amiens, Bordeaux, Reims and PariSanté Campus. Thanks to our 900 employees, we design, host, integrate and distribute solutions designed by and for healthcare professionals, in relation to their territory. 725 members and clients are equipped with Mipih solutions and we are now moving towards supporting healthcare professionals in their digitalisation around 4 major axes: patient care, strengthening the coordination of care paths, the City-Hospital relationship and the protection of healthcare data.

Could you tell us about the creation of the digihosp Patient portal dedicated to hospitals and its application?
The digitalisation of the patient relationship is a powerful lever for improving the patient’s care path and experience. Accessible from a PC, a tablet or a mobile phone, the digihosp Patient assistant reinvents the patient-hospital relationship through a unique solution for digitising the patient pathway for all public health institutions. This solution allows to control the care pathway, to reinforce attractiveness and to optimise organisations. On the patient’s side, it enables them and their carers to organise their hospital care
with peace of mind, from the preparation of their arrival to their return home. With this portal, the patient becomes a player in his or her own health: he or she is better informed, better prepared and more serene. digihosp Patient is already available in more than 30 establishments for online administrative admission, and the pathway enriched with personalised medical steps according to the pathology is currently being tested at the Montpelier University Hospital. This solution has been referenced in Mon Espace Santé since December 2022 and Mipih continues to develop it in connection with the new services of Mon Espace Santé, particularly with data exchanges.
Could you give us some examples of current partnerships in the region?
As part of our digihosp Patient offermentioned above - last May we signed a partnership with the Toulouse startup Yooli, which has enriched our admission portal with a personalised medical and nursing pathway according to the type of pathology.

In February 2020, at the very beginning of the health crisis, we set up Medicam with the Union Régionale des Professionnels de Santé (URPS) Occitanie: this is the first secure public teleconsultation platform, accessible to all health professionals in France. Launched on 10 March, two months later it had already received more than 50,000 teleconsultations, i.e. more than 70% of the teleconsultations in the Occitanie region.
At the territorial level, Mipih is also involved with associations and clusters such as Ekitia, Ad’Occ or Digital 113 in order to support local entrepreneurial initiatives and to set up a skills sponsorship for the benefit of the health and digital sectors.
What are the future challenges that mobilise you?
The first challenge is that of digital transformation in order to improve the care process and move towards a more inclusive patient experience. Our digihosp Patient offer will therefore continue to evolve with new features. Another challenge is to give time back to healthcare staff and to optimise decision-making processes by capitalising on new technologies such as AI and Big Data. The processing and security of health data is also a major challenge, as is the construction of a sovereign, ethical and efficient data ecosystem. We are also committed to promoting the CSR dimension of digital health (Mipih is the first health player to join the Institut du Numérique Responsable), to be a player in the new 2023-2027 Ségur roadmap for digital health and to facilitate its implementation.
Mipih
2 bis, impasse Michel Labrousse F-31036 Toulouse
Tél. : +33 (0)5 34 61 50 00
E-mail : contact@mipih.fr - https://mipih.fr/
Publireportage 39 April 2023
© Mipih © Mipih
Environnement et développement durable : l’innovation au service des transitions et des besoins de demain
Économie de la mer et naturalité sont au cœur des enjeux des régions Sud et Occitanie. Et pour cause : les perspectives d’une industrie maritime performante et d’une production agricole durable sont des plus intéressantes pour les entreprises locales en quête de compétitivité et les pouvoirs publics soucieux d’atteindre un niveau satisfaisant de souveraineté alimentaire. Des défis que les acteurs de la recherche et de l’innovation contribuent à relever.

Première région maritime française en nombre d’emplois liés à la mer (124 000, soit près de 30 % de la filière française), la région Sud se distingue par son littoral de 1.000 km de côtes qui fait d’elle la première destination française pour le nautisme et la croisière, mais aussi par son économie industrielle et de services innovante et ouverte sur l’international, avec des acteurs portuaires et logistiques de référence (Grand Port Maritime de Marseille, CMA CGM, hub GNL d’Elengy à Fos-sur-Mer) et un positionnement fort sur l’éolien offshore flottant illustré par le projet de ferme pilote « Provence Grand Large », porté par EDF renouvelables, et un fort écosystème d’acteurs pour la conception, l’assemblage, l’exploitation ou la maintenance des futures fermes en mer. Par ailleurs, la région Sud bénéficie d’un écosystème de recherche et d’innovation pluridisciplinaire au travers des trois Universités (Aix-Marseille, Côte d’Azur, Toulon), de l’École Nationale Supérieure Maritime, de l’école d’ingénieurs Seatech à Toulon, de l’École Centrale de Marseille et de l’Institut de la Mer de Villefranche.
Sur cette base solide, les acquis de l’opération d’intérêt national (OIR) Économie de la mer 2016-2021 sont encourageants : sur les 48 projets recensés et analysés, 10 ont bénéficié d’un accompagnement par le plateau OIR sur tous ses secteurs d’activités (défense, sureté, sécurité, yachting, nautisme, robotique sous-marine, éolien offshore flottant, transport maritime, aménagements et logistique portuaire) et 10 projets ont été présentés au Comité d’ingénierie financière des OIR pour près de 104,8 M€ d’investissements publics-privés dont 92,6 M€ ont été sécurisés. La mandature a également été marquée par l’adoption du Plan « Escales zéro fumée », destiné à lutter contre la pollution de l’air dans les ports de commerce et doté de 30 M€ pour l’électrification des quais et la modernisation des navires à Marseille, Nice et Toulon. L’OIR et ses acteurs ont aussi pu compter sur l’appui du Pôle Mer Méditerranée, du cluster Riviera Yachting
Network et du Campus des métiers et des qualifications Économie de la mer pour le volet formation.
D’ici 2028, la promotion d’un leadership régional en économie de la mer doit reposer sur l’exigence d’une double performance économique et environnementale. La feuille de route de l’OIR 2021-2028, inscrite dans une dynamique mondiale qui projette un doublement de la valeur ajoutée en quinze ans d’après le rapport de l’OCDE « L’économie de la mer en 2030 » publié le 18 mai 2017, a déterminé quatre axes prioritaires d’action et d’investissement : renforcer l’excellence des industries navales et réussir leur transition écoénergétique (nouveaux modes de propulsion, navires autonomes…), promouvoir des infrastructures portuaires et des chaînes logistiques compétitives, propres et résilientes (port du futur, hubs portuaires pour des carburants alternatifs de type GNL ou hydrogène, aménagements côtiers…), accélérer le positionnement sur les activités sous-marines et les grands fonds (systèmes de drones et de robots sous-marins, monitoring environnemental, capteurs innovants
et synergies entre technologies spatiales pour la filière grands fonds…), déployer l’éolien offshore flottant et structurer une économie de la biodiversité marine (biomimétisme, bio-inspiration, biotechnologies bleues telles que la culture d’algues et de micro-algues)1

40 Avril 2023
Tour CMA-CGM face à la digue du Fort Saint-Jean à Marseille / CMA-CGM Tower facing the Fort Saint-Jean dike in Marseille
© Patrick Nouhailler’s
© OCDE
Vers une alimentation durable et de qualité
Un second domaine lié au développement durable mobilise la région Sud : celui de la naturalité qui englobe l’alimentation durable et de qualité, les ingrédients naturels, la cosmétique naturelle et la parfumerie, la nutraceutique, le bio-contrôle et la bio-stimulation. Adapter la production agricole aux crises climatique, sanitaire et géostratégique, concilier les exigences accrues en termes d’environnement, de traçabilité et de « juste » prix pour tous, adapter les modèles économiques pour maintenir la compétitivité via la modernisation des outils de production, l’innovation et la structuration des filières : autant de défis pour lesquels la région Sud dispose de plusieurs atouts. Elle abrite en effet les sièges de plusieurs interprofessions comme les Plantes à Parfum, Aromatiques et Médicinales, France Olive et France Amande. Elle occupe la seconde place en matière de cosmétique, s’appuie sur un secteur de la nutraceutique en plein essor (avec quelque 80 acteurs dont Naturex racheté par Givaudan, Robertet, Thalgo, Genevrier, Arkopharma, Horus, Ineldea, NHCO…) ainsi que des entreprises tout aussi dynamiques dans la bio-stimulation et le bio-contrôle, des semenciers de renom international et un tissu industriel historique particulièrement diversifié dans l’agroalimentaire.

Le concept de naturalité, initié en 2016 et porté par la Région Sud, a pu s’appuyer sur un fort dynamisme entrepreneurial et académique : la « Task force des industriels » a été clé pour le lancement de cette OIR et son dynamisme. Treize projets structurants ont été accélérés par le plateau d’ingénierie financière des OIR, 19 ont été présentés en Comité d’Ingénierie Financière, ce qui représente 168,7 M€ sécurisés dont 78,1 M€ privés et 90,6 M€ publics ; 8,1% des financements sont issus de la Région, soit 13,6 M€. L’effort a porté sur la structuration de filières traditionnelles et emblématiques (amande, bigaradier…), la construction de filières nouvelles (Lou Pan d’Ici), la consolidation d’écosystèmes territoriaux (dont le Grand Avignon avec la Cité de l’Innovation et l’école d’ingénieurs agronomes ISARA), le soutien à l’innovation (implantation de cultures hors sol –Futuragaia –, expérimentation de la mise en place d’un label régional bas carbone à partir de l’agriculture), le renforcement de l’offre de services régionale (Natura’Lub à Cavaillon, future ZAE dédiée aux entreprises de la naturalité, fonds d’amorçage et capital-risque pour les start-up de la Footech, Agritech, Winetech porté par le Pôle Innov’Alliance, accélérateur Obratori porté par L’Occitane à Marseille, Campus Arôme-Parfum-Cosmétique sur Nice).
Face aux défis à relever (souveraineté, accélération de la relocalisation, développement et pérennisation de l’industrialisation, consolidation de l’attractivité et rayonnement à l’export), les acteurs de la naturalité (à commencer par ceux de la R&D et de l’innovation) ambitionnent d’ici 2028 de consolider les filières régionales, renforcer la compétitivité des agriculteurs, entreprises et industries de la naturalité et développer des modèles économiques innovants pour déployer des systèmes agro-alimentaires durables et résilients et faire rayonner le territoire et ses acteurs. Quatre axes stratégiques ont été identifiés : accompagner la croissance, la réindustrialisation et la relocalisation des entreprises de la Naturalité en région Sud (en collaboration étroite avec SUD Accélérateur et le Parcours Sud Industries 4.0), renforcer la souveraineté alimentaire régionale par la structuration et le développement des filières régionales autour de modèles économiques écoresponsables et innovants (multiplication des boucles d’approvisionnement local et des projets relevant de l‘économie circulaire avec la valorisation des co-produits de l’agriculture), accompagner l’évolution des modèles économiques de la naturalité pour accélérer la 3ème révolution agricole, les expérimentations et les systèmes agro-agri durables (innovation autour du triptyque numérique, robotique et génétique pour faciliter le virage de l’agriculture 4.0, expérimentations autour du biocontrôle et de la bio-stimulation, opérations de démonstration, développement de plateformes de recherche et de formations, poursuite de l’expérimentation sur le label régional bas carbone), développer l’offre de formation
et le rayonnement régional sur les marchés de la naturalité autour de lieux et territoires emblématiques (métiers en tension, formations de pointe innovantes, appui à l’export des acteurs de la naturalité, consolidation de lieux et d’écosystèmes territoriaux proposant des offres de service de pointe différenciantes à l’échelle nationale). Autant d’actions pilotées par le comité de pilotage de l’OIR Naturalité qui regroupe le Pôle de compétitivité Innov’Alliance, l’ARIA Sud, le CRITT, l’IFRIAA, les organismes de formation, la Chambre régionale d’agriculture, les interprofessions, la Coopération Agricole Sud ainsi qu’une Task Force d’entrepreneurs renouvelée (Le Roy René, Arkopharma, Les Biolonistes, Pronatura, Agapé, Acanthis, OvinAlp…)2. L’union fait la force !
Soutenir les objectifs d’innovation et de croissance des acteurs de l’eau La région Occitanie n’est pas en reste lorsqu’il s’agit d’accélérer le développement par l’innovation des entreprises actives dans les services environnementaux. C’est la raison d’être de France Water Team : basé à Montpellier, le pôle de compétitivité de la filière eau a identifié les principaux marchés-cibles (l’eau dans la ville et les territoires ruraux, l’eau dans l’agriculture, l’eau dans l’industrie, l’eau dans le bien-être, les loisirs et la santé, l’eau dans les milieux naturels) et décliné les enjeux qui structurent la filière en France (qualité, quantité, économie circulaire, patrimoine, transition numérique). Il accompagne les acteurs de la filière (entreprises, laboratoires de recherche et collectivités) dans la préparation, la labellisation et la réalisation de leurs projets d’innovation.
41 April 2023
Le lichen du genre Xanthoria, une source d’inspiration pour le biomimétisme / The lichen of the genus Xanthoria, a source of inspiration for biomimicry
© Bj.schoenmakers
France Water Team et les pôles régionaux qu’il fédère, AQUA-VALLEY, DREAM Eau & Milieux et HYDREOS, sont parties prenantes de projets aux échelles transfrontalière, européenne et internationale. L’objectif de la participation à de tels projets est de mobiliser de nouvelles collaborations, synergies et expertises mais également de nouvelles sources de financement au service des membres affiliés France Water Team. Au total, plus de 220 projets ont été labellisés depuis 2010 pour un budget total de R&D de 297 M€ sur l’ensemble des guichets de financement de l’innovation.
Au niveau européen, le pôle AQUA-VALLEY est notamment impliqué dans le projet Interreg Sudoe AQUIFER: d’une durée de 30 mois (novembre 2020 – avril 2023), il avait pour objectif de capitaliser, tester, diffuser et transférer des pratiques innovantes pour la préservation, la surveillance et la gestion intégrée des aquifères qui sont utiles lors de la prise de décisions sur la gestion des ressources en eau souterraines. Le BRGM (France), la Comunitat d’usuaris d’aigua del Llobregat (Espagne), l’IGME (porteur, Espagne), Catalan Water Partnership (Espagne), Aguas do Ribatejo (Portugal), PPA (Portugal) et l’Instituto Superior de Agronomia (Espagne) faisaient partie des partenaires du projet. Pour sa part, AQUA-VALLEY a été chargé de la mise en œuvre aux côtés des deux autres clusters du projet (CWP et PPA) de l’activité 4 du projet, à savoir l’identification, l’analyse et la diffusion de pratiques innovantes en matière de gestion intégrée des eaux souterraines ; il était aussi leader de la mise en œuvre de la plateforme interrégionale des bonnes pratiques. Mais ce projet était tout aussi intéressant pour les membres affiliés France Water Team à travers la détection, le test et la mise en œuvre de pratiques innovantes de gestion des eaux souterraines, l’amélioration de la coopération et le transfert de pratiques innovantes pour la préservation, la surveillance et la gestion intégrée des aquifères, la mise en place d’un réseau transfrontalier de surveillance des nappes en temps réel, en termes de quantité (piézométrie) et de qualité, le développement d’outils communs de gestion et l’accès à un outil d’aide à la décision pour diffuser les bonnes pratiques via un site internet permanent et gratuit pour tous les acteurs du secteur de l’eau.

En parallèle, France Water Team poursuit activement sa mission d’ingénierie de projet. Sur la période 2019-2022, 125 projets nationaux et régionaux ont été

accompagnés et/ou labellisés, témoignant de la dynamique R&D de ses membres affiliés pour répondre aux enjeux dans le domaine de l’eau. Parmi ces 125 projets, 71 projets sont collaboratifs et 54 non collaboratifs. Les projets labellisés et financés sont au nombre de 29 pour les collaboratifs et 37 pour les non collaboratifs. De plus, 53 % des projets accompagnés et labellisés par le pôle France Water Team sont lauréats des Appels à Projets sur lesquels ils ont candidaté. France Water Team accompagne également ses adhérents sur des projets européens : entre 2019 et 2022, 20 projets ont été labellisés, dont 12 ont été financés.
La diversité de projets accompagnés et labellisés sur cette période, allant de projets à Technology Readiness Level (TRL) bas (projet ANR) jusqu’à des projets du Plan de Relance, démontre que le pôle accompagne ses adhérents sur l’ensemble de la chaîne de valeur. Ces projets permettent d’accroître les connaissances scientifiques et de les communiquer, de lever des verrous techniques et technologiques pour répondre aux enjeux d’aujourd’hui et de demain, de développer le savoir-faire des entreprises dans un seul et unique objectif : innover pour protéger, gérer les ressources en eau et les milieux associés et accroître la résilience des territoires dans le contexte du changement climatique.
Cet objectif se retrouve dans les appels à projets de l’année 2023, dont deux appels à projets de PRIMA (un partenariat pour la recherche et l’innovation dans la région méditerranéenne sur les systèmes alimentaires et les ressources en eau pour des sociétés méditerranéennes durables et inclusives), à savoir Section 1 : Topic 1.1.1 IA : « Integrated adaptive wastewater management plans in the Mediterranean region » et Section 2 : Topic 2.1.1 RIA : « New governance models to define best practices for sustainable water management and conflict mitigation », mais aussi l’appel « Innover pour réussir les transitions agroécologique et alimentaire », ou encore un appel du plan d’investissement France 2030 visant des projets de recherche, de développement et d’innovation liés à 2 thématiques (innover pour réussir la transition agroécologique ; besoins alimentaires de demain). De nouvelles opportunités de croître pour les membres de France Water Team3
Pôle Mer Méditerranée : pour un développement durable de l’économie maritime et littorale


476 membres dont 50 % de PME, 534 projets coopératifs labellisés pour un budget total de 1 322,89 M€, 51 projets structurants labellisés (platesformes mutualisées d’innovation, ITE, IRT, Labex, Equipex...) pour un montant de 1 837,21 M€ : le Pôle Mer PACA met résolument le cap sur l’innovation et la compétitivité. Il fédère et accompagne des start-ups, PME, grands groupes, organismes de recherche et de formation autour de six domaines d’actions stratégiques : défense, sécurité et sûreté maritime ; naval et nautisme ; ressources énergétiques et minérales marines ; ressources biologiques marines ; littoral et environnement marin ; ports, infrastructures et logistique. Labellisé en 2023, le projet de DEESS porte sur le développement d’un système d’imagerie des fonds marins par un essaim de micro-drones et le traitement massif des données pour l’inventaire et le suivi systématique des écosystèmes benthiques.
Autre projet en cours, européen celui-ci : BlackSeaConnect, dont l’objectif global est de coordonner le développement du programme stratégique de recherche et d’innovation (SRIA) en mer Noire, sur la base des principes définis dans le document de vision de Burgas, et de soutenir le développement de la croissance bleue. Le Pôle Mer Méditerranée facilite aussi l’accès de ses membres aux marchés porteurs de l’Europe et de la Méditerranée, mais aussi de l’Amérique du Nord, du Brésil, du Japon, de l’Asie du Sud-Est et de l’Australie. Un réseau export puissant et une offre optimisée, organisée sur les pays cibles les plus attractifs, et plusieurs conventions de partenariats internationaux pour offrir aux adhérents une visibilité sur les marchés et des points de relai d’information privilégiés. Ce faisant, le Pôle Mer Méditerranée affirme haut et fort son ambition à la fois méditerranéenne et internationale4.
42 Avril 2023
3 Source : France Water Team.
4 Source : Pôle Mer Méditerranée.
Environment and sustainable development: innovation to meet the transitions and needs of tomorrow
The economy of the sea and naturalness are at the heart of the challenges facing the Southern and Occitan regions. And for good reason: the prospects of a high-performance maritime industry and sustainable agricultural production are most interesting for local businesses seeking competitiveness and for public authorities concerned with achieving a satisfactory level of food sovereignty. Research and innovation players are helping to meet these challenges.
As the leading maritime region in France in terms of the number of jobs linked to the sea (124,000, i.e. nearly 30% of the French sector), the South region is distinguished by its 1,000 km of coastline, which makes it a key player in the development of the maritime sector. It also has an innovative industrial and service economy that is open to the international market, with leading port and logistics players (Grand Port Maritime de Marseille, CMA CGM, Elengy’s LNG hub in Fos-sur-Mer) and a strong position in floating offshore wind energy, illustrated by the «Provence Grand Large» pilot farm project, supported by EDF Renewables, and a strong ecosystem of players for the design, assembly, operation and maintenance of future offshore farms. In addition, the southern region benefits from a multidisciplinary research and innovation ecosystem through the three universities (Aix-Marseille, Côte d’Azur, Toulon), the École Nationale Supérieure Maritime, the Seatech engineering school in Toulon, the École Centrale de Marseille and the Institut de la Mer in Villefranche.

On this solid basis, the achievements of the Operation of National Interest (OIR) Economy of the Sea 2016-2021 are encouraging: out of the 48 projects identified and analysed, 10 benefited from support from the OIR platform in all its sectors of activity (defence, safety, security, yachting, nautical engineering, underwater robotics, floating offshore wind, maritime transport, port facilities and logistics) and 10 projects were presented to the OIR Financial Engineering Committee for nearly €104.8m of public-private investment, of which €92.6m was secured. The mandate was also marked by the adoption of the «Zero Smoke Ports» plan, designed to combat air pollution in commercial ports and endowed with €30m for the electrification of quays and the modernisation of ships in Marseille, Nice and Toulon. The OIR and its stakeholders have also been able to count on the support of the Pôle Mer Méditerranée, the Riviera Yachting Network cluster and the Campus of trades and qualifications “Economy of the sea” for the training aspect.
Between now and 2028, the promotion of regional leadership in the marine economy must be based on the requirement of a double economic and environmental performance. The OIR 2021-2028 roadmap, which is part of a global dynamic that projects a doubling of added value in fifteen years according to the OECD report «The Ocean Economy in 2030» published on April 27, 2016, has determined four priority areas for action and investment: strengthen the excellence of the naval industries and make a success of their eco-energy transition (new modes of propulsion, autonomous ships...), promote competitive, clean and resilient port infrastructures and logistics chains (port of the future, port hubs for alternative fuels such as LNG or hydrogen, coastal developments... ), accelerate the positioning of underwater and deep-sea activities (drone and underwater robot systems, environmental monitoring, innovative sensors and synergies between space technologies for the deep-sea sector, etc.), deploy floating offshore wind turbines and structure an economy based on marine biodiversity (biomimicry, bio-inspiration, blue biotechnologies such as the cultivation of algae and micro-algae).
Towards sustainable and quality food
A second area linked to sustainable development is mobilising the Southern Region: that of naturalness which includes sustainable and quality food, natural ingredients, natural cosmetics and perfumery, nutraceuticals, bio-control and bio-stimulation. Adapting agricultural production to the climatic, health and geostrategic crises, reconciling the increased demands in terms of the environment, traceability and «fair» prices for all, adapting economic models to maintain competitiveness through the modernisation of production tools, innovation and the structuring of sectors: these are all challenges for which the South region has several assets. It is home to the headquarters of several interprofessions such as Perfumed, Aromatic and Medicinal Plants, France Olive and France Almond. It occupies second place on a national level in cosmetics, and is supported by a booming nutraceutical sector (with some 80 players including Naturex, acquired by Givaudan, Robertet, Thalgo, Genevrier, Arkopharma, Horus, Ineldea, NHCO, etc.) as well as equally dynamic companies in bio-stimulation and bio-control, internationally renowned
43 April 2023
The Belem returns to Toulon harbour. / Le Belem rentre en rade de Toulon..
© Patrick Nouhailler’s
seed companies and a particularly diversified historical industrial fabric in the food industry.
The concept of naturalness, initiated in 2016 and supported by the Southern Region, has been able to rely on a strong entrepreneurial and academic dynamism: the «Industrialists’ Task Force» has been key to the launch of this OIR and its dynamism. Thirteen structuring projects have been accelerated by the RIO financial engineering platform, 19 have been presented to the Financial Engineering Committee, representing €168.7M secured, of which €78.1M is private and €90.6M public; 8.1% of the funding comes from the Region, i.e. €13.6M. The effort has been focused on structuring traditional and emblematic sectors (almonds, sour cherries, etc.), the construction of new sectors (Lou Pan d’Ici), the consolidation of territorial ecosystems (including Greater Avignon with the Cité de l’Innovation and the ISARA agricultural engineering school), and support for innovation (establishment of off-farm crops - Futuragaia -, experimentation with the implementation of a regional low-carbon label based on agriculture), strengthening the regional service offer (Natura’Lub in Cavaillon, a future economic activity zone dedicated to naturalness companies, seed capital and venture capital for Footech start-ups, Agritech, Winetech supported by the Innov’Alliance cluster, Obratori accelerator supported by L’Occitane in Marseille, Aroma-Parfum-Cosmetics Campus in Nice).

Faced with the challenges to be met (sovereignty, acceleration of relocation,
development and perpetuation of industrialisation, consolidation of attractiveness and export influence), the players in the naturalness sector (starting with those in R&D and innovation) aim to consolidate the regional sectors by 2028, strengthen the competitiveness of farmers, companies and industries in the naturalness sector and develop innovative economic models to deploy sustainable and resilient agrifood systems and promote the territory and its players. Four strategic axes have been identified: supporting the growth, reindustrialisation and relocation of naturalness companies in the South region (in close collaboration with SUD Accelerator and Parcours Sud Industries 4. 0 course), strengthen regional food sovereignty by structuring and developing regional sectors around eco-responsible and innovative economic models (multiplication of local supply loops and projects relating to the circular economy with the valorisation of agricultural co-products), accompany the evolution of naturalness economic models to accelerate the 3rd agricultural revolution, experimentation and sustainable agri-systems (innovation around the digital, robotics and genetics triptych to facilitate the shift to 4. 0 agriculture, experiments on biocontrol and bio-stimulation, demonstration operations, development of research and training platforms, continuation of the experimentation on the regional low-carbon label), develop the training offer and the regional influence on the naturalness markets around emblematic places and territories (jobs in tension, innovative advanced training, support for the export of naturalness actors, consolidation of places and territorial ecosystems
proposing advanced service offers that are differentiating on a national scale). All these actions are steered by the Naturality OIR steering committee, which includes the Innov’Alliance competitiveness cluster, the ARIA Sud, the CRITT, the IFRIAA, training organisations, the Regional Chamber of Agriculture, interprofessions, the Coopération Agricole Sud and a renewed Task Force of entrepreneurs (Le Roy René, Arkopharma, Les Biolonistes, Pronatura, Agapé, Acanthis, OvinAlp, etc.). Unity is strength!
Supporting the innovation and growth objectives of water players
The Occitanie region is not to be outdone when it comes to accelerating the development through innovation of companies active in environmental services. This is the raison d’être of France Water Team: based in Montpellier, the competitiveness cluster for the water sector has identified the main target markets (water in cities and rural areas, water in agriculture, water in industry, water in well-being, leisure and health, water in natural environments) and defined the issues that structure the sector in France, namely quality, quantity, circular economy, heritage, and digital transition. It supports the players in the sector (companies, research laboratories and local authorities) in the preparation, labelling and implementation of their innovation projects.
France Water Team and the regional clusters it federates, AQUA-VALLEY, DREAM Eau & Milieux and HYDREOS, are involved in projects on a cross-border, European and international scale. The objective of participating in such projects is to mobilise new
44 Avril 2023
©
Packaging line for pill boxes at Arkopharma Laboratories in Carros / Chaîne de conditionnement de piluliers (mise en étui) aux Laboratoires d’Arkopharma à Carros
Root66
collaborations, synergies and expertise, but also new sources of funding for the affiliated members of the France Water Team. In total, more than 220 projects have been accredited since 2010 for a total R&D budget of €297M from all innovation funding windows.

At the European level, the AQUA-VALLEY cluster is notably involved in the Interreg Sudoe AQUIFER project: lasting 30 months (November 2020 - April 2023), its objective was to capitalise, test, disseminate and transfer innovative practices for the preservation, monitoring and integrated management of aquifers that are useful when making decisions on the management of groundwater resources. BRGM (France), Comunitat d’usuaris d’aigua del Llobregat (Spain), IGME (leader, Spain), Catalan Water Partnership (Spain), Aguas do Ribatejo (Portugal), PPA (Portugal) and Instituto Superior de Agronomia (Spain) were among the project partners. For its part, AQUA-VALLEY was in charge of implementing, together with the two other project clusters (CWP and PPA), activity 4 of the project, i.e. the identification, analysis and dissemination of innovative practices in integrated groundwater management; it was also the leader of the implementation of the interregional platform of good practices. But this project was also of interest to the France Water Team affiliates through the detection, testing and implementation of innovative groundwater management practices, the improvement of cooperation and the transfer of innovative practices for aquifer preservation, mo-

nitoring and integrated management, the implementation of a cross-border network for real-time monitoring of groundwater quantity (piezometry) and quality, the development of common management tools and access to a decision support tool to disseminate good practices via a permanent website free of charge for all stakeholders in the water sector.
In parallel, France Water Team is actively pursuing its project engineering mission. Over the period 2019-2022, 125 national and regional projects have been supported and/or labelled, testifying to the R&D dynamics of its affiliated members to meet the challenges in the water sector. Of these 125 projects, 71 are collaborative and 54 are non-collaborative. The number of labelled and financed projects is 29 for collaborative projects and 37 for non-collaborative projects. Moreover, 53% of the projects supported and labelled by France Water Team cluster are winners of the calls for projects for which they applied. France Water Team also supports its members in European projects: between 2019 and 2022, 20 projects have been accredited, of which 12 have been funded.
The diversity of projects supported and accredited over this period, ranging from low Technology Readiness Level (TRL) projects (ANR projects) to Recovery Plan projects, demonstrates that the cluster supports its members across the entire value chain. These projects enable scientific knowledge to be increased and communicated, technical and technological barriers to be removed in order to meet the challenges of today and tomorrow, and the know-how of companies to be developed with a single objective in mind: to innovate in order to protect and manage water resources and associated environments and increase the resilience of territories in the context of climate change.
This objective is reflected in the calls for projects of the year 2023, including two calls for projects of PRIMA (a partnership for research and innovation in the Mediterranean region on food systems and water resources for sustainable and inclusive Mediterranean societies), namely Section 1: Topic 1.1.1 IA: «Integrated adaptive wastewater management plans in the Mediterranean region» and Section 2: Topic 2. 1.1 RIA: «New governance models to define best practices for sustainable water management and conflict mitigation», but also the call «Innovating for successful agro-ecological and food transitions», or a call of the France 2030 investment plan targeting research, development and innovation projects related to 2 themes (innovating for successful agro-ecological transition; food needs of tomorrow). New opportunities for growth for the members of France Water Team.
Mediterranean Sea Cluster: for a sustainable development of the maritime and coastal economy



476 members, 50% of which are SMEs, 534 accredited cooperative projects with a total budget of €1,322.89 million, 51 accredited structuring projects (shared innovation platforms, ITE, IRT, Labex, Equipex, etc.) for a total of €1,837.21 million: the PACA Sea Cluster is firmly focused on innovation and competitiveness. It brings together and supports start-ups, SMEs, major groups, research and training organisations around six strategic areas of action: defence, security and maritime safety; naval and nautical engineering; marine energy and mineral resources; marine biological resources; coastline and marine environment; ports, infrastructures and logistics. The DEESS project, which was accredited in 2023, involves the development of a seabed imaging system using a swarm of micro-drones and the massive processing of data for the inventory and systematic monitoring of benthic ecosystems.
Another ongoing project, this one European: BlackSeaConnect, whose overall objective is to coordinate the development of the Strategic Research and Innovation Agenda (SRIA) in the Black Sea, based on the principles defined in the Burgas vision document, and to support the development of blue growth. The Pôle Mer Méditerranée also facilitates the access of its members to promising markets in Europe and the Mediterranean, but also in North America, Brazil, Japan, South-East Asia and Australia. A powerful export network and an optimised offer, organised on the most attractive target countries, and several international partnership agreements to offer members visibility on the markets and privileged information relays. In so doing, the Mediterranean Sea Cluster is asserting its Mediterranean and international ambitions loud and clear.
45 April 2023
Photobioreactor of Microphyt, a Montpellier-based company specialised in nutraceuticals, cosmetics and microalgae culture / Photobioréacteur de Microphyt, une entreprise montpelliéraine spécialisée dans la nutraceutique, la cosmétique et la culture de microalgues
© Arnaud Muller-Feuga
Accompagner la transition hydrique des territoires grâce aux solutions innovantes
Un entretien avec M. Sylvain BOUCHER, Président du Pôle Aqua-Valley

Quels sont les chiffres-clés et les axes stratégiques du Pôle Aqua-Valley ?
Créé en 2011, le Pôle Aqua-Valley rassemble 245 membres dont 225 entreprises (à 84 % des TPE, PME et startups) qui représentent 4 000 salariés et 1,5 Md€ de chiffre d’affaires. Il est un des 3 membres fondateurs de France Water Team, le Pôle de Compétitivité de la filière de l’eau et regroupe l’ensemble des métiers de la filière. Par ailleurs, il a labellisé 98 projets de R&D pour un budget total de près de 160 M€ et son équipe de 10 personnes est très mobilisée par l’organisation de quelque 150 événements par an. Le Pôle Aqua-Valley a identifié 4 axes stratégiques : l’identification et la mobilisation des ressources en eau, la gestion concertée de ces ressources et de leurs usages, la réutilisation des eaux de toutes origines (qualité, identification et traitement des pollutions), les approches institutionnelles et sociétales des eaux et de leurs usages (acceptation sociétale des solutions innovantes pour le traitement de l’eau).
Pourriez-vous nous présenter votre offre de services ?
Dédié comme tous les pôles à l’innovation collaborative, Aqua-Valley accompagne le développement économique des entreprises pour leur permettre de répondre aux besoins des marchés. Aqua-Valley est un animateur de réseau avec la participation à des salons, l’organisation de journées techniques, de conférences, de rencontres et de formations-actions pour favoriser la constitution de consortia d’innovation et l’accès à de nouveaux marchés. Il accompagne les entreprises dans leurs démarches d’innovation, d’export, de croissance, de montage de projets européens, de normalisation et d’intégration de la RSE pour accroître leur capacité à répondre aux appels d’offres. Dans le cadre du projet AQUARHESE, il assure la bonne application de la charte qualité des réseaux d’eau et d’assainissement, et alimente la réflexion sur la gestion intégrée des eaux pluviales ou l’efficience des réseaux en milieu urbain. Il représente également les entreprises adhérentes au sein du comité stratégique de la filière Eau, du Partenariat Français pour l’Eau et de l’Institut Méditerranéen de l’Eau. Il est aussi partenaire de plusieurs clusters d’entreprises à l’international. Il soutient enfin tous événements susceptibles de valoriser la filière à l’instar du hackathon organisé par le centre international Unesco sur l’eau de
Montpellier - ICIREWARD : la 5ème édition a eu lieu cette année avec 410 participants de 17 pays et 3 continents. Le forum annuel AQUA SÛRETÉ de Nîmes bénéficie également de notre soutien. Tous ces événements convergent vers les Aqua Business Days que nous organisons annuellement.

Pourriez-vous nous donner quelques exemples de projets labellisés par le Pôle Aqua-Valley ?
La réutilisation des eaux usées traitées est abordée dans de nombreux projets tels que Irrialt’eau (irrigation raisonnée de la vigne), SmartFertiReuse (ferti-irrigation de plein champ sur 30 ha) ou encore Zeus (traitement et recyclage des eaux de process industriels). Pour sa part, le projet Neophil porte sur la conception d’une nouvelle génération de membranes, fibres creuses hydrophiles, pour la filtration et le recyclage d’eaux résiduaires urbaines, Matrics se concentre sur la définition de modèles d’écoulement dans les réseaux d’assainissement en vue d’anticiper leur vieillissement tandis que Sirhyus se focalise sur le grand cycle de l’eau pour identifier les réserves constituées en hiver, les confronter aux besoins des agriculteurs et prévenir d’éventuels risques de pénurie. D’autres projets portent sur le développement d’un outil de gestion patrimoniale des réseaux, de solution pour la détection rapide de polluants tels que les cyanobactéries ou encore d’outils pour une gestion plus performante des usages industriels ou publics de l’eau.
Quels sont les enjeux liés au développement économique de la filière régionale de l’eau ?
Pour nos entreprises adhérentes, il y a un triple enjeu d’accès aux marchés internationaux, aux financements européens et à la commande publique, frileuse quand il s’agit d’être la première à utiliser une innovation. Elles doivent aussi intégrer la rareté de l’eau et généraliser les pratiques de reuse et de recyclage dans tous les domaines afin de réduire leur empreinte hydrique. Selon l’ONU, 78 % des activités économiques dépendent de la présence de l’eau. Il est donc urgent d’innover à grande échelle pour partager l’eau et l’économiser : recharge maîtrisée des aquifères, récupération des eaux de pluie, réutilisation des eaux usées traitées pour l’irrigation, l’arrosage et le lavage urbains. Nous devons aussi améliorer nos connaissances sur les nouveaux polluants (microplastiques, fongicides, résidus médicamenteux) pour mieux les éliminer. Enfin, il est crucial d’identifier les formations qui répondront aux métiers de demain - des métiers fortement touchés par la révolution du numérique - et d’accompagner la transition hydrique des territoires pour une meilleure gestion et un partage durable de la ressource en eau.
Publireportage 46 Avril 2023
© Pôle Aqua-Valley
© Pôle Aqua-Valley
Supporting the territories Hydric Transition through innovative solutions
What are the key figures and strategic axes of the Aqua-Valley cluster?
Created in 2011, the Aqua-Valley cluster has 245 members, including 225 companies (84% of which are VSEs, SMEs and startups) representing 4,000 employees and €1.5 billion in turnover. It is one of the 3 founding members of France Water Team, the competitiveness cluster for the water sector, and brings together all the professions in the sector. In addition, it has approved 98 R&D projects for a total budget of nearly €160 million and its team of 10 people is very active in organising some 150 events per year. The Aqua-Valley cluster has identified 4 strategic areas: the identification and mobilisation of water resources, the concerted management of these resources and their uses, the reuse of water from all sources (quality, identification and treatment of pollution), institutional and societal approaches to water and its uses (societal acceptance of innovative solutions for water treatment).


Could you present your service offer to us?
Dedicated, like all clusters, to collaborative innovation, Aqua-Valley supports the economic development of companies to enable them to respond to market needs. Aqua-Valley is a network facilitator with participation in trade fairs, the organisation of technical days, conferences, meetings and training-actions to encourage the creation of innovation consortia and access to new markets. It supports companies in their innovation, export, growth, European project development, standardisation and CSR integration processes to increase their capacity to respond to calls for tender. Within the
framework of the AQUARHESE project, it ensures the proper application of the quality charter for water and wastewater networks, and feeds the reflection on the integrated management of rainwater or the efficiency of networks in urban areas. It also represents its member companies on the strategic committee of the Water sector, the French Water Partnership and the Mediterranean Water Institute. It is also a partner in several international business clusters. Finally, it supports all events likely to promote the sector, such as the hackathon organised by the UNESCO International Centre for Water in Montpellier - ICIREWARD: the 5th edition took place this year with 410 participants from 17 countries and 3 continents. The annual AQUA SÛRETÉ forum in Nîmes also benefits from our support. All these events are converging on the Aqua Business Days that we organise annually.
Could you give us some examples of projects labelled by the Aqua-Valley cluster?
The reuse of treated wastewater is addressed in many projects such as Irrialt’eau (reasoned vine irrigation), SmartFertiReuse (open field fertigation on 30 ha) or Zeus (treatment and recycling of industrial process waters). For its part, the Neophil project focuses on the design of a new generation of hydrophilic hollow fiber membranes for the filtration and recycling of urban wastewater, Matrics concentrates on the definition of flow models in sewage networks with a view to anticipating their ageing, while Sirhyus focuses on the great water cycle to identify the reserves built up in winter, compare them with the needs of farmers and prevent possible risks of shortage. Other projects address
the development of a tool for managing network assets, a solution for the rapid detection of pollutants such as cyanobacteria, and tools for more efficient management of industrial or public water uses.
What are the challenges linked to the economic development of the regional water sector?
For our member companies, there is a triple challenge to access international markets, European funding and public orders, which are reluctant to be the first to use an innovation. They must also integrate water scarcity and generalise reuse and recycling practices in all areas in order to reduce their water footprint. According to the UN, 78% of economic activities depend on water. It is therefore urgent to innovate on a large scale to share and save water: controlled recharging of aquifers, recovery of rainwater, reuse of treated wastewater for irrigation, urban watering and washing. We must also improve our knowledge of new pollutants (microplastics, fungicides, drug residues) to better eliminate them. Finally, it is crucial to identify the training courses that will meet the needs of tomorrow’s professions - professions that will be strongly affected by the digital revolution - and to support the hydric transition of the territories for better management and sustainable sharing of water resources.
Publireportage 47 April 2023
An interview with Mr. Sylvain BOUCHER, President of the Aqua-Valley Cluster
© Pôle
Aqua-Valley
© Pôle
Aqua-Valley
Le Pôle Aqua-Valley : un écosystème de spécialité acteur de la transition hydrique des économies et des territoires
Le Pôle Aqua-Valley fédère un réseau de 245 adhérents (entreprises, organismes de recherche et de formation, associations) principalement localisés en région Occitanie et région Sud, qui représentent notamment l’une des plus fortes concentrations de chercheurs et entreprises du domaine de l’eau.

l’optimisation des investissements des collectivités et des financeurs publics, et à la préservation de l’environnement.
Les acteurs publics et privés sont ainsi informés sur la Charte Qualité des réseaux d’eau potable et d’assainissement, et peuvent s’ils le souhaitent participer aux groupes de travail sur la gestion patrimoniale des réseaux ou la gestion intégrée des eaux pluviales urbaines. Un guide pour les études préalables aux projets de Gestion intégrée des eaux pluviales a ainsi été publié en novembre 2022, disponible en téléchargement https://aqua-valley. com/notre-offre-de-services/aquarhese/
L’objectif du Pôle Aqua-Valley est de contribuer au développement de l’innovation et à la croissance des acteurs de la filière, notamment au niveau des TPE et PME-PMI par l’animation des réseaux d’acteurs, la mutualisation des moyens et la mise en œuvre d’actions collectives couvrant la totalité des métiers et du cycle de l’eau.
Aqua-Valley promeut l’ensemble des métiers de la filière de l’eau, dans une démarche de développement économique régional. Le Pôle accompagne ses adhérents sur les sujets de développement de marchés, d’innovation, de consolidation des compétences, de partenariats et d’internationalisation.
Il s’est structuré depuis 2011 autour de 4 axes stratégiques, révélateurs de la vision de ses fondateurs au regard des impacts des changements globaux sur les ressources en eau et leurs usages, adaptés à son territoire d’action : les 2 bassins hydrographiques du sud de la France.
Forte de cet écosystème de spécialité unique en France, et de sa transversalité sur l’ensemble des métiers et des sujets du domaine de l’eau, la région Occitanie a retenu, dans le cadre de la stratégie
de spécialisation intelligente (S3) du territoire, le domaine d’innovation « Eaux : Économie et gestion maîtrisée, usages et risques ». C’est la seule, parmi l’ensemble des régions européennes, qui présente une spécialisation d’innovation couvrant l’ensemble du cycle de l’eau.
6 ensembles de solutions intégrées pour une transition hydrique 360°
6 ensembles de solutions intégrées ont dans ce contexte été définis, afin de positionner les acteurs du domaine et leurs solutions face aux enjeux et défis de l’eau de demain. Ces solutions sont de surcroît construites en solutions intégrées ou solutions complètes, en associant les savoir-faire individuels des TPE et PME de l’écosystème du Pôle. Des exemples et modèles d’organisation individuelle ou en groupement pour l’export ont également été conçus, afin de préparer les entreprises dans la commercialisation de leurs produits et services.
AQUARHESE : Un projet pour améliorer la qualité des réseaux, et l’efficience des services d’eau et d’assainissement
Le projet AQUARHESE est une animation destinée aux collectivités et aux entreprises du secteur de l’eau. Il contribue à l’amélioration de la qualité des réseaux, à l’efficience des services d’eau et d’assainissement, à
Les Aqua Business Days by Aqua-Valley
Les Aqua Business Days : une convention d’affaires organisée sur 2 jours, rassemblant collectivités, acteurs économiques et académiques autour de conférences, d’ateliers de travail, et de visites de sites. Cet évènement vise, à partir de débats partagés, à favoriser le développement de réponses et solutions concrètes basées sur les compétences métiers des acteurs.
L’édition 2023 aura lieu les 13 et 14 décembre, avec pour thématique « De la sobriété à la transition hydrique : Quelles solutions pour une efficacité durable ? »

Publireportage 48 Avril 2023
© Pôle Aqua-Valley
© Pôle
Aqua-Valley
The Aqua-Valley cluster: a specialised ecosystem for the hydric transition of economies
and territories
The Aqua-Valley cluster federates a network of 245 members (companies, research and training organisations, associations) mainly located in the Occitanie and Sud Regions, which represent one of the highest concentrations of researchers and companies in the water sector.

The objective of the Aqua-Valley cluster is to contribute to the development of innovation and the growth of the sector’s members, particularly at the level of VSEs and SME-SMIs, by coordinating networks of stakeholders, pooling resources and implementing collective actions covering of the water cycle.
Aqua-Valley promotes all the professions in the water sector, with a regional economic development perspective. The cluster supports its members in market development, innovation, skills consolidation, partnerships and internationalisation.
Since 2011, it has been structured around 4 strategic areas, reflecting the vision of its founders with regard to the impacts of global changes on water resources and their uses, adapted to its area of action: the basins of the 2 Water Agencies of southern France.
Considering the strength of this specialised ecosystem, which is unique in France, and its transversal approach to all the professions and subjects in the field of water, the Occitanie region has selected the «Waters: Economy and controlled
management, uses and risks» field of innovation as part of the territory’s smart specialisation strategy (S3). It is the only one, among all the European regions, which presents an innovation specialisation covering the entire water cycle.
6 sets of integrated solutions for a 360° hydric transition
In this context, 6 sets of integrated solutions have been defined, in order to position the sector members and their solutions towards the tomorrow water issues and challenges. These solutions are moreover constructed as integrated or turnkey solutions, by combining the individual know-how of the VSEs and SMEs of the cluster’s ecosystem. Examples and models of individual or group organisation for export have also been designed, in order to prepare companies for the marketing of their products and services.
AQUARHESE: A project to improve the quality of networks and the efficiency of water and sanitation services
The AQUARHESE project is an animation dedicated to local authorities and companies in the water sector. It contributes to the
improvement of network quality, the efficiency of water and sanitation services, the optimisation of investments by local authorities and public financiers, and the preservation of the environment.
Public and private stakeholders are thus informed about the Quality Charter for drinking water supply and sanitation networks, and can, if they wish, participate in the working groups on the management of network assets or the integrated management of urban rainwater. A guide for preliminary studies for Integrated Stormwater Management projects was published in November 2022, available for download at https://aqua-valley.com/ notre-offre-de-services/aquarhese/
Aqua Business Days by Aqua-Valley
The Aqua Business Days: a business convention organised over 2 days, bringing together local authorities, economic actors and academics around conferences, workshops and site visits. This event aims to promote the development of concrete solutions based on the professional skills of the players through shared discussions.
The 2023 edition will take place on 13 and 14 December, with the theme «From sobriety to hydric transition: Which solutions for a sustainable efficiency?”
Pôle Aqua-Valley
Immeuble MIBI
672, rue du Mas de Verchant - CS 37777
F-34967 Montpellier Cedex 02
Tél. : +33 (0)4 34 88 34 45
E-mail : communication@aqua-valley.com
https://aqua-valley.com/
Publireportage 49 April 2023
© Pôle Aqua-Valley
Toulouse INP
Les nouveaux partenariats structurants d’un acteur leader des transitions socio-écologiques, environnementales et numériques
L’Institut national polytechnique de Toulouse fédère 6 écoles d’ingénieurs dont les formations sont stratégiquement adossées aux 14 laboratoires de recherche de l’établissement, partagés avec les grands organismes CNRS et INRAE. Avec 6 000 étudiants en ingénierie et 500 doctorants, les interactions avec les territoires et entreprises d’Occitanie d’une part, de nombreux acteurs nationaux et internationaux d’autre part, sont d’une exceptionnelle intensité comme en témoignent les classements U-Multirank.
Une culture « réflexe » du partenariat sur mesure
Les réflexes partenariaux sont aussi riches que divers au sein de Toulouse INP. Les partenariats envisagés avec les acteurs socio-économiques sont systématiquement conçus sur mesure. L’écoute des besoins, des désirs et des manques ressentis par les partenaires prévaut. Elle se double d’un partage de valeurs qui associe les grandes préoccupations (RH, R&D et RSE) des industriels avec le développement de l’impact académique et sociétal de l’établissement.
Certains acteurs s’engagent avec Toulouse INP dans des dispositifs de co-formation (parrainage de promotions, interventions en enseignement, contrats d’apprentissage et de professionnalisation). Des entreprises adossent leur R&D sur Toulouse INP selon diverses modalités (laboratoires communs, projets collaboratifs, contrats directs, prestations et transferts technologiques). D’autres partenaires associent co-formation et recherche autour de chaires industrielles qui bénéficient fiscalement du mécénat (recherche et innovation ouvertes, soutien aux activités des élèves ingénieurs, création de think-tank). Deux exemples emblématiques de nouveaux partenariats structurants sont illustrés ci-après.
Plateforme Hydrogène de Toulouse : l’hydrogène-énergie au service de l’industrie C’est en 2019 que le laboratoire LAPLACE a inauguré sa Plateforme Hydrogène de 650 m² sur le campus de Toulouse INP. Sa vocation : réaliser des travaux de recherche sur les utilisations et la production de l’hydrogène et accompagner les industriels dans ce domaine. Fonctionnant depuis 2010, cette plateforme héberge aujourd’hui 3 autres laboratoires aux compétences complémentaires : le CIRIMAT (matériaux), le LGC (génie chimique) et l’IMFT (mécanique des fluides), sous tutelle du CNRS, de Toulouse INP et de l’université Toulouse III - Paul Sabatier.

La Plateforme Hydrogène de Toulouse fait désormais partie des plus importantes
plateformes de recherche françaises sur les technologies hydrogène. « Nous avons déjà mis en place 30 bancs d’essais, dont 19 pour les piles à combustible, et d’autres bancs d’essais sont en cours de fabrication. Nos activités sont menées en collaboration avec de grands industriels dont Safran, Airbus ou encore Helion Hydrogen Power (Alstom), ou des grands instituts de recherche et développement comme par exemple l’IRT Saint-Exupéry » explique Christophe Turpin, Directeur de Recherche CNRS au Laboratoire Plasma et Conversion d’Energie. La Plateforme Hydrogène de Toulouse facilite la mise en place de nouveaux partenariats industriels et académiques en vue d’optimiser le développement de l’hydrogène-énergie dans l’industrie, et notamment l’aéronautique ou le ferroviaire.
Au cours de l’année 2025, l’ensemble de la Plateforme Hydrogène de Toulouse déménagera sur le site de Francazal (Cugnaux, près de Toulouse) où le « Technocampus Hydrogène Occitanie » est en train d’être développé (35 M€ d’infrastructure, 17 M€ d’équipements scientifiques) sous son pilotage scientifique et technique. Il comportera une surface proche de 10 000 m². Outre le regroupement de toutes les expérimentations autour des technologies de l’hydrogène des quatre laboratoires impliqués, il offrira une approche intégrée formation pratique / recherche bas TRL (niveaux de maturité) / recherche hauts
TRL, permettant un accueil d’essais industriels jusqu’à 1 MW.
OneStock : la chaire Retail Responsable Toulouse INP, le CNRS et OneStock ont officialisé le 28 septembre 2022 le lancement d’une chaire de Recherche et de Formation dédiée au Retail Responsable. Confiée au Dr Sandra Ulrich Ngueveu, elle s’appuie sur l’équipe « Recherche Opérationnelle, Optimisation Combinatoire, Contraintes » du laboratoire LAAS-CNRS (Laboratoire d’analyse et d’architecture des systèmes). Elle aborde le principal défi du commerce omnicanal : aller vers un mode de consommation plus respectueux de l’environnement.
Les travaux se focaliseront sur l’optimisation de la performance environnementale des livraisons confiées à de multiples transporteurs et provoquées par la multiplication des canaux de commande et des points de distribution (entrepôts, boutiques). Innover pour mieux maîtriser l’impact environnemental en s’appuyant sur les dernières avancées en Recherche Opérationnelle et Intelligence Artificielle : un objectif qui s’inscrit parfaitement dans la stratégie de OneStock, le leader européen de l’OMS (Order Management System). La chaire contribue au sein de Toulouse INP–ENSEEIHT à la formation des nouvelles générations d’ingénieurs, acteurs majeurs des transitions socio-écologiques et numériques.
Publireportage 50 Avril 2023
© Région Occitanie/CTV Architecte
Vue depuis la voie royale du futur Technocampus Hydrogène à Francazal / View from the main road of the future Hydrogen Technocampus in Francazal
Une transformation pour répondre aux défis d’aujourd’hui et de demain Centrale Toulouse Institut : c’est sous ce nouveau nom que Toulouse INP se réinvente pour devenir un établissement leader des transitions socio-écologiques, environnementales et numériques. Une opportunité de rejoindre le Groupe des Ecoles Centrale (GEC) et de repenser son offre globale de formation d’ingénieurs de haut niveau scientifique, responsables, dotés d’une vision systémique ou plus spécialisée.
Toulouse INP vient enrichir le GEC en apportant son amplitude disciplinaire (sciences et ingénierie pour la matière, le vivant, l’énergie, l’environnement et le numérique) au sein du grand Sud-Ouest, un territoire attractif pour les étudiants comme pour les entreprises. Les partenariats structurants sont en effet l’un des éléments de la démarche de transformation qui favorisent la pluridisciplinarité. Avec, à la clé, une attractivité et une visibilité accrues aux échelles locale, nationale et internationale grâce aux implantations du GEC au Maroc, en Chine et en Inde. De son côté,
Toulouse INP apportera sa contribution, ses réseaux internationaux et son savoir-faire en matière de montage de projets internationaux et d’ingénierie pédagogique.

L’organisation du futur établissement sera affinée d’ici 2024 avec un plan d’accompagnement de tous les personnels, le processus d’accréditation CTI puis une première rentrée des élèves ingénieurs en septembre 2025 pour une première diplomation en 2028.
Toulouse INP est un des 7 membres fondateurs de l’Université de Toulouse (UT) dont les nouveaux statuts de janvier 2023 témoignent de la marche du site vers une Grande Université de Recherche. Cette transformation est préfigurée par le projet TIRIS, Toulouse Initiative for Research’s Impact on Society, lauréat de l’appel à projets « Excellence sous toutes ses formes - ExcellencES ». Totalement engagée dans la politique de site, Toulouse INP contribue à ce projet scientifique par sa transformation en un nouvel établissement tourné vers les besoins de la société, des entreprises et des territoires.
Toulouse INP
De gauche à droite et de haut en bas :
Martial Coulon, responsable relations entreprises INP-ENSEEIHT, Jean-François Rouchon, Directeur INP-ENSEEIHT, Catherine Lambert, Vice-Présidente N7Dev, Sandra Ulrich Ngueveu, titulaire de la chaire, Christophe Giraud, ancien délégué régional CNRS Occitanie Ouest, Catherine Xuereb, Présidente Toulouse INP, Mohamed Kaâniche, Directeur LAAS-CNRS, Thierry Bosch, Vice-Président relations entreprises Toulouse INP, Romulus Grigoras, PDG OneStock. / From left to right and top to bottom: Martial Coulon, INP-ENSEEIHT corporate relations manager, Jean-François Rouchon, INP-ENSEEIHT Director, Catherine Lambert, N7Dev Vice-President, Sandra Ulrich Ngueveu, chairholder, Christophe Giraud, former CNRS Occitanie Ouest regional delegate, Catherine Xuereb, Toulouse INP President, Mohamed Kaâniche, LAAS-CNRS Director, Thierry Bosch, Toulouse INP Corporate Relations Vice-President, Romulus Grigoras, OneStock CEO.

The new structuring partnerships of a leading player in socio-ecological, environmental and digital transitions
The Institut National Polytechnique de Toulouse is a federation of 6 engineering schools whose courses are strategically linked to the 14 research laboratories of the institution, shared with the major organizations CNRS and INRAE. With 6,000 engineering students and 500 doctoral students, the interactions with the territories and companies of Occitania on the one hand, and with numerous national and international players on the other, are exceptionally intense, as shown by the U-Multirank rankings.
A«reflex» culture of customized partnerships
The partnership reflexes are as rich as they are diverse within Toulouse INP. The partnerships envisaged with the socio-economic players are systematically tailored to their needs. We listen to the needs, desires and shortcomings felt by our partners. This is coupled with a sharing of values that combines the major concerns (HR, R&D and CSR) of industrialists with the development of the academic and societal impact of our institution.
Certain players are involved with Toulouse INP in co-training programs (sponsorship of graduating classes, teaching interventions, apprenticeship and professionalization contracts). Some companies back their R&D at Toulouse INP in various ways (joint laboratories, collaborative projects, direct contracts, services and technology transfers).
Other partners associate co-training and research through industrial chairs that benefit fiscally from sponsorship (open research and innovation, support for
engineering students’ activities, creation of think-tanks). Two emblematic examples of new structuring partnerships are illustrated below.
Publireportage 51 April 2023
© Toulouse INP
Aerial view of the future Hydrogen Technocampus in Francazal Vue aérienne du futur Technocampus Hydrogène à Francazal
© Région Occitanie/CTV Architecte
Toulouse Hydrogen Platform: hydrogen energy for industry
In 2019, the LAPLACE laboratory inaugurated its 650 m² Hydrogen Platform on the Toulouse INP campus. Its vocation: to carry out research on the uses and production of hydrogen and to support industrialists in this field. The platform has been in operation since 2010 and today houses three other laboratories with complementary skills: CIRIMAT (materials), LGC (chemical engineering) and IMFT (fluid mechanics), under the supervision of the CNRS, Toulouse INP and the University of Toulouse III - Paul Sabatier.

The Toulouse Hydrogen Platform is now one of the most important French research platforms for hydrogen technologies. «We have already set up 30 test benches, including 19 for fuel cells, and other test benches are being built. Our activities are carried out in collaboration with major industrial companies such as Safran, Airbus and Helion Hydrogen Power (Alstom), as well as major research and development institutes such as IRT Saint-Exupéry,» explains Christophe Turpin, CNRS Research Director at the Plasma and Energy Conversion Laboratory. The Toulouse Hydrogen Platform facilitates the establishment of new industrial and academic partnerships in order to optimize the development of hydrogen energy in industry, particularly in the aeronautics and rail sectors.
In 2025, the entire Toulouse Hydrogen Platform will move to the Francazal site (Cugnaux, near Toulouse) where the «Technocampus Hydrogène Occitanie» is being developed (€35M infrastructure, €17M scientific equipment) under its scientific and technical management. It will have a surface area of nearly 10,000 m². In addition to grouping together all the hydrogen technology experiments of the four laboratories involved, it will offer an integrated approach to practical training /
low TRL research (maturity levels) / high TRL research, allowing industrial trials to be hosted up to 1 MW.
OneStock: the Responsible Retail Chair
On September 28, 2022, Toulouse INP, the CNRS and OneStock officially launched a research and training chair dedicated to Responsible Retail. The chair is headed by Dr. Sandra Ulrich Ngueveu and is based on the «Operational Research, Combinatorial Optimization, Constraints» team of the LAAS-CNRS laboratory (Systems Analysis and Architecture Laboratory). It addresses the main challenge of omnichannel commerce: moving towards a more environmentally friendly mode of consumption.
The work will focus on optimizing the environmental performance of deliveries entrusted to multiple carriers and caused by the multiplication of order channels and distribution points (warehouses, stores). Innovating to better control the environmental impact by using the latest advances in Operational Research and Artificial Intelligence: an objective that fits perfectly with the strategy of OneStock, the European leader in OMS (Order Management System). Within Toulouse INP-ENSEEIHT the chair contributes to the training of new generations of engineers, who are major players in socio-ecological and digital transitions.
A transformation to meet the challenges of today and tomorrow
Centrale Toulouse Institute: under this new name, Toulouse INP is reinventing itself to become a leader in socio-ecological, environmental and digital transitions. An opportunity to join the Groupe des Ecoles Centrale (GEC) and to rethink its global training offer for engineers of a high scientific level, responsible, with a systemic or more specialized vision.
Toulouse INP has enriched the GEC by bringing its disciplinary breadth (sciences and engineering for matter, life, energy,
the environment and digital technology) within the Greater Southwest, a region that is attractive to students and companies alike. Structuring partnerships are one of the elements of the transformation process that promotes multidisciplinarity. The result is increased attractiveness and visibility at the local, national and international levels thanks to the GEC’s locations in Morocco, China and India. For its part, Toulouse INP will bring its contribution, its international networks, and its knowhow in setting up international projects and educational engineering.
The organization of the future institution will be refined between now and 2024 with a support plan for all the personnel, the CTI accreditation process, and the first intake of engineering students in September 2025 for a first graduation in 2028.
Toulouse INP is one of the 7 founding members of the University of Toulouse (UT), whose new statutes of January 2023 testify to the site’s progress towards a Large Research University. This transformation is prefigured by the TIRIS project, Toulouse Initiative for Research’s Impact on Society, winner of the «Excellence in all its forms - ExcellencES» call for projects. Fully committed to the site policy, Toulouse INP is contributing to this scientific project by transforming itself into a new institution focused on the needs of society, businesses and territories.
Toulouse INP
6, allée Emile Monso - BP 34038
F-31029 Toulouse Cedex 4
Tél. : +33 (0)5 34 32 30 00
E-mail : inpact@toulouse-inp.fr

http://www.inp-toulouse.fr/

Publireportage 52 Avril 2023
©
©
Toulouse INP
Freepik
NOS DOMAINES DE COMPÉTENCES

Mécanique
Matériaux
Procédés
Robotique
Mécatronique de puissance
Numérique
Réalité virtuelle
Intelligence arti cielle Systèmes intelligents
UNE ÉCOLE INNOVANTE OUVERTE SUR LE MONDE EN PHASE AVEC LE MILIEU INDUSTRIEL
Depuis 60 ans, l’École Nationale d’Ingénieurs de Tarbes s’investit pour développer des actions de progrès et accompagner les entreprises à relever leurs nombreux dé s.




FORMATION
Formation tout au long de la vie VAE
Formation des ingénieurs de demain


INNOVATION
Contrats de Recherche
Expertises
Plateformes technologiques
RECRUTEMENT
Stages
Alternance
Job dating
Conférences Industrielles

53 April 2023
École Nationale d’Ingénieurs de Tarbes 47, avenue d’Azereix BP 1629 65016 Tarbes Cedex 05 62 44 27 00
École d’Ingénieurs de PURPAN Une recherche appliquée au service de la transition agroécologique

Créée en 1919, l’École d’Ingénieurs de PURPAN est une « institution » en matière de formation et recherche pour les mondes agricoles et agroalimentaires dans le Sud-Ouest. Ses approches et outils de recherche originaux répondent aux besoins du terrain. Grâce à son fort ancrage territorial, elle bénéficie régulièrement du soutien de l’Occitanie.
Proposant 2 formations (bac+3 et bac+5) à ses plus de 1 500 étudiants par an, l’École délivre chaque année plus de 300 diplômes. Elle s’appuie sur 2 campus, 5 départements de recherche, 8 plateformes et laboratoires ainsi que sur 160 collaborateurs, dont 75 enseignants-chercheurs qui portent 80 publications par an et qui, pour deux tiers, appartiennent à des Unités Mixtes de Recherche (UMR). Elle a aussi créé une Unité Propre de Recherche (UPR) : Physiologie, pathologie et génétique végétale (PPGV). L’École d’Ingénieurs de PURPAN est l’une des rares écoles d’ingénieurs à posséder une véritable exploitation agricole : d’une superficie de 250 ha, conçue comme un outil productif, pédagogique, de recherche et de rayonnement, elle mobilise 8 à 10 salariés et rassemble un atelier de 120 vaches laitières, un atelier aviculture, des parcelles pour l’alimentation du bétail et la production de céréales, un atelier de méthanisation ainsi que des micro-parcelles à des fins expérimentales. Un véritable démonstrateur ouvert aux scolaires comme au grand public lors de journées dédiées pour permettre à tous de redécouvrir l’agriculture.
PURPAN a structuré ses activités de recherche autour de 5 départements (Sciences Végétales et Agronomie, Sciences
Animales et Systèmes d’Élevage, Sciences de l’Agroalimentaire et de la Nutrition, Sciences de l’Environnement et numérique, Sciences Humaines, Économiques et Sociales) et de plateformes mutualisées de recherche, ayant bénéficié de soutiens financiers notamment de la Région Occitanie : la Halle de technologies Agroalimentaires, la Plateforme TOAsT (technologies oxydatives pour l’agriculture et l’agroalimentaire sur Toulouse), la Plateforme TFFFC (Toulouse FieldFlow Fractionation Center, reconnue via ses outils de chimie analytique pour la caractérisation de molécules de très grande taille), des laboratoires d’analyses physico-chimiques, de microbiologie et de biologie moléculaire, la Plateforme Agronomique, de Physiologie & d’Amélioration des plantes, le Living Lab Vaches Laitières & Aviculture, l’Atelier Méthanisation / Carbone / Énergie et l’Observatoire de la Biodiversité.

Sur la base de ces outils différenciants, l’École poursuit une recherche pluridisciplinaire et diversifiée qui l’amène à avoir, entre autres, défini des schémas de sélection adaptés à la production locale de variétés de stévia à haute valeur ajoutée (avec L’Epi Salvagnacois et Pepsico), développé des alternatives aux produits phytosanitaires à base d’ozone pour la protection
des cultures et le traitement post-récolte des fruits et légumes (avec BlueWhale, Compagnie fruitière, Absoger, …), amélioré les systèmes de productions animales en misant sur les écosystèmes microbiens et les additifs alternatifs (avec Ajinomoto et Lallemand), étudié la féminisation de la filière viti-vinicole en Occitanie ou encore élaboré un levain lactique de terroir pour l’AOP Rocamadour (avec Les Fermiers du Rocamadour et la Ferme des Champs-Bons).
Cette structuration permet à l’École de répondre aux enjeux économiques, sociétaux, climatiques, énergétiques auxquels les secteurs agricoles et agroalimentaires font face, et d’accompagner le monde agricole dans ses transitions sociologique (féminisation, transmission…), numérique (robotisation, télédétection…) et agroécologique. À ce titre, l’École est évidemment attentive aux orientations portées par les élus et qui s’inscrivent dans cette volonté. Comme, par exemple : l’autorisation – attendue – du déploiement de solutions alternatives à base d’ozone, pour l’agriculture et l’agroalimentaire, que d’autres pays que la France ont d’ores et déjà entérinées.
À noter, enfin, que PURPAN envisage de créer une école vétérinaire pour compléter ses actions de recherche et de formation.
Publireportage 54 Avril 2023
Campus de Lamothe vu du ciel / Lamothe campus from the air
©
Campus de Lamothe – Living Lab Vaches Laitières / Lamothe Campus - Living Lab Dairy Cows
G. Olivier © G. Olivier
PURPAN School of Engineering Applied research for the agro-ecological transition
Created in 1919, the PURPAN School of Engineering is an «institution» in terms of training and research for the agricultural and agri-food worlds in the South-West. Its original research approaches and tools meet the needs of the field. Thanks to its strong territorial roots, it regularly benefits from the support of the Occitanie Region.

Offering 2 courses (bac+3 and bac+5) to its more than 1,500 students per year, the School awards more than 300 diplomas each year. It has two campuses, five research departments, eight platforms and laboratories and 160 employees, including 75 teacher-researchers who publish 80 publications a year and two-thirds of whom belong to Joint Research Units (UMR). It has also created its own research unit (UPR): Plant Physiology, Pathology and Genetics (PPGV). The PURPAN School of Engineering is one of the few engineering schools to have a real farm: with a surface area of 250 ha, designed as a productive, educational, research and outreach tool, it employs 8 to 10 people and includes a workshop with 120 dairy cows, a poultry farming workshop, plots of land for cattle feed and cereal production, a methanisation workshop as well as micro plots for experimental purposes. A real demonstrator open to schoolchildren and the general public on dedicated days to allow everyone to rediscover agriculture.
PURPAN has structured its research activities around 5 departments (Plant Sciences and Agronomy, Animal Sciences and Breeding Systems, Food and Nutrition Sciences, Environmental and Digital Sciences, Human, Economic and Social Sciences) and shared research platforms, which have received financial support from the Occi-
tanie Region in particular: the Food Technology Hall, the TOAsT Platform (oxidative technologies for agriculture and agri-food in Toulouse), the TFFFC Platform (Toulouse Field-Flow Fractionation Center, known for its analytical chemistry tools for the characterisation of very large molecules), physico-chemical analysis, microbiology and molecular biology laboratories, the Agronomy, Physiology & Plant Improvement Platform, the Dairy Cows & Poultry Living Lab, the Methanisation / Carbon / Energy Workshop and the Biodiversity Observatory.

On the basis of these differentiating tools, the School pursues multidisciplinary and diversified research which has led it to have, among other things, defined breeding schemes adapted to the local production of high value-added stevia varieties (with L’Epi Salvagnacois and Pepsico), developed alternatives to ozone-based phytosanitary products for crop protection and post-harvest treatment of fruit and vegetables (with BlueWhale, Compagnie fruitière, Absoger,...), improved animal production systems by focusing on microbial ecosystems and alternative additives (with Ajinomoto and Lallemand), studied the feminisation of the wine industry in Occitania and developed a local lactic sourdough for the Rocamadour PDO (with Les Fermiers du Rocamadour and the Ferme des Champs-Bons).
This structure enables the School to respond to the economic, societal, climatic and energy challenges facing the agricultural and agri-food sectors, and to support the agricultural world in its sociological (feminisation, transmission, etc.), digital (robotisation, remote sensing, etc.) and agro-ecological transitions. In this respect, the School is obviously attentive to the orientations taken by the elected representatives which are in line with this desire. For example, the expected authorisation of the deployment of alternative ozone-based solutions for agriculture and the agri-food industry, which other countries than France have already approved.
Finally, it should be noted that PURPAN plans to create a veterinary school to complement its research and training activities.
École d’Ingénieurs de PURPAN
75, voie du Toec - BP57611
F-31076 Toulouse Cedex 3
Tél. : +33 (0)5 61 15 30 30
E-mail : frederic.violleau@purpan.fr
https://www.purpan.fr/
Publireportage 55 April 2023
Toulouse Campus / Campus de Toulouse
Storage chamber of the TOAsT platform / Chambre de stockage de la plateforme TOAsT
© École
d’Ingénieurs de PURPAN © École d’Ingénieurs de PURPAN
Occitanie :
vers une « Région à énergie positive »

Hydrogène vert, éolien flottant, solaire : la Région Occitanie se mobilise pour décarboner l’industrie, la mobilité et la production d’énergie. Acteurs académiques, industriels et pouvoirs publics mutualisent leurs compétences de R&D, d’innovation et d’accompagnement au service d’une autonomie énergétique accrue et d’une compétitivité renforcée.
Désireuse d’être un acteur de premier plan de la transition énergétique, la Région Occitanie pousse la filière hydrogène vert avec un plan doté de 150 M€ pour encourager sa production, sa distribution et ses usages. Produit à partir d’énergies renouvelables comme l’éolien et le solaire, l’hydrogène vert permet la décarbonation des transports et le stockage des énergies renouvelables. C’est un élément-clé de l’ambition « Région à énergie positive ».
Soutenus par la Région Occitanie, de nombreux projets innovants se développent dans la recherche, les transports et l’industrie. Du côté de Toulouse, la Région est impliquée avec le CNRS, l’université de Toulouse, Safran, Airbus et d’autres grands groupes et laboratoires dans le projet de Technocampus Hydrogène à Francazal, qui sera le plus grand centre français de recherche, d’essai, d’innovation technologique et d’enseignement sur l’hydrogène à l’horizon 2024. Réunissant industriels et chercheurs, ce projet à 40 M€ aura pour première application « l’avion vert » (essais pour les moteurs à hydrogène des avions du futur). Pour sa part, Hyport se met en place dans la zone aéroportuaire de Toulouse-Blagnac. Toute première unité de production d’hydrogène vert au monde,
cette société, dont la Région Occitanie est actionnaire via l’Agence Régionale Énergie Climat (AREC), alimentera notamment bus et véhicules légers.
Dans les Hautes-Pyrénées, une unité similaire verra le jour à l’aéroport de Tarbes-Lourdes-Pyrénées tandis que, dans l’Hérault, Béziers accueille Genvia : lancée en mars 2021, la nouvelle société commune (Schlumberger New Energy, CEA, Vicat, Vinci, la Région à travers l’AREC) se focalise sur la production d’hydrogène décarboné à partir d’une technologie de rupture de l’électrolyse du CEA qui permet une production beaucoup plus compétitive. L’activité de Genvia s’intègre dans l’usine Cameron de Béziers appartenant à Schlumberger.
De même, Hyd’Occ est une société détenue par Qair Premier Élément et l’AREC à Port-la-Nouvelle dans l’Aude. Son objectif : disposer à terme d’une

capacité de production de 50 MW (megawatts) d’hydrogène renouvelable par électrolyse. Hyd’Occ est l’un des trois lauréats du premier appel à projets lancé dans le cadre de Corridor H2.
Par ailleurs, quinze autocars liO alimentés à l’hydrogène doivent être mis en service en 2023 par la Région Occitanie sur les lignes Albi - Saint-Sulpice-La-Pointe et Albi - Saint-Sulpice-La-Pointe - Lavaur. Ils seront rétrofités, c’est-à-dire convertis à l’hydrogène par l’entreprise locale Safra, conceptrice du bus hydrogène Businova. Cette conversion de cars liO s’inscrit dans le projet Corridor H2 qui comporte également le déploiement d’ici deux ans de 40 camions à propulsion hydrogène et de 62 remorques / unités frigorifiques. En complément, la Région Occitanie mettra en service un premier train bimode électrique/hydrogène en 2025 sur la ligne Toulouse-Montréjeau-Luchon, en faisant l’acquisition de trois rames qui seront construites par Alstom, dont l’usine de Tarbes (Hautes-Pyrénées) supervisera la partie hydrogène. Ces trois rames fonctionneront avec de l’hydrogène vert entre Luchon et Montréjeau et en mode électrique sur les voies électrifiées entre Montréjeau et Toulouse. En Occitanie, cette liaison ferroviaire constituera une ligne pilote électrique / hydrogène. Objectifs : éprouver les avantages apportés par ces trains et identifier quelles sont les lignes où l’hydrogène constituera la solution la plus adéquate.
La Région a également lancé la transformation écologique « Green Harbour » du port de Sète-Frontignan et contribue aux études d’un projet « d’hydrogène à quai ». Chiffré à 13 M€, ce projet piloté par la société Nexeya, basée à Toulouse, implique une barge chargée d’hydrogène et une pile à combustible pour fournir de l’électricité aux bateaux à quai. À Port-la-Nouvelle, l’AREC et l’opérateur Qair projettent une usine de production d’hydrogène vert pour alimenter un réseau de distribution le long de l’A9, au port de Sète, et stocker l’énergie électrique produite par le futur parc éolien flottant Eolmed.
56 Avril 2023
© Gyrostat (Wikimedia, CC-BY-SA 4.0)
L’aéroport de Toulouse-Blagnac accueille Hyport, la toute première unité de production d’hydrogène vert qui alimentera notamment bus et véhicules légers. / Toulouse-Blagnac airport is home to Hyport, the very first green hydrogen production unit that will supply buses and light vehicles.
Si elle encourage la production d’hydrogène, la Région Occitanie va intervenir aussi sur sa distribution. Lors du Forum Energaïa en décembre 2020, la présidente de Région Carole Delga a signé avec la Banque Européenne d’Investissement un contrat de prêt de 40 M€ pour financer le « Corridor H2 » : ce projet unique en Europe de 110 M€, monté par la Région avec Ad’Occ et l’AREC, comprend des stations de production et de distribution d’hydrogène sur un axe Méditerranée-mer du Nord et les autoroutes d’Occitanie.
La Région Occitanie participe aussi à une expérimentation sur le bus à hydrogène avec le constructeur albigeois Safra. Son appel à projets « Territoires d’Hydrogène » visait à encourager les écosystèmes locaux de mobilité hydrogène, comme le projet de flotte de bus à hydrogène de la métropole de Montpellier et celui de stations de production-distribution « OccHyTarn ». La Région subventionne aussi (à 50 %) le déploiement de véhicules hydrogène pour du transport professionnel de personnes ou de marchandises. Toutes ces actions vont pousser les emplois « verts » : une étude impulsée par la Cité de l’Économie et des Métiers de Demain auprès de 150 structures de la filière hydrogène (comme Safra, Qair,
Cameron, EDF, Engie…) envisage la création de plus de 4 000 emplois d’ici à 2024, dont plus de 2 000 en Occitanie.
Éolien flottant : une nouvelle filière industrielle
L’éolien flottant devrait créer localement près de 3 000 emplois directs, indirects ou induits. La Région Occitanie mène différentes actions pour favoriser le développement de cette filière avec l’ambition de devenir la première région à énergie positive d’Europe à horizon 2050. Propriétaire du Port-La-Nouvelle (Aude), idéalement situé au carrefour des zones les plus ventées du Golfe du Lion, elle investit plus de 230 M€ pour étendre le port et le doter d’infrastructures portuaires nécessaires pour permettre la construction, l’assemblage, l’exploitation et la maintenance d’éoliennes flottantes. Deux fermes pilotes, EFGL (Leucate) et EolMed (Gruissan et Port-la-Nouvelle), seront opérationnelles à partir de 2023 et emploieront chacune une quarantaine de personnes pour les opérations de maintenance et de logistique maritimes.
Au-delà des emplois projetés, cette activité est également source d’innovation. À ce titre, la Région Occitanie a mis en place une stratégie de développement de cette filière
industrielle : Wind’Occ, une démarche collective regroupant 170 entreprises régionales recensées comme contribuant ou pouvant contribuer à la chaîne de valeur de l’éolien en mer et localisées sur tout le territoire. Parmi elles, Valeco, Qair, MP ArchiMed ou encore Ocean Winds.

Les énergies renouvelables appliquées au bâtiment et à l’industrie Développer aux niveau régional, national et international l’innovation, la recherche, la formation, le transfert de technologie, le développement et la création d’entreprises dans le domaine des énergies renouvelables appliquées au bâtiment et à l’industrie : c’est l’objectif du pôle de compétitivité Derbi. Basé à Perpignan avec une antenne à Montpellier et une à Toulouse, il rassemble plus de 200 membres qui agissent et innovent en région Occitanie pour la transition énergétique.
Solaire, bâtiment durable, éolien, biomasse énergie, stockage d’énergie, géothermie basse température, réseaux intelligents, numérique, hydraulique, hydrogène et gaz « vert » sont les filières d’excellence de Derbi qui se positionne comme un partenaire clef de la Région Occitanie qu’il a accompagnée dans la définition de sa stratégie Région à Energie
57 April 2023
La Région a lancé la transformation écologique « Green Harbour » du port de Sète-Frontignan et contribue aux études d’un projet « d’hydrogène à quai ». / The Region has launched the «Green Harbour» ecological transformation of the port of Sète-Frontignan and is contributing to the studies of a «quayside hydrogen» project.
© Lundeux (Wikimedia, CC-BY-SA 2.5)
Positive à l’horizon 2050 et dans l’élaboration de l’axe « transition énergétique » de sa Stratégie Régionale de l’Innovation (SRI).

L’objectif majeur de Derbi est d’accélérer l’émergence et la commercialisation de produits et de services innovants sur des marchés en fort développement portés par la demande internationale, les directives européennes sur l’énergie et la transition énergétique en France. Son activité se structure autour de 3 Domaines d’Activités Stratégiques (DAS) représentatifs de la chaîne de valeur des systèmes énergétiques (de la production à la consommation finale en passant par la gestion des réseaux), renforcés par 2 DAS transverses relatifs d’une part aux enjeux de l’utilisation croissante des technologies du numérique et du digital dans les systèmes énergétiques, et d’autre part aux questions sociétales associées aux évolutions de ces systèmes.
Depuis 2006 Derbi a labellisé 366 projets dont 213 projets financés pour un investissement global de 475 M€ dont 185 M€ de financements publics. Entre 2020 et 2022 le Pôle s’est engagé dans deux projets de coopération transfrontalière dans le cadre du Programme Interreg V-A Espagne - France - Andorre (POCTEFA 2014-2020), cofinancé par le FEDER. Le projet EKATE portait sur la gestion de l’énergie renouvelable photovoltaïque en autoconsommation partagée dans l’espace transfrontalier France / Espagne, avec les technologies « Blockchain » et « Internet of Things (IoT). Il était issu d’un partenariat entre six structures transfrontalières, l’ESTIA (pilote du projet), Derbi et TECSOL en France, l’Université du Pays Basque, le CIMNE et ENERCLUSTER en Espagne. Pour sa part, le projet EDIFICAT portait sur le secteur de l’efficacité énergétique de part et d’autre des Pyrénées, aux côtés de la mairie de Gérone (pilote du projet), de l’agglomération de Perpignan et du cluster catalan pour l’efficacité énergétique CEEC. L’objectif : mettre en place des conditions favorables à une réorientation du secteur de la construction vers une activité plus durable et qualitative, par un travail transfrontalier de mise en relation, de formation et de collaboration entre entreprises et professionnels du bâtiment.

Par ailleurs, le Pôle Derbi collabore régulièrement avec des consortiums en s’associant notamment à des projets des membres de la Smart Energy Alliance et de ses partenaires régionaux et européens. C’est le cas de DIAGTASE : lauréat de l’Appel à manifestation d’intérêt « Compétences et Métiers d’Avenir »
lancé par l’État dans le cadre de France 2030 (PIA4) et opéré par l’Agence nationale de la recherche (ANR) et la Caisse des dépôts et consignations (CdC), ce projet clôturé en décembre 2022 répond au volet 1 « Diagnostic » de la Stratégie d’accélération « Technologie avancée pour les systèmes énergétiques » (TASE). Il regroupe un consortium de 4 partenaires : l’École Nationale d’Ingénieurs de Tarbes, porteur du projet, le Campus des Métiers et des Qualifications d’Excellence «Habitat, Energies Renouvelables et EcoConstruction» (CMQE-HEREC), le Campus des Métiers et des Qualifications «Transition Energétique» (CMQ-TE) et Derbi. Il a permis la réalisation d’un diagnostic des emplois et compétences dans la thématique TASE, ciblé sur les filières éolien offshore, photovoltaïque et réseaux énergétiques en Occitanie. S’appuyant sur cette étude, le consortium proposera une évolution ou la création d’une offre de formation à déployer pour répondre à ces attentes. Pour le Campus CMQE-HEREC, le diagnostic viendra consolider et/ou réorienter les actions menées dans le cadre du projet PIA3 «Territoire d’innovation pédagogique» (2020-2030). Les formations proposées dans l’éolien, le photovoltaïque et le pilotage par les smart grids seront particulièrement concernées par les préconisations issues de l’étude. Cette dernière permettra au Campus CMQ-TE d’affiner la co-construction du projet pilote MOSAHYC, une plateforme de formation, d’innovation et de R&D sur les énergies renouvelables et les réseaux intelligents «smart grids».

Autre projet innovant auquel participe Derbi : Flexitanie, le premier démonstrateur V2G. Ce projet cible le déploiement sur le territoire de 100 bornes bidirectionnelles de recharge de véhicules électriques reposant sur la technologie V2G, Vehicle-to-Grid. L’action est menée conjointement par la Région Occitanie, l’Ad’Occ, l’ADEME et le groupe EDF, en partenariat avec Leader Occitanie, l’AVERE ainsi que la CleanTech Vallée. De la formation à la mobilité, un seul mot d’ordre : revoir entièrement notre rapport à l’énergie et ses usages1.

Occitanie : un plan Hydrogène Vert ambitieux Ambitionnant d’être la première Région à énergie positive à l’horizon 2050, l’Occitanie est la toute première Région de France à se doter d’un plan Hydrogène Vert. D’un montant de 150 M€ pour la période 2019-2030, ce plan ambitieux est réalisé par étapes. D’ici 2024, il prévoit la création d’un site de production massive d’hydrogène renouvelable, de 20 stations hydrogène, des trois rames électrique / hydrogène et la mise en service de 600 véhicules hydrogène lourds, utilitaires et légers. Entre 2024 et 2030, deux autres sites de production massive, 55 stations et plus de 3 000 véhicules s’ajouteront.
Couvrant l’ensemble de la chaîne de valeur - production, distribution et usages -, ce plan bénéficie d’un soutien de l’État et de l’ADEME, l’Agence de la transition écologique. Son corollaire, Corridor H2, est soutenu à hauteur de 14,5 M€ par l’Union européenne ainsi que par la Banque Européenne d’Investissement au travers d’un prêt d’un montant de 40 M€ accordé à la Région Occitanie2.

58 Avril 2023
Un projet du pôle de compétitivité DERBI / A project of the DERBI competitiveness cluster
1 Source : Pôle Derbi.
2 Source : Région Occitanie.
© Pôle DERBI
Occitania: towards a “positive energy region”


Green hydrogen, floating wind power, solar energy: the Occitanie Region is mobilising to decarbonise industry, mobility and energy production. Academic players, industrialists and public authorities are pooling their R&D, innovation and support skills to achieve greater energy autonomy and enhanced competitiveness.
Eager to be a leading player in the energy transition, the Occitanie Region is pushing the green hydrogen sector with a €150 million plan to encourage its production, distribution and use. Produced from renewable energies such as wind and solar, green hydrogen allows the decarbonisation of transport and the storage of renewable energies. It is a key element of the «Positive Energy Region» ambition.
Supported by the Occitanie Region, many innovative projects are being developed in research, transport and industry. In Toulouse, the Region is involved with the CNRS, the University of Toulouse, Safran, Airbus and other major groups and laboratories in the Technocampus Hydrogène project in Francazal, which will be the largest French centre for research, testing, technological innovation and teaching on hydrogen by 2024. Bringing together industrialists and researchers, this €40 million project will have as its first application «the
green aircraft» (tests for hydrogen engines for the aircraft of the future). For its part, Hyport is being set up in the Toulouse-Blagnac airport area. The very first green hydrogen production unit in the world, this company, in which the Occitanie Region is a shareholder via the Regional Energy and Climate Agency (AREC), will supply buses and light vehicles.
In the Hautes-Pyrénées, a similar unit will be created at Tarbes-Lourdes-Pyrénées airport, while in the Hérault, Béziers is home to Genvia: launched in March 2021, the new joint company (Schlumberger New Energy, CEA, Vicat, Vinci, the Region
through AREC) focuses on the production of decarbonated hydrogen from a breakthrough electrolysis technology from the CEA, which allows for much more competitive production. Genvia’s activity is integrated into the Cameron plant in Béziers belonging to Schlumberger.
Similarly, Hyd’Occ is a company owned by Qair Premier Élément and AREC in Port-la-Nouvelle in the Aude. Its objective is to eventually have a production capacity of 50 MW (megawatts) of renewable hydrogen by electrolysis. Hyd’Occ is one of the three winners of the first call for projects launched in the framework of Corridor H2.
In addition, fifteen hydrogen-powered liO coaches are due to be put into service in 2023 by the Occitanie Region on the Albi - Saint-Sulpice-La-Pointe and Albi - SaintSulpice-La-Pointe - Lavaur routes. They will be retrofitted, i.e. converted to hydrogen by the local company Safra, designer of the
59 April 2023
© Wikimedia, CC-BY-SA 2.5
Port-La-Nouvelle will be extended and equipped with port facilities for the construction, assembly, operation and maintenance of floating wind turbines Port-La-Nouvelle va être étendu et doté d’infrastructures portuaires pour la construction, l’assemblage, l’exploitation et la maintenance d’éoliennes flottantes.
Businova hydrogen bus. This conversion of liO buses is part of the Corridor H2 project, which also includes the deployment of 40 hydrogen-powered trucks and 62 trailers / refrigeration units within two years. In addition, the Occitanie Region will put into service a first dual-mode electric/hydrogen train in 2025 on the Toulouse-Montréjeau-Luchon line, by acquiring three trainsets that will be built by Alstom, whose factory in Tarbes (Hautes-Pyrénées) will oversee the hydrogen part. These three trains will run on green hydrogen between Luchon and Montréjeau and in electric mode on the electrified tracks between Montréjeau and Toulouse. In Occitania, this rail link will be a pilot electric/hydrogen line. The aim is to test the advantages of these trains and to identify the lines where hydrogen will be the most appropriate solution.
The Region has also launched the «Green Harbour» ecological transformation of the port of Sète-Frontignan and is contributing to the studies of a «hydrogen on the quay» project. Costing €13 million, this project, piloted by the Toulouse-based company Nexeya, involves a barge loaded with hydrogen and a fuel cell to supply electricity to the boats on the quayside. In Port-la-Nouvelle, AREC and the operator Qair are planning a green hydrogen production plant to supply a distribution network along the A9, at the port of Sète, and to store the electrical energy produced by the future Eolmed floating wind farm.
If it encourages the production of hydrogen, the Occitanie Region will also intervene in its distribution. During the Energaïa Forum in December 2020, the President of the Region, Carole Delga, signed a €40 million loan agreement with the European

Investment Bank to finance the «Corridor H2»: this unique €110 million project, set up by the Region with Ad’Occ and AREC, includes hydrogen production and distribution stations on a Mediterranean-North Sea axis and the motorways of Occitanie.
The Occitanie Region is also participating in an experiment on hydrogen buses with the Albi manufacturer Safra. Its «Territoires d’Hydrogène» call for projects aimed to encourage local hydrogen mobility ecosystems, such as the Montpellier metropolitan area’s hydrogen bus fleet project and the «OccHyTarn» production-dis-
tribution station project. The Region also subsidises (at 50%) the deployment of hydrogen vehicles for professional transport of people or goods. All of these actions will boost «green» jobs: a study conducted by the Cité de l’Économie et des Métiers de Demain among 150 structures in the hydrogen sector (such as Safra, Qair, Cameron, EDF, Engie, etc.) envisages the creation of more than 4,000 jobs by 2024, of which more than 2,000 will be in Occitanie.
Floating wind: a new industrial sector

Floating wind energy should create nearly 3,000 direct, indirect and induced jobs locally. The Occitanie Region is carrying out various actions to encourage the development of this sector with the ambition of becoming the first positive energy region in Europe by 2050. As the owner of PortLa-Nouvelle (Aude), ideally located at the crossroads of the windiest areas of the Gulf of Lion, it is investing more than €230 million to extend the port and equip it with the necessary port infrastructure to enable the construction, assembly, operation and maintenance of floating wind turbines. Two pilot farms, EFGL (Leucate) and EolMed (Gruissan and Port-la-Nouvelle), will be operational from 2023 and will each employ around forty people for maintenance operations and maritime logistics.
In addition to the jobs planned, this activity is also a source of innovation. For this reason, the Occitanie Region has set up
60 Avril 2023
Themis Solaire Innovation, a research and development centre dedicated to solar energy Thémis Solaire Innovation, un centre de recherche et de développement consacré à l’énergie solaire
© David66
–Wikimedia
Characteristics of a smart grid (right) compared to the traditional electricity system (left) Caractéristiques d’un réseau intelligent (à droite) par rapport au système électrique traditionnel (à gauche)
© Bartz/Stockmar (Wikimedia, CC-BY-SA 4.0)
a development strategy for this industrial sector: Wind’Occ, a collective approach bringing together 170 regional companies identified as contributing or potentially contributing to the offshore wind energy value chain and located throughout the region. Among them are Valeco, Qair, MP ArchiMed and Ocean Winds.
Renewable energies applied to building and industry
To develop innovation, research, training, technology transfer, development and business creation in the field of renewable energies applied to buildings and industry at regional, national and international levels: this is the objective of the Derbi competitiveness cluster. Based in Perpignan with a branch in Montpellier and one in Toulouse, it brings together more than 200 members who act and innovate in the Occitanie region for the energy transition.
Solar energy, sustainable building, wind power, biomass energy, energy storage, low-temperature geothermal energy, smart grids, digital technology, hydraulics, hydrogen and «green» gas are the fields of excellence of Derbi, which is a key partner of the Occitanie Region, which it has helped to define its Positive Energy Region strategy for 2050 and to develop the «energy transition» axis of its Regional Innovation Strategy (RIS).

Derbi’s main objective is to accelerate the emergence and marketing of innovative products and services on fast-growing markets driven by international demand, European directives on energy and the energy transition in France. Its activity is structured around 3 Strategic Business Areas (SBAs) representative of the energy systems value chain (from production to final consumption via network management), reinforced by 2 cross-cutting SBAs relating on the one hand to the challenges of the growing use of digital technologies in energy systems, and on the other hand to the societal issues associated with the evolution of these systems.
Since 2006, Derbi has approved 366 projects, 213 of which have been financed for a total investment of €475M, of which €185M is public funding. Between 2020 and 2022 the cluster was involved in two cross-border cooperation projects within the framework of the Interreg V-A Spain - France - Andorra Programme (POCTEFA 2014-2020), co-financed by the ERDF. The EKATE project concerned the management of renewable photovoltaic energy in shared self-consumption in

the France/Spain cross-border area, using «Blockchain» and «Internet of Things» (IoT) technologies. It was the result of a partnership between six cross-border structures, ESTIA (project leader), Derbi and TECSOL in France, the University of the Basque Country, CIMNE and ENERCLUSTER in Spain.
For its part, the EDIFICAT project focused on the energy efficiency sector on both sides of the Pyrenees, along with Girona City Council (project leader), the Perpignan urban area and the Catalan energy efficiency cluster CEEC. The objective was to establish conditions favourable to a reorientation of the construction sector towards a more sustainable and qualitative activity, through cross-border work on networking, training and collaboration between companies and building professionals.
In addition, the Derbi cluster regularly collaborates with consortia, in particular by associating itself with projects of the members of the Smart Energy Alliance and its regional and European partners. This is the case of DIAGTASE: winner of the «Skills and Professions of the Future» call for expressions of interest launched by the State within the framework of France 2030 (PIA4) and operated by the National Research Agency (ANR) and the Caisse des Dépôts et Consignations (CdC), this project, which was completed in December 2022, responded to the «Diagnosis» component 1 of the «Advanced Technology for Energy Systems» (TASE) Acceleration Strategy. It brought together a consortium of 4 partners: the École Nationale d’Ingénieurs de Tarbes, the project leader, the Campus des Métiers et des Qualifications d’Excellence «Habitat, Renewable Energies and EcoConstruction» (CMQE-HEREC), the Campus des Métiers et des Qualifications «Transition Energétique» (CMQ-TE) and Derbi. It has enabled a diagnosis of jobs and skills in the TASE theme to be carried out, targeting the offshore wind, photovoltaic and energy network sectors in Occitania. Based on this study, the consortium will propose an evolution or the creation of a training offer to be deployed to meet these expectations. For the CMQE-HEREC Campus, the diagnosis will consolidate and/or redirect the actions carried out within the framework of the PIA3 project «Territory of educational innovation» (2020-2030). The training courses offered in wind energy, photovoltaics and smart grids management will be particularly concerned by the recommendations resulting from the study. The latter will enable the CMQ-
TE Campus to refine the co-construction of the MOSAHYC pilot project, a training, innovation and R&D platform on renewable energies and smart grids.
Another innovative project in which Derbi is participating: Flexitanie, the first V2G demonstrator. This project targets the deployment of 100 bi-directional charging stations for electric vehicles based on V2G (Vehicle-to-Grid) technology. The action is being carried out jointly by the Occitanie Region, Ad’Occ, ADEME and the EDF group, in partnership with Leader Occitanie, AVERE and CleanTech Valley. From training to mobility, there is only one watchword: to completely review our relationship with energy and its uses.
Occitania: an ambitious Green Hydrogen Plan

With the ambition of being the first positive energy region by 2050, Occitania is the very first region in France to adopt a Green Hydrogen Plan. With a budget of €150 million for the period 2019-2030, this ambitious plan is being implemented in stages. Between now and 2024, it provides for the creation of a massive renewable hydrogen production site, 20 hydrogen stations, three electric/hydrogen trains and the commissioning of 600 heavy, utility and light hydrogen vehicles. Between 2024 and 2030, two other mass production sites, 55 stations and over 3,000 vehicles will be added.
Covering the entire value chain - production, distribution and use - this plan is supported by the State and ADEME, the French agency for ecological transition. Its corollary, Corridor H2, is supported to the tune of €14.5 million by the European Union and by the European Investment Bank through a €40 million loan granted to the Occitanie Region.

61 April 2023
École Nationale d’Ingénieurs
de Tarbes -
ENIT
Une formation pragmatique et une recherche appliquée au service de l’industrie
Accueillant 1 200 étudiants et 60 doctorants, l’École Nationale d’Ingénieurs de Tarbes (ENIT) peut se féliciter de ses quelque

8 000 diplômés à l’heure où elle fête ses 60 ans. Un succès qui doit beaucoup à ses 200 membres du personnel et à son Laboratoire Génie de Production, qui rassemble 130 enseignants-chercheurs, personnels techniques et doctorants. Un terreau fertile dont bénéficient pleinement ses 200 diplômés par an.
de l’ENIT avec les entreprises. L’École est même l’une des rares écoles d’ingénieurs à proposer une formation par valorisation des acquis de l’expérience. Chaque année, quelques personnes se servent de ce tremplin pour booster leur carrière.
Former des ingénieurs généralistes de terrain, à la fois technologues et pragmatiques : c’est l’ambition de l’ENIT. L’École recrute aux niveaux bac et bac+2 et sa formation de 5 ans comprend un an de stage. On comprend, dès lors, les liens très étroits qu’elle a su tisser avec le monde de l’entreprise. Ces liens revêtent diverses formes : en plus des stages sont proposés des contrats de recherche partenariale mais aussi une offre de plateformes technologiques idéales pour favoriser l’innovation et assurer le transfert de technologies et de compétences.
100 % employables, reconnus pour leur capacité à s’intégrer très rapidement dans les entreprises, les diplômés de l’ENIT sont très recherchés. Il faut dire qu’ils bénéficient d’un campus à taille humaine et des très larges collaborations que l’ENIT a pris soin de bâtir dans les domaines de la formation et de la recherche. Les plus de 150 partenariats internationaux offrent en effet des opportunités de stages et de semestres d’études des plus fructueuses. L’ENIT propose même à ses élèves un accompagnement financier. Résultat : tous passent au moins un semestre à l’étranger. Une belle expérience humaine et un réel plus pour le C.V. Mais ce n’est pas tout : l’École propose aussi la formation d’ingénieurs en alternance ou apprentissage. Ces derniers représentent un cinquième des diplômés : une preuve de plus de la proximité naturelle
Les travaux de recherche de l’ENIT sont portés par le Laboratoire Génie de Production. Ses axes de recherche sont en lien direct avec les besoins de l’industrie : les matériaux, la mécanique, l’automatique, la robotique, le génie électrique, les systèmes et l’industrie du futur. Ces axes s’appuient sur des plateformes de transfert de technologie de premier plan pilotées par la direction des affaires industrielles de l’École. La plateforme CIMMES est dédiée au triptyque mécanique, matériaux et surfaces, la plateforme idce est spécialisée dans l’information, la décision et la communication, la plateforme Primes fonctionne comme un hôtel à projets pour la mécatronique de puissance et le management de l’énergie, la plateforme MetallicAdour se consacre à l’usinage, l’assemblage et la robotisation des procédés tandis que la plateforme CEF3D s’est taillé une solide réputation dans le domaine de la fabrication additive métallique (cf. encadré). En bref : une recherche partenariale, technologique et appliquée.
Le goût du partenariat ne se limite pas aux entreprises pour l’ENIT. L’École porte en effet un stimulant projet avec l’IUT de Tarbes (1 500 étudiants) : celui de créer une université de technologie afin de rassembler leurs forces respectives en technologie et ingénierie. La démarche va bon train et la nouvelle université devrait ouvrir ses portes à la rentrée 2024. Sous l’impulsion de l’ENIT, elle constituera un pôle résolument international et proposera de nouvelles formations de niveau master. La recherche devrait aussi s’en trouver stimulée. Un gage de visibilité accrue en France et à l’étranger. De belles perspectives d’attirer les talents de demain.
CEF3D : une plateforme technologique au service de la fabrication additive métallique
La production industrielle vit une véritable révolution : le passage de la fabrication soustractive à la fabrication additive. La réalisation de formes innovantes est désormais possible. Dans ce contexte en pleine effervescence, la plateforme CEF3D rassemble l’ENIT et des partenaires industriels, des startups aux grands groupes. Au sein de ce consortium, les chercheurs de l’École mettent leurs nombreuses compétences au service de l’ensemble de la chaîne de valeur : conception 3D, réalisation et utilisation des pièces. Une complémentarité évidente pour une compétitivité accrue.

Publireportage 62 Avril 2023
© ENIT © ENIT
National Engineering School of Tarbes - ENIT
Pragmatic training and applied research in the service of industry
Welcoming 1,200 students and 60 doctoral students, the National Engineering School of Tarbes (ENIT) can congratulate itself on its 8,000 graduates as it celebrates its 60th anniversary. This success owes much to its 200 staff members and its Production Engineering Laboratory, which brings together 130 teacher-researchers, technical staff and doctoral students. A fertile ground from which its 200 graduates per year benefit fully.
ENIT’s ambition is to train general engineers in the field who are both technologists and pragmatists. The school recruits at the baccalaureate and baccalaureate+2 levels, and its five-year course includes a one-year internship. It is therefore easy to understand the very close links it has forged with the business world. These links take various forms: in addition to internships, partnership research contracts are offered, as well as technological platforms that are ideal for promoting innovation and ensuring the transfer of technologies and skills.
ENIT graduates are 100% employable, recognised for their ability to integrate very quickly into companies, and are highly sought after. It must be said that they benefit from a campus on a human scale and from the very wide-ranging collaborations that ENIT has taken care to build in the fields of training and research. The more than 150 international partnerships offer some of the most fruitful internship and study semester opportunities. ENIT even offers its students financial support. The result: all students spend at least one semester abroad. A great human experience and a real plus for the C.V. But that’s not all: the School also offers training for engineers on a sandwich course or apprenticeship. The latter represent one fifth of the graduates: further proof of ENIT’s natural proximity to companies. The School is even one of the few engineering schools to offer training through the valorization of acquired experience. Every year, a few people use this springboard to boost their careers.
ENIT’s research work is carried out by the Production Engineering Laboratory. Its research areas are directly linked to the needs of industry: materials, mechanics, automation, robotics, electrical engineering, systems and the industry of the future. These areas are supported by leading technology transfer platforms managed by
the School’s industrial affairs department. The CIMMES platform is dedicated to the triptych of mechanics, materials and surfaces, the idce platform is specialised in information, decision and communication, the Primes platform functions as a project hotel for power mechatronics and energy management, the MetallicAdour platform is dedicated to machining, assembly and process robotisation, while the CEF3D platform has built a solid reputation in the field of metal additive manufacturing (see box). In short: partnership, technological and applied research.
ENIT’s taste for partnership is not limited to companies. The school has a stimulating project with the IUT of Tarbes (1,500 students) to create a university of technology in order to bring together their respective strengths in technology and engineering. The process is well underway and the new university should open its doors in 2024. Under the impetus of the ENIT, it will constitute a resolutely international pole and will offer new master’s level courses. Research should also be stimulated. A guarantee of increased visibility in France and abroad. Great prospects for attracting the talents of tomorrow.
CEF3D: a technology platform for metal additive manufacturing

Industrial production is undergoing a real revolution: the transition from subtractive to additive manufacturing. The creation of innovative shapes is now possible. In this fast-moving context, the CEF3D platform brings together ENIT and industrial partners, from start-ups to large groups. Within this consortium, the School’s researchers put their numerous skills at the service of the entire value chain: 3D design, production and use of parts. An obvious complementarity for increased competitiveness.
École Nationale d’Ingénieurs de Tarbes - ENIT 47, avenue d’Azereix - BP 1629

F-65016 Tarbes Cedex
Tél. : +33 (0)5 62 44 27 00
E-mail : mathilde.courtes@enit.fr
https://www.enit.fr/fr/index.html
Publireportage 63 April 2023
© ENIT

64 Avril 2023 © ENIT
Institut Carnot Chimie Balard Cirimat

Créé en 2006, l’Institut Carnot Chimie Balard Cirimat regroupe 772 personnels de recherche reconnus pour leur expertise dans le domaine de la Chimie, des Matériaux et des Procédés et réalise 8,2 M€ de recettes partenariales par an. En 2022 il a réalisé 4,3 M€ de recherche contractuelle bilatérale dans le cadre de 142 contrats non subventionnés avec près de 100 entreprises.
L’offre technologique à destination des entreprises est organisée autour de 5 thématiques : Chimie et Procédés durables, Énergie, Matériaux pour les transports, Matériaux hautes performances, Santé et Cosmétique. Cette offre s’appuie sur 5 plateformes technologiques que sont ChemLab pour la synthèse et l’extraction à différentes échelles, MultiFab pour la fabrication additive, une plateforme d’analyse et de caractérisation physico-chimique de la molécule au matériau (PAC), la plateforme nationale de frittage flash (PNF2) ainsi que SynBio3 pour la synthèse de peptides ou polymères.
L’Institut Carnot Chimie Balard accompagne les entreprises dans le cadre de contrats de prestation et de recherche subventionnée et non-subventionnée. À titre d’exemple récent, il peut se prévaloir d’une collaboration réussie avec le groupe Thales et le CNES. À la clé : le dépôt d’un brevet sur la fabrication de multilatéraux céramique-métal. De même, il a créé un laboratoire commun avec la société Michelin pour le développement de piles à combustible à hydrogène basse température.
La recherche partenariale permet à l’Institut Carnot Chimie Balard de s’investir aux côtés des acteurs du secteur privé pour développer des approches méthodologiques plus respectueuses de l’environnement. Substitution de substances dangereuses, élaboration de molécules et matériaux biosourcés, conception de procédés verts, recyclage et usage limité de métaux stratégiques, promotion de l’énergie bas carbone : autant de défis à relever grâce aux dernières innovations sur les procédés d’élaboration de molécules et de matériaux.
Created in 2006, the Institut Carnot Chimie Balard Cirimat gathers 772 research staff recognized for their expertise in the field of Chemistry, Materials and Processes and realizes 8.2 M€ of partnership revenues per year. In 2022, it carried out €4.3M of bilateral contractual research within the framework of 142 non-subsidised contracts with nearly 100 companies.
The technological offer for companies is organised around 5 themes: Sustainable Chemistry and Processes, Energy, Transport Materials, High Performance Materials, Health and Cosmetics. This offer is based on 5 technological platforms: ChemLab for synthesis and extraction at different scales, MultiFab for additive manufacturing, a platform for physico-chemical analysis and characterisation from the molecule to the material (PAC), the national platform for flash sintering (PNF2) and SynBio3 for the synthesis of peptides or polymers.
The Institut Carnot Chimie Balard supports companies in the framework of service contracts and subsidised and non-subsidised research. As a recent example, it can boast of a successful collaboration with the Thales group and the CNES. This resulted in the filing of a patent on the manufacture of ceramic-metal multilaterals. Similarly, it has created a joint laboratory with Michelin for the development of low-temperature hydrogen fuel cells.

Partnership research allows the Institut Carnot Chimie Balard to invest alongside private sector actors to develop more environmentally friendly methodological approaches. Substitution of dangerous substances, elaboration of biosourced molecules and materials, design of green processes, recycling and limited use of strategic metals, promotion of low-carbon energy: so many challenges to be taken up thanks to the latest innovations on the elaboration processes of molecules and materials.
Ecole Nationale Supérieure de Chimie de Montpellier
240 Avenue du Professeur Emile Jeanbrau
F-34296 Montpellier
Tél.: +33 (0)4 67 14 43 96
E-mail: contact@carnot-chimie-balard-cirimat.fr
https://www.carnot-chimie-balard-cirimat.fr
Publireportage 65 April 2023
© Institut Carnot Chimie Balard Cirimat
Région Sud PACA : « Gardons une COP d’avance »
Voté le 23 avril 2021, le plan climat 2 « Gardons une COP d’avance » vise à faire de la région Sud un territoire moteur en atteignant la neutralité carbone à l’horizon 2050 grâce à la réduction / décarbonation de la consommation énergétique dans l’industrie et la mobilité, la sobriété et l’autonomie énergétique dans le bâtiment, la multiplication par 5 de la production actuelle d’énergies renouvelables dont l’hydrogène vert.
Dès 2017, la feuille de route de l’opération d’intérêt national (OIR) Énergies de Demain se positionne sur les 3 principaux marchés de l’énergie (industrie et agriculture, mobilité, bâtiment et quartier) et établit des priorités thématiques : l’éolien offshore flottant, les gaz renouvelables dont l’hydrogène, le stockage, le nucléaire et la rénovation énergétique des bâtiments. Plus d’une centaine de projets ont été détectés, une vingtaine ont bénéficié d’un accompagnement et 16 bénéficié de 35 M€ de financements privés et publics. Si les projets de la filière hydrogène (HyGreen, Hynovar, MassHylia…) ont eu une place prépondérante, les solutions de production d’énergies décarbonées (énergies marines, gaz renouvelables, nucléaire) sont également soutenues. En outre, une belle dynamique a été engendrée par le programme Flexgrid, clôturé en 2021, pour les systèmes énergétiques optimisés.
L’OIR Énergies de Demain s’appuie sur la transition énergétique comme opportunité de développement d’activités, d’innovation, d’industrialisation et de construction de nouveaux modèles économiques sur les marchés de la transition énergétique et de l’hydrogène. La Région Sud veut permettre aux entreprises de tester leurs solutions et de s’ouvrir à d’autres marchés pour contribuer à la modification du mix énergétique et à l’évolution des usages de demain.
La feuille de route 2021-2028 de l’OIR Énergies de Demain se décline en 3 axes : le premier apporte une brique de décarbonation à l’industrie et aux transports grâce à l’hydrogène, le second fournit des énergies de substitution au fossile tandis que le troisième propose une approche système, basée sur les ressources des deux premiers pour traiter l’efficacité énergétique, l’intégration des énergies renouvelables intermittentes, le pilotage des productions et consommations, la nécessaire flexibilité… De plus, la sobriété et l’efficacité énergétiques devront être un préalable à tout projet, toute solution proposée.
R&D et innovation, attractivité et international, croissance des entreprises clés de l’OIR, formation, écosystèmes territoriaux : l’OIR adresse l’ensemble des leviers utiles au développement de ses filières et acteurs. Le nouveau fonds de participation pour la reconquête industrielle,
Terra Néa, permettra des prises de participation directe dans certains projets structurants.
Faire de la région Sud un leader de la filière hydrogène
Le premier axe de la feuille de route de l’OIR Énergies de Demain s’appuie sur trois leviers. Premier levier : accélérer la décarbonation de l’industrie grâce à l’hydrogène. Priorité est donnée à la ZIP de Marseille Fos qui fait l’objet d’une approche spécifique avec le bassin hydrogène Marseille-Fos : les industries ciblées (sidérurgie, chimie…) incluent la production de dérivés de l’hydrogène (méthanation, e-carburant, composants chimiques…). Deuxième levier : développer les solutions innovantes de production massive d’hydrogène décarboné, les infrastructures de transport, distribution et stockage pour structurer la filière. Le troisième levier est celui de la mobilité avec un accent sur les applications maritimes (ports, navires, logistique…), les actions prospectives pour l’aéronautique, les e-carburants (maritime, aéronautique) ou les écosystèmes de mobilité terrestre innovants.

Le deuxième axe de la feuille de route vise à innover pour la production d’énergies décarbonées. Cela implique d’industrialiser la production d’énergies renouvelables et de récupération (filière solaire, pyrogazéification, méthanisation, production de carburants de synthèse bas carbone ou de biocarburants),
de structurer la filière éolien offshore flottant (couplage ou complémentarité entre l’éolien offshore et l’hydrogène, intégration de la production des éoliennes offshore dans les systèmes énergétiques) et de soutenir des initiatives dans le cadre de la filière nucléaire : en lien avec le plan France 2030 (dont l’objectif sur les small modular reactors) et la programmation du nouveau nucléaire, l’objectif est de favoriser la participation des entreprises régionales aux marchés des grands donneurs d’ordre et aux appels à projets nationaux. L’accompagnement des entreprises impliquées dans le programme ITER et la diversification de leurs activités au-delà d’ITER seront également promus.
Enfin, le troisième axe de la feuille de route a pour objectif d’optimiser les systèmes énergétiques pour accompagner la décarbonation des usages. Cela passe par trois actions : accompagner les projets de décarbonation industrielle (projet de Zone Industrielle Bas Carbone (ZIBAC), intégration d’un volet transition énergétique dans le futur Parcours Sud Industries 4.0 de l’OIR Industries du futur) ; soutenir les solutions pour les systèmes énergétiques à l’échelle du bâtiment, du quartier ou d’une zone d’activité (efficacité énergétique, intégration des énergies renouvelables, couplage multi-énergies, auto-consommation, réseaux…) ; et accompagner le déploiement d’offres dédiées à la mobilité (systèmes énergétiques et recharge
66 Avril 2023
© Rama –Wikimedia
Le port de Marseille-Fos, future vitrine de la décarbonation de l’industrie grâce à l’hydrogène / The port of Marseille-Fos, future showcase for the decarbonisation of industry thanks to hydrogen
intelligente de véhicules électriques, systèmes multi-énergies, logistique portuaire…). Ces différents objectifs sont portés par le Comité de pilotage de l’OIR Énergies de Demain : co-présidé par Anne Claudius-Petit, conseillère régionale et présidente de la Commission Transition énergétique, stratégie des déchets et Qualité de l’air, et Jacques Vayron, directeur du CEA Cadarache jusqu’en mars 2023, il s’appuie notamment sur les pôles de compétitivité Capenergies et Mer Méditerranée, Novachim (Association des Industries de Procédés Méditerranée) et Eco Entreprises1
Capenergies : de nouveaux systèmes énergétiques compétitifs pour une société décarbonée
Répondre aux enjeux de la transition énergétique et développer une filière énergétique d’excellence grâce à de nouveaux produits et services commercialisables : c’est l’objectif du pôle de compétitivité Capenergies. Basé à Aix-en-Provence et bénéficiant de l’appui de l’Agence de Développement Économique de la Corse, du CEA et d’EDF, il totalise 530 membres, 300 partenaires européens et plus de 800 projets labellisés dont 464 projets financés et près de 570 M€ d’aides obtenues depuis 2006. Il s’est fixé trois domaines d’activités stratégiques (DAS) : efficacité énergétique, systèmes énergétiques insulaires et zones isolées, production d’énergie décarbonée.
Parmi les projets de R&D et industriels récemment labellisés, le projet H2 Vaucluse a pour objectif le déploiement d’un écosystème hydrogène pour amorcer la décarbonation des usages : ramassage des déchets, transport de marchandises, logistique, transports en commun et industrie. L’hydrogène sera produit en partie localement grâce à l’électricité issue d’un parc photovoltaïque au sol, ce qui permettra la maîtrise du prix de revient de l’hydrogène. À sa mise en service prévue pour début 2025 (phase 1),
le projet alimentera 15 véhicules lourds, 20 véhicules utilitaires et 1 site industriel, avec une augmentation progressive des usages permettant à terme l’évitement de plus de 6.000 t.éq.CO2/an.

Autre exemple, le projet Agriterma vise à développer un système de régulation climatique des serres agricoles grâce à un mix de solutions de production et de stockage d’énergies renouvelables (solaire thermique, géothermie de surface, stockeurs thermiques, récupération de chaleur fatale, pompes à chaleur réversibles) en substitution des énergies fossiles. Cette approche intégrée permet à la fois la protection des cultures contre les aléas climatiques, la réduction et la décarbonation des consommations énergétiques des cultures agricoles sous serres.
Les entreprises membres de Capenergies ont d’ores et déjà développé des produits et services innovants : un équipement et des systèmes pour le transport et la distribution d’énergie pour Actia Telecom, des solutions de production d’hydrogène pour Areva, des systèmes de conversion électronique des énergies renouvelables pour EverGrid Solutions & Systems, des technologies de production de chaleur et de froid par énergie solaire pour Helioclim…
Capenergies s’appuie sur des plateformes technologiques dédiées. Créée en 2011 sur le site du CEA Cadarache, la Cité des Énergies réunit des acteurs de la formation, de la recherche et des industriels pour favoriser le transfert technologique en direction des PME régionales et accompagner leur croissance selon 4 axes stratégiques : performance des démonstrateurs solaires et smart grids thermiques ou électriques, production et efficacité énergétique pour les bâtiments méditerranéens, recherche sur les biocarburants à partir de microalgues et développement d’un axe de recherche autour des bio-raffineries, serres du
futur et piles microbiennes. Partenaire de la Cité des Énergies depuis sa création, Capenergies a labellisé bon nombre des projets présentés (grande centrale solaire, plateforme dédiée à la biomasse, démonstrateurs d’efficacité et de rénovation énergétique des bâtiments) et accompagne les orientations de la plateforme qui mobilise un budget de 6,5 M€ et rassemble à ce jour 30 partenaires industriels dont 27 PME-ETI (certains sont membres du Pôle), autour d’une trentaine de contrats de R&D engagés.
Par ailleurs, Capenergies a pour ambition de devenir un pôle de référence en Europe et sur le pourtour méditerranéen dans les domaines de l’efficacité énergétique et des énergies renouvelables. Il contribue activement au pilotage de plusieurs projets européens aux côtés de partenaires et de clusters d’innovation : H2GOLBAL, qui vise à accompagner l’essor international des entreprises européennes de l’hydrogène vert sur toute la chaîne de valeur, FLEXIGRID, qui cible le développement de solutions interopérables pour la mise en œuvre de services holistiques de FLEXIbilité dans le GRID de distribution, et GREENinMED, dont l’objectif est de favoriser l’innovation durable à destination des hébergements touristiques en Méditerranée.
Capenergies développe ainsi un réseau international, un vivier de partenaires technologiques potentiels et une source d’information privilégiée pour l’identification d’opportunités à l’étranger. En complément des réseaux propres à chaque projet qu’il a intégré, Capenergies est identifié par le réseau Enterprise Europe Network. Autant d’opportunités pour valoriser les produits et le savoir-faire de ses adhérents tout en créant des synergies au-delà des frontières nationales2
67 April 2023
Partenariat public-privé entre ENGIE (via sa filiale Storengy et son entité dédiée à l’hydrogène) et la communauté d’agglomération Durance Luberon Verdon (DLVA), HyGreen Provence vise à produire de l’électricité solaire et à en transformer une part croissante en hydrogène vert. / A public-private partnership between ENGIE (via its subsidiary Storengy and its hydrogen unit) and the Durance Luberon Verdon agglomeration community (DLVA), HyGreen Provence aims to produce solar electricity and convert an increasing proportion of it into green hydrogen.
1 Source : Région Sud PACA.
© ENGIE
2 Source : Pôle Capenergies
Coupe du tokamak d’ITER, un dispositif de confinement magnétique expérimental explorant la physique des plasmas et les possibilités de produire de l’énergie par fusion nucléaire / Cross-section of the ITER tokamak, an experimental magnetic confinement device exploring plasma physics and the possibilities of producing energy by nuclear fusion

ITER : la fusion nucléaire pour produire de l’énergie

Le CEA est un des premiers organismes de recherche européens dans le domaine de la fusion par confinement magnétique. Son Institut de Recherche sur la Fusion par confinement Magnétique (CEA-IRFM) à Cadarache participe pleinement à la feuille de route européenne de la recherche dans ce domaine. Au centre de ces travaux, le projet international ITER mobilise l’Union Européenne, la Russie, les États-Unis, le Japon, la Chine, la Corée du Sud et l’Inde. En construction à proximité du centre de Cadarache, un tokamak expérimental aura pour mission de démontrer qu’il est possible de générer des réactions de fusion produisant 500 MW pendant plus de 6 minutes, et dans un second temps, que ces réactions peuvent être maintenues pendant plus de 16 minutes. Il devrait entrer en opération vers 2025 et mobilise sept partenaires internationaux regroupant 34 pays pour sa conception, sa réalisation et son fonctionnement. Contribuant sous forme de fournitures d’équipements et de prestations à la construction de la machine, implantée au voisinage immédiat du CEA Cadarache, les équipes du CEA se préparent à participer à son exploitation scientifique.





Forte des retours d’expérience sur ITER, la communauté de scientifiques et d’ingénieurs systèmes étudie déjà l’étape suivante : conduire à une filière industrielle de réacteurs de fusion électrogènes. Elle doit permettre de démontrer la faisabilité de la production d’électricité et de qualifier les technologies spécifiques à un réacteur industriel. Le CEA participe en particulier à la R&D dans le domaine des couvertures tritigènes et des matériaux résistants aux neutrons produits par les réactions de fusion, deux technologies essentielles pour le réacteur industriel.
Le CEA est également impliqué dans le programme de coopération Europe - Japon « Approche élargie » d’ITER avec deux grandes infrastructures de recherche actuellement en construction au Japon : le tokamak JT-60SA, qui vise à étudier des configurations tokamaks potentiellement plus performantes qu’ITER, et le projet Ifmif/Eveda (Engineering Validation and Engineering Design Activities) pour le design et la validation des principaux composants technologiques (accélérateur et cible en lithium liquide) de la future source d’irradiation Ifmif. Il s’agit de produire une source de neutrons similaires à ceux produits par les réactions de fusion, dont la très haute énergie induit des modifications structurelles des aciers de structure. Le CEA y assurera la qualification de nouveaux aciers en cours de développement et susceptibles de maintenir leurs qualités mécaniques sous un tel bombardement. Il a aussi fourni des équipements industriels fabriqués majoritairement en France. Une belle manière de faire rayonner son expertise sur les plasmas de longue durée et les technologies associées : l’astrophysique, la physique nucléaire, la physique des particules, les nouvelles technologies pour l’énergie et l’environnement3
le comportement de matériaux et combustibles sous irradiation, en soutien aux réacteurs nucléaires actuels et futurs. Le RJH, actuellement en construction sur le site CEA de Cadarache, constituera un outil expérimental d’irradiation unique en Europe à la disposition de l’industrie nucléaire, des organismes de recherche, des autorités de sûreté nucléaire et de leurs appuis techniques.
Les études sur le comportement des combustibles et matériaux de structure sous irradiation constituent un enjeu fondamental pour la sûreté, la compétitivité des centrales nucléaires actuelles et futures, et l’augmentation de leur durée de fonctionnement. Le RJH permettra de réaliser ces études de manière sûre et rapide. Grâce à sa plateforme scientifique et technique, le RJH bombardera d’un flux neutronique intense les échantillons de composants que les chercheurs ou industriels souhaitent tester. Au sein des dispositifs expérimentaux du RJH, ces échantillons pourront également être soumis, si besoin, à des pressions et températures extrêmes. Ces composants subiront ainsi un vieillissement accéléré et seront poussés au-delà des limites prévues pour leur usage nominal, jusqu’à, si besoin, des conditions incidentelles et accidentelles, afin de les qualifier pour un usage industriel. Une exigence de sécurité impérative pour ce projet qui regroupe, autour du CEA, propriétaire, exploitant nucléaire et maître d’ouvrage de l’installation, Areva-SA, Framatome, TechnicAtome et EDF (France), CIEMAT (Espagne), UJV (République tchèque), SCK.CEN (Belgique), VTT (Finlande), la Commission européenne, DAE (Inde), IAEC (Israël), NNL (Royaume-Uni) et STUDSVIK (Suède). En échange de leur participation financière, les membres du consortium bénéficieront de droits d’accès garantis aux capacités expérimentales du RJH pour mener à bien leurs propres recherches sur le comportement des matériaux sous irradiation4
Ces recherches s’avèrent d’ores et déjà complémentaires du projet gouvernemental de construire d’ici à 2050 six réacteurs nucléaires de type EPR 2, un modèle de réacteur nucléaire à eau pressurisée de génération III+, une évolution de l’EPR (Evolutionary Power Reactor).

Réacteur de recherche Jules Horowitz (RJH) : focus sur le comportement de matériaux et combustibles sous irradiation
Le projet de réacteur de recherche Jules Horowitz (RJH), piloté par le CEA sur le centre de Cadarache, répond à un défi scientifique et technologique essentiel : tester
L’objectif : améliorer la réalisation industrielle et abaisser les coûts de fabrication via des modifications de design, tout en maintenant le niveau de sûreté (fonctionnement, protection du personnel, limitation de production de déchets radioactifs, gestion de perte de confinement, résistance aux agressions internes ou externes)5 Une équation délicate et un défi stimulant pour les chercheurs.
3 Source : CEA.
4 Source : CEA
5 Source : Wikipédia.
68 Avril 2023
© Rama Wikimedia
Schéma des circuits de refroidissement du réacteur de recherche Jules Horowitz (RJH) / Diagram of the cooling circuits of the Jules Horowitz Research Reactor (RJH).
© Guy Willermoz
Southern PACA Region: “Let’s keep one COP ahead”
Voted on 23 April 2021, the Climate Plan 2 «Keeping a COP ahead» aims to make the Southern Region a driving force in achieving carbon neutrality by 2050 through the reduction / decarbonisation of energy consumption in industry and mobility, energy sobriety and autonomy in the building sector, and a fivefold increase in the current production of renewable energies including green hydrogen.
Since 2017, the roadmap of the national interest operation (OIR) Energies of Tomorrow has been positioned on the three main energy markets (industry and agriculture, mobility, buildings and neighbourhoods) and establishes thematic priorities: floating offshore wind energy, renewable gases including hydrogen, storage, nuclear energy and energy renovation of buildings. More than a hundred projects have been detected, twenty or so have received support and 16 have benefited from €35 million in private and public funding. While projects in the hydrogen sector (HyGreen, Hynovar, MassHylia, etc.) have had a predominant place, decarbonised energy production solutions (marine energies, renewable gases, nuclear) are also supported. In addition, the Flexgrid programme, which was completed in 2021, has created a great dynamic for optimised energy systems.
The Energies of Tomorrow OIR is based on the energy transition as an opportunity for the development of activities, innova-
tion, industrialisation and the construction of new economic models in the energy transition and hydrogen markets. The Southern Region wants to enable companies to test their solutions and to open up to other markets in order to contribute to the modification of the energy mix and to the evolution of tomorrow’s uses.
The 2021-2028 roadmap of the Energies of Tomorrow OIR is divided into 3 areas: the first provides a decarbonisation brick for industry and transport thanks to hydrogen, the second provides alternative energies to fossil fuels, while the third proposes a system approach, based on the resources of the first two, to deal with energy efficiency, the integration of intermittent renewable energies, the management of production and consumption, the necessary flexibility, etc. In addition, energy sobriety and efficiency will have to be a prerequisite for any project, any proposed solution.
R&D and innovation, attractiveness and internationalisation, growth of the OIR’s key
companies, training, territorial ecosystems: the OIR addresses all the levers useful for the development of its sectors and players. The new participation fund for industrial recovery, Terra Nea, will allow direct participation in certain structuring projects.
Making the Southern Region a leader in the hydrogen sector
The first axis of the roadmap of the Energies of Tomorrow OIR is based on three levers. First lever: accelerate the decarbonisation of industry thanks to hydrogen. Priority is given to the Marseille Fos Industrial-Port Zone (ZIP), which is the subject of a specific approach with the Marseille Fos hydrogen basin: the targeted industries (iron and steel, chemicals, etc.) include the production of hydrogen derivatives (methanation, e-fuel, chemical components, etc.). The second lever is to develop innovative solutions for the massive production of carbon-free hydrogen, transport, distribution and storage infrastructures to structure the sector. The third lever is

69 April 2023
Aerial photo of the CEA in Cadarache / Photo aérienne du CEA à Cadarache
© Muyoku
mobility, with a focus on maritime applications (ports, ships, logistics, etc.), prospective actions for aeronautics, e-fuels (maritime, aeronautics) and innovative land mobility ecosystems.
The second axis of the roadmap aims to innovate for the production of decarbonised energy. This involves industrialising the production of renewable and recovered energy (solar energy, pyrogasification, methanisation, production of low-carbon synthetic fuels or biofuels), structuring the floating offshore wind energy sector (coupling or complementarity between offshore wind energy and hydrogen, integration of the production of offshore wind turbines into energy systems) and supporting initiatives in the nuclear sector: in line with the France 2030 plan (including the objective of small modular reactors) and the new nuclear programming, the objective is to encourage the participation of regional companies in the markets of major contractors and in national calls for projects. The support of companies involved in the ITER programme and the diversification of their activities beyond ITER will also be promoted.

Finally, the third axis of the roadmap aims to optimise energy systems to accompany the decarbonisation of uses. This involves three actions: supporting industrial decarbonisation projects (Low Carbon Industrial Zone (ZIBAC) project, integration of an energy transition component in the future Parcours Sud Industries 4. 0 pathway of the Industries of the Future OIR); support solutions for energy
systems at the building, district or activity zone level (energy efficiency, integration of renewable energies, multi-energy coupling, self-consumption, networks, etc.); and support the deployment of offers dedicated to mobility (energy systems and intelligent recharging of electric vehicles, multi-energy systems, port logistics, etc.). These different objectives are supported by the Energies of the Future OIR Steering Committee: co-chaired by Anne Claudius-Petit, regional councillor and chair of the Energy Transition, Waste Strategy and Air Quality Commission, and Jacques Vayron, director of CEA Cadarache until March 2023, it relies in particular on the Capenergies and Mer Méditerranée competitiveness clusters, Novachim (Association des Industries de Procédés Méditerranée) and Eco Entreprises.
Capenergies: new competitive energy systems for a low-carbon society
Responding to the challenges of the energy transition and developing an energy sector of excellence thanks to new marketable products and services: this is the objective of the Capenergies competitiveness cluster. Based in Aix-en-Provence and supported by the Corsican Economic Development Agency, the CEA and EDF, it has 530 members, 300 European partners and more than 800 approved projects, including 464 projects financed and nearly €570 million in aid obtained since 2006. It has set itself three strategic areas of activity (DAS): energy efficiency, island energy systems and isolated areas, and decarbonised energy production.
Among the R&D and industrial projects recently approved, the H2 Vaucluse project aims to deploy a hydrogen ecosystem to initiate the decarbonisation of uses: waste collection, goods transport, logistics, public transport and industry. The hydrogen will be produced in part locally thanks to the electricity generated by a photovoltaic park on the ground, which will make it possible to control the cost price of the hydrogen. When it comes into service in early 2025 (phase 1), the project will supply 15 heavy vehicles, 20 commercial vehicles and 1 industrial site, with a gradual increase in usage that will eventually enable the avoidance of more than 6,000 t.eq.CO2/year.
Another example is the Agriterma project, which aims to develop a climate control system for agricultural greenhouses using a mix of renewable energy production and storage solutions (solar thermal, surface geothermal, thermal storage, waste heat recovery, reversible heat pumps) to replace fossil fuels. This integrated approach allows both the protection of crops against climatic hazards and the reduction and decarbonisation of the energy consumption of agricultural crops in greenhouses.
Capenergies’ member companies have already developed innovative products and services: equipment and systems for energy transport and distribution (Actia Telecom), hydrogen production solutions (Areva), electronic conversion systems for renewable energies (EverGrid Solutions & Systems), solar heat and cold production technologies (Helioclim)...
70 Avril 2023
Wind turbines in the Camargue, near the Grand-Rhône / Éoliennes en Camargue, à proximité du Grand-Rhône © Deuxtroy Wikimedia
Capenergies relies on dedicated technological platforms. Created in 2011 on the CEA Cadarache site, the Cité des Énergies brings together players from training, research and industry to promote technology transfer to regional SMEs and support their growth along four strategic lines: performance of solar demonstrators and thermal or electrical smart grids, energy production and efficiency for Mediterranean buildings, research on biofuels from microalgae and development of a research axis around bio-refineries, greenhouses of the future and microbial cells. Capenergies has been a partner of the Cité des Énergies since its creation and has approved many of the projects presented (large solar power plant, biomass platform, demonstrators of energy efficiency and renovation of buildings) and supports the platform’s orientations, which has a budget of €6.5 million and currently brings together 30 industrial partners, including 27 SME’s (some of which are members of the cluster), and around thirty committed R&D contracts.
In addition, Capenergies’ ambition is to become a reference cluster in Europe and around the Mediterranean in the fields of energy efficiency and renewable energy. It actively contributes to the management of several European projects alongside partners and innovation clusters: H2GOLBAL, which aims to support the international development of European green hydrogen companies across the value chain, FLEXIGRID, which targets the development of interoperable solutions for the implementation of holistic FLEXIbility services in the distribution GRID, and GREENinMED, whose objective is to promote sustainable innovation for tourist accommodation in the Mediterranean.




Capenergies is thus developing an international network, a pool of potential technological partners and a privileged source of information for identifying opportunities abroad. In addition to the networks specific to each project it has integrated, Capenergies is identified by the Enterprise Europe Network. These are all opportunities to promote the products and know-how of its members while creating synergies beyond national borders.

ITER: nuclear fusion to produce energy

The CEA is one of the leading European research organisations in the field of fusion by magnetic confinement. Its Institute for Research on Fusion by Magnetic Confinement (CEA-IRFM) in Cadarache is fully involved in the European roadmap for research in this field. At the heart of this work is the international ITER project in-
volving the European Union, Russia, the United States, Japan, China, South Korea and India. Under construction near the Cadarache centre, an experimental tokamak will have the task of demonstrating that it is possible to generate fusion reactions producing 500 MW for more than 6 minutes, and in a second phase, that these reactions can be maintained for more than 16 minutes. It is expected to be operational by 2025 and involves seven international partners from 34 countries in its design, construction and operation. Contributing in the form of equipment supplies and services to the construction of the machine, located in the immediate vicinity of CEA Cadarache, the CEA teams are preparing to participate in its scientific operation.
On the strength of the feedback from ITER, the community of scientists and systems engineers is already studying the next stage: leading to an industrial line of electrogenic fusion reactors. This should make it possible to demonstrate the feasibility of electricity production and to qualify the specific technologies for an industrial reactor. The CEA is particularly involv ed in R&D in the field of tritiated blankets and materials resistant to the neutrons produced by fusion reactions, two essential technologies for the industrial reactor.
The CEA is also involved in the EuropeJapan cooperation programme «Broader Approach» to ITER with two major research infrastructures currently under construction in Japan: the JT-60SA tokamak, which aims to study tokamak configurations potentially more efficient than ITER, and the Ifmif/Eveda project (Engineering Validation and Engineering Design Activities) for the design and validation of the main technological components (accelerator and liquid lithium target) of the future Ifmif irradiation source. The aim is to produce a source of neutrons similar to those produced by fusion reactions, the very high energy of which leads to structural modifications of the structural steels. The CEA will be responsible for qualifying new steels under development that are likely to maintain their mechanical qualities under such a bombardment. It also supplied industrial equipment, most of which was manufactured in France. This is a good way to promote its expertise in long-duration plasmas and associated technologies: astrophysics, nuclear physics, particle physics, new technologies for energy and the environment.
Jules Horowitz Research Reactor (JHR): focus on the behaviour of materials and fuels under irradiation
The Jules Horowitz Research Reactor (JHR) project, piloted by CEA at the Cadarache centre, meets an essential scientific and technological challenge: testing the behaviour of materials and fuels under irradiation, in support of current and future nuclear reactors. The JHR, currently under construction on the CEA Cadarache site, will be a unique experimental irradiation tool in Europe available to the nuclear industry, research organisations, nuclear safety authorities and their technical support.
Studies on the behaviour of fuels and structural materials under irradiation are a fundamental issue for the safety and competitiveness of current and future nuclear power plants and for increasing their operating life. The JHR will enable these studies to be carried out safely and rapidly. Thanks to its scientific and technical platform, the JHR will bombard with an intense neutron flux the component samples that researchers or industrialists wish to test. Within the RJH’s experimental facilities, these samples can also be subjected to extreme pressures and temperatures if necessary. These components will thus undergo accelerated ageing and will be pushed beyond the limits of their nominal use, up to incidental and accidental conditions if necessary, in order to qualify them for industrial use. This is an imperative safety requirement for this project which brings together, around the CEA, owner, nuclear operator and project manager of the installation, Areva-SA, Framatome, TechnicAtome and EDF (France), CIEMAT (Spain), UJV (Czech Republic), SCK.CEN (Belgium), VTT (Finland), the European Commission, DAE (India), and IAEC (Israel). In exchange for their financial participation, the consortium members will have guaranteed access to the experimental capabilities of the JHR to carry out their own research on the behaviour of materials under irradiation.
This research is already complementary to the government’s plan to build six EPR 2 nuclear reactors by 2050, a generation III+ pressurised water nuclear reactor model, an evolution of the EPR (Evolutionary Power Reactor). The objective: to improve industrial production and reduce manufacturing costs through design modifications, while maintaining the level of safety (operation, protection of personnel, limitation of radioactive waste production, management of loss of containment, resistance to internal or external aggression). A delicate equation and a stimulating challenge for researchers.
71 April 2023
L’innovation en santé place le patient au cœur des actions
Un entretien avec M. Philippe DE MESTER, Directeur général sortant de l’ARS PACA

Pourriez-vous nous rappeler les missions de l’ARS PACA ?
L’ARS Paca est un établissement public administratif, sous tutelle ministérielle. Elle définit, programme et s’assure de la mise en œuvre de la politique régionale de santé, en lien avec les acteurs de santé, les élus et les usagers du système de santé en tenant compte des spécificités régionales. L’ARS propose une approche globale, cohérente et transversale de la santé. Son champ d’intervention couvre tous les domaines de la santé publique : la prévention, la promotion de la santé, la veille et la sécurité sanitaires, l’organisation de l’offre de soins dans les cabinets médicaux de ville, en établissements de santé et dans les structures médico-sociales accueillant des personnes âgées ou des personnes en situation de handicap.
Et les fondements de la politique régionale de santé ?
Le projet régional de santé 2018-2023 est le document stratégique défini par l’ARS. Il permet d’organiser et de programmer la mise en œuvre des priorités de santé de notre région.

Quels partenariats avez-vous développés avec les acteurs de la santé en région pour que chacun ait accès à des soins de qualité ? La mise en œuvre de la stratégie régionale d’accès aux soins de proximité repose à la fois sur une structuration interne au sein de l’ARS ainsi qu’un renforcement de la mobilisation des acteurs du territoire. Dans notre région, cette mobilisation s’articule et se renforce autour d’instances régionales de gouvernance : la commission de coordination de l’offre de proximité régionale (CCOPr) et la commission de coordination de l’offre de proximité départementale (CCOPd). Ces instances réunissent nos partenaires principaux : Union régionale des médecins libéraux et URPS des autres professions de santé, Conseils de l’Ordre des professions de santé, Assurance maladie, collectivités territoriales et Conseil régional, préfectures, universités et départements universitaires de médecine générale, etc.
Comment l’ARS PACA favorise-t-elle l’innovation en santé ?
L’innovation en santé dessine la médecine de demain et place le patient au cœur des actions. C’est pourquoi les pouvoirs publics s’engagent pour que les patients, usagers et associations de patients puissent prendre part à ces évolutions aux côtés des industriels, professionnels de santé, chercheurs... La loi de financement de la sécurité sociale de 2018 a introduit, en son article 51, un dispositif permettant d’expérimenter de nouvelles organisations en santé reposant sur des modes de financement inédits. Grâce à ce dispositif, l’ARS Paca a mis en place un parcours de soins pour améliorer la prise en charge chirurgicale de l’obésité. Il permet aux patients souffrant d’obésité sévère bénéficiant d’un traitement chirurgical d’accéder sans surcoût à un parcours de soins complet et pertinent et à les impliquer dans leur prise en charge. D’autres projets innovants ont également vu le jour
comme le déploiement de la pratique avancée qui soutient la formation des infirmières libérales. Le programme e-Parcours vise à déployer des services numériques de coordination afin d’améliorer les parcours de santé des patients. Il permet aux professionnels, quel que soit leur secteur d’activité, de se coordonner en sécurisant et fluidifiant les échanges. L’ARS Paca accompagne et soutient le développement de la télémédecine qui utilise les technologies de l’information et de la communication et offre de nouvelles possibilités pour améliorer l’accès aux soins et rapprocher au plus près des patients l’expertise médicale.
Quels sont selon vous les grands enjeux de santé publique en région Sud et comment l’ARS PACA s’efforce-t-elle d’y répondre ?
La région Paca est marquée par de grandes diversités géographiques, démographiques, économiques, sociales, urbaines et environnementales. Ces caractéristiques sont à l’origine de besoins spécifiques qui influencent la consommation et l’offre de soins et doivent nécessairement être prises en compte dans les priorités de santé publique. L’analyse de l’état de santé de la population régionale, la réponse aux besoins de santé exprimés par les patients et leur famille, et la déclinaison de la stratégie nationale de santé sur notre territoire se traduisent en enjeux et priorités régionales de santé publique. Ces priorités président aux orientations des schémas, aux actions retenues par les appels à projet et aux allocations de ressources :
�Prendre en compte les besoins d’une population vieillissante
�Mettre en place une politique globale en faveur des enfants et des jeunes
��Proposer une palette de réponses diversifiées aux personnes en situation de handicap
�Renforcer la politique de santé mentale pour faire face aux défis à venir
�Poursuivre la baisse de la mortalité prématurée
�Organiser la prise en charge des maladies chroniques
��Réduire l’impact sur la santé de l’exposition aux risques environnementaux.
72 Avril 2023
© ARS PACA
© ARS PACA
Innovation in health puts the patient at the heart of actions
Could you remind us of the missions of ARS PACA?
The ARS PACA is a public administrative establishment, under ministerial supervision. It defines, programmes and ensures the implementation of the regional health policy, in conjunction with health actors, elected representatives and users of the health system, taking into account the specificities of the region. The ARS proposes a global, coherent and transversal approach to health. Its field of intervention covers all areas of public health: prevention, health promotion, health monitoring and health security, organisation of care in town doctors’ surgeries, in health establishments and in medico-social structures for the elderly or people with disabilities.
What about the foundations of regional health policy?
The 2018-2023 regional health project is the strategic document defined by the ARS. It enables the organisation and programming of the implementation of our region’s health priorities.
What partnerships have you developed with regional health actors to ensure that everyone has access to quality care?
The implementation of the regional strategy for access to local care is based on both internal structuring within the ARS and a strengthening of the mobilisation of local players. In our region, this mobilisation is structured and reinforced around regional governance bodies: the regional local supply coordination commission (CCOPr) and the departmental local supply coordination commission (CCOPd). These bodies bring together our main partners: the regional union of private practitioners and URPSs of other health professions, the councils of the health
professions, health insurance, local authorities and the Regional Council, prefectures, universities and university departments of general medicine, etc.
How does ARS PACA promote innovation in health?
Innovation in health is shaping the medicine of tomorrow and putting the patient at the heart of the actions. This is why the public authorities are committed to ensuring that patients, users and patient associations can take part in these developments alongside manufacturers, health professionals, researchers, etc. Article 51 of the 2018 Social Security Financing Act introduced a mechanism for experimenting with new healthcare organisations based on new financing methods. Thanks to this mechanism, the ARS Paca has set up a care pathway to improve the surgical management of obesity. It allows patients suffering from severe obesity and receiving surgical treatment to access a complete and relevant care pathway at no extra cost and to involve them in their care. Other innovative projects have also been launched, such as the deployment of advanced practice, which supports the training of private nurses. The e-Parcours programme aims to deploy digital coordination services in order to improve patients’ healthcare pathways. It enables professionals, whatever their sector of activity, to coordinate by securing and streamlining exchanges. ARS PACA supports the development of telemedicine, which uses information and communication technologies and offers new possibilities for
improving access to care and bringing medical expertise closer to patients.
In your opinion, what are the major public health issues in the South of France and how is ARS PACA trying to respond to them?


The PACA region is marked by great geographical, demographic, economic, social, urban and environmental diversity. These characteristics give rise to specific needs which influence the consumption and supply of care and must necessarily be taken into account in public health priorities. The analysis of the state of health of the regional population, the response to the health needs expressed by patients and their families, and the implementation of the national health strategy in our territory are translated into regional public health issues and priorities. These priorities govern the orientations of the plans, the actions selected by the calls for projects and the allocation of resources:
� To take into account the needs of an ageing population
�Implement a comprehensive policy for children and young people
�Offer a range of diversified responses to people with disabilities
�Strengthen mental health policy to meet future challenges
�Continue to reduce premature mortality
�Organise the management of chronic diseases
�Reduce the impact on health of exposure to environmental risks.
73 April 2023
© ARS PACA ©
An interview with Mr. Philippe DE MESTER, Outgoing Director General of ARS PACA
ARS PACA
Santé et biotechs : des thérapies innovantes au service de la médecine de demain
Biotechnologies médicales, cancérologie, immunothérapie, bio-informatique, intelligence artificielle, santé numérique, entrepreneuriat healthtech : la médecine de demain se construit aujourd’hui en régions Sud et Occitanie.
La région Sud figure parmi les régions leaders en santé avec une chaîne de valeur complète, des entreprises pionnières et un potentiel scientifique de rang international dans les biotechnologies médicales, le diagnostic, la cancérologie, l’infectiologie et l’immunothérapie, les dispositifs médicaux et la santé numérique de demain. Avec un réseau hospitalier parmi les plus denses de France, elle dispose d’un ensemble de plateformes de recherche translationnelle, d’une forte activité de recherche clinique industrielle et académique et se positionne comme 2ème territoire d’essais cliniques à l’échelle nationale. Le territoire régional compte 170 000 salariés dans la santé (publics & privés) dont 6 000 sur les thérapies innovantes, 39 000 étudiants en sciences de la santé, de nombreux chercheurs-entrepreneurs, des plateformes de recherche mutualisées, des grandes entreprises et des PME innovantes en lien avec les marchés-cibles : Innate Pharma, Imcheck Therapeutics, Biotech Dental, Beaufour Ipsen Industrie, Neuroservice, Nuvisan France, Provepharm Life Solutions, Sangamo Therapeutics, Sanofi, Sartorius, Veracyte EU Headquarters, Virbac, Laboratoire Genevrier ou encore Median Technologies.
La filière s’articule notamment autour des sites d’excellence de Marseille (bioparc de Luminy, cluster Marseille Immunopôle, IHU Méditerranée Infection…) et de Sophia Antipolis, 1ère technopole européenne en matière d’innovation. Appuyés par l’OIR (opération d’intérêt régional) Thérapies innovantes, ces acteurs de la healthtech sont regroupés au sein d’Eurobiomed, premier pôle santé en Europe du Sud. La Région Sud a également souhaité développer un Plan Cancer pour la période 2022-2027. Doté de 40 M€, il vise 4 grands enjeux de santé : améliorer le dépistage et la prévention, renforcer l’offre de soins et d’accompagnement des malades et de leurs familles, développer la recherche autour de projets différenciants autour des usages de l’IA ou de l’expérimentation de nouveaux traitements, et renforcer les innovations et leurs retombées économiques.

Faire de la région Sud le territoire leader de l’entrepreneuriat healthtech à fort potentiel Dans le cadre de l’OIR 2016-2021, six projets ont été accompagnés par le plateau d’accélération des OIR et huit ont été présentés en Comité d’ingénierie financière.
L’action a porté sur le renforcement du soutien aux entreprises innovantes (projet Go4BioBusiness porté par Eurobiomed, pépinière Grand Luminy, reconversion du site Galderma en bioparc dans les Alpes-Maritimes), le renforcement de l’accès aux marchés via des projets collaboratifs de R&D et des plateformes, des manifestations en lien avec l’attractivité des acteurs (salons Biofit, BioUSA et Bio Japan, accueil en région du Congrès de l’AFSSI), ainsi que des initiatives dédiées pour lever les verrous identifiés dans la feuille de route (MI Jobs sur les talents, Comité « Invest in biomed » d’Eurobiomed pour renforcer les fonds propres, investissements dans Sartorius Stedim Biotech à Aubagne ou Sanofi à Sisteron pour renforcer leurs capacités industrielles).
D’ici 2028 l’ambition de l’OIR Thérapies innovantes est de faire de la région Sud le territoire leader de l’entrepreneuriat healthtech à fort potentiel au service de la médecine et des thérapies de demain. Trois axes prioritaires d’action et d’investissement structurent la nouvelle feuille de route : renforcer l’excellence académique régionale et la recherche translationnelle (développer l’offre de formation, favoriser l’entrepreneuriat et le transfert de l’innovation, renforcer les capacités de recherche clinique, attirer les talents), accompagner le développement d’entreprises leaders positionnées sur les segments-clés des thérapies innovantes et attirer les cham-
pions de demain (parcours résidentiel lisible pour les entreprises innovantes en santé, fonds d’investissement spécialisés, accélération de la production de biomédicaments, déploiement de projets en matière de santé numérique), et renforcer le leadership et l’attractivité de la région Sud en favorisant le développement de pôles d’excellence et les collaborations public-privé (conforter les principaux écosystèmes territoriaux d’excellence autour d’offres de services intégrées, renforcer les collaborations telles que le projet Biocluster Marseille Immunologie, renforcer l’écosystème régional en immunologie et oncologie, accompagner la rencontre entre usages et innovations, contribuer à une souveraineté nationale en santé)1
L’IA au service de la santé
S’appuyant sur 48 chaires, 54 doctorants, 16 post-doctorants, 140 entreprises partenaires, 57 contrats, 4 start-ups et 23 certifications de formation avec un contenu en IA, le 3IA Côte d’Azur a dédié 2 de ses 4 axes de recherche à la santé. L’axe «AI for Integrative Computational Medicine» s’articule autour de 3 thématiques : l’IA basée sur la biophysique (apprentissage des paramètres biophysiques pour le diagnostic quantitatif, prédiction de l’évolution des pathologies et de l’effet des thérapies (jumeau numérique), augmentation des données à partir de la simulation biophysique), la gestion des données médicales (Medical Data Lab
74 Avril 2023
Lymphocytes infiltrant la tumeur (TIL) lors d’un cancer colorectal - Coloration Hématoxyline-Eosine / Tumour-infiltrating lymphocytes (TIL) in colorectal cancer - Haematoxylin-Eosin staining
© Nephron
(UCA Idex), Health Data Hub, EDS APHP, bases de données internationales, sécurité, confidentialité, GDPR en collaboration avec d’autres instituts 3IA) et l’IA axée sur les données (biomarqueurs d’imagerie et omiques (génétique, transcriptomique, protéomique, métabolomique) et mode de vie, comportement, etc. pour la sélection des patients, analyse vidéo et capteurs pour le suivi des patients). Pour sa part, l’axe « AI for Computational Biology and Bio-inspired AI » est structuré en deux enjeux que sont la biologie computationnelle (molécules, réseaux, cellules et tissus, cerveau) et l’IA bio-inspirée (niveau neuronal, cognition et simulation / électronique)2.
Le campus SophiaTech n’est pas en reste. Situé au cœur de Sophia-Antipolis, première technopole européenne et l’un des berceaux mondiaux du numérique, ce lieu d’enseignement, de recherche, d’innovation et d’expérimentation pour les technologies du futur accueille plus de 2 500 étudiants pour un effectif total de 3 500 personnes. Les chercheurs des laboratoires I3S, LEAT, Centre de recherche Inria, Polytech’Lab, EURECOM et Mines ParisTech y travaillent en synergie dans un écosystème fertile grâce à la présence de nombreux acteurs de l’innovation (SoFab, KIC EIT ICT Labs, Maison de l’intelligence artificielle, Pôle de Compétitivité SCS, Telecom Valley, SATT Sud-Est, incubateurs de start-ups, etc.), à la proximité immédiate des 2 500 entreprises que compte Sophia Antipolis mais aussi de l’IPMC (Institut de Pharmacologie Moléculaire et Cellulaire)3.
Focus sur le centre Inria d’Université Côte d’Azur : créé en 1983, il s’inscrit dans le développement des sites de Sophia Antipolis et de Nice, avec l’Université Côte d’Azur. Il est également implanté à Montpellier où il accompagne le développement de l’Université de Montpellier et la dynamique de l’I-site MUSE. Fort de 35 équipes-projets, 10 lauréates et lauréats ERC dans les équipes-projets et 15 startups issues de ces dernières, il consacre à la santé un axe scientifique prioritaire : la médecine, les neurosciences et la biologie computationnelles. Par ailleurs, le centre accompagne le développement d’une antenne Inria sur le site de Montpellier, dont l’un des objectifs concerne la spécialisation de l’antenne sur la médecine et la science des données. À titre d’exemple, l’équipe-projet ABS (Algorithmes et Biologie Structurale) utilise des implémentations éprouvées et optimisées d’algorithmes, intégrées à la Structural Bioinformatics Library, pour étudier des systèmes d’importance critique en biologie et médecine en collaboration avec des collègues biologistes et bio-physiciens4
Oncologie : des technologies innovantes pour la culture cellulaire, l’analyse et les modèles in-vitro Être un acteur essentiel de l’innovation thérapeutique en PACA : telle est l’ambition du Canceropôle PACA fondé en 2003 par l’AP-HM, Aix-Marseille Université, le Centre Antoine Lacassagne, le CHU de Nice, le CNRS, l’Institut Paoli-Calmettes, l’Université Côte d’Azur et l’Inserm. Avec plus de 20 M€ investis pour la recherche régionale depuis 2003, plus de 250 plateformes, actions et projets financés et animés, 650 chercheurs activement impliqués et plus de 50 partenaires associés, il porte plusieurs actions structurantes en réponse aux besoins de la communauté régionale : PETRA Network (Réseau PrEclinique et TRAnslationnel de recherche en neuro-oncologie), CRISPR Screen Action (une technologie révolutionnaire de modification du génome), la Plateforme 3D-Hub (des modèles de culture 3D en cancérologie), BioInformatique (pour renforcer l’expertise et la puissance d’analyse des équipes), Single cell (une plateforme multisites ouverte à toute la communauté régionale), Métabolomique (de nouveaux moyens d’analyses pour les projets des entreprises), Histopathologie expérimentale et microscopie virtuelle (l’imagerie de lames pour une interprétation partagée de l’analyse de tissus), la Cohorte des Leucémies de l’Enfant et de l’Adolescent (LEA, un support de données pour les recherches) ainsi que la Plateforme Nationale Qualité de Vie et Cancer (idem).

1 Source : Région Sud PACA.
2 Source : 3IA Côte d’Azur.
3 Source : Campus SophiaTech.
4 Source : Centre Inria d’Université Côte d’Azur.
5 Source : Cancéropôle PACA.
À ces actions structurantes s’ajoutent une large gamme d’appels à projets (Émergence, SHS-E-SP Équipement, Prématuration, Recherche translationnelle et clinique, Événements, Mobilité), diverses actions d’accompagnement (recrutement, financement, export, publications, dissémination des résultats), d’animation et de networking. Parmi les success-stories, citons l’aide du Canceropôle à une technologie bioélectronique de rupture pour les modèles in-vitro : le Pr Róisín Owens, biochimiste travaillant au sein du Centre microélectronique de Provence (Gardanne) a pu bénéficier d’une assistance-conseil pour soumettre aux fonds de l’European research council (ERC) son projet IMBIBE, qui vise à développer une solution technologique innovante pour explorer les effets du microbiome sur les physiopathologies de l’intestin (dont le cancer colorectal) et du cerveau. Résultat : la chercheuse a obtenu une bourse ERC Consolidator de 2 M€ - la reconnaissance d’un parcours scientifique particulièrement prometteur5
Entourer le patient, encercler la maladie
La recherche et l’innovation sont tout aussi dynamiques en Occitanie. Entourer le patient, encercler la maladie : c’est le credo de l’IUCT-Oncopole de Toulouse. Ce centre de soin, de recherche et de formation en cancérologie regroupe l’expertise de 1 800 professionnels sur un même site labellisé « Comprehensive Cancer Center » avec plusieurs installations cliniques de pointe pour le traitement du cancer et une infrastructure de recherche de classe mondiale sur un campus intégré qui rassemble des parties prenantes publiques et privées, y compris des partenaires industriels. L’IUCT-Oncopole, qui réunit l’Institut Claudius Regaud (ICR)
75 April 2023
© Wiki210397
Bioréacteur Biostat A de Sartorius Stedim Biotech, une entreprise basée à Aubagne qui fournit des équipements et des services destinés aux processus de développement, d’assurance qualité et de production dans l’industrie biopharmaceutique / Biostat A bioreactor from Sartorius Stedim Biotech, an Aubagne-based company that provides equipment and services for development, quality assurance and production processes in the biopharmaceutical industry
et plusieurs équipes du CHU de Toulouse, traite plus de 10 000 nouveaux patients chaque année, et plus d’un patient sur huit est inscrit dans des études cliniques. En 2021 il a enregistré 691 publications, 336 essais cliniques ouverts aux inclusions et 1 744 patients inclus dans un essai.
L’IUCT-Oncopole rassemble les expertises d’un continuum allant de la recherche fondamentale à la recherche clinique. La recherche fondamentale est composée de 18 équipes du Centre de recherches en cancérologie de Toulouse (CRCT) et 164 chercheurs. Les équipes de recherche translationnelle disposent de plateformes de biologie moléculaire et génétique et d’un des plus importants services d’anatomopathologie d’Europe. Le centre de ressources biologiques regroupe tous les échantillons tumoraux de la cancérologie du CHU et de l’Institut Claudius Regaud. L’IUCT-Oncopole abrite également un Centre labellisé INCa phases précoces (CLIPP) et un service de pharmacologie référent en France.



Le 1er février 2022, à l’occasion de la journée mondiale contre le cancer qui a lieu chaque année le 4 février, la société de biotechnologie Transgene, l’IUCT-Oncopole et l’association de patients Corasso sont revenus sur les avancées du vaccin personnalisé qui fait l’objet de deux essais cliniques de phase I, l’un concernant certains cancers de la tête et du cou (les cancers ORL qui ne sont pas liés au papillomavirus) et l’autre, les cancers de l’ovaire. Ces deux essais sont les seuls portant sur un vaccin personnalisé menés en France (à l’Oncopole et à l’Institut Curie) en vue de diminuer les risques de récidive. TG4050, le vaccin thérapeutique personnalisé développé par Transgene, est issu de l’expertise du japonais NEC, leader mondial dans le domaine de l’intelligence artificielle (IA), et s’appuie sur des technologies et un positionnement uniques : des essais en monothérapie afin de suivre la réponse immunitaire déclenchée par la seule action du vaccin, une technologie qui repose sur des vecteurs viraux (des virus atténués de la vaccine, avec une très bonne tolérance et une réponse immunitaire durable induisant des lymphocyte « mémoires »), un

ciblage large avec 30 mutations tumorales concernées et une réponse en moyenne contre 10 néoantigènes (protéines présentes uniquement à la surface des cellules tumorales), vs 5 pour les autres produits similaires actuellement en essais cliniques.
En 2020, ce vaccin est entré en évaluation clinique pour les patients atteints d’un cancer ORL non viro-induit et pour les femmes atteintes d’un cancer de l’ovaire, dans le cadre d’un essai international de phase I. Le premier patient inclus et recevant ce traitement innovant a été pris en charge à l’Oncopole. Plus de 15 patients, sur un objectif de 30 environ visés pour ces essais, ont déjà reçu le vaccin avec des résultats encourageants : tous les patients qui ont reçu le vaccin ont présenté une réponse immunitaire et, chez ceux atteints d’un cancer de la tête et du cou et ayant reçu TG4050, aucun n’a subi de rechute. Deux patients ont quant à eux déjà rechuté dans le bras de contrôle suivi dans le cadre de cet essai randomisé. Ces patients ont pu bénéficier du vaccin depuis le diagnostic de récidive6

En outre, l’IUCT-Oncopole accueille sur son site plusieurs projets innovants dont le Labex TOUCAN (Analyse intégrée de la résistance dans les cancers hématologiques), porté par les équipes toulousaines de la Fondation Recherche Innovation Thérapeutique Cancérologie. TOUCAN vise en effet à comprendre les mécanismes de résistance et de rechute dans les cancers du sang et par extension dans certains cancers solides. S’appuyant sur 6 équipes de recherche, une plateforme reconnue pour son expertise en microscopie virtuelle et en analyse d’images et une Cellule bio-informatique de l’Institut universitaire du cancer de Toulouse (IUCT) et du Centre de recherche en Cancérologie de Toulouse (CRCT), il s’efforce de trouver des biomarqueurs de résistance des cancers hématopoïétiques ainsi que des cibles thérapeutiques potentielles permettant de contourner ces résistances. Ces travaux, portés par 30 ingénieurs et techniciens, 28 doctorants, 50 chercheurs et enseignants-chercheurs permanents ainsi que 6 praticiens hospitaliers, ont déjà produit des résultats significatifs : le métabolisme mitochondrial soutient la résistance aux inhibi-



teurs des mutants de l’IDH (une enzyme) dans la leucémie myéloïde aiguë, les lymphocytes T matures transformés par la tyrosine kinase oncogène (ALK) restaurent les caractéristiques des progéniteurs précoces du thymus et l’activité de la Focal-Adhesion Kinase (FAK) dans les fibroblastes associés au cancer est un marqueur pronostique et un acteur métastatique clé médicamentable dans le cancer du pancréas. Des perspectives appréciables pour améliorer la qualité de vie des patients7
Owkin : l’IA au service de la médecine de précision
Le 19 janvier 2023, Owkin, biotech spécialisée dans l’IA appliquée à la recherche médicale, a publié ses derniers résultats dans Nature Medicine sur les avantages de l’IA et de l’apprentissage fédéré pour la médecine de précision. Ces résultats démontrent pour la première fois que l’apprentissage fédéré peut être utilisé pour entraîner des modèles de deep learning sur des données d’histopathologie provenant simultanément de plusieurs hôpitaux, ces dernières restant à l’abri derrière les pare-feux des hôpitaux d’où elles proviennent. Cette découverte, à laquelle l’IUCT-Oncopole de Toulouse a participé, ouvre la voie à une recherche médicale dont l’un des moteurs serait l’IA utilisant de plus grands ensembles de données multicentriques. Ce qui permettrait aux modèles d’échapper aux biais des études monocentriques et, à terme, de réaliser des percées dans la médecine de précision grâce à l’utilisation d’une IA sécurisée préservant la confidentialité et la gouvernance des données8





6 Source : IUCT-Oncopole de Toulouse.
7 Source : Labex TOUCAN.
8 Source : Transgene - IUCT-Oncopole de Toulouse
- Corasso, « Vaccins individualisés contre le cancer : des résultats encourageants présentés aujourd’hui à Toulouse », communiqué de presse du 1er février 2022.

76 Avril 2023
Health and biotech: innovative therapies for tomorrow’s medicine

Medical biotechnologies, oncology, immunotherapy, bioinformatics, artificial intelligence, digital health, healthtech entrepreneurship: the medicine of tomorrow is being built today in the South and Occitania regions.
The South region is one of the leading health regions with a complete value chain, pioneering companies and an international scientific potential in medical biotechnology, diagnostics, oncology, infectious diseases and immunotherapy, medical devices and the digital health of tomorrow. With one of the densest hospital networks in France, the region has a number of translational research platforms, a strong industrial and academic clinical research activity and is the 2nd largest clinical trial area in France. The region has 170,000 employees in the health sector (public and private), including 6,000 in innovative therapies, 39,000 students in the health sciences, numerous researcher-entrepreneurs, shared research platforms, large companies and innovative SMEs linked to the target markets: Innate Pharma, Imcheck Therapeutics, Biotech Dental, Beaufour Ipsen Industrie, Neuroservice, Nuvisan France, Provepharm Life Solutions, Sangamo Therapeutics, Sanofi, Sartorius, Veracyte EU Headquarters, Virbac, Laboratoire Genevrier and Median Technologies.
The sector is based around the sites of excellence in Marseille (Luminy biopark, Marseille Immunopôle cluster, IHU Méditerranée Infection, etc.) and Sophia Antipolis, Europe’s leading technology park in terms of innovation. Supported by the OIR (operation of regional interest) Innovative Therapies, these healthtech players are grouped together within Eurobiomed, the leading health cluster in Southern Europe. The Southern Region has also developed a Cancer Plan for the period 2022-2027. With a budget of €40 million, it aims to address four major health issues: improving screening and prevention, strengthening the supply of care and support for patients and their families, developing research around differentiating projects based on the use of AI or the testing of new treatments, and strengthening innovations and their economic impact.
Making the South region the leading territory for high-potential healthtech entrepreneurship
Within the framework of the OIR 20162021, six projects were supported by the RIO Acceleration Platform and eight were presented to the Financial Engineering Committee. The action focused on strengthening
support for innovative companies (Go4BioBusiness project led by Eurobiomed, Grand Luminy incubator, conversion of the Galderma site into a biopark in the Alpes-Maritimes), strengthening access to markets via collaborative R&D projects and platforms, events linked to the attractiveness of players (Biofit, BioUSA and Bio Japan trade fairs, hosting the AFSSI Congress in the region), as well as dedicated initiatives to remove the barriers identified in the roadmap (MI Jobs on talents, Eurobiomed’s «Invest in biomed» Committee to strengthen equity capital, investments in Sartorius Stedim Biotech in Aubagne or Sanofi in Sisteron to strengthen their industrial capacities).
By 2028, the ambition of the Innovative Therapies OIR is to make the South Region the leading territory for high-potential healthtech entrepreneurship in the service of the medicine and therapies of tomorrow. Three priority areas of action and investment structure the new roadmap: strengthening regional academic excellence and translational research (developing the training offer, encouraging entrepreneurship and the transfer of innovation, strengthening clinical research capacities, attracting talent), supporting the development of leading companies positioned
in the key segments of innovative therapies and attracting the champions of tomorrow (clear residential pathway for innovative health companies, specialised investment funds, acceleration of the production of biomedicines, deploying digital health projects), and strengthening the leadership and attractiveness of the South region by promoting the development of centres of excellence and public-private collaborations (consolidating the main territorial ecosystems of excellence around integrated service offers, strengthening collaborations such as the Marseille Immunology Biocluster project, reinforcing the regional immunology and oncology ecosystem, supporting the meeting of uses and innovations, contributing to national sovereignty in health).
AI in the service of health
With 48 chairs, 54 doctoral students, 16 post-doctoral students, 140 partner companies, 57 contracts, 4 start-ups and 23 training certifications with AI content, the 3IA Côte d’Azur has dedicated 2 of its 4 research axes to health. The «AI for Integrative Computational Medicine» axis is based on 3 themes: AI based on biophysics (learning biophysical parameters for quantitative diagnosis, prediction of the evolution
77 April 2023
© KGH
Histopathological image of multiple myeloma. Bone marrow aspirates. Hematoxylin & esoin stain. Image histopathologique d’un myélome multiple. Aspirats de moelle osseuse. Coloration à l’hématoxyline et à l’ésoin.
of pathologies and the effect of therapies (digital twin), data augmentation from biophysical simulation), medical data management (Medical Data Lab (UCA Idex), Health Data Hub, EDS APHP, international databases, security, privacy, GDPR in collaboration with other 3IA institutes) and data-driven AI (imaging and omics biomarkers (genetics, transcriptomics, proteomics, metabolomics) and lifestyle, behaviour, etc. for patient selection, video analysis and sensors for patient monitoring). For its part, the «AI for Computational Biology and Bio-inspired AI» axis is structured around two issues: computational biology (molecules, networks, cells and tissues, brain) and bio-inspired AI (neuronal level, cognition and simulation/electronics).
The SophiaTech campus is not to be outdone. Located in the heart of Sophia-Antipolis, Europe’s leading technology park and one of the world’s cradles of digital technology, this place of education, research, innovation and experimentation for the technologies of the future welcomes more than 2,500 students for a total workforce of 3,500 people. Researchers from the I3S, LEAT, Inria research centre, Polytech’Lab, EURECOM and Mines ParisTech laboratories work in synergy in a fertile ecosystem thanks to the presence of numerous innovation players (SoFab, KIC EIT ICT Labs, Maison de l’intelligence artificielle, SCS competitiveness cluster, Telecom Valley, SATT Sud-Est, start-up incubators, etc.), in the immediate vicinity of the 2,500 companies in Sophia Antipolis and the IPMC (Institute of Molecular and Cellular Pharmacology).
Focus on the Inria centre of the Université Côte d’Azur: created in 1983, it is part of the development of the Sophia Antipolis and Nice sites, with the Université Côte d’Azur. It is also based in Montpellier where it supports the development of the University of Montpellier and the dynamics of the MUSE I-site. With 35 project-teams, 10 ERC laureates in the project-teams and 15 start-ups resulting from the latter, it devotes a priority scientific axis to health: medicine, neurosciences and computational biology. In addition, the centre is supporting the development of an Inria branch on the Montpellier site, one of the objectives of which is to specialise in medicine and data science. For example, the ABS (Algorithms and Structural Biology) project-team uses proven and optimised implementations of algorithms, integrated into the Structural Bioinformatics Library, to study systems of critical importance in biology and medicine in collaboration with biologist and biophysicist colleagues.
Oncology: innovative technologies for cell culture, analysis and in-vitro models
To be a key player in therapeutic innovation in the PACA region: this is the ambition of the PACA Canceropole, which was founded in 2003 by the AP-HM, Aix-Marseille University, the Antoine Lacassagne Centre, the Nice University Hospital, the CNRS, the Paoli-Calmettes Institute, the Côte d’Azur University and Inserm. With more than 20 M€ invested in regional research since 2003, more than 250 platforms, actions and projects financed and run, 650 researchers actively involved and more than 50 associated partners, it has several structuring actions in response to the needs of the regional community: PETRA Network (PrEclinical and TRAnslational Research Network in Neuro-Oncology), CRISPR Screen Action (a revolutionary genome modification technology), the 3D-Hub Platform (3D culture models in oncology), BioInformatics (to strengthen the expertise and analysis power of the teams), Single cell (a multi-site platform open to the entire regional community), Metabolomics (new analysis resources for company projects), Experimental Histopathology and Virtual Microscopy (slide imaging for shared interpretation of tissue

analysis), the Child and Adolescent Leukaemia Cohort (LEA, a data support for research) and the National Quality of Life and Cancer Platform (idem).
In addition to these structuring actions, there is a wide range of calls for projects (Emergence, SHS-E-SP Equipment, Prematurity, Translational and Clinical Research, Events, Mobility), various support actions (recruitment, financing, export, publications, dissemination of results), animation and networking. Among the success stories, let’s mention the Canceropole’s support for a breakthrough bioelectronic technology for in-vitro models: Prof. Róisín Owens, a biochemist working at the Provence Microelectronics Centre (Gardanne), was able to benefit from consulting assistance to submit her IMBIBE project to the European Research Council (ERC) for funding. The project aims to develop an innovative technological solution to explore the effects of the microbiome on intestinal pathophysiology (including colorectal cancer) and the brain. The result: the researcher was awarded an ERC Consolidator grant of €2 million - the recognition of a particularly promising scientific career.
78 Avril 2023
Three-dimensional structure of a protein in structural bioinformatics Structure tridimensionnelle d’une protéine en bioinformatique structurale
© Andrei Lomize
Surrounding the patient, encircling the disease


Research and innovation are just as dynamic in Occitania. Surrounding the patient, encircling the disease: this is the credo of the IUCT-Oncopole in Toulouse. This cancer care, research and training centre brings together the expertise of 1,800 professionals on a single site labelled «Comprehensive Cancer Center» with several state-of-the-art clinical facilities for cancer treatment and a world-class research infrastructure on an integrated campus that brings together public and private stakeholders, including industrial partners. The IUCT-Oncopole, which brings together the Claudius Regaud Institute (ICR) and several teams from the Toulouse University Hospital, treats more than 10,000 new patients each year, and more than one in eight patients is enrolled in clinical studies. In 2021, it recorded 691 publications, 336 clinical trials open for inclusion and 1,744 patients included in a trial.
The IUCT-Oncopole brings together the expertise of a continuum ranging from basic research to clinical research. Basic research is composed of 18 teams from the Toulouse Cancer Research Centre (CRCT) and 164 researchers. The translational research teams have molecular and genetic biology platforms and one of the largest anatomopathology departments in Europe. The biological resource centre brings together all the tumour samples from the cancerology department of the University Hospital and the Claudius Regaud Institute. The IUCT-Oncopole also houses an INCa-labelled early phase centre (CLIPP) and a pharmacology department that is a reference in France.



On 1 February 2022, on the occasion of World Cancer Day which takes place every year on 4 February, the biotechnology company Transgene, the IUCT-Oncopole and the patient association Corasso reported on the progress of the personalised vaccine which is the subject of two phase I clinical trials, one concerning certain head and neck cancers (ENT cancers which are not linked to the papillomavirus) and the other, ovarian
cancers. These two trials are the only ones involving a personalised vaccine conducted in France (at Oncopole and Institut Curie) with the aim of reducing the risk of recurrence. TG4050, the personalised therapeutic vaccine developed by Transgene, is the result of the expertise of Japanese company NEC, a world leader in the field of artificial intelligence (AI), and is based on unique technologies and positioning: single-agent trials to monitor the immune response triggered by the action of the vaccine alone, a technology based on viral vectors (attenuated vaccinia viruses, with very good tolerance and a lasting immune response inducing «memory» lymphocytes), broad targeting with 30 tumour mutations concerned and an average response against 10 neoantigens (proteins present only on the surface of tumour cells), compared with 5 for other similar products currently in clinical trials.
In 2020, the vaccine entered clinical evaluation in patients with non-viral-induced ENT cancer and in women with ovarian cancer in an international phase I trial. The first patient included and receiving this innovative treatment was managed at Oncopole. More than 15 patients, out of a target of approximately 30 for these trials, have already received the vaccine with encouraging results: all patients who received the vaccine showed an immune response and none of those with head and neck cancer who received TG4050 suffered a relapse. Two patients have already relapsed in the control arm of this randomised trial. These patients have been able to benefit from the vaccine since the diagnosis of recurrence.

In addition, the IUCT-Oncopole hosts several innovative projects on its site, including the TOUCAN Labex (Integrated Analysis of Resistance in Haematological Cancers), led by the Toulouse teams of the Fondation Recherche Innovation Thérapeutique Cancérologie. TOUCAN aims to understand the mechanisms of resistance and relapse in blood cancers and by extension in certain solid cancers. With the support of 6 research teams, a platform recognised for its expertise in virtual microscopy and image analysis,

and a bioinformatics unit of the Toulouse University Cancer Institute (IUCT) and the Toulouse Cancer Research Centre (CRCT), it is striving to find biomarkers of resistance in haematopoietic cancers as well as potential therapeutic targets that would make it possible to circumvent this resistance. This work, carried out by 30 engineers and technicians, 28 doctoral students, 50 researchers and permanent teacher-researchers as well as 6 hospital practitioners, has already produced significant results: mitochondrial metabolism supports resistance to inhibitors of IDH mutants (an enzyme) in acute myeloid leukaemia, mature T cells transformed by the oncogenic tyrosine kinase (ALK) restore the characteristics of early progenitors in the thymus, and Focal-Adhesion Kinase (FAK) activity in cancer-associated fibroblasts is a prognostic marker and a key drugable metastatic player in pancreatic cancer. Significant potential to improve patient quality of life.



Owkin: AI for precision medicine
On 19 January 2023, Owkin, a biotech specialising in AI applied to medical research, published its latest results in Nature Medicine on the benefits of AI and federated learning for precision medicine. These results demonstrate for the first time that federated learning can be used to train deep learning models on histopathology data from multiple hospitals simultaneously, with the data remaining behind the firewalls of the hospitals from which it originated. This discovery, in which the IUCT-Oncopole in Toulouse participated, opens the way for medical research in which one of the drivers would be AI using larger multicentre data sets. This would allow models to escape the biases of single-centre studies and ultimately lead to breakthroughs in precision medicine through the use of secure AI that preserves data privacy and governance.




79 April 2023
Une recherche translationnelle et pluridisciplinaire au bénéfice des patients
Un entretien avec le Pr Norbert VEY, Professeur d’Hématologie à Aix-Marseille Université, Directeur Général de l’Institut Paoli Calmettes (IPC)

En quoi consiste le programme clinique et translationnel Leucémie et Hémopathies Myéloïdes ?
Quels sont les grands axes de la recherche clinique de l’Institut Paoli Calmettes ? Nos priorités sont le cancer du sein, le cancer du pancréas et les leucémies aigues grâce à nos importantes cohortes de patients : elles nous permettent d’organiser un continuum entre la recherche fondamentale (portée par le Centre de Cancérologie de Marseille - CRCM), la recherche clinique et l’offre de soins. Par ailleurs nous nous focalisons sur 3 sujets principaux, à savoir la médecine personnalisée (profils moléculaires des tumeurs et testing in vitro pour mesurer leur sensibilité à différents médicaments et prédire les effets de différents traitements) ; l’immunothérapie autour des anticorps monoclonaux mais également de la thérapie cellulaire ; les sciences humaines et sociales (empowerment du patient par l’information et l’onco-coaching, modélisations économiques…).
Pourriez-vous nous donner quelques exemples de projets de recherche en cours ?
Dans le cadre d’un partenariat avec la société marseillaise Innate Pharma, spécialisée dans l’immunothérapie pour le traitement du cancer, l’Institut conduit la phase I du développement d’un anticorps anti-CD73 dans le cancer du sein. Nous pilotons aussi un projet de sciences humaines et sociales en onco-coaching, qui consiste à utiliser les techniques de coaching réservées aux sportifs de haut niveau pour aider les patients à rebondir après un cancer. Cette stratégie nouvelle fait l’objet d’une étude prospective randomisée (essai REBOND-2) auprès de patients ayant reçu une greffe de moelle osseuse après une leucémie aigüe.

Ce programme assure un continuum de la recherche fondamentale jusqu’au lit du patient. Il s’appuie sur trois piliers : une collection d’échantillons de cellules tumorales à partir de prises de sang ou de ponctions de la moelle osseuse, une équipe pluridisciplinaire (cliniciens et chercheurs débattent des molécules d’intérêt pour de futures études) et des essais cliniques de nouveaux médicaments issus de nos propres équipes de recherche ou non. Nous avons d’ailleurs été chargés par la société parisienne Inatherys de conduire une étude de première administration chez l’homme d’un anticorps immunoconjugué, une molécule de chimiothérapie vectorisée par cet anticorps pour se fixer sur les cellules leucémiques. Une thérapie ciblée en somme.
Pourriez-vous nous présenter les activités du Centre Labellisé D’Essais de Phase Précoce (CLIP²) ?
Le CLIP² a reçu un label et un financement de l’INCa pour structurer ses essais de phase I, I-II et II. C’est important pour satisfaire les exigences élevées en matière de sécurité des patients et donner de l’ampleur à nos travaux. En outre, notre CLIP² se distingue par une activité mixte, orientée à la fois vers l’hématologie et les tumeurs solides : le rapprochement de ces aires thérapeutiques d’habitude séparées est fort utile pour partager les avancées des connaissances. Chaque année 200 à 250 patients sont inclus dans
les essais de phase précoce à l’IPC. Cette activité permet d’offrir un accès à l’innovation aux patients ayant épuisé les solutions thérapeutiques conventionnelles. Nous recrutons principalement des patients de la région PACA, mais aussi plus largement au niveau national.
Quels sont selon vous les grands enjeux de la recherche en hématologie ?
Il y a selon moi deux grandes priorités : les thérapies ciblées et l’immunothérapie pour le traitement des leucémies. La route est encore longue malgré les progrès réalisés et nous avons tout intérêt à appliquer à ces pathologies complexes les découvertes de nouveaux produits actifs et la compréhension des mécanismes de dérèglement des cellules cancéreuses. Il est urgent de sortir de son silo, de rassembler chercheurs, cliniciens, physiciens, mathématiciens pour faire progresser nos connaissances de toutes les pathologies. Il faut aussi tisser des liens avec des entreprises de biotechnologie et des pharmas pour accélérer la diffusion des avancées vers les patients. C’est ce que nous faisons, par exemple avec ImCheck Therapeutics, une start-up co-fondée par l’un des chercheurs de l’Institut. À l’origine d’innovations dans le domaine de la modulation du système immunitaire, elle conçoit la prochaine génération d’anticorps immunothérapeutiques pour le traitement du cancer et en particulier des leucémies. Son gros potentiel est de bon augure pour l’attractivité de l’écosystème marseillais !
80 Avril 2023
©
© Institut Paoli Calmettes
Institut Paoli Calmettes
Translational and multidisciplinary research for the benefit of patients
of new drugs from our own research teams or not. We have also been commissioned by the Paris-based company Inatherys to conduct a study of the first administration in humans of an immunoconjugated antibody, a chemotherapy molecule vectored by this antibody to bind to the leukaemia cells. A targeted therapy in short.
Could you tell us about the activities of the Centre Labellisé D’Essais de Phase Précoce (CLIP²)?
CLIP² has received a label and funding from the INCa (National Cancer Institute) to structure its phase I, I-II and II trials. This is important in order to meet the high requirements for patient safety and to give scale to our work. In addition, our CLIP² is distinguished by its mixed activity, oriented towards both haematology and solid tumours: bringing together these usually separate therapeutic areas is very useful for sharing advances in knowledge. Each year 200 to 250 patients are included in early phase trials at the IPC. This activity allows us to offer access to innovation to patients who have exhausted conventional therapeutic solutions. We mainly recruit patients from the PACA region, but also more widely at national level.
What are the main areas of clinical research at the Institut Paoli Calmettes?
Our priorities are breast cancer, pancreatic cancer and acute leukaemia thanks to our large patient cohorts: they enable us to organise a continuum between fundamental research (carried out by the Marseille Cancer Centre - CRCM), clinical research and the provision of care. In addition, we focus on three main subjects, namely personalised medicine (molecular profiles of tumours and in vitro testing to measure their sensitivity to different drugs and predict the effects of different treatments); immunotherapy based on monoclonal antibodies but also on cell therapy; and human and social sciences (patient empowerment through information and onco-coaching, economic modelling, etc.).
Could you give us some examples of current research projects?
Within the framework of a partnership with the Marseille-based company Innate
Pharma, which specialises in immunotherapy for the treatment of cancer, the Institute is conducting phase I of the development of an anti-CD73 antibody for breast cancer. We are also piloting a human and social sciences project in onco-coaching, which consists of using coaching techniques reserved for top-level athletes to help patients bounce back after cancer. This new strategy is the subject of a randomised prospective study (REBOND-2 trial) in patients who have received a bone marrow transplant after acute leukaemia.
What is the clinical and translational programme Leukaemia and Myeloid Haemopathies?
This programme ensures a continuum from basic research to the patient’s bed. It is based on three pillars: a collection of tumour cell samples from blood samples or bone marrow punctures, a multidisciplinary team (clinicians and researchers discuss molecules of interest for future studies) and clinical trials

In your opinion, what are the major challenges in haematology research?
In my opinion, there are two main priorities: targeted therapies and immunotherapy for the treatment of leukaemia. There is still a long way to go, despite the progress made, and it is in our interest to apply the discoveries of new active products and the understanding of the mechanisms by which cancer cells are disrupted to these complex pathologies. It is urgent to get out of our silos, to bring together researchers, clinicians, physicists and mathematicians to advance our knowledge of all pathologies. We also need to forge links with biotechnology companies and pharmas to speed up the dissemination of advances to patients. This is what we are doing, for example with ImCheck Therapeutics, a start-up co-founded by one of the Institute’s researchers. It is developing the next generation of immunotherapeutic antibodies for the treatment of cancer, particularly leukaemia. Its great potential bodes well for the attractiveness of the Marseilles ecosystem!
81 April 2023
© Institut Paoli Calmettes
An interview with Prof. Norbert VEY, Professor of Haematology at Aix-Marseille University, Director General at the Institut Paoli Calmettes (IPC)
Centre de Recherche en Cancérologie de
Marseille – CRCM
50 ans de recherche pour améliorer le diagnostic et le pronostic des cancers, et leur traitement
Créé en 1972 sur le site de l’Institut Paoli-Calmettes (IPC) avec l’Inserm comme partenaire, le CRCM rassemble 450 personnes de 30 nationalités réparties en 22 équipes et 18 plates-formes technologiques, produit 250 publications par an et forme 90 docteurs en science et une cinquantaine d’étudiants en master par an.
Soutenu par l’Inserm, le CNRS, Aix-Marseille Université et l’IPC, le CRCM s’appuie sur une recherche transversale, du fondamental à la clinique, pour identifier les anomalies dans les cellules tumorales ou immunitaires et faire bénéficier les patients de nouvelles avancées diagnostiques et thérapeutiques. Ses domaines de recherche clinique ciblent les cancers du sein agressifs, les cancers digestifs dont celui du pancréas, les leucémies aigues, le cancer du poumon et les cancers de l’enfant. Des échantillons tumoraux sont prélevés avec le consentement des patients afin de les étudier et produire de nouvelles connaissances utilisables en clinique. Par ailleurs, les axes de recherche fondamentale concernent les mécanismes de l’épigénétique et de l’intégrité du génome et les anomalies chromosomiques retrouvées dans de nombreux cancers, la réponse du système immunitaire des patients lors de la survenue d’un cancer et la communication entre les cellules tumorales et leur environnement, source d’élaboration de nouveaux traitements.
Parmi les projets-phares du CRCM, huit équipes sont impliquées dans un programme de recherche axé sur la compréhension du processus de transition de l’état pré-leucémique à l’état leucémique des patients en vue d’améliorer la prévention et le traitement. De plus, un nouveau bâtiment sera livré fin 2023
sur le site de l’IPC (avec le soutien de l’Inserm, de l’IPC, de la Région, du Département, de la Ville de Marseille, de la Métropole et de la Ligue Contre le Cancer 13) pour accueillir la plus forte concentration d’équipes se consacrant à l’étude du cancer du pancréas pour lequel il existe peu d’options thérapeutiques. Le CRCM s’implique aussi dans la recherche sur le cancer du sein triple négatif qui représente parmi les 15 à 20 % des cancers du sein les plus agressifs.
Depuis sa création, le CRCM s’appuie sur une collaboration très forte avec l’IPC : son activité est située à 20% à la Faculté de Pharmacie et à la Faculté des Sciences et à 80 % sur le campus de l’IPC avec 8 000 m² dédiés à des projets médico-scientifiques proches de l’hôpital. Ce partenariat privilégie l’identification des altérations des cellules tumorales et le développement de procédés technologiques capables de rapidement les diagnostiquer chez les patients. Depuis 5 ans, le CRCM et l’IPC ont multiplié les dépôts de brevets conjoints – des dépôts suivis par des études de faisabilité dans les champs du diagnostic ou de la thérapeutique dans les cancers du sein, du pancréas et des leucémies nécessitant la recherche de financements institutionnels, associatifs et industriels pour passer à la phase de production.
Ce faisant, des chercheurs du CRCM et leurs collaborateurs ont créé 5 entreprises
à partir de brevets déposés. Parmi elles figurent ImCheck Therapeutics, Emergence Therapeutics, toutes deux dans le champ de l’immunothérapie, AB Science, dans le champ des médicaments inhibiteurs de kinases et Ipsogen dans celui des signatures moléculaires. Deux de ces entreprises ont réalisé d’importantes levées de fonds leur permettant de réaliser de premiers essais cliniques en 2023 avec des patients de l’IPC. Au total, ces 5 entreprises représentent plus de 500 emplois à Marseille. Cette dynamique de transfert technologique est à l’œuvre dans le dépôt, en septembre 2022, d’une candidature dans le cadre de l’appel à manifestation d’intérêt Biocluster qui s’inscrit dans la Stratégie 2030 (Marseille a postulé pour la production de médicaments en immunologie) et rassemble le CRCM, l’IPC, l’APHM et d’autres partenaires en recherche.
In fine, le CRCM cherche à mieux appréhender la complexité des cellules cancéreuses et immunitaires pour améliorer le diagnostic, le pronostic et la thérapeutique. Il ambitionne aussi de mieux anticiper l’apparition et l’évolution des cancers afin d’éviter des traitements inutilement lourds, de limiter les effets secondaires pour le patient et de réduire le coût des traitements en collaboration avec ses partenaires de recherche et de formation, avec le soutien constant des patients et de leurs associations.



Publireportage 82 Avril 2023
Cancer
© CRCM © CRCM © CRCM
Anticorps thérapeutiques et immunociblage / Therapeutic antibodies and immuno-targeting
pancréatique / Pancreatic cancer
Biologie
structurale et chimie-biologie intégrée / Structural biology and integrated chemistry-biology
Marseille Cancer Research CentreCRCM

50 years of research to improve the diagnosis and prognosis of cancers and their treatment

Created in 1972 on the site of the Institut Paoli-Calmettes (IPC) with Inserm as a partner, the CRCM brings together 450 people of 30 nationalities in 22 teams and 18 technological platforms, produces 250 publications per year and trains 90 doctors in science and around 50 master’s students per year.
Supported by Inserm, CNRS, Aix-Marseille University and the IPC, the CRCM relies on cross-disciplinary research, from the fundamental to the clinical, to identify anomalies in tumour or immune cells and provide patients with new diagnostic and therapeutic advances. Its clinical research areas target aggressive breast cancer, digestive cancers including pancreatic cancer, acute leukaemia, lung cancer and childhood cancers. Tumour samples are collected with the consent of patients in order to study them and generate new knowledge that can be used in the clinic. In addition, basic research focuses on the mechanisms of epigenetics and genome integrity and the chromosomal abnormalities found in many cancers, the response of the patient’s immune system to the onset of cancer and the communication between tumour cells and their environment, which is the source of new treatments.
Among the CRCM’s flagship projects, eight teams are involved in a research programme focused on understanding the transition process from pre-leukaemia to leukaemia in patients in order to improve prevention and treatment. In addition, a new building will be delivered at the end of 2023 on the IPC site (with the support of Inserm, the IPC, the Region, the Department, the City of Marseille, the Metropolis and the Ligue Contre le Cancer 13) to accommodate the largest concentration of teams dedicated to the
study of pancreatic cancer for which there are few therapeutic options. The CRCM is also involved in research on triple-negative breast cancer, which represents 15-20% of the most aggressive breast cancers.

Since its creation, the CRCM has relied on a very strong collaboration with the IPC: 20% of its activity is located at the Faculty of Pharmacy and Faculty of Sciences, and 80% of its activity is located on the IPC campus with 8,000 m² dedicated to medical-scientific projects close to the hospital. This partnership focuses on the identification of tumour cell alterations and the development of technological processes capable of rapidly diagnosing them in patients. Over the past five years, the CRCM and the IPC have filed numerous joint patents - filings followed by feasibility studies in the fields of diagnosis or therapy in breast, pancreatic and leukaemia cancers, requiring the search for institutional, associative and industrial funding to move on to the production phase.
In the process, CRCM researchers and their collaborators have created five companies based on patents filed. These include ImCheck Therapeutics and Emergence Therapeutics, both in the field of immunotherapy, AB Science, in the field of kinase inhibitor drugs, and Ipsogen in the field of molecular signatures. Two of these companies have raised significant funds enabling
them to carry out their first clinical trials in 2023 with IPC patients. In total, these five companies represent more than 500 jobs in Marseille. This technology transfer dynamic is at work in the submission, in September 2022, of an application under the Biocluster call for expressions of interest, which is part of the 2030 Strategy (Marseille applied for the production of immunology drugs) and gathers the CRCM, the IPC, the APHM and other research partners.
Ultimately, the CRCM seeks to better understand the complexity of cancerous and immune cells in order to improve diagnosis, prognosis and therapy. It also aims to better anticipate the onset and evolution of cancers in order to avoid unnecessarily burdensome treatments, to limit the side effects for the patient and to reduce the cost of treatments in collaboration with its research and training partners, with the constant support of patients and their associations.
27, boulevard Leï Roure, CS 30059
B-13273 Marseille Cedex 09
Tél. : +33 (0)4 86 97 72 00
E-mail : secretariat.u1068@inserm.fr

https://www.crcm-marseille.fr/ https://www.crcm-marseille.fr/en/




Publireportage 83 April 2023
Centre de Recherche en Cancérologie de Marseille - CRCM
Discovery of novel targets and therapies in paediatric oncology / Découverte de cibles et thérapies innovantes en oncologie pédiatrique
© CRCM © CRCM
Telomeres and chromatin / Télomères et chromatine
CHU de Nîmes
Des plateformes dédiées pour répondre aux besoins des chercheurs et des industriels
Partenaire du Programme d’Excellence I-Site et du Pôle Universitaire d’Innovation portés par l’Université de Montpellier, le CHU de Nîmes propose des prestations de recherche de haut niveau au sein de plateformes consacrées au développement de l’innovation. Visite guidée de quatre d’entre elles.
La PPPOH s’est spécialisée dans les myélofibroses, l’onco-urologie, les cancers du sein et les cancers ORL, de plus en plus traités par immunothérapie ou thérapies ciblées (anticorps, CAR-T cells, injections virales au niveau du lit tumoral, vaccination anticancéreuse ou petites molécules inhibitrices). Son environnement sécurisé et pluridisciplinaire offre un recours à des patients en bon état général, sans comorbidité. « Les premiers essais ont été lancés avec une dizaine de patients atteints d’un cancer ORL ou d’un cancer de la vessie » souligne le Pr Houédé. Elle envisage déjà d’accroître l’offre thérapeutique pour inclure un plus grand nombre de patients et de lancer des essais dans le domaine de l’hémato-oncologie et du cancer de la prostate. Une belle preuve de proactivité.
DFoRM : des médicaments et dispositifs médicaux sur-mesure
Permettre aux cliniciens de disposer de petites quantités de placebos dans le cadre d’essais sur le repositionnement de molécules pour d’autres indications : c’est l’objectif initial de la platerforme DFoRM, lancée en 2020 par le Dr Ian Soulairol, responsable de l’unité Préparation, Contrôle, Essais cliniques de la pharmacie du CHU de Nîmes et chercheur à l’Institut Charles Gerhardt de Montpellier spécialisé dans l’impression 3D de médicaments. En 2022 il est rejoint par le Pr Xavier Garric de l’Institut de Biomolécules
Max Mousseron (IBMM) de l’Université de Montpellier qui s’appuie sur l’impression 3D pour satisfaire les besoins de prototypage de dispositifs médicaux. « Cette plateforme vise à minimiser les problèmes d’approvisionnement en dispositifs médicaux, développer des dispositifs sur-mesure et positionner le CHU de Nîmes comme lieu d’innovation » explique le Pr Garric.
Cinq dossiers ont déjà été déposés pour des médicaments expérimentaux. « Nous travaillons actuellement sur 6 autres projets dont 4 portent sur la fabrication du placebo et du verum » ajoute le Dr Soulairol. Un premier dispositif médical pour la prise en charge des adhérences intra-utérines a été élaboré en collaboration avec le service Gynécologie et a donné naissance à la société Womed sur la
base d’un brevet dont le CHU de Nîmes et l’Université de Montpellier sont co-propriétaires. « Nous dressons actuellement un état des lieux des besoins des différents services hospitaliers afin de mettre en place des programmes de R&D pour le développement de prototypes d’ici 5 à 10 ans » souligne le Pr Garric. La Plateforme DFoRM a doublé sa surface de production en 2022 et s’installera en 2025 dans un bâtiment flambant neuf. « Cela nous permet de maintenir nos savoir-faire et nos équipements pour être plus résilients face aux futures crises sanitaires » conclut le Dr Soulairol.
Des essais de phase précoce en oncologie et hématologie
Agréée en septembre 2022 par l’ARS, la Plateforme de phase précoce en oncologie et hématologie (PPPOH) s’inscrit dans la continuité de l’Institut de cancérologie du Gard (17 000 séances de chimiothérapie en ambulatoire et plus de 6 500 patients pris en charge en 2022 pour des pathologies hématologiques ou certains cancers solides). « L’agrément permet à la PPPOH d’aller plus loin que les essais de phases 2 et 3 avec l’appui du CHU, du Centre de ressources biologiques et de plusieurs unités de recherche dont l’U1194 Inserm - ICM, l’Institut du Cancer de Montpellier dont je fais partie », explique le Pr Nadine Houédé, chef de pôle adjoint du pôle Oncologie du CHU de Nîmes.
Imaging Platform for Innovation
Offrir des prestations de recherche en radiologie et imagerie médicale : c’est l’objectif de l’Imaging Platform for Innovation (IPI) qui s’appuie sur deux bases complémentaires : une équipe de recherche pluridisciplinaire, « Medical Imaging Group (MIG) Nîmes », et une plateforme d’imagerie dotée de machines multiconstructeurs de dernières générations (scanners, IRM, salles de radiologie interventionnelle dont une 4DCT, équipements numériques, fantômes anthropomorphiques) avec des créneaux horaires dédiés. « IPI s’adresse aux industriels du médicament et du dispositif médical, aux industriels de la radiologie et aux cliniciens porteurs de projets thérapeutiques » explique le Pr Julien Frandon, responsable de l’unité Radiologie interventionnelle au sein du pôle Radiologie - Imagerie Médicale et responsable médical d’IPI.
IPI met ses savoir-faire « from code to bedside » au service de 140 études structurées en 3 axes : le numérique et l’IA, les biomarqueurs en imagerie et les thérapies guidées par l’image. IPI a aussi développé deux axes de recherche propre : l’imagerie ultralow dose (ULD) qui propose une nouvelle radiologie 3D très peu exposante aux rayons X (un PHRCi est en cours comparant radiographie et scanner ULD appliqués à la traumatologie) et la thérapie par ischémie contrôlée qui étudie l’embolisation pour

Publireportage 84 Avril 2023
© CHU de Nîmes
L’équipe de l’Imaging Platform for Innovation (IPI) / The Imaging Platform for Innovation (IPI) team
stimuler la néoangiogénèse. « Nous envisageons de passer au scanner photonique pour pousser encore plus loin le développement de ces thématiques émergentes » anticipe le Pr Frandon. Une révolution qui permettrait de développer de nouveaux biomarqueurs et de réduire encore plus les doses de rayonnement.
Micro&Bio : vers de nouvelles solutions thérapeutiques
Hébergée par le Service de Microbiologie et Hygiène hospitalière du CHU Carémeau, la plateforme Micro&Bio est composée de deux plateaux. Le plateau GéMIC évalue l’organisation des microbiotes humains et l’évolution génétique et épidémiologique des génomes microbiens. Il a récemment permis l’analyse du génome d’une nouvelle bactérie (Brucella amazonia sp. nov.) et mis en place un séquenceur de nouvelle génération, de la taille d’un smartphone, identifiant les pathogènes à l’origine d’une méningite, déterminant leur génome (à ADN ou à ARN) pour faire ressortir tel gène de virulence ou de résistance. Pour le Pr Jean-Philippe Lavigne, chef du Service de Microbiologie du CHU de Nîmes, les outils génomiques sont une solution d’avenir pour faciliter et accélérer le diagnostic, orienter au mieux le traitement et
éviter la propagation des bactéries résistantes aux antibiotiques. « Des kits d’analyses des génomes séquencés sont en cours de développement en collaboration avec la société bioMérieux sur la base de logiciels d’interprétation bio-informatique rapide permettant des rendus de résultats dans la journée ».
Pour sa part, le plateau bioMONOPOLY étudie les différentes étapes de la formation et de la régulation des bactéries organisées en biofilm devenant de facto résistantes à tous les antibiotiques. « Nous utilisons une technologie de microfluidique pour mimer l’implantation d’une ou des bactéries sur une plaie et évaluer l’efficacité thérapeutique de nouvelles molécules à potentiel antibiotique ou antibiofilm » précise le Pr Lavigne. Micro&Bio s’est associée avec la société BioFilm Control pour développer également l’antibiofilmogramme qui met en présence une bactérie et un antibiotique et observe si ce dernier induit la formation de biofilm, rendant l’antibiotique inefficace. Des premiers essais cliniques ont permis d’expliquer grâce à cet outil des échecs thérapeutiques lors de traitement antibiotique pourtant efficace sur l’antibiogramme, mieux utiliser les antibiotiques et développer des alternatives. Une association avec la société
Menarini a aussi permis d’évaluer l’activité de nouveaux traitements antibiotiques sur des biofilms mono et polymicrobiens. Autant d’avancées au service d’une médecine de précision.
Nîmes University Hospital
Dedicated platforms to meet the needs of researchers and industry
As a partner in the I-Site Excellence Programme and the University Innovation Pole supported by the University of Montpellier, the Nîmes University Hospital offers high-level research services within platforms dedicated to the development of innovation. Take a guided tour of four of them.
DFoRM: tailor-made medicines and medical devices
Enabling clinicians to have small quantities of placebos available for trials on the repositioning of molecules for other indications: this is the initial objective of the

DFoRM platform, launched in 2020 by Dr Ian Soulairol, head of the Preparation, Control, Clinical Trials unit of the Nîmes University Hospital pharmacy and a researcher at the Charles Gerhardt Institute in Montpellier, which specialises in the 3D printing of drugs. In 2022 he is joined by Prof. Xavier Garric of the Max Mousseron Institute of Biomolecules (IBMM) at the University of Montpellier, which relies on 3D printing to meet the needs of medical device prototyping. «This platform aims to minimise the problems of supplying medical devices, to develop tailor-made devices and to position the Nîmes University Hospital as a place of innovation,» explains Prof. Garric.
Five applications have already been submitted for experimental drugs. «We are currently working on six other projects,
four of which concern the manufacture of placebo and verum,» adds Dr Soulairol. A first medical device for the treatment of intra-uterine adhesions was developed in collaboration with the Gynaecology Department and gave rise to the company Womed on the basis of a patent co-owned by the Nîmes University Hospital and the University of Montpellier. «We are currently drawing up an inventory of the needs of the various hospital departments in order to set up R&D programmes for the development of prototypes within the next 5 to 10 years,» stresses Prof. Garric. The DFoRM Platform doubled its production area in 2022 and will move into a brand new building in 2025. «This will enable us to maintain our know-how and equipment to be more resilient in the face of future health crises,» concludes Dr Soulairol.

Publireportage 85 April 2023
La platerforme DEform / The DEform
© CHU de Nîmes
©
The Early Phase Platform in Oncology and Haematology La Plateforme de phase précoce en oncologie et hématologie (PPPOH)
CHU de Nîmes
Early phase trials in oncology and haematology
Approved in September 2022 by the ARS, the Early Phase Oncology and Haematology Platform (PPPOH) is a continuation of the Gard Cancer Institute (17,000 outpatient chemotherapy sessions and more than 6,500 patients treated in 2022 for haematological diseases or certain solid cancers). «The accreditation allows the PPPOH to go beyond phase 2 and 3 trials with the support of the CHU, the Biological Resource Centre and several research units including the U1194 Inserm - ICM, the Montpellier Cancer Institute, of which I am a member,» explains Prof. Nadine Houédé, deputy head of the Oncology Unit of the Nîmes CHU.
The PPPOH specialises in myelofibrosis, onco-urology, breast cancer and ENT cancers, which are increasingly treated by immunotherapy or targeted therapies (antibodies, CAR-T cells, viral injections into the tumour bed, anti-cancer vaccination or small molecule inhibitors). Its secure and multidisciplinary environment offers recourse to patients in good general condition, without comorbidity. «The first trials have been launched with a dozen patients suffering from ENT cancer or bladder cancer,» stresses Prof. Houédé. She is already planning to increase the therapeutic offer to include a greater number of patients and to launch trials in the field of hemato-oncology and prostate cancer. A fine example of proactivity.
Imaging Platform for Innovation
Offering research services in radiology and medical imaging: this is the objective of the Imaging Platform for Innovation (IPI), which is based on two complementary foundations: a multidisciplinary research team, the «Medical Imaging Group (MIG) Nîmes», and an imaging platform equipped with the latest generation of multi-machine equipment (scanners, MRI, interventional radiology rooms, including a 4DCT, digital equipment, anthropomorphic phantoms) with dedicated time slots. «IPI is aimed at drug and medical device manufacturers, radiology manufacturers and clinicians with therapeu-
tic projects,» explains Prof. Julien Frandon, head of the Interventional Radiology unit within the Radiology - Medical Imaging division and IPI’s medical manager.
IPI puts its know-how «from code to bedside» at the service of 140 studies structured in 3 areas: digital and AI, biomarkers in imaging and image-guided therapies. IPI has also developed two research areas of its own: ultra-low dose (ULD) imaging, which offers a new 3D radiology with very low exposure to X-rays (a PHRCi is underway comparing ULD radiography and scanner applied to traumatology) and controlled ischemia therapy, which studies embolization to stimulate neoangiogenesis. «We plan to move on to photonic scanning to further develop these emerging themes,» says Prof. Frandon. A revolution that would make it possible to develop new biomarkers and reduce radiation doses even further.


Micro&Bio: towards new therapeutic solutions
Hosted by the Microbiology and Hospital Hygiene Department of the Carémeau University Hospital, the Micro&Bio platform is composed of two platforms. The GéMIC platform evaluates the organisation of human microbiota and the genetic and epidemiological evolution of microbial genomes. It recently made it possible to analyse the genome of a new bacterium (Brucella amazonia sp. nov.) and set up a new-generation sequencer, the size of a smartphone, to identify the pathogens that cause meningitis, determining their genome (DNA or RNA) in order to highlight a particular virulence or resistance gene. For Prof. Jean-Philippe Lavigne, head of the Microbiology Department at the Nîmes University Hospital, genomic tools are a solution for the future to facilitate and accelerate diagnosis, better orient treatment and avoid the spread of antibiotic-resistant bacteria. «Sequenced genome analysis kits are currently being developed in collaboration with bioMérieux, based on rapid bioinformatics interpretation software that allows results to be delivered within a day.”
For its part, the bioMONOPOLY platform studies the various stages of formation and regulation of bacteria organised in biofilms that become de facto resistant to all antibiotics. «We use microfluidic technology to mimic the implantation of one or more bacteria on a wound and to evaluate the therapeutic effectiveness of new molecules with antibiotic or antibiofilm potential,» explains Prof. Lavigne. Micro&Bio has joined forces
with the company BioFilm Control to also develop the antibiofilmogram, which brings together a bacterium and an antibiotic and observes whether the latter induces the formation of a biofilm, making the antibiotic ineffective. Initial clinical trials have used this tool to explain therapeutic failures during antibiotic treatment, despite the fact that the antibiogram is effective, to make better use of antibiotics and to develop alternatives. An association with the Menarini company has also made it possible to evaluate the activity of new antibiotic treatments on mono and polymicrobial biofilms. These are all advances in the service of precision medicine.
CHU de Nîmes
Direction de la Recherche, des Partenariats
Hospitalo-Universitaires et Internationaux
Place du Professeur Robert Debré
F-30029 Nîmes Cedex 9
Tél. : +33 (0)4 66 68 30 52
E-mail : alysson.briffa@chu-nimes.fr
https://www.chu-nimes.fr/

Publireportage 86 Avril 2023
The Early Phase Platform in Oncology and Haematology / La Plateforme de phase précoce en oncologie et hématologie (PPPOH)
© CHU de Nîmes
© CHU de
The DFoRM platform / La plateforme DFoRM
Nîmes
Horus Pharma

Innovation et éthique au service de l’ophtalmologie
Créé en 2003 par Martine et Claude Claret, Horus Pharma est un laboratoire indépendant spécialisé en ophtalmologie et dermatologie. Goût de l’innovation, respect de l’environnement et expansion internationale sont ses credo.

Fort de 202 employés répartis entre son siège de SaintLaurent du Var et ses filiales au Benelux, en Espagne, aux PaysBas, en Suisse et récemment, dans les pays nordiques, Horus Pharma affiche un chiffre d’affaires en 2022 de 85,5 M€ et mobilise 20 % de son personnel pour la R&D. Le laboratoire propose aux médecins de ville et aux praticiens hospitaliers une large gamme de solutions innovantes en ophtalmologie et en dermocosmétique - le tout sans conservateurs. Les traitements de la sécheresse oculaire, de certaines affections de la rétine et du glaucome font partie de ses best-sellers.
L’offre de Horus Pharma s’appuie sur 11 brevets couvrant le brevet de fabrication Epifree® Technology, le flacon multidose sans conservateur I Free System®, diverses nanoémulsions, une solution osmolaire pour le traitement de l’œdème de la cornée... Les innovations en 2023 : une gamme complète de produits pour le traitement du glaucome ainsi qu’une nouvelle gamme cosmétique, Clarté Laboratoire, à base d’acide hyaluronique de haute qualité. La marque s’inspire d’Horus Pharma avec des produits sans conservateurs. Sa gamme de produits se veut minimaliste, avec moins de 15 ingrédients, sans silicone, sans parfum, sans alcool et sera commercialisée avec un fort support digital.
De plus, poursuivant sa démarche écoresponsable débutée par des produits sans aucun conservateur, le laboratoire développe le programme Eco’ Ophtalmo. Son objectif : réduire l’empreinte environnementale des produits et procédés en ophtalmologie et sensibiliser les ophtalmologistes sur l’impact des pratiques dans le milieu médical.
En parallèle, Horus Pharma poursuit son expansion à l’international grâce aux autorisations de mise sur le marché européennes obtenues pour l’ensemble de ses gammes. Cette expansion se traduit aussi par la création, en avril, d’une nouvelle filiale dans les pays nordiques et par la poursuite de nombreux partenariats de distribution. Autant de raisons d’ambitionner un doublement du chiffre d’affaires dans les 5 ans. Mais c’est dès avril 2023 que Horus Pharma emménage au sein d’un immeuble flambant neuf de l’Écovallée de Nice : un signe fort de sa volonté de pérenniser son activité dans la région.
Innovation and ethics at the service of ophthalmology
Created in 2003 by Martine and Claude Claret, Horus Pharma is an independent laboratory specialising in ophthalmology and dermatology. A taste for innovation, respect for the environment and international expansion are its credo.
With 202 employees spread between its headquarters in SaintLaurent du Var and its subsidiaries in Benelux, Spain, the Netherlands, Switzerland and the Nordic countries, Horus Pharma has a turnover of €85.5 million in 2022 and mobilises 20% of its staff for R&D. The laboratory offers a wide range of innovative ophthalmology and dermocosmetic solutions to both general practitioners and hospital practitioners - all without preservatives. Its best-sellers include treatments for dry eyes, certain retinal disorders and glaucoma.

Horus Pharma’s offer is based on 11 patents covering the Epifree® Technology manufacturing patent, the preservative-free I Free System® multi-dose bottle, various nanoemulsions, an osmolar solution for the treatment of corneal oedema, etc. Innovations in 2023: a complete range, of products for the treatment of glaucoma as well as a new cosmetic range, named Clarté Laboratoire, based on high-quality hyaluronic acid. The brand is inspired by Horus Pharma preservative-free products. The range of products is minimalist, with less than 15 ingredients, silicone-free, fragrance-free, alcohol-free and will be marketed with strong digital support.
In addition, continuing its eco-responsible approach, which began with preservative-free products, the laboratory is developing the Eco’ Ophtalmo programme. Its objective: to reduce the environmental footprint of ophthalmology products and processes and raise awareness among ophthalmologists about the impact of practices in the medical field.
At the same time, Horus Pharma is continuing its international expansion thanks to the European marketing authorisations obtained for all its ranges. This expansion also resulted, in April, in the creation of a new subsidiary in the Nordic countries and the continuation of numerous distribution partnerships. These are all reasons to aim for a doubling of turnover within 5 years. But it is in April 2023 that Horus Pharma will move into a brand new building in the Nice Ecovallée: a strong sign of its desire to perpetuate its activity in the region.
Publireportage 87 April 2023
Horus Pharma 22, allée Camille MUFFAT - Inedi 5 - F-06200 Nice Tél. : +33(0)4 93 19 54 03 - E-mail : contact@horus-pharma.fr www.horus-pharma.com
© Horus Pharma © Horus Pharma
Martine Claret, co-fondatrice et présidente de Horus Pharma / Martine Claret, co-founder and president of Horus Pharma
Horus Pharma’s new offices in Nice Ecovallée (left building) Les nouveaux bureaux de Horus Pharma à Nice Ecovallée (bâtiment de gauche)
Institute of Research on Cancer and Aging in Nice - IRCAN
La biologie du vieillissement, un enjeu majeur de santé et d’innovation
Créé en 2012 sous la direction du Pr Eric Gilson avec la triple tutelle de l’Inserm, du CNRS et de l’Université Côte d’Azur, l’IRCAN s’appuie sur 220 personnes réparties en 16 équipes de recherche. Avec 726 articles originaux publiés dans des journaux internationaux au cours des cinq dernières années, il peut se prévaloir de 28 brevets et a suscité la création de trois start-ups.
Comprendre les mécanismes biologiques du vieillissement sur les plans fondamental et appliqué : c’est l’ambition première de l’IRCAN, leader français et européen dans cette thématique émergente associée à de nombreuses maladies chroniques et de nombreux cancers. Les travaux de recherche de l’IRCAN sont structurés en cinq pôles principaux : la sénescence cellulaire, l’(épi)génomique, la régénération, le milieu extracellulaire et l’environnement (avec notamment l’étude de l’impact du changement climatique sur le vieillissement).
L’IRCAN est particulièrement actif dans le domaine de la sénescence cellulaire en partant d’une découverte américaine déjà ancienne : l’organisme vieillit d’abord par accumulation de cellules sénescentes suite à divers dommages. Il s’agit donc d’empêcher l’entrée en sénescence des cellules ou de les éliminer de manière préventive ou curative. C’est tout l’enjeu de la sénothérapie. L’équipe du Dr Dmitry Bulavin à l’IRCAN a récemment jeté un pavé dans la mare en publiant en 2020 ses découvertes dans la revue Cell Metabolism : en utilisant un modèle de souris, elle a démontré que les cellules sénescentes tuées ne sont pas remplacées, formant ainsi des trous dans les organes concernés. La sénothérapie doit donc être repensée pour neutraliser les cellules sénescentes au moyen de drogues sénomorphiques ou les tuer en les remplaçant en même temps par la mobilisation de cellules souches.



D’autres découvertes sur la cellule sénescente sont à mettre à l’actif de l’équipe du Dr Julien Cherfils-Vicini : l’étude des propriétés immunosuppressives de la cellule sénescente a permis d’identifier une cible (brevetée depuis) avec production d’anticorps en vue de bloquer ce mécanisme. Cette approche d’immunothérapie est au stade du modèle préclinique où son efficacité est testée sur la fibrose du poumon par exemple.
La recherche sur les télomères est aussi très présente à l’IRCAN puisqu’elle mobi-
lise quatre de ses équipes. Il est vital de mieux comprendre le fonctionnement de cette horloge du vieillissement programmée au cours du développement - une horloge qui peut s’emballer en cas de stress. Or le défi est de taille : découvrir les facteurs télomériques contribuant au vieillissement mais pas au cancer ! Pour ce faire, les chercheurs de l’IRCAN développent des organismes dotés de caractéristiques de longévité et de régénération extrêmes tels que des invertébrés marins considérés comme « quasi immortels » comme les coraux et autres anémones de mer : des pistes prometteuses étudiées par les équipes du Dr Éric Röttinger et du Pr Éric Gilson, qui essayent notamment de comprendre comment les télomères de ces organismes réagissent à des environnements contrastés et quels sont les mécanismes moléculaires impliqués.
Soucieux d’agir au niveau de la prévention comme de la guérison, le Pr Éric Gilson a assuré la coordination scientifique du grand programme transversal de l’Inserm « AgeMed » (2017-2023). La participation d’une vingtaine d’équipes françaises a permis de consolider une communauté de recherche interdisciplinaire au niveau national. Successeur de « AgeMed », le programme de Coopération Thématique « InterAging » s’étend sur 2021-2025 et vise à élargir le périmètre des collaborations sous la houlette de l’Inserm, toujours coordonné par le Pr Éric Gilson, avec des équipes d’Allemagne (Cologne), de Singapour, du Royaume-Uni (Londres) et de Chine (Shanghai).
L’IRCAN est donc idéalement placé pour fournir aux cliniciens des marqueurs utiles pour évaluer l’état de fragilité d’une personne ou anticiper la réponse à un traitement d’immunothérapie. C’est par exemple le cas d’un ambitieux programme de la Fondation ARC sur « Cancer et vieillissement » dont l’IRCAN est partenaire : l’étude de cohortes de patients atteints d’un cancer lié à l’âge permettra d’agréger ces différents paramètres. Avec un objectif ultime : améliorer la prise en charge du patient.
Publireportage 88 Avril 2023
© IRCAN © IRCAN © IRCAN
Institute of Research on Cancer and Aging in Nice - IRCAN
The biology of ageing, a major challenge for health and innovation
Created in 2012 under the direction of Prof. Eric Gilson with three supervising bodies: Inserm, CNRS and the Université Côte d’Azur, the IRCAN has a staff of 220 people divided into 16 research teams. With 726 original articles published in international journals over the last five years, it can boast 28 patents and has led to the creation of three start-ups.
Understanding the biological mechanisms of ageing at the fundamental and applied levels: this is the primary ambition of IRCAN, the French and European leader in this emerging field associated with many chronic diseases and cancers. IRCAN’s research work is structured into five main areas: cellular senescence, (epi)genomics, regeneration, the extracellular environment and the environment (including the study of the impact of climate change on ageing).

IRCAN is particularly active in the field of cellular senescence, based on a long-standing American discovery: the organism first ages by accumulating senescent cells following various forms of damage. It is therefore a question of preventing cells from going into senescence or eliminating them in a preventive or curative manner. This is what senotherapy is all about.
Dr Dmitry Bulavin’s team at the IRCAN recently threw a spanner in the works by publishing their findings in the journal Cell Metabolism in 2020: using a mouse model, they demonstrated that senescent cells that are killed are not replaced, thus forming holes in the organs concerned. Senotherapy must therefore be rethought to neutralise senescent cells by means of senomorphic drugs or to kill them by replacing them at the same time by mobilising stem cells.
Other discoveries on the senescent cell can be attributed to Dr Julien Cherfils-Vicini’s team: the study of the immunosuppressive properties of the senescent cell has made it possible to identify a target (since patented) with production of antibodies to block this mechanism. This immunotherapy approach is at the preclinical model stage where its effectiveness is being tested on lung fibrosis for example.
Telomere research is also very present at IRCAN, involving four of its teams. It is vital to better understand the functioning of this ageing clock programmed during development - a clock that can run out of control in the event of stress. The
challenge is a major one: to discover the telomeric factors that contribute to ageing but not to cancer! To do this, IRCAN researchers are developing organisms with extreme longevity and regeneration characteristics, such as marine invertebrates considered to be ‘quasi-immortal’, such as corals and other sea anemones: promising avenues studied by the teams of Dr Eric Röttinger and Prof. Eric Gilson, who are trying to understand how the telomeres of these organisms react to contrasting environments.
With a view to taking action on both prevention and cure, Prof. Éric Gilson has been responsible for the scientific coordination of Inserm’s major transverse programme «AgeMed» (2017-2023). The participation of some twenty French teams has enabled the consolidation of an interdisciplinary research community at national level. The successor to «AgeMed», the Thematic Cooperation Programme «InterAging» runs from 2021-2025 and aims to broaden the scope of collaborations under the leadership of Inserm, still coordinated by Prof. Éric Gilson, with teams from Germany (Cologne), Singapore, the UK (London) and China (Shanghai).
The IRCAN is therefore ideally placed to provide clinicians with useful markers for assessing a person’s state of frailty or anticipating the response to an immunotherapy treatment. This is the case, for example, of an ambitious programme of the ARC Foundation on «Cancer and Ageing» in which the IRCAN is a partner: the study of cohorts of patients suffering from age-related cancer will make it possible to aggregate these different parameters. The ultimate goal is to improve patient care.

Publireportage 89 April 2023
Institute for Research on Cancer and Aging, Nice School of Medicine 28, avenue Valombrose F-06107 Nice Cedex 02
: +33 (0)4 89 15 36 03
: ircan-communication@unice.fr https://ircan.org/ © IRCAN
Tél.
E-mail
Labex SIGNALIFE
L’excellence niçoise au service de la signalisation cellulaire en sciences du vivant
Créé en 2012 dans le cadre du Programme d’Investissements d’Avenir, le Laboratoire d’Excellence « Labex SIGNALIFE » est spécialisé dans la signalisation cellulaire en sciences de la vie. Grâce à leur haut niveau d’excellence, ses équipes de recherche contribuent à améliorer notre compréhension de la communication cellulaire en santé humaine et dans les mécanismes biologiques fondamentaux.
Le Labex s’appuie sur 6 structures de recherche de Nice - Sophia Antipolis : 5 grands instituts de Biologie (iBV1,IPMC2, C3M3, IRCAN4, ISA5) ainsi que l’Inria6 Ses 56 équipes rassemblent 600 personnes dont 250 chercheurs, soit 40 % de la biologie niçoise. Elles travaillent en partenariat avec l’Université Côte d’Azur (UCA), le CNRS, l’Inserm, l’INRAE, l’Inria, le CHU ainsi que le Centre de lutte contre le cancer de Nice.
SIGNALIFE est structuré en 5 axes scientifiques : l’architecture cellulaire, la plasticité cellulaire, la réponse cellulaire aux stress environnementaux, les pathologies humaines et le vieillissement ainsi qu’un axe transversal sur la modélisation et les approches translationnelles.


L’histoire de SIGNALIFE se découpe en deux périodes. La première période (2012-2019) dirigée par S. Noselli, dotée de 11 M€ a consisté à développer un « International PhD Program » très sélectif (4 % de reçus). Au total, 36 nationalités différentes et 84 % d’étrangers, avec près de 80 doctorants et 10 post-doctorants ont été financés. 20 % d’entre eux ont intégré la recherche publique ou privée, la moitié est actuellement en post-doctorat
tandis que 20 à 30 % ont trouvé des débouchés en relation indirecte avec la recherche. In fine, ce programme a permis de structurer la recherche niçoise en biologie.
La seconde période (2020-2024) dirigée par P. Abad, dotée de 4,3 M€ conjugue deux actions, en faveur de l’attractivité du hub niçois et de l’innovation. L’attractivité a été stimulée par la création de 5 chaires d’excellence en partenariat avec UCA. À ce jour, l’International Scientific Advisory Board du Labex a sélectionné 5 scientifiques d’envergure internationale. Deux d’entre eux ont déjà été recrutés comme directeurs de recherche à l’Inserm et au CNRS.
Pour sa part, l’innovation a été soutenue par le programme Jeune Entrepreneur. L’objectif : créer des start-ups issues de la communauté scientifique SIGNALIFE en accompagnant les porteurs de projets affichant un haut potentiel (niveau de maturité technologique TRL de 2 à 4). Les commissions d’innovation de SIGNALIFE et d’UCA ont évalué la faisabilité des projets et retenu pour financement 5 programmes sur l’oncologie (2), l’obésité, l’antibiorésistance mais également l’amélioration génétique et génomique des levures.
Tout au long de cette décennie, l’organisation de workshops internationaux sur des « fronts de science », notamment sur la lipidomique, les aspects fonctionnels des ARN ou encore l’immunité comparée entre animaux et plantes, a permis des avancées conceptuelles significatives en biologie.
Aujourd’hui, SIGNALIFE se positionne comme un creuset pour les biologistes azuréens où la démarche prospective initiée à l’interface avec la chimie, la physique et les sciences du numérique a constitué un élément fondateur pour la création de l’académie d’excellence de Biologie de l’IDEX 7 d’UCA, valorisant ainsi au mieux nos connaissances en signalisation cellulaire au service de la santé humaine et des biotechnologies.
1 iBV : Institut de Biologie Valrose
2 IPMC : Institut de Pharmacologie Moléculaire et Cellulaire
3 C3M : Centre Méditerranéen de Médecine Moléculaire
4 IRCAN : Institut de Recherche sur le Cancer et le Vieillissement, Nice
5 ISA : Institut Sophia Agrobiotech
6 Inria : Institut national de recherche en sciences et technologies du numérique
7 IDEX : Initiative d’Excellence
Publireportage 90 Avril 2023
© Pegard ISA © Estrach IRCAN
Labex SIGNALIFE
Excellence in Nice at the service of cell signalling in life sciences
Created in 2012 as part of the «Investissements d’Avenir» programme, the «Labex SIGNALIFE» Laboratory of Excellence is specialised in cell signalling in the life sciences. Thanks to their high level of excellence, its research teams contribute to improving our understanding of cellular communication in human health and in fundamental biological mechanisms.

The Labex is supported by 6 research structures in Nice - Sophia Antipolis: 5 major Biology institutes (iBV1, IPMC2, C3M3, IRCAN4, ISA5) as well as Inria6. Its 56 teams bring together 600 people including 250 researchers, i.e., 40% of the research forces in Nice. They work in partnership with the Université Côte d’Azur (UCA), the CNRS, Inserm, INRAE, Inria, the CHU and the Nice Cancer Centre.
SIGNALIFE is structured in 5 scientific axes: cell architecture, cell plasticity, cell response to environmental stress, human pathologies and ageing, as well as a transversal axis on modelling and translational approaches.
The history of SIGNALIFE is divided into two periods. The first period (20122019) headed by S. Noselli, with a budget of €11M, consisted of developing a highly selective «International PhD Program» (4% of successful applicants). In total, 36 different nationalities and 84% foreigners, with nearly 80 PhD students and 10 post-docs were funded. Twenty percent of them have entered public or private research, half of them are currently in post-doctoral studies, while 20 to 30% have found job opportunities indirectly related to research. Ultimately, this programme has made it possible to structure Nice’s research in biology.
The second period (2020-2024) headed by P. Abad, with a budget of €4.3M, combines two actions, one to promote the attractiveness of the Nice hub and the other to promote innovation. Attractiveness has been stimulated by the creation of 5 chairs of excellence in partnership with UCA. To date, the Labex International Scientific Advisory Board has selected 5 scientists of international stature. Two of them have already been recruited as research directors at Inserm and CNRS.
For its part, innovation has been supported by the Young Entrepreneur programme. The objective is to create start-ups from the SIGNALIFE scientific community
by supporting projects with a high potential (TRL - technology readiness levels of 2 to 4). The SIGNALIFE and UCA innovation commissions evaluated the feasibility of the projects and selected 5 programmes for funding in the fields of oncology (2), obesity, antibiotic resistance and genetic and genomic improvement of yeast.
Throughout this decade, the organisation of international workshops on «science fronts», notably on lipidomics, the functional aspects of RNA and comparative immunity between animals and plants, has led to significant conceptual advances in biology.
Today, SIGNALIFE is positioned as a melting pot for biologists on the Côte d’Azur where the prospective approach initiated at the interface with chemistry, physics and digital sciences has been a founding element for the creation of the Academy of Excellence in Biology of the UCA IDEX, thus enhancing our
knowledge in cell signalling for human health and biotechnologies.
Pierre Abad and Martine Avella
1 iBV : Institut de Biologie Valrose
2 IPMC : Institut de Pharmacologie Moléculaire et Cellulaire
3 C3M : Centre Méditerranéen de Médecine Moléculaire
4 IRCAN : Institut de Recherche sur le Cancer et le Vieillissement, Nice
5 ISA : Institut Sophia Agrobiotech
6 Inria : Institut national de recherche en sciences et technologies du numérique
7 IDEX : Initiative d’Excellence
Labex SIGNALIFE
Université Côte d’Azur Grand Château
28, avenue de Valrose - F-06103 Nice Cedex 2
Tél. : +33 (0)4 92 38 66 02
E-mail : pierre.abad@inrae.fr
https://signalife.univ-cotedazur.fr/

Publireportage 91 April 2023
© Rauzi iBV
Therapixel
Créée en juin 2013 à partir de l’expertise en imagerie médicale de ses deux fondateurs, ingénieurs à Inria, Therapixel a réorienté son activité en 2017 en direction du cancer du sein. Une stratégie judicieuse, portée par une quarantaine de collaborateurs répartis entre Paris, Nice et Chicago.
Created in June 2013 from the medical imaging expertise of its two founders, engineers at Inria, Therapixel reoriented its activity in 2017 towards breast cancer. A judicious strategy, supported by some forty employees spread between Paris, Nice and Chicago.
It was an international competition organised by IBM in 2017 that sealed Therapixel’s fate. After coming first in the detection of breast cancer based on mammograms, the team decided to transform the trial. The €1 million won thanks to the competition was followed by two rounds of financing: €5 million in 2018 to develop the MammoScreen™ software and €15 million in April 2022 to accelerate its commercialisation and develop the next generation.
The first version of MammoScreen™ already offers radiologists a decision-making tool in two ways: it helps them to locate anomalies and to assess the probability that they are cancerous. A partially autonomous reading of the images, synonymous with efficiency, speed and therefore time saving at a time of hyperinflation of the images to be treated.

C’est un concours international organisé par IBM en 2017 qui a scellé le destin de Therapixel. En arrivant première dans la détection de cancers du sein sur la base de mammographies, l’équipe a décidé de transformer l’essai. Au 1 M€ du concours ont succédé deux levées de fonds : 5 M€ en 2018 pour développer le logiciel MammoScreen™ et 15 M€ en avril 2022 pour accélérer sa commercialisation et développer la génération suivante.

La première version de MammoScreen™ offre déjà au radiologue un outil d’aide à la décision à double titre : il l’aide à localiser les anomalies et à évaluer la probabilité qu’elles soient cancéreuses. Une lecture partiellement autonome des clichés, synonyme d’efficience, de rapidité et donc de gain de temps à l’heure de l’hyperinflation des images à traiter.
Deux études cliniques (l’une lancée en octobre 2022 dans la région Sud, l’autre prévue à l’été 2023 dans plusieurs régions) vont évaluer l’impact de l’IA dans un programme de dépistage du cancer du sein comme aide à la décision, alternative à la deuxième lecture d’une même mammographie et première sélection des clichés requérant l’attention d’un radiologue. Un score de 1 à 10 a été établi : entre 1 et 2, l’absence d’anomalie cancéreuse est quasi certaine ; entre 9 et 10, sa présence l’est tout autant. L’objectif : atteindre un très haut degré de certitude dans un quart à 30 % des cas. Les premiers résultats sont respectivement attendus pour fin 2023 et fin 2024.
Aujourd’hui Therapixel poursuit son développement aux États-Unis grâce à sa proposition de valeur garantissant des coûts plus faibles et des gains d’efficacité. Autre perspective d’avenir, la commercialisation en France et la poursuite du développement d’un logiciel partiellement autonome pour les cas bénins.
Two clinical studies (one launched in October 2022 in the South region, the other planned for the summer of 2023 in several regions) will evaluate the impact of AI in a breast cancer screening programme as a decision aid, an alternative to a second reading of the same mammogram and a first selection of images requiring the attention of a radiologist. A score from 1 to 10 has been established: between 1 and 2, the absence of a cancerous anomaly is almost certain; between 9 and 10, its presence is equally certain. The aim is to achieve a very high degree of certainty in a quarter to 30% of cases. The first results are expected at the end of 2023 and 2024 respectively.
Today, Therapixel is pursuing its development in the United States thanks to its value proposition that guarantees lower costs and efficiency gains. Another future prospect is the marketing in France and further development of partially autonomous software for mild cases.

Publireportage 92 Avril 2023
Therapixel 455, promenade des Anglais - F-06200 Nice Tél. : +33 (0)9 72 55 20 39 E-mail : contact@therapixel.com https://www.therapixel.com/ © Therapixel ©
Therapixel
NOS DOMAINES DE COMPÉTENCES

Mécanique
Matériaux
Procédés
Robotique
Mécatronique de puissance
Numérique
Réalité virtuelle
Intelligence arti cielle
Systèmes intelligents
UNE ÉCOLE INNOVANTE OUVERTE SUR LE MONDE EN PHASE AVEC LE MILIEU INDUSTRIEL
Depuis 60 ans, l’École Nationale d’Ingénieurs de Tarbes s’investit pour développer des actions de progrès et accompagner les entreprises à relever leurs nombreux dé s.




FORMATION
Formation tout au long de la vie VAE
Formation des ingénieurs de demain


INNOVATION
Contrats de Recherche
Expertises
Plateformes technologiques
RECRUTEMENT
Stages
Alternance
Job dating
Conférences Industrielles

93 April 2023
École Nationale d’Ingénieurs de Tarbes 47, avenue d’Azereix BP 1629 65016 Tarbes Cedex 05 62 44 27 00
Industrie du futur, villes et mobilités durables : un enjeu de décarbonation
et de mutation des usages
Qu’il s’agisse de produire, d’habiter ou de se déplacer, le modus vivendi est en pleine métamorphose. Souveraineté et relocalisation industrielles, résilience, transition environnementale et transition numérique, smart grids, transports plus verts : autant de leviers pour commencer à vivre autrement.
Région Sud : une stratégie axée sur l’industrie 4.0
L’industrie en région Sud représentait en 2021 17 Mds€ de PIB (soit 12 % du PIB industriel national et 11 % du PIB régional total), près d’un tiers des emplois avec 426 000 emplois, dont 174 000 emplois directs et plus de 50 % du chiffre d’affaires export de la région, soit 13,8 Mds€. Riche d’un tissu dense de TPE et PME (21 000 entreprises), elle totalise 2 350 créations d’entreprises par an (4,5 % du total régional) et représente une force en matière de R&D : les entreprises industrielles de la région ont déposé ou co-déposé 2 818 brevets, soit 63 % du total régional entre janvier 2010 et décembre 2020 (hors brevets universitaires). Par ailleurs, 19 % des salariés de l’industrie travaillent dans des entreprises de haute technologie ou de R&D à caractère préindustriel (contre 14 % au niveau national). Très diversifiée, multi-filières et résiliente, elle peut compter sur la présence de grands groupes : TotalEnergies, LyondellBasell, Arkema, STMicroelectronics, ArcelorMittal, Airbus Helicopters, Thales…
La stratégie régionale pour l’industrie s’incarne dans la feuille de route de l’opération d’intérêt régional (OIR) Industries du Futur qui cible plus spécifiquement les filières aéronautique-spatial, sécurité-défense, chimie-matériaux, sidérurgie, optique-photonique. De plus, elle traite de façon transversale la transformation vers l’industrie 4.0, la décarbonation de l’industrie et les enjeux de souveraineté et de relocalisation industrielles, en adéquation avec France 2030, notamment au travers des stratégies d’accélération de la décarbonation de l’industrie ou du recyclage et de la réincorporation de matériaux recyclés.
Forte des acquis de l’OIR 2016-2021 (Parcours Sud Industrie 4.0 avec, à la mi-mai 2022, 420 entreprises inscrites et 90 demandes de subventions octroyées pour 10 M €, Fonds d’Investissement pour les Entreprises Régionales (FIER) et « Pack Sud relocalisation », Campus des Métiers et des Qualifications Industrie du Futur, labellisé campus d’excellence et lauréat du 2ème puis du 3ème
Programme d’Investissements d’avenir (PIA), démarche Territoires d’industrie et démarche sur le foncier économique stratégique, TEAM Henri-Fabre, Centre régional de ressources drones (C2RD), projet Stratobus, 14 projets présentés au Comité d’ingénierie financière du plateau OIR pour un montant de 107,2 M€ de perspectives d’investissements privés et publics dont 65,3 M€ sécurisés, définition de 8 territoires d’industrie comme territoires d’ancrage privilégiés pour le développement des projets : Aix – Rousset - Gardanne ; Istres - Fos - MarignaneÉtang de Berre / Métropole Aix-Marseille
Provence ; Avignon - Sorgues - Cavaillon - Ventoux ; Carros ; Gap - Tallard - Buëch ; Pays de Grasse - Sophia Antipolis - Cannes ; Toulon - Ollioules - La Seyne-sur-Mer - Saint-Mandrier - SixFours-les-Plages ; Vallée de la Durance ; Haute Vallée de la Durance), la Région Sud ambitionne d’ici 2028 de renforcer l’écosystème industriel régional par l’accélération de sa performance opérationnelle (innovation, 4.0), de sa performance économique (compétitivité des entreprises, compétences, attractivité des métiers) et de sa performance environnementale (transition écologique, énergétique, décarbonation et déploiement de nouvelles filières).
L’OIR Industries du futur a défini trois axes prioritaires d’action et d’investissement : accélérer la transformation vers l’industrie du futur et accompagner l’innovation et la croissance des entreprises industrielles, déployer une « Cop d’avance » dans l’industrie (en accompagnant notamment les efforts d’innovation sur l’hydrogène, les mutations des filières industrielles de l’OIR et la structuration de nouvelles filières vertes en lien avec le recyclage et l’économie circulaire, en massifiant la stratégie de décarbonation avec un mix de financements publics-privés), faire rayonner la région Sud comme Territoire d’industrie et renforcer son attractivité au service de la reconquête d’une souveraineté industrielle (foncier économique stratégique, « Parcours premium » pour l’implantation des projets industriels les plus stratégiques, actions de prospection ciblée sur les segments stratégiques de l’OIR et les chaînons manquants des chaînes de valeur régionales, mise en réseaux des acteurs et des écosystèmes territoriaux au travers des Territoires d’industrie)1
Un accompagnement multi-filières
La stratégie régionale est soutenue par de nombreux acteurs dynamiques à l’instar de l’association TEAM Henri-Fabre : héritière du projet Henri-Fabre qui a vu

94 Avril 2023
Microsystème électromécanique MPU-6050, puce servant de gyroscope et d’accéléromètre pour drone / MPU-6050 Micro-Electro-Mechanical System, gyroscope and accelerometer chip for UAV
© Andres Rueda
le jour en 2012 en vue de construire un nouveau modèle de développement industriel plus collectif, plus collaboratif, tiré par l’innovation et les opportunités technologiques issues du numérique, cette initiative public-privé met en synergie l’expertise de ses partenaires autour de l’aéronautique, l’énergie, la photonique, du naval, du biomédical, etc. La TEAM Henri-Fabre compte parmi ses partenaires INOVSYS, une société technologique spécialisée dans la détection, la validation et le transfert de technologies, méthodes et solutions industrielles. Elle a de belles réalisations à son actif : contrôle robotisé de défauts de surface, méthode de protection de pièces critiques, nettoyage d’ensembles mécaniques, technologies de décapage… Par ailleurs, INOVSYS a développé deux expertises technologiques en fabrication additive d’une part, réindustrialisation et refabrication d’autre part. Sa capacité à détecter, valider et transférer des technologies a été reconnue au travers de deux labels : « Plateforme Mutualisée d’Innovation » dans le cadre du PIA et « Offreur de solutions » dans le cadre du Programme Industrie du Futur.
En 2022, TEAM Henri-Fabre a présenté un excellent bilan, avec de nouveaux projets structurants pour le territoire autour de 4 thèmes : attractivité et compétences, évolution des PME industrielles, accompagnement des grands donneurs d’ordres et visibilité de l’industrie. Malgré une conjoncture difficile, elle considère l’année 2023 comme une belle source d’opportunités pour trois raisons : l’attractivité de l’industrie et le développement des compétences s’améliorent, l’évolution de 300 TPE-PME vers l’Industrie du Futur est en bonne voie (grâce à l’accélérateur vers l’Industrie du Futur PRACCIIS qui poursuit l’amorçage opéré par PSI 4.0) et des projets innovants sont menés par de grands donneurs d’ordres à l’image d’Arqane (Actions de Réalisation et Qualification en Additif pour le Nucléaire) : lancé en 2022, ce projet permet d’accélérer l’intégration des méthodes et pratiques de fabrication additive dans ce secteur, en réalisant des pièces pré-qualifiées de qualité nucléaire2
Autre acteur de poids : le Centre Régional de Ressource Drone (C2RD, ex CEEMA). Référence internationale et partenaire de la filière Drone depuis 2008, le C2RD est un guichet unique multi-services dédié aux acteurs de la filière Drone Air-Terre-Mer, civile et militaire. Il s’est spécialisé dans la conduite d’essais en vol avec l’émergence dès 2008 d’une plateforme aéronautique unique au monde. Son expertise et les moyens développés au fil des ans en font aujourd’hui un acteur reconnu par les autorités de réglementation et les acteurs
industriels de la filière Drone. Devenu en 2020 le Centre Régional de Ressource Drone, le C2RD propose aux acteurs de la filière un cadre complet d’essais multi-milieux, instrumenté et sécurisé, qui concentre tous les moyens et services attendus : tests et essais en vol, expertise et AMOA, campus, événementiel, pépinière d’entreprises… Son site pilote implanté à Pourrières sur près de 85 ha bénéficie d’infrastructures uniques pour réussir toutes les campagnes d’essais : piste de 300 m en enrobé, zone ségréguée réglementée… Les services du C2RD sont particulièrement appréciés de ses nombreux partenaires, à l’instar d’Airbus Group, la Direction de la Coopération Internationale de Sécurité (DCIS), Sud Drone, Flying Whales, la Région Sud, Techsys (créateur de solutions drones), l’A-NSE (Aero-Nautic Services & Engineering), DPDgroup (livreur de colis par drone)…3
Vers des territoires « intelligents » Co-conçu par la Métropole Nice-Côte d’Azur (NCA) et l’Université Côte d’Azur et opérationnel entre 2018 et 2020, le Smart City Innovation Center (SCIC) a fait figure de pionnier en tant que plateforme technologique collaborative unique en France, dédiée à l’innovation et au développement économique autour de la Smart City, ville durable et connectée. Installé à l’Institut Méditerranéen du Risque, de l’Environnement et du Développement Durable (IMREDD) au cœur de l’Eco-vallée, ce showroom de 300 m² a réuni l’université et des industriels leaders en matière d’innovation et de ville « intelligente » (Veolia, IBM, m2ocity, Orange, ERDF, EDF). L’objectif était de favoriser les synergies autour de projets traitant de 4 problématiques majeures pour la Smart City : l’énergie,

l’environnement, les risques et la mobilité. Grâce au SCIC, les parties prenantes ont pu expérimenté de nouveaux usages et de nouveaux services. Des capteurs répartis sur l’ensemble du territoire métropolitain ont alimenté la plateforme par la mesure de divers paramètres (qualité de l’air, volumes des pluies, fluidité du trafic routier, nuisances sonores, consommation énergétique de particuliers ou d’entreprises volontaires) et le SCIC a permis de matérialiser et visualiser en temps réel l’ensemble de ces données collectées, avec le pilotage global de la ville qui peut en découler. Ouvert à tous, le SCIC a également servi de lieu de sensibilisation et de formation pour construire la ville « intelligente » de demain.
Partenaire de l’IMREDD, le pôle de compétitivité Capenergies s’est notamment impliqué dans le Smart Campus Nice Sophia Antipolis (2017-2022), un réseau électrique intelligent expérimental qui avait 3 objectifs : servir de support aux formations existantes et aux nouvelles formations, accélérer le transfert industriel issu des projets collaboratifs par une exploitation directe par un partenaire industriel ou la création de jeunes pousses et développer des projets collaboratifs de recherche entre partenaires académiques, de recherche et entreprises en vue de développer une plateforme unifiée de conception, planification, gestion, simulation et analyse de solutions « smart grids »4
Occitanie : deux « plateformes d’accélération vers l’industrie du futur » Le 21 novembre 2021 ont été annoncés les lauréats de l’appel à projet national « Plateformes d’accélération vers l’industrie du futur ». Deux projets occitans
95 April 2023
Centre spatial de Cannes - Mandelieu, siège de Thales Alenia Space / Cannes - Mandelieu Space Centre, headquarters of Thales Alenia Space
1 Source : Région Sud PACA. / 2 Source : TEAM Henri-Fabre. / 3 Source : C2RD. / 4 Source : Capenergies.
© Guy Lebègue
ont été retenus dans ce cadre. Log’In est une plateforme d’open innovation portée par le groupe Daher, leader français de la logistique industrielle, avec le soutien de la Région Occitanie et de l’État. Son but : accompagner la transformation des métiers de la logistique en s’appuyant sur un espace de 600 m² dédié à la collaboration. Un espace mais aussi des moyens, des formations, un réseau, un programme d’animation… Bref, toute une expertise logistique mise à disposition des projets et des équipes des start-up, PME et ETI du secteur. Premier client de Log’In, EasyMile est un fournisseur mondial de logiciels et de solutions complètes pour la mobilité urbaine autonome et le transport de marchandises dans un environnement contrôlé. L’entreprises vise aussi à développer des véhicules pour les environnements industriels. C’est dans cette perspective que la collaboration avec Log’In s’est enclenchée. Le périmètre d’étude concerne un véhicule destiné aux flux intralogistiques dans certaines usines et aux flux en zone portuaire. Grâce à l’infrastructure expérimentale de Log’In, EasyMile peut reproduire à l’identique les situations opérationnelles qu’elle sera amenée à rencontrer chez ses clients. Une capacité d’anticipation bienvenue pour gagner en vitesse d’exécution et en efficacité lors des déploiements à venir5.

Autre projet lauréat : Pad’Occ. Porté par l’Université de Toulouse, ce projet collaboratif regroupe Aerospace Valley, le CEA, le Pôle OPTITEC, l’IRT Saint-Exupéry, Mechachrome, le Campus des Métiers et des Qualifications d’Excellence « Aéronautique et spatial Occitanie », INSA, ISAE Supaero et l’Université Toulouse III Paul




Sabatier. La plateforme Pad’Occ s’appuie sur son Usine-École 4.0 ainsi que des outils et équipements de dernière génération pour répondre aux besoins des entreprises. Elle les accompagne dans leur transformation industrielle, technologique et humaine à travers des parcours personnalisés. Pour ce faire, elle réalise diverses prestations allant de la PoC (Proof of Concept) à la mise en place de processus « end to end ». Elle offre aussi aux entreprises un ensemble de services destinés à favoriser leur transformation vers l’excellence industrielle et environnementale. Ces services sont structurés en 4 axes : découvrir et s’approprier les apports de l’industrie du futur, réussir son projet de transformation industrielle et environnementale, réussir son projet de transformation humaine et sociétale, accéder aux dispositifs institutionnels et de financement. Un parcours cousu-main pour des résultats optimaux6

Des transports plus nombreux et plus verts L’industrie n’est pas la seule à être revue de fond en comble. Le secteur des transports l’est aussi. La Région Occitanie crée les conditions d’un fret ferroviaire décarboné. Cela se traduit notamment par le développement de nouvelles plateformes de transfert rail-route, l’aménagement d’une plateforme intermodale rail-route au port de Sète-Frontignan, la réouverture de lignes de fret et bien sûr la promotion de la mobilité lourde zéro émission avec le projet « Corridor H2 Occitanie » : soutenu par l’Union européenne, il vise à remplacer l’usage de carburants fossiles par l’hydrogène vert pour les camions, groupes frigorifiques et autocars7. Une première nationale qui devrait faire des émules.

StratobusTM : une rupture technologique pour un dirigeable stratosphérique

Thales Alenia Space, société conjointe entre Thales (67 %) et Leonardo (33 %), a sélectionné en juin 2021 la commune d’Istres (Bouches du Rhône) pour l’implantation de sa ligne de produit StratobusTM, un dirigeable stratosphérique autonome multi-missions couvrant les domaines de l’observation, de l’environnement et des télécommunications. Une véritable rupture technologique pour cet engin doté de moyens de propulsion électrique, économe en énergie. Thales Alenia Space et ses partenaires ont réussi dans une première étape à en démontrer la faisabilité technique par le biais d’un très grand nombre de démonstrations et de modélisations système complexes.
Fortement soutenu par l’État, la Région et la Métropole d’Aix-Marseille-Provence, le projet StratobusTM associe l’ensemble du tissu économique régional et doit permettre la création de 200 emplois directs dès le début du projet, 300 à terme dont 60 % d’ingénieurs dans le secteur du pôle aéronautique d’Istres, et plus de 600 emplois indirects. Ce satellite sans lanceur, entièrement alimenté à l’énergie solaire, représente une réelle avancée en matière de télécommunication et de transition énergétique pour toute la région. Il aura besoin de la coopération européenne pour compléter l’accompagnement régional et national et finaliser son développement, sa certification et son industrialisation.
96 Avril 2023
La ligne 1 du tramway de Montpellier / Line 1 of the Montpellier tramway
Vue d’artiste du Stratobus / Artist’s view of the Stratobus
©
–CC0 –Wikimedia
5 Source : Log’In. / 6 Source : Pad’Occ. / 7 Source : Région Occitanie.
Willem_90
CC
4.0 –
© Master Image Programmes
BY-SA
Wikimedia
Industry of the future, sustainable cities and mobility: a challenge of decarbonization and change of use
Whether it is a question of producing, living or travelling, the modus vivendi is undergoing a complete metamorphosis. Industrial sovereignty and relocation, resilience, environmental transition and digital transition, smart grids, greener transport: these are all levers to start living differently.
Southern Region: a strategy focused on Industry 4.0
In 2021, industry in the Southern Region represented €17 billion in GDP (i.e. 12% of national industrial GDP and 11% of total regional GDP), almost a third of jobs with 426,000 jobs, including 174,000 direct jobs and more than 50% of the region’s export turnover, i.e. €13.8 billion. With a dense fabric of VSEs and SMEs (21,000 companies), the region has 2,350 new companies per year (4.5% of the regional total) and is a force in R&D: the region’s industrial companies filed or co-filed 2,818 patents, i.e. 63% of the regional total between January 2010 and December 2020 (excluding university patents). Furthermore, 19% of industrial employees work in high-tech or pre-industrial R&D companies (compared to 14% at national level). Highly diversified, multi-sector and resilient, it can count on the presence of major groups: TotalEnergies, LyondellBasell, Arkema, STMicroelectronics, ArcelorMittal, Airbus Helicopters, Thales...
The regional strategy for industry is embodied in the roadmap of the regional interest operation (OIR) Industries of the Future, which more specifically targets the aeronautics-space, security-defence, chemicals-materials, steel and optics-photonics sectors. In addition, it deals transversally with the transformation towards Industry 4.0, the decarbonisation of industry and the challenges of industrial sovereignty and
relocation, in line with France 2030, particularly through strategies for accelerating the decarbonisation of industry or recycling and the reincorporation of recycled materials.
Building on the achievements of the OIR 2016-2021 (Parcours Sud Industrie 4. 0 with, by mid-May 2022, 420 companies registered and 90 requests for subsidies granted for €10M, Investment Fund for Regional Companies (FIER) and «Pack Sud relocation», Campus des Métiers et des Qualifications Industrie du Futur, labelled campus of excellence and winner of the 2nd and 3rd Programme d’Investissements d’avenir (PIA), Territoires d’industrie approach and strategic economic land approach, TEAM Henri-Fabre, Regional Centre for UAV Resources (C2RD), Stratobus project, 14 projects presented to the Financial Engineering Committee of the OIR board for a total of €107.2M in private and public investment prospects, of which €65.3M is secured, definition of 8 industrial territories as privileged anchor territories for project development: AixRousset - Gardanne ; Istres - Fos - Marignane - Étang de Berre / Aix-Marseille
Provence Metropolis ; Avignon - SorguesCavaillon - Ventoux ; Carros ; Gap - Tallard
- Buëch ; Pays de Grasse - Sophia Antipolis


- Cannes ; Toulon - Ollioules - La Seynesur-Mer - Saint-Mandrier - Six-Fours-lesPlages; Vallée de la Durance; Haute Vallée de la Durance), the Southern Region aims to strengthen the regional industrial ecosystem by 2028 through the acceleration of its operational performance (innovation, 4. 0), its economic performance (competitiveness of companies, skills, attractiveness of professions) and its environmental performance (ecological and energy transition, decarbonisation and deployment of new sectors).
The Industries of the Future OIR has defined three priority areas for action and investment: accelerate the transformation towards the industry of the future and support the innovation and growth of industrial companies, deploy a «Cop d’avance» (One COP ahead) in industry (in particular by supporting innovation efforts on hydrogen, the changes in the industrial sectors of the OIR and the structuring of new green sectors in connection with recycling and the circular economy, by consolidating the decarbonisation strategy with a mix of public-private financing), to promote the South region as a Territory of Industry and to reinforce its attractiveness in order to regain industrial sovereignty (strategic economic land, «Premium Route» for the
97 April 2023
© Geanncarlo Lugo
The University of Toulouse III - Paul Sabatier / L’Université de Toulouse III – Paul Sabatier
establishment of the most strategic industrial projects, prospecting actions targeted on the strategic segments of the OIR and the missing links in the regional value chains, networking of the actors and territorial ecosystems through the Territories of Industry).
Multi-strand support
The regional strategy is supported by many dynamic players, such as the TEAM Henri-Fabre association: heir to the Henri-Fabre project, which was launched in 2012 with a view to building a new, more collective and collaborative industrial development model, driven by innovation and technological opportunities arising from digital technology, this public-private initiative brings together the expertise of its partners in the aeronautics, energy, photonics, naval and biomedical sectors. TEAM Henri-Fabre’s partners include INOVSYS, a technology company specialising in the detection, validation and transfer of technologies, methods and industrial solutions. It has a number of achievements to its credit: robotic control of surface defects, protection methods for critical parts, cleaning of mechanical assemblies, pickling technologies, etc. In addition, INOVSYS has developed two areas of technological expertise in additive manufacturing on the one hand, and reindustrialisation and remanufacturing on the other. Its ability to detect, validate and transfer technologies has been recognised through two labels: «Mutualised Innovation Platform» within the framework of the PIA and «Solution Provider» within the framework of the Industry of the Future Programme.
In 2022, TEAM Henri-Fabre presented an excellent report, with new structuring projects for the territory around 4 themes: attractiveness and skills, evolution of industrial SMEs, support for major contractors and visibility of the industry. Despite a difficult economic situation, it considers the year 2023 as a great source of opportunities for three reasons: the attractiveness of the industry and the development of skills are improving, the evolution of 300 VSE-SMEs towards the Industry of the Future is well underway (thanks to the accelerator towards the Industry of the Future PRACCIIS which continues the priming operated by PSI 4. 0) and innovative projects are being carried out by major contractors such as Arqane (Actions of Realization and Qualification in Nuclear Additive): launched in 2022, this project will accelerate the integration of additive manufacturing methods and practices in this sector, by producing pre-qualified parts of nuclear quality.
Another key player is the Regional Drone Resource Centre (C2RD, formerly CEEMA). An international reference and partner of the Drone sector since 2008, the C2RD is a one-stop multi-service centre dedicated to the players in the AirLand-Sea, civil and military Drone sector. It specialises in conducting flight tests with the emergence in 2008 of an aeronautical platform that is unique in the world. Its expertise and the resources developed over the years have made it a recognised player by the regulatory authorities and industrial players in the Drone sector. In 2020, the C2RD became the Regional Drone Resource Centre, offering players in the

sector a complete framework for multi-milieu tests, instrumented and secure, which concentrates all the expected resources and services: tests and flight trials, expertise and AMOA, campus, events, business incubator, etc. Its pilot site, located in Pourrières on nearly 85 hectares, benefits from unique infrastructures to ensure the success of all test campaigns: 300 m asphalt track, regulated segregated area... C2RD’s services are particularly appreciated by its many partners, such as Airbus Group, the Directorate of International Security Cooperation (DCIS), Sud Drone, Flying Whales, the Southern Region, Techsys (creator of drone solutions), A-NSE (Aero-Nautic Services & Engineering), DPDgroup (delivery of parcels by drone)...
Towards «smart» territories
Co-designed by the Nice-Côte d’Azur (NCA) Metropolis and the Université Côte d’Azur and operational between 2018 and 2020, the Smart City Innovation Center (SCIC) has been pioneered as a unique collaborative technological platform in France, dedicated to innovation and economic development around the Smart City, the sustainable and connected city. Located at the Mediterranean Institute of Risk, Environment and Sustainable Development (IMREDD) in the heart of the Eco-vallée, this 300 m² showroom brought together the university and leading industrialists in the field of innovation and the «smart» city (Veolia, IBM, m2ocity, Orange, ERDF, EDF). The aim was to encourage synergies around projects dealing with four major issues for the Smart City: energy, the environment, risks and mobility. Thanks to the SCIC, the stakeholders were able to experiment with new uses and new services. Sensors spread throughout the metropolitan area have fed the platform by measuring various parameters (air quality, rainfall volumes, road traffic flow, noise pollution, energy consumption of individuals or volunteer companies) and the SCIC has made it possible to materialise and visualise in real time all of the data collected, with the overall management of the city that can result from it. Open to all, the SCIC also served as a place for awareness-raising and training to build the «smart» city of tomorrow.
As a partner of IMREDD, the Capenergies competitiveness cluster was notably involved in the Smart Campus Nice Sophia Antipolis (2017-2022), an experimental “smart grid” which had 3 objectives: to support existing and new training courses, to accelerate the industrial transfer resulting from collaborative projects through direct exploitation by an industrial partner or the creation of start-ups and to develop collaborative research projects between academic and research partners and com-
98 Avril 2023
EC145 (Airbus Helicopters) of the Sécurité civile working in the Gorges du Gardon / EC145 (Airbus Helicopters) de la Sécurité civile travaillant dans les Gorges du Gardon
© Gérard Joyon
panies with a view to developing a unified platform for the design, planning, management, simulation and analysis of «smart grids» solutions.
Occitania: two “Acceleration platforms for the industry of the future”



On 21 November 2021, the winners of the national call for projects «Acceleration platforms for the industry of the future» were announced. Two projects from the Occitan region have been selected in this context. Log’In is an open innovation platform led by the Daher Group, the French leader in industrial logistics, with the support of the Occitanie Region and the State. Its aim is to support the transformation of the logistics professions by relying on a 600 m² space dedicated to collaboration. A space, but also resources, training, a network, an animation programme... In short, a whole range of logistics expertise made available to the projects and teams of start-ups, SMEs and ETIs in the sector. Log’In’s first client, EasyMile, is a global provider of software and complete solutions for autonomous urban mobility and the transport of goods in a controlled environment. The company also aims to develop vehicles for industrial environments. It is in this perspective that the collaboration with Log’In was initiated. The scope of the study concerns a vehicle intended for intralogistics flows in certain factories and flows in port areas. Thanks to Log’In’s experimental infrastructure, EasyMile can reproduce exactly the operational situations it will encounter at its customers’ sites. This is a welcome ability to anticipate
in order to gain speed of execution and efficiency in future deployments.
Another winning project: Pad’Occ. Led by the University of Toulouse, this collaborative project brings together Aerospace Valley, the CEA, the OPTITEC cluster, the IRT Saint-Exupéry, Mechachrome, the Campus des Métiers et des Qualifications d’Excellence «Aéronautique et spatial Occitanie», INSA, ISAE Supaero and the University of Toulouse III Paul Sabatier. The Pad’Occ platform relies on its Factory-School 4.0 as well as the latest generation tools and equipment to meet the needs of companies. It supports them in their industrial, technological and human transformation through personalised courses. To do this, it provides various services ranging from PoC (Proof of Concept) to the implementation of «end to end» processes. It also offers companies a range of services designed to promote their transformation towards industrial and environmental excellence. These services are structured in 4 areas: discovering and appropriating the contributions of the industry of the future, making a success of one’s industrial and environmental transformation project, making a success of one’s human and societal transformation project, and accessing institutional and financing mechanisms. A tailor-made course for optimal results.



More and greener transport
It is not only industry that is being overhauled. The transport sector is too. The Occitanie Region is creating the conditions for
carbon-free rail freight. This is reflected in the development of new road-rail transfer platforms, the construction of an intermodal road-rail platform at the port of Sète-Frontignan, the reopening of freight lines and, of course, the promotion of zero-emission heavy mobility with the «Occitanie H2 Corridor» project: supported by the European Union, it aims to replace the use of fossil fuels with green hydrogen for trucks, refrigeration units and coaches. A national first that should be emulated.
StratobusTM: a technological breakthrough for a stratospheric airship
Thales Alenia Space, a joint venture between Thales (67%) and Leonardo (33%), selected the commune of Istres (Bouches du Rhône) in June 2021 as the site for its StratobusTM product line, an autonomous multi-mission stratospheric airship covering the fields of observation, the environment and telecommunications. This is a real technological breakthrough for this vehicle, which is equipped with electric propulsion and energy-saving technology. Thales Alenia Space and its partners have succeeded in demonstrating the technical feasibility of the spacecraft through a large number of complex demonstrations and system modelling.
Strongly supported by the State, the Region and the Metropolis of Aix-Marseille-Provence, the StratobusTM project involves the entire regional economic fabric and should lead to the creation of 200 direct jobs at the start of the project, 300 in the long term, 60% of which will be engineers in the aeronautics cluster of Istres, and more than 600 indirect jobs. This launcher-less satellite, powered entirely by solar energy, represents a real advance in telecommunications and energy transition for the entire region. It will need European cooperation to complete the regional and national support and finalise its development, certification and industrialisation.

99 April 2023
© Visse CC BY-SA 3.0 Wikimedia
ArcelorMittal in Fos-sur-Mer / ArcelorMittal à Fos-sur-Mer
Aéronautique et spatial : un vecteur d’excellence industrielle pour l’Occitanie
Le secteur aéronautique et spatial constitue la première industrie d’Occitanie / Pyrénées-Méditerranée avec plus de 1 000 fournisseurs, sous-traitants, bureaux d’études et 98 000 emplois1. Toulouse abrite le siège mondial d’Airbus Group et le quartier général du pôle de compétitivité Aerospace Valley. En outre, la région est le premier pôle français d’enseignement supérieur et de recherche en aéronautique, les trois-quarts des ingénieurs français y étant formés. Petit aperçu des principaux acteurs.

Qui dit aérospatial dit Airbus. Désireux d’être le pionnier de l’aérospatiale durable, le groupe s’engage à mener la décarbonisation du secteur aérospatial en développant de nouvelles technologies. À cette fin, il a pour objectif de livrer le premier avion à émissions nulles au monde d’ici 2035, ce qui ouvrira la voie à des voyages neutres sur le plan climatique. Dans le même temps, ses avancées en matière de mobilité urbaine aérienne offriront des options plus propres pour une solution de mobilité plus rapide et plus fiable dans les zones urbaines : un service présenté comme sûr, écologique et pratique qui exploite l’espace aérien au-dessus de nos têtes.
De même, les technologies spatiales d’Airbus permettent à l’humanité d’envoyer des vaisseaux spatiaux vers des planètes, des lunes et des comètes, à la fois près de notre soleil et à des millions de kilomètres de distance. Pour leur part, ses solutions d’imagerie satellitaire ne cessent de développer la connaissance humaine de notre univers, qu’il s’agisse de la capacité à capturer des événements critiques sur Terre ou de fournir les solutions qui permettent l’exploration de l’espace lointain. Si Airbus est à la proue de l’écosystème régional à l’instar de Safran, Thales ou encore Liebherr-Aerospace Toulouse, il n’en n’est pas moins conforté par tout un réseau de PME ou ETI locales (Steel Electronique, Mecano-ID, Comat, Erems…).
Une recherche de pointe Avec 6 271 millions d’euros dédiés aux dépenses intérieures en R&D (soit 12,3 % des dépenses intérieures R&D de France métropolitaine), qui correspondent à 3,6 % de son PIB, l’Occitanie se hisse au premier rang des régions françaises en termes d’efforts de recherche2. 49 679 personnes en équivalent temps plein étaient rémunérées pour des activités de R&D en Occitanie en 2018, ce qui correspond à 11,2 % des effectifs R&D de France métropolitaine. L’Occitanie occupe ainsi la troisième place dans la hiérarchie des régions (derrière l’Île-de-France et Auvergne-Rhône-Alpes).
Face aux grands défis mondiaux de la transformation digitale et de la transformation environnementale, le renforcement de la compétitivité industrielle et le développement de produits de rupture exigent des activités de recherche partenariale entre l’industrie et les acteurs de la recherche publique. C’est tout l’enjeu de l’IRT Saint Exupéry, qui a vocation à accélérer le transfert de la recherche académique vers l’industrie, des start-ups aux grands groupes, pour les filières aéronautique, spatiale et systèmes embarqués. Engagé sur l’électrification des avions, il s’est fixé 4 axes technologiques : les technologies intelligentes, les méthodes et outils pour le développement de systèmes complexes, les technologies plus vertes et les technologies de fabrication avancées. Ses plateformes
technologiques offrent une gamme complète d’équipements différenciateurs et multidisciplinaires dans ses quatre domaines d’expertise : matériaux et procédés, énergie, ingénierie et modélisation de systèmes, intelligence artificielle et communications.
En outre, l’IRT Saint Exupéry propose trois types de projets de recherche. Premier type : des projets de recherche « internes » en réponse aux besoins de recherche partagés des industriels. Ils s’inscrivent dans les feuilles de route des 4 axes technologiques et bénéficient d’un cofinancement dans le cadre de France Relance 2030. Les membres contributeurs de ces projets, qu’ils soient industriels, ETI, PME ou académiques, ont un accès privilégié aux résultats. Deuxième type : les projets de recherche collaboratifs. Ils sont lancés en réponse à divers appels à projets régionaux, nationaux ou européens pour développer des résultats communs autour d’un thème de recherche innovant. Dans ce cadre, l’IRT propose d’associer ses compétences à celles des entreprises et de constituer ensemble un consortium. Enfin, les projets de recherche en sous-traitance répondent aux besoins spécifiques des entreprises en s’appuyant sur son expertise et ses plateformes technologiques : conseil et expertise, étude de faisabilité, soutien technique, test de caractérisation, preuve de concept, accès à la plateforme et aux équipements, formation.
100 Avril 2023
© Keta CC BY-SA 2.5 Wikimedia
A380 à Toulouse / A380 in Toulouse
À titre d’exemple, l’IRT Saint Exupéry soutient MAMA, un projet lancé en 2018 et doté d’un budget de 10.4 M € qui vise 30 % d’économie de matière première pour les pièces d’aérostructure en titane. Plus largement, les objectifs industriels sont de réduire significativement les coûts récurrents de fabrication, de réduire le volume des matières premières utilisées et de développer des solutions de réparation de pièces aéronautiques à très haute valeur ajoutée. Le projet contribue également à une réduction significative de l’empreinte environnementale de l’industrie aéronautique.

Parmi les résultats présentés, un démonstrateur Ti64 en titane de 800 mm de long correspondant à une section à l’échelle 1:1 d’un cadre de fuselage d’Airbus A350 a été dévoilé. Il a démontré une réduction de plus de 30 % de la quantité de matière première utilisée en matriçage fermé par rapport à la solution industrielle actuelle. Une belle opportunité de proposer de nouvelles conditions de matriçage/modelage de pièces aéronautiques en alliage de titane (Ti64) et les combiner avec les techniques émergentes de fabrication additive par dépôt de poudres et de fils métalliques. L’ensemble des avancées scientifiques s’appuie sur une plateforme de recherche unique en Europe développée au cours du projet et dédiée à l’hybridation entre les procédés de matriçage et les technologies de fabrication additive métallique.
Ce projet prendra fin à l’été 2023 mais les premiers résultats ont déjà permis d’identifier des débouchés industriels potentiels pour les procédés de fabrication additive dans le domaine de l’outillage et de la réparation de pièces d’aéronefs ainsi que sur le marché des pièces de rechange. Une belle réussite pour les 11 membres impliqués : des industriels bien sûr (Airbus, Aubert & Duval, IRT Saint Exupéry, Mecaprec, OPT’ALM, Recaero, Sciaky), des acteurs académiques (CIRIMAT, ENIT de Tarbes) et des acteurs publics (SGPI, Région d’Occitanie).
Ce projet multidisciplinaire illustre à merveille la nécessité de rassembler l’ensemble des compétences régionales, tout aussi bien représentées par des acteurs tels que Mercator Ocean, une organisation intergouvernementale dont les services scientifiques visent la préservation des océans et l’utilisation durable de ses ressources, Météo-France, le CNES, l’IRAP (Institut de recherche en astrophysique et planétologie), Toulouse Aerospace et bien sûr Aerospace Valley, le premier pôle de compétitivité européen de la filière aérospatiale au service de trois filières


sur les régions Occitanie / Pyrénées-Méditerranée et Nouvelle-Aquitaine : avec 861 membres dont 614 PME et 1 070 projets labellisés, il favorise l’innovation dans l’aéronautique, l’espace, les drones, la défense et 5 écosystèmes d’excellence que sont l’économie des données et l’IA, les structures, matériaux et procédés, les systèmes embarqués et communicants, la propulsion et l’énergie embarquée ainsi que les solutions pour l’usine du futur.
L’Occitanie, piste de décollage des futurs avions verts
En juin 2022, la Région a adopté un plan Avion Vert qui mobilise et soutient les compétences industrielles et académiques de l’Occitanie afin d’accélérer la décarbonation du transport aérien. Ce faisant, elle rejoint l’engagement pris par l’Association internationale du transport aérien de ramener à zéro les émissions de carbone des aéronefs en 2050.
D’après l’Institut Montaigne, plusieurs leviers permettront d’aboutir à la décarbonation du transport aérien : les carburants alternatifs (53 % de l’effort nécessaire), les développements technologiques (34 %), l’optimisation des opérations en vol et au sol (7 %) et les mesures de compensation (6 %). Le Plan que la Région engage les prend en compte.

Premier volet : grâce à lui, un centre d’essais axé sur le développement des nouvelles technologies hydrogène et carburants durables verra le jour à Francazal. Ce technocampus sera au service du développement non seulement des futurs avions à hydrogène, mais aussi des bus et camions. D’autres équipements scientifiques, centrés sur les carburants alternatifs, le compléteront. Concentration unique en France de compétences, il sera le plus grand d’Europe et s’étendra sur 10 000 m² pour accueillir des plates-formes d’équipements
scientifiques, des surfaces dévolues aux partenaires industriels et des espaces tertiaires.
En parallèle, la Région accompagnera le développement des carburants durables d’aviation au travers d’Appels à Manifestation d’Intérêt et elle amplifiera son soutien au développement de l’aviation légère durable. Sur ce point, 17 projets, impliquant plus de 20 entreprises régionales, ont déjà été retenus, portant, entre autres, sur la réalisation de drones hydrogène et sur le développement d’un train d’atterrissage intégralement électrique.
L’accent sera également mis sur le renouvellement des compétences, les nouveaux métiers et l’attractivité de la filière. Pas de transition possible vers la décarbonation sans personnels formés. La Région Occitanie, qui est déjà à l’origine du projet GENHYO de création d’un Campus Hydrogène porté par les acteurs de la formation, soutiendra aussi la formation des salariés du secteur.
Enfin, les efforts d’innovation des entreprises régionales, centrés sur l’aviation verte, seront soutenus, tout comme le projet de création d’un Institut de l’Aviation Durable, porté par l’ISAE SUPAERO à Toulouse. Pour mener de front toutes ces actions, la Région a décidé d’affecter une enveloppe de 100 M€ au Plan Avion Vert3. Un volontarisme qui rassemble acteurs publics et privés et devra s’accompagner d’une réduction significative du trafic aérien pour relever un défi urgent : assainir l’atmosphère terrestre… et au-delà !
1 Source : Campus des Métiers et des Qualifications d’Excellence.
2 Chiffres de l’INPI et du ministère de la Recherche et de l’Innovation analysés par l’Observatoire Économique (OBSéco) d’Occitanie.
3 Source : Région Occitanie / Pyrénées-Méditerranée.

101 April 2023
© Institut Montaigne
Aeronautics and space: a vector of industrial excellence for Occitania
The aeronautics and space sector is the leading industry in Occitanie / Pyrénées-Méditerranée with more than 1,000 suppliers, subcontractors, design offices and 98,000 jobs. Toulouse is home to the world headquarters of Airbus Group and the headquarters of the Aerospace Valley competitiveness cluster. In addition, the region is France’s leading centre for higher education and research in aeronautics, with three-quarters of French engineers trained here. Here is a brief overview of the main players.

Aerospace means Airbus. The group is committed to leading the decarbonisation of the aerospace sector by developing new technologies. To this end, it aims to deliver the world’s first zero-emission aircraft by 2035, paving the way for climate-neutral travel. At the same time, its advances in urban air mobility will offer cleaner options for a faster and more reliable mobility solution in urban areas: a service touted as safe, green and convenient that harnesses the airspace above our heads.
Similarly, Airbus’ space technologies enable mankind to send spacecraft to planets, moons and comets, both close to our sun and millions of kilometres away. In turn, its satellite imaging solutions continue to expand human knowledge of our universe, from the ability to capture critical events on Earth to providing the solutions that enable deep space exploration. While Airbus is at the forefront of the regional ecosystem, following the example of Safran, Thales and Liebherr-Aerospace Toulouse, it is nonetheless supported by a whole network of local SMEs and ETIs (Steel Electronique, Mecano-ID, Comat, Erems, etc.).
Cutting-edge research
With 6,271 million euros dedicated to domestic R&D expenditure (i.e. 12.3% of domestic R&D expenditure in mainland
France), which corresponds to 3.6% of its GDP, Occitania ranks first among French regions in terms of research efforts. 49,679 people in full-time equivalent were paid for R&D activities in Occitania in 2018, which corresponds to 11.2% of the R&D workforce in mainland France. Occitania is thus in third place in the regional hierarchy (behind Île-de-France and AuvergneRhône-Alpes).
Faced with the major global challenges of digital and environmental transformation, the strengthening of industrial competitiveness and the development of disruptive products require partnership research activities between industry and public research players. This is the challenge of the IRT Saint Exupéry, which aims to accelerate the transfer of academic research to industry, from start-ups to large groups, for the aeronautics, space and embedded systems sectors. Committed to the electrification of aircraft, it has set itself 4 technological axes: intelligent technologies, methods and tools for the development of complex systems, greener technologies and advanced manufacturing technologies. Its technological platforms offer a complete range of differentiating and multidisciplinary equipment in their four areas of expertise: materials and processes, energy, engineering and systems modelling, artificial intelligence and communications.
In addition, IRT Saint Exupéry offers three types of research projects. First type: «internal» research projects in response to the shared research needs of industry. They are part of the roadmaps of the 4 technological axes and benefit from co-financing within the framework of France Relance 2030. The contributing members of these projects, whether they are industrialists, ETIs, SMEs or academics, have privileged access to the results. Second type: collaborative research projects. They are launched in response to various regional, national or European calls for projects to develop common results around an innovative research theme. In this context, the IRT proposes to associate its skills with those of companies and to form a consortium together. Finally, subcontracted research projects meet the specific needs of companies by relying on its expertise and technological platforms: advice and expertise, feasibility studies, technical support, characterisation tests, proof of concept, access to the platform and equipment, training.
As an example, IRT Saint Exupéry is supporting MAMA, a project launched in 2018 with a budget of €10.4M that aims to achieve a 30% saving in raw materials for titanium aerostructure parts. More broadly, the industrial objectives are to significantly reduce recurring manufacturing costs, to
102 Avril 2023
© Girostat CC BY-SA 4.0 Wikimedia
Entrance to the Toulouse Space Centre / Entrée du Centre spatial de Toulouse
reduce the volume of raw materials used and to develop repair solutions for aeronautical parts with very high added value. The project also contributes to a significant reduction of the environmental footprint of the aeronautical industry.
Among the results presented was an 800 mm long titanium Ti64 demonstrator corresponding to a 1:1 scale section of an Airbus A350 fuselage frame. It demonstrated a reduction of more than 30% in the amount of raw material used in closed die-forging compared to the current industrial solution. This is a great opportunity to propose new closed die-forging/moulding conditions for aeronautical parts made of titanium alloy (Ti64) and to combine them with the emerging techniques of additive manufacturing by deposition of powders and metallic wires. All the scientific advances are based on a research platform, unique in Europe, developed during the project and dedicated to the hybridization between closed die-forging processes and metal additive manufacturing technologies.
This project will end in the summer of 2023, but the initial results have already identified potential industrial outlets for additive manufacturing processes in the field of tooling and the repair of aircraft parts, as well as in the spare parts market. A great success for the 11 members involved: industrialists of course (Airbus, Aubert & Duval, IRT Saint Exupéry, Mecaprec, OPT’ALM, Recaero, Sciaky), academic players (CIRIMAT, ENIT of Tarbes) and public players (SGPI, Occitanie Region).


This multidisciplinary project is a perfect example of the need to bring together all regional skills, which are also well represented by players such as Mercator Ocean, an intergovernmental organisation whose


scientific services aim to preserve the oceans and ensure the sustainable use of its resources, Météo-France, CNES, IRAP (Institute for Research in Astrophysics and Planetology), Toulouse Aerospace and, of course, Aerospace Valley, the leading European competitiveness cluster in the aerospace sector, serving three sectors in the Occitanie / Pyrénées-Méditerranée and Nouvelle-Aquitaine regions: with 861 members, including 614 SMEs and 1,070 accredited projects, it promotes innovation in aeronautics, space, drones, defence and five ecosystems of excellence, namely the data economy and AI, structures, materials and processes, embedded and communicating systems, propulsion and embedded energy, and solutions for the factory of the future.


Occitania, the runway for future green aircraft
In June 2022, the Region adopted a Green Aircraft Plan which mobilises and supports the industrial and academic skills of Occitania to accelerate the decarbonisation of air transport. In doing so, it is joining the commitment made by the International Air Transport Association to reduce aircraft carbon emissions to zero by 2050.
According to the Institut Montaigne, several levers will make it possible to achieve the decarbonisation of air transport: alternative fuels (53% of the effort required), technological developments (34%), optimisation of flight and ground operations (7%) and compensation measures (6%). The Plan that the Region is undertaking takes them into account.
Firstly, thanks to it, a test centre focused on the development of new hydrogen technologies and sustainable fuels will be created at Francazal.
This technocampus will serve the development not only of future hydrogen-powered aircraft, but also of buses and trucks. Other scientific facilities, focused on alternative fuels, will complete it. A unique concentration of skills in France, it will be the largest in Europe and will cover 10,000 m² to accommodate scientific equipment platforms, areas devoted to industrial partners and service areas.
At the same time, the Region will support the development of sustainable aviation fuels through calls for expressions of interest and will increase its support for the development of sustainable light aviation. On this point, 17 projects, involving more than 20 regional companies, have already been selected, including the development of hydrogen drones and a fully electric landing gear.
Emphasis will also be placed on the renewal of skills, new professions and the attractiveness of the sector. No transition to decarbonation is possible without trained personnel. The Occitanie Region, which is already behind the GENHYO project for the creation of a Hydrogen Campus supported by the training players, will also support the training of employees in the sector.
Finally, the innovation efforts of regional companies, focused on green aviation, will be supported, as will the project to create a Sustainable Aviation Institute, led by ISAE SUPAERO in Toulouse. To carry out all these actions, the Region has decided to allocate a budget of €100 million to the Green Aircraft Plan. This voluntary approach brings together public and private players and must be accompanied by a significant reduction in air traffic to meet an urgent challenge: cleaning up the earth’s atmosphere... and beyond!
103 April 2023
Aerial view of the Lagardère Airbus factory / Vue aérienne de l’usine Lagardère d’Airbus
© Duch CC BY-SA 4.0 Wikimedia © Pascalou Petit CC BY-SA 3.0 Wikimedia
Telescope Bernard Lyot (Pic du Midi Observatory) at sunrise Le télescope Bernard Lyot (Observatoire du Pic du Midi) au lever du soleil
Occitanie : cap sur l’emploi,

la souveraineté et la transformation écologique
Accompagner la transformation de l’économie, de l’emploi, de l’enseignement supérieur et la recherche, de l’agriculture ou encore du tourisme : c’est, pour 2023, le maître-mot de Carole Delga, présidente de la Région. Le Stratégie Régionale pour l’Emploi, la Souveraineté et la Transformation Écologique (SRESTE) engage la Région dans la reconquête d’une souveraineté industrielle, énergétique et alimentaire.
Faire de l’urgence climatique une opportunité de bâtir un nouveau modèle de développement qui ne laisse personne au bord du chemin : telle est l’ambition de la Région Occitanie. Issue d’une vaste concertation (13 réunions territoriales, deux réunions thématiques, deux cycles d’ateliers réunissant plus de 1 200 participants et une centaine de contributions recueillies en ligne), la SRESTE vise à accroître la souveraineté industrielle, énergétique, alimentaire et celle des savoirs.
Comment regagner une souveraineté sur des secteurs stratégiques ? Par la relocalisation d’activités et de savoir-faire sur le territoire. Les marques Sud de France pour la souveraineté alimentaire, ou Fabriqué en Occitanie pour l’excellence industrielle, ont déjà lancé cette dynamique. La Région veut désormais accompagner les entreprises et les territoires pour soutenir les approvisionnements en région et encourager la relocalisation d’activités.
Les nouvelles filières seront soutenues, telles que les biothérapies, l’hydrogène ou l’éolien flottant, pour poser les bases de la mobilité du futur, de l’écoconstruction et du tourisme durable. Les PME locales seront encouragées à explorer l’export et l’international.
Le Fonds Souverain Régional, doté de 400 millions d’euros, va être amplifié pour que les entreprises stratégiques ou à fort potentiel puissent se développer en toute indépendance. La Région se dotera de sa propre société de gestion pour le fonds.
Accélérer la transformation du modèle économique et préparer les compétences de demain Soucieuse de promouvoir la Responsabilité Sociétale des Entreprises (RSE), la Région accompagne dans un même élan la trans-
formation des grandes filières économiques du territoire. Plusieurs plans d’actions sont déployés : le Plan Avion Vert pour la filière aéronautique, le plan Habitat Durable pour la filière du bâtiment, le Plan Hydrogène Vert ou encore les contrats de filières agricoles et agroalimentaires. 150 millions d’euros vont par ailleurs être consacrés sur 2023-2027 à un numérique durable, plus éthique et responsable.

Enfin, la Région agira sur le modèle économique régional en anticipant les besoins en compétences et métiers de demain, dont ceux concourant à la transition énergétique.
Renforcer le rayonnement de la région par l’innovation
Pour faire de l’Occitanie une des premières régions scientifiques et technologiques d’Europe, et renforcer son rayonnement par l’innovation, la Région entend s’appuyer sur le levier de l’économie de la connaissance. S’appuyant sur 35 grandes écoles et universités (dont les deux pôles universitaires majeurs de Toulouse et Montpellier ainsi que les « villes universitaires d’équilibre »), des organismes de recherche et des pôles de compétitivité, la Région veut renforcer les liens entre la recherche et les entreprises pour booster la création d’entreprises innovantes, mais aussi insuffler cette dynamique dans les PME et TPE.
104 Avril 2023
Airbus A350-900 atterrissant à l’aéroport de Toulouse-Blagnac / Airbus A350-900 landing at Toulouse-Blagnac airport
© Laurent Errera –Wikimedia Commons
TER du Transpyrénéen Oriental avec l’ancienne livrée Midi-Pyrénées à la gare de Latour-de-Carol - Enveitg près de la frontière avec l’Espagne dans les Pyrénées / TER of the Transpyrénéen Oriental with the old Midi-Pyrénées livery at Latour-de-Carol - Enveitg station near the border with Spain in the Pyrenees
© Smiley.toerist Wikimedia Commons
Parmi les actions mises en place, la Région renforce sa boîte à outils en faveur de la R&D et de l’innovation avec 20 Défis Clés pour l’Occitanie, une collaboration laboratoires-PME avec ReadyNov, ou encore les Contrats Innovation pour les entreprises, dotés de 100 M€.

Quatre défis clés pour stimuler la dynamique de la recherche occitane Bâtis par la Région avec les communautés scientifiques, les « Défis clés » veulent rendre la recherche régionale encore plus collaborative, visible et attractive. Stratégiques, quatre défis ont été lancés en janvier 2021 sur la biodiversité, l’hydrogène vert, les technologies quantiques et les « risques infectieux et vecteurs ».
En échange des « feuilles de route » établies avec chaque communauté scientifique jusqu’en 2024, la Région apporte des moyens : 2 à 3 M€ par défi. De quoi appuyer des projets de recherche, cofinancer des thèses, stimuler les collaborations entre laboratoires et avec les entreprises, agrandir la visibilité de la recherche régionale et attirer chercheurs, étudiants et entrepreneurs en Occitanie. Au-delà du montant alloué, la Région innove en confiant les budgets des Défis clés directement aux communautés scientifiques.
PRIHyO mise sur l’hydrogène vert Engagée dans son « Plan Hydrogène vert » de 150 M€, la Région mobilisera 3 M€ pour le Défi-clé baptisé PRIHyO. Porté par l’Université Fédérale de Toulouse Midi-Pyrénées, il vise à faire de l’Occitanie le 2ème pôle français (hors Île-de-France) sur le sujet. 130 chercheurs et techniciens de 18 laboratoires occitans travaillent déjà sur ces technologies - un chiffre qui pourrait monter à 200 en 2024. PRIHyO se focalise sur la production d’hydrogène, son stockage, son utilisation
pour la production d’énergie, la sécurité, l’acceptation et la vulgarisation des technologies. L’objectif : améliorer les technologies existantes et développer les technologies de nouvelle génération en se basant sur les compétences régionales en matière d’électrolyseur et de stockage. Des projets de recherche seront accompagnés et une vingtaine de thèses cofinancées sur quatre ans.
Les scientifiques veulent aussi nouer des partenariats avec des industriels régionaux - acteurs aéronautiques et producteurs d’hydrogène - et contribuer à l’offre de formations spécialisées. Ce Défi clé s’insère naturellement dans les grands projets « Hydrogène » d’Occitanie : quatre laboratoires participant à PRIHyO sont impliqués dans le techno-campus prévu à Francazal en 2024. Autre avantage appréciable : un positionnement comme acteur unique, et donc plus visible, vis-à-vis de l’Agence nationale de la recherche et de la Commission européenne.
RIVOC veut prévenir les maladies vectorielles
Englober des recherches sur la santé des êtres humains, des animaux et des plantes (le fameux concept de « one health »), c’est l’originalité du Défi clé RIVOC, issu de la key initiative RIVE de l’I-Site MUSE (Montpellier Université d’Excellence). Les chercheurs étudient les vecteurs (moustiques, moucherons, pucerons, bactéries…), transmetteurs de maladies humaines comme le paludisme, la dengue, le chikungunya, ou de maladies touchant la vigne et l’arboriculture… Un millier d’acteurs sont concernés à Montpellier, Toulouse et Perpignan. Ce Défi clé va permettre de développer des projets inter-laboratoires, associant plusieurs sites d’Occitanie. Avec, en ligne de mire, la consolidation du positionnement régional. RIVOC reçoit 2 M€ de la Région :
un effet de levier plus que probable pour accéder à des financements complémentaires régionaux, nationaux ou européens. Une opportunité, aussi, d’élargir les collaborations et d’accroître l’attractivité d’une région au dynamisme déjà bien affiché1
L’Institut quantique occitan, booster de recherches
En Occitanie, 200 chercheurs de 12 laboratoires du Cnrs, des universités de Montpellier et Toulouse III-Paul Sabatier, de l’Insa et d’Isae-Supaero planchent sur la mécanique et l’ingénierie quantiques, tout comme IBM, ATOS, Timelink Microsystems, Airbus, Thales Alenia Space, le Cnes et Cerfacs. De quoi justifier un Défi clé « technologies quantiques », doté de 2 M€ par la Région. Animé par le Cnrs via l’Institut quantique occitan, ce Défi clé se concentre sur les communications sécurisées, les capteurs, la métrologie et la simulation quantique. En 2021, une douzaine de thèses et une dizaine de contrats « post-doc » ont été cofinancées, comme des recherches associant laboratoires publics et entreprises, et des actions de formation. Deux appels à projets similaires ont été lancés en 2022. En plus de renforcer la main d’œuvre régionale sur cette thématique hautement stratégique, la Région s’appuie sur l’Institut quantique occitan pour soutenir le développement de nouvelles plateformes expérimentales autour de projets collaboratifs ainsi que des actions d’éducation autour de pratiques pédagogiques partagées au sein du territoire.


105 April 2023
© I’ingénieur Wikimedia Commons
Le campus d’Isae-Supaéro / The Isae-Supaéro campus
Centre de Recherche Pierre-Fabre, Oncopole à Toulouse / Pierre-Fabre Research Centre, Oncopole in Toulouse
© Don-vip Wikimedia Commons
1 Source : Conseil régional Occitanie / Pyrénées-Méditerranée.
Occitania: focus on employment, sovereignty and ecological transformation
Accompanying the transformation of the economy, employment, higher education and research, agriculture and tourism: this is the watchword of Carole Delga, President of the Region, for 2023. The Regional Strategy for Employment, Sovereignty and Ecological Transformation (SRESTE) commits the Region to the reconquest of industrial, energy and food sovereignty.
The Occitanie Region’s ambition is to turn the climate emergency into an opportunity to build a new development model that leaves no one by the wayside. The SRESTE is the result of a vast consultation process (13 territorial meetings, two thematic meetings, two cycles of workshops bringing together more than 1,200 participants and a hundred or so contributions collected online), and aims to increase industrial, energy, food and knowledge sovereignty.
How can we regain sovereignty over strategic sectors? By relocating activities and know-how in the region. The Sud de France brand for food sovereignty and the Fabriqué en Occitanie brand for industrial excellence have already launched this process. The Region now wants to support companies and territories to sustain supplies in the region and encourage the relocation of activities.
New sectors will be supported, such as biotherapies, hydrogen or floating wind power, to lay the foundations for the mobility of the future, eco-construction and sustainable tourism. Local SMEs will be encouraged to explore export and international markets.
The Regional Sovereign Fund, endowed with 400 million euros, will be expanded so that strategic or high-potential companies can develop independently. The Region will set up its own management company for the fund.
Accelerating the transformation of the economic model and preparing the skills of tomorrow
Anxious to promote Corporate Social Responsibility (CSR), the Region is also supporting the transformation of the region’s major economic sectors. Several action plans are being deployed: the Green Plane Plan for the aeronautical industry, the Sustainable Housing Plan for the construction industry, the Green Hydrogen Plan and the agricultural and agri-food industry contracts. 150 million euros will also be devoted over the period 2023-2027 to sustainable, more ethical and responsible digital technology.
Finally, the Region will act on the regional economic model by anticipating the needs in skills and professions of tomorrow, including those contributing to the energy transition.
Strengthening the region’s influence through innovation

To make Occitania one of the leading scientific and technological regions in Europe, and to strengthen its influence through innovation, the Region intends to rely on the lever of the knowledge economy. Relying on 35 grandes écoles
and universities (including the two major university centres of Toulouse and Montpellier as well as the «balanced university cities»), research organisations and competitiveness clusters, the Region wants to strengthen the links between research and business to boost the creation of innovative companies, but also to instil this dynamic in SMEs and VSEs.
Among the actions implemented, the Region is strengthening its toolbox in favour of R&D and innovation with 20 Key Challenges for Occitania, a laboratory-SME
106 Avril 2023
Model of the Ariane 5 rocket in Toulouse / Maquette de fusée Ariane 5 à Toulouse
© Mike Peel
collaboration with ReadyNov, and the Innovation Contracts for companies, endowed with €100M.
Four key challenges to stimulate the dynamics of Occitan research
Built by the Region with the scientific communities, the «Key Challenges» aim to make regional research even more collaborative, visible and attractive. Four strategic challenges were launched in January 2021 on biodiversity, green hydrogen, quantum technologies and «infectious risks and vectors».
In exchange for the «roadmaps» established with each scientific community until 2024, the Region is providing resources: €2 to 3 million per challenge. This will support research projects, co-finance theses, stimulate collaboration between laboratories and with companies, increase the visibility of regional research and attract researchers, students and entrepreneurs to Occitania. Beyond the amount allocated, the Region is innovating by entrusting the budgets of the Key Challenges directly to the scientific communities.
PRIHyO focuses on green hydrogen Committed to its €150 million «Green Hydrogen Plan», the Region will mobilise €3 million for the Key Challenge named PRIHyO. Supported by the Toulouse Midi-Pyrénées Federal University, it aims to make Occitania the 2nd French cluster (outside the Ile-de-France region) on the subject. 130 researchers and technicians from 18 laboratories in Occitania are already working on these technologies - a figure that could rise to 200 by 2024. PRIHyO focuses on the production of hydrogen, its storage, its use for energy production, safety, acceptance and popularisation of technologies. The aim is to improve existing technologies and develop new generation technologies based on regional expertise in electrolyser and storage. Research projects will be supported and around twenty theses co-financed over four years.
The scientists also want to forge partnerships with regional industrialists - aeronautical players and hydrogen producers - and contribute to the provision of specialised training. This Key Challenge fits naturally into the major «Hydrogen» projects in Occitania: four laboratories participating in PRIHyO are involved in the techno-campus planned for Francazal in 2024. Another appreciable advantage is the positioning as a single player, and therefore more visible, vis-à-vis the National Research Agency and the European Commission.


RIVOC wants to prevent vector-borne diseases
The originality of the RIVOC Key Challenge, which stems from the RIVE key initiative of the MUSE (Montpellier University of Excellence) I-Site, lies in the fact that it encompasses research on the health of humans, animals and plants
(the famous ‘one health’ concept). Researchers are studying vectors (mosquitoes, midges, aphids, bacteria, etc.), which transmit human diseases such as malaria, dengue fever and chikungunya, as well as diseases affecting vines and arboriculture. This Key Challenge will enable the development of inter-laboratory projects, associating several sites in Occitania. The aim is to consolidate the region’s position. RIVOC is receiving €2 million from the Region: a more than likely leverage effect to access additional regional, national or European funding. It is also an opportunity to broaden collaborations and increase the attractiveness of a region that is already very dynamic.
The Occitan Quantum Institute, a research booster
In Occitania, 200 researchers from 12 laboratories of the CNRS, the universities of Montpellier and Toulouse III-Paul Sabatier, the Insa and Isae-Supaero are working on quantum mechanics and engineering, as are IBM, ATOS, Timelink Microsystems, Airbus, Thales Alenia Space, the Cnes and Cerfacs. This justifies the creation of a «quantum technologies» key challenge, endowed with €2 million by the Region. Led by the CNRS via the Occitan Quantum Institute, this Key Challenge focuses on secure communications, sensors, metrology and quantum simulation. In 2021, a dozen theses and a dozen «post-doctoral» contracts have been co-financed, encompassing research associating public laboratories and companies, as well as training actions. Two similar calls for projects have been launched in 2022. In addition to strengthening the regional workforce in this highly strategic field, the Region is relying on the Occitan Quantum Institute to support the development of new experimental platforms around collaborative projects as well as educational actions around shared pedagogical practices within the territory.

107 April 2023
©
K
Assembly of an Airbus A350 / Assemblage d’un Airbus A350
Bernd
Wikimedia Commons
© Longershanks English Wikipedia
Diagram of green hydrogen production and consumption (the wind turbine represents decarbonised electricity production) A350 / Schéma de production et de consommation d’hydrogène vert (l’éolienne représente la production d’électricité décarbonée)
Innover pour les entreprises
Un entretien avec M. Jean-Denis MULLER, Directeur général de l’AiCarnot (lereseaudescarnot.fr)

Pourriez-vous nous présenter le réseau des instituts Carnot ?
Le label Carnot a été créé en 2006 sur le modèle des instituts allemands Fraunhofer pour accroître l’impact sociétal et économique de la recherche française. Aujourd’hui, le réseau compte 39 instituts Carnot sélectionnés tous les 4 ans par le ministère de la Recherche en fonction de l’excellence technique et scientifique, du volume d’activité de R&D partenariale et du professionnalisme dans la relation avec les entreprises. Chaque année, les 35 000 professionnels de notre réseau (20 % des effectifs de la recherche publique française) réalisent 55 % de la recherche partenariale avec les entreprises (600 M€ en 2021). Les instituts Carnot réinvestissent dans le ressourcement scientifique, le renforcement de l’effet réseau et la poursuite de la professionnalisation de la relation avec les entreprises. Avec 1 150 dépôts de brevets prioritaires et plus de 28 500 publications de rang A en 2021, le réseau des Carnot est un allié fiable et reconnu pour franchir la fameuse « vallée de la mort » de l’innovation afin qu’un produit ou un service deeptech puisse exister et trouver son marché à partir d’une technologie initiale. De plus, près d’une centaine de spin-off sortent chaque année de nos laboratoires. Depuis la loi de finances 2021, le réseau des Carnot bénéficie d’une trajectoire de soutien financier accru et ambitionne d’atteindre un volume annuel de recherche partenariale d’un milliard d’euros en 2030. Les Rendez-vous Carnot, l’un des plus importants salons européens consacré à l’innovation deeptech, sont là pour permettre à de nouveaux partenariats d’éclore. En 2023, cet événement aura lieu les 18 et 19 octobre à Lyon.
Pourriez-vous nous présenter les instituts
Carnot actifs dans la région Sud ?
Treize instituts Carnot ont des implantations dans la région Sud : 3BCAR (bioéconomie et chimie verte), ARTS (industrie du futur), CALYM (lymphome), Clim’adapt, Cognition, Eau & Environnement, Inria, M.I.N.E.S., OPALE (leucémies et maladies apparentées), Plant2Pro (productions végétales), Qualiment, STAR (sport), Télécom & Société numérique. CALYM a conclu un important contrat pluriannuel avec Bristol Myers Squibb pour identifier des biomarqueurs pronostiques et comprendre l’origine des rechutes dans le lymphome (cancer du sang). Ce partenariat de format original a généré des résultats prometteurs et d’ores et déjà permis d’engager d’autres partenariats avec cette entreprise. Qualiment accompagne des start-ups porteuses de projets d’innovation
alimentaire, attire des entrepreneurs sur la base d’une offre technologique dédiée et collabore avec des entreprises aussi diverses que Claranor, leader mondial de la stérilisation d’emballage par lumière pulsée, l’Atelier du Fruit, une PME qui a lancé deux thèses de doctorat, ou encore Albert Vieille, société centenaire spécialisée dans la distillation et l’extraction des plantes à parfum et médicinales. 3BCAR collabore avec la start-up Oléoinnov, prix i-Lab 2021, pour valoriser le tourteau de colza. Enfin, Télécom & Société numérique a déposé de nombreux brevets sur la standardisation de la 5G et propose aux industriels une plate-forme de communication mobile open source pour le développement d’accès aux réseaux : cette collaboration en amont lui permet de se positionner sur les normes qui devraient être adoptées in fine.

Quels sont selon vous les grands défis qui attendent les entreprises ?
Le premier défi est celui de la souveraineté économique et les instituts Carnot sont une opportunité pour construire une stratégie d’innovation solide reposant sur des compétences scientifiques et techniques de niveau mondial. Les entreprises doivent innover pour réduire l’impact environnemental de leurs activités, s’adapter à des réglementations qui vont se durcir et continuer à attirer les talents. La chimie, les matériaux, l’environnement et la biodiversité devraient bénéficier d’investissements financiers et humains massifs dans les années à venir. D’autres enjeux majeurs concernent la santé, l’alimentation, la cybersécurité, l’éco-innovation… Dans tous ces domaines, le réseau des Carnot peut monter très rapidement une équipe projet, voire un laboratoire commun qui restera opérationnel le temps nécessaire à l’entreprise pour atteindre ses objectifs stratégiques. Une fois les premiers résultats engrangés, l’entreprise augmente souvent le périmètre et le volume du partenariat initial. La même souplesse d’accès prévaut pour les infrastructures de test et de validation développées par la recherche publique, qui sont notamment cruciales pour le nucléaire, l’aéronautique ou le spatial. N’oublions pas que beaucoup de nos grands organismes de recherche ont été créés par le pouvoir politique après la deuxième guerre mondiale pour reconstruire et soutenir notre industrie par l’innovation. Ces capacités sont toujours bien vivantes au sein du réseau des Carnot et désormais, tous les secteurs de l’économie ont accès à ces moyens, avec des dispositions fiscales incitatives pour les entreprises. Une raison de plus de bénéficier de ce formidable outil !
108 Avril 2023
© AiCarnot
© Ema Martins
Innovating for business
Qualiment supports start-ups with food innovation projects, attracts entrepreneurs on the basis of a dedicated technological offer and collaborates with companies as diverse as Claranor, the world leader in sterilisation of packaging by pulsed light, l’Atelier du Fruit, an SME that has launched two doctoral theses, and Albert Vieille, a century-old company specialising in the distillation and extraction of perfume and medicinal plants. 3BCAR is working with the start-up Oléoinnov, which won the i-Lab 2021 prize, to add value to rapeseed cake. Finally, Télécom & Société Numérique has filed numerous patents on the standardisation of 5G and offers manufacturers an open-source mobile communication platform for the development of network access: this upstream collaboration enables it to position itself on the standards that should eventually be adopted.
In your opinion, what are the main challenges that await companies?
Could you present the Carnot institutes network?
The Carnot label was created in 2006 on the model of the German Fraunhofer institutes to increase the societal and economic impact of French research. Today, the network includes 39 Carnot institutes selected every 4 years by the Ministry of Research according to their technical and scientific excellence, the volume of their R&D activities and their professionalism in their relations with companies. Each year, the 35,000 professionals in our network (20% of the French public research workforce) carry out 55% of the partnership research with companies (€600 million in 2021). The Carnot institutes reinvest in scientific resourcing, the reinforcement of the network effect and the pursuit of the professionalization of the relationship with companies. With 1,150 priority patents and more than 28,500 rank A publications in 2021, the Carnot network is a reliable and recognized ally to cross the famous «valley of death» of innovation so that a deeptech product or service can exist and find its market from an initial technology. In addition, nearly a hundred spin-offs emerge from our laboratories each year. Since the 2021
finance law, the Carnot network has benefited from an increased financial support trajectory and aims to achieve an annual volume of partnership research of one billion euros by 2030. The Rendez-vous Carnot, one of the most important European fairs dedicated to deeptech innovation, is there to allow new partnerships to bloom. In 2023, this event will take place on 18 and 19 October in Lyon.

Could you present the Carnot institutes active in the South region?
Thirteen Carnot institutes are located in the South of France: 3BCAR (bioeconomy and green chemistry), ARTS (future industry), CALYM (lymphoma), Clim’adapt, Cognition, Water & Environment, Inria, M.I.N.E.S., OPALE (leukemia and related diseases), Plant2Pro (crop production), Qualiment, STAR (sports), Télécom & Société numérique. CALYM signed a major multi-year contract with Bristol Myers Squibb to identify prognostic biomarkers and understand the origin of relapse in lymphoma (blood cancer). This original format partnership has generated promising results and has already led to other partnerships with this company.
The first challenge is that of economic sovereignty and the Carnot institutes are an opportunity to build a solid innovation strategy based on world-class scientific and technical skills. Companies must innovate in order to reduce the environmental impact of their activities, to adapt to regulations that will become stricter and to continue to attract talents. Chemistry, materials, the environment and biodiversity should benefit from massive financial and human investments in the years to come. Other major stakes concern health, food, cybersecurity, eco-innovation... In all these fields, the Carnot network can very quickly set up a project team, or even a common laboratory which will remain operational for the time necessary for the company to reach its strategic objectives. Once the first results are obtained, the company often increases the scope and the volume of the initial partnership. The same flexibility of access prevails for the test and validation infrastructures developed by public research, which are particularly crucial for the nuclear, aeronautical and space industries. Let us not forget that many of our major research organisations were created by the political authorities after the Second World War to rebuild and support our industry through innovation. These capacities are still very much alive within the Carnot network and now all sectors of the economy have access to these resources, with attractive tax provisions for companies. One more reason to benefit from this formidable tool!
109 April 2023
An interview with Mr. Jean-Denis MULLER, Director General of AiCarnot (lereseaudescarnot.fr)
© Stefan Meyer AiCarnot.
Région Sud PACA : la région industrielle du XXIème siècle
En juin 2022 la Région Sud a adopté une stratégie économique 100 % Plan Climat. Son ambition : conserver une industrie forte, innovante, engagée dans la transition environnementale et bâtir ainsi la région industrielle du XXIème siècle.
En adoptant son nouveau Schéma régional de développement économique, d’innovation et d’internationalisation (SRDEII) pour la période 2022-2028, le Conseil régional Sud PACA affiche sa volonté de répondre aux défis majeurs du territoire : défi démographique, création d’emplois, développement des entreprises, réduction de la pauvreté et des inégalités sociales et territoriales et lutte contre le changement climatique. Cinq axes stratégiques ont été définis dans cette optique : vers une croissance régionale 100 % Plan Climat, vers une région souveraine et résiliente face aux crises, faire de la région Sud l’une des régions les plus innovantes d’Europe, accélérer la croissance des entreprises (compétences, international, développement et transmission), une Région plus simple, plus proche et plus lisible au service d’une croissance équilibrée des territoires.
Vers une croissance régionale 100 % Plan Climat
Promouvoir une croissance économique plus respectueuse de l’environnement et atteindre la neutralité carbone en 2050 : c’est la double ambition de la Région Sud. Il faut dire que le territoire s’appuie sur un potentiel d’énergies renouvelables riches et variées : 1er gisement solaire, 2ème région
forestière et hydraulique de France, des ressources d’énergies marines encore inexploitées… Un écosystème porté par des partenariats forts entre centres de R&D, entreprises innovantes, grands groupes…

Quatre objectifs ont été fixés dans ce cadre. Premier objectif : produire une énergie décarbonée et changer de mix énergétique. Cela passe par une triple action, à savoir innover et produire localement et massivement des énergies renouvelables en tirant parti des ressources naturelles locales telles que le solaire photovoltaïque et l’éolien offshore flottant, en optimisant les systèmes énergétiques pour décarboner l’industrie, la mobilité et les bâtiments ; produire de l’hydrogène vert et massifier son utilisation dans l’industrie et la mobilité avec le soutien aux projets structurants pour faire de la région le hub hydrogène de l’Europe du sud ; conforter l’expertise nucléaire pour contribuer à la souveraineté énergétique en soutenant les écosystèmes territoriaux sur les SMR (petits réacteurs modulaires), les réacteurs de 4ème génération et la fusion nucléaire (ITER).
Deuxième objectif : décarboner l’industrie et les transports pour réduire l’empreinte énergétique et bâtir la région industrielle
du 21ème siècle en s’appuyant sur les filières innovantes. Cela implique deux actions concomitantes : accompagner la mutation de l’industrie - grands groupes, ETI, PME - vers la décarbonation (baisser les émissions de gaz à effet de serre via l’amélioration des procédés, la réduction de la consommation d’énergie, la substitution des énergies fossiles et par le financement des projets - Terra Néa, Fonds Transition Juste, France 2030, Green Deal - et leur accompagnement - démarche Zone Industrielle Bas Carbone…) ; réduire l’empreinte carbone liée à la mobilité des personnes et des marchandises et faire évoluer les pratiques en matière de déplacement (Programme Escales Zéro Fumée, report modal, Plan vélo, optimisation de la logistique du dernier kilomètre, promotion des circuits courts et des tiers lieux...).
Troisième objectif : soutenir de nouveaux modèles de développement économique plus vertueux en matière environnementale et l’économie circulaire. À cette fin, la Région entend réduire la production de déchets et les valoriser en tant que ressources, c’est-à-dire faire émerger des sites de réemploi, recyclage, tri et transformation, soutenir une filière de biodéchets ainsi que les filières de valorisation des
110 Avril 2023
Aéroport de Nice, 2e aéroport français / Nice airport, 2nd French airport © Abxbay
ressources naturelles (bois, éco matériaux) et mobiliser les filières pour s’adapter aux enjeux climatiques (BTP, transport, agriculture…). La Région veille aussi à mettre en œuvre des modèles économiques collaboratifs et résilients : écologie industrielle et territoriale, économie de la fonctionnalité, REGAL’im, soutien à la demande locale (agriculture urbaine, plateforme d’achat local...), Plateforme de l’économie circulaire (PRECI)…
Quatrième objectif : embarquer toutes les entreprises dans la réussite de leur transition écologique pour une croissance vertueuse et responsable. Trois actions sont prévues dans ce cadre : massifier les aides pour couvrir les besoins des entreprises (renforcement du dispositif CEDRE, parcours accélérateur emblématique de la transition écologique avec ses solutions d’accompagnement et de financement), renforcer l’éco-conditionnalité des aides régionales pour encourager les pratiques respectueuses de la transition écologique (aides ciblées, critères environnementaux, soutien aux bonnes pratiques RSE...) et permettre aux entreprises de disposer des compétences
requises par ces transitions (faire évoluer la commande publique de formation pour que 100 % de l’offre de formation intègre la “compétence climat”, mieux sensibiliser et orienter vers les métiers verts (www. orientation-regionsud.fr), créer un campus de l’environnement…).

Pour une région industrielle souveraine et plus résiliente face aux crises Faire de la région une capitale euroméditerranéenne : un défi à la portée de la Région Sud si l’on considère que le GPMM (grand port maritime de Marseille) est le 1er port de France et que le territoire abrite l’un des principaux hubs logistiques et industrialo-portuaires du sud de l’Europe, sans oublier ses deux aéroports internationaux. De plus, il s’appuie sur un réseau diversifié et multi-filières avec plus de 21 000 TPE et PME industrielles, de grands groupes internationaux, un écosystème performant, trois métropoles parmi les plus attractives d’Europe…
Trois objectifs ont été déterminés dans le cadre de ce deuxième axe. Premier objectif : renforcer la capacité des entreprises, des filières et des territoires à faire face aux crises pour assurer la souveraineté sur les besoins essentiels. La Région met ainsi l’accent sur une agriculture plus résiliente au changement climatique avec la stratégie agricole 2022-2027, des aides à la transition écologique des exploitations... et sur des filières stratégiques souveraines sur les besoins essentiels : santé et thérapies innovantes, énergie, défense, nouvelles technologies, alimentation.
Deuxième objectif : une chaine de valeur renforcée et diversifiée pour sécuriser les approvisionnements et la distribution. Ce qui induit un effort concentré sur des filières d’excellence, des segments stratégiques, des entreprises porteuses de briques technologiques ou d’un savoir-faire par -
ticulier pour renforcer le tissu régional (avec une task-force régionale accompagnant les projets à enjeux, un parcours d’implantation et d’installation premium), une Team France Invest Région Sud et des Ambassadeurs du sud pour renforcer l’attractivité du territoire, une stratégie pour la Méditerranée afin de favoriser les échanges avec les territoires limitrophes et de sécuriser les chaines d’approvisionnement et de distribution (Pack Sud Relocalisation) et un plan régional de la logistique pour rationaliser les flux, fluidifier les connexions intermodales, développer la mutualisation, les circuits courts et les coopérations entre producteurs et distributeurs.

Troisième objectif : la reconquête industrielle afin de bâtir l’industrie du 21ème siècle. Dans cette perspective, la Région envisage un soutien renforcé aux entreprises industrielles par la mobilisation de financements régionaux, nationaux et européens (Région Sud Investissement, Terra Nea - avec un objectif de 100 M€ pour financer les projets de transitions écologiques et énergétiques et pour investir dans les greentech -, Programme d’Investissement d’Avenir 4 régionalisé en lien avec France 2030), un accompagnement de la croissance et du changement d’échelle des industries pour plus de scale-up et d’ETI en vue de passer le cap de l’industrie du 4.0 (French Tech, pôles et clusters, Sud Place, plateforme d’accélération PRACCIS, Accélérateur Sud), une offre de formation ajustée aux besoins des entreprises (CPRDFOP pour adapter les dispositifs de formations aux réalités économiques d’aujourd’hui et demain, Campus des métiers et qualifications) ainsi qu’une stratégie foncière partenariale fondée sur 4 piliers : identifier, optimiser, renforcer et promouvoir pour concilier l’attractivité, le développement économique et la sobriété.
Faire de PACA l’une des régions les plus
111 April 2023
Un TGV près de Cavaillon / A TGV near Cavaillon © Jean-Marc Rosier
© Région Sud PACA
innovantes d’Europe Forte de 4 universités, des centres et infrastructures de recherche de pointe (ITER, 3IA, IDEX…), 8 pôles de compétitivité et clusters, des filières d’excellence et un réseau régional d’innovation structuré, la Région Sud est l’une des trois régions françaises labellisées « Région Européenne Entreprenante ». Quatre objectifs ont été fixés pour aller encore plus loin.
Le premier objectif vise à rapprocher les acteurs de la recherche et de l’innovation des entreprises pour renforcer la dynamique d’innovation et répondre aux défis sociétaux. Ce qui passe par deux actions concrètes : attirer et fidéliser les talents pour booster l’innovation du territoire, favoriser sa visibilité et son rayonnement (programmes de mobilité internationale, « Ingénierie compétences et talents » avec risingSUD, mobilisation sur des projets nationaux et européens, soutien aux établissements de formation, nouveaux cursus de formation adaptés aux besoins) ; conforter les infrastructures de recherche et de transfert d’excellence (soutien à des projets structurants, partenariats recherche-entreprise, nouveaux équipements, challenges de l’innovation ouverte, vouchers de prestation… et en assurer une meilleure lisibilité auprès des entreprises).
Le second objectif cible la création d’entreprises innovantes à travers trois champs d’intervention : favoriser un écosystème souple et innovant (pôles Pepite, Centre Européen d’Entreprises et d’Innovation, pépinières, incubateurs) ; renforcer l’articulation entre les acteurs pour accélérer l’incubation des projets, diffuser l’innovation, faciliter l’accès aux infrastructures, aider à la faisabilité et à
la preuve du concept ; favoriser l’innovation de service dans tous les secteurs (tourisme, agriculture, économie présentielle...) pour mieux se différencier.

Le troisième objectif vise à accompagner l’accélération des entreprises et l’industrialisation des innovations à travers deux axes : consolider et renforcer le potentiel de développement des entreprises, startups et PME, accroitre le nombre d’ETI et conquérir de nouveaux marchés avec des outils d’ingénierie de financement de l’innovation renforcés pour accompagner les phases d’amorçage, d’accélération, de croissance et d’industrialisation (FIER, France Relance 2030, mobilisation de grands fonds d’investissements privés, publics et sectoriels sur les thématiques prioritaires de la Région) ; faciliter les collaborations entre startups, PME innovantes et donneurs d’ordre avec la plateforme Sud Place, regrouper et coordonner les acteurs du financement au sein de Sud Place financière, officiellement lancée en octobre 2022, accompagner des projets de démonstrateurs, capter des fonds européens, protéger la propriété intellectuelle et les innovations avec l’INPI.
Enfin, le quatrième objectif vise à accélérer la transformation numérique des entreprises via 2 grandes actions : favoriser la transition numérique des territoires pour renforcer leur compétitivité et leur attractivité (déploiement du très haut débit d’ici 2025 et soutien à des projets portés par les intercommunalités dans le cadre du Parcours Sud Smart Territoires, intensification de l’accompagnement méthodologique et financier des entreprises dans leur démarche de transformation numérique avec un dispositif d’aide unique, le « Coach digital »,
et un accès à une offre de formation ajustée grâce à « E-Dih ») ; les protéger des cybermenaces avec une offre régionale de service structurée sur la cybersécurité, un centre d’urgence et d’alerte cyber (CSIRT), et la création d’un cyber campus régional. Pour booster l’innovation et contribuer au développement économique des acteurs du territoire, une solution a en outre été développée par la Région : une plateforme de mise en relation 100 % gratuite entre les porteurs de solutions innovantes - startups et PME - et ceux qui ont besoin de ces solutions, à savoir les grandes entreprises, les ETI, les PME ou encore les administrations publiques. https://sudplace.maregionsud.fr
Accélérer la croissance des entreprises Troisième région la plus riche de France en PIB régional par habitant, membre du top 3 de la création d’entreprises, PACA peut se prévaloir de 11 000 entreprises exportatrices et s’appuie sur des partenaires-clés comme risingSUD, les agences de développement, la Chambre régionale de l’économie sociale et solidaire, les chambres consulaires, Business France, BPIfrance, la Banque des Territoires et bien d’autres. Un écosystème fort, engagé aux côtés de l’État et des métropoles pour remplir les 3 objectifs fixés par la Région.
Premier objectif : gagner la bataille de l’emploi et favoriser la croissance durable en améliorant l’adéquation entre l’offre de formation et les besoins en compétences des entreprises grâce à 2 actions phares : renforcer les interactions entre le monde de l’entreprise et de la formation (informer sur les métiers et parcours, orienter avec “Cartosud”, ajuster les contenus de formation initiale/continue et favoriser les passerelles
112 Avril 2023
L’université Côte d’Azur / The Côte d’Azur University
© Louis-Kenzo Cahier
ou compétences de base (AFEST), Fonds d’Innovation pour la Formation ou FIF, Écoles de la deuxième chance, valoriser les métiers et faciliter le recrutement avec Fonds Sud Compétences…) ; prioriser les formations en lien avec les secteurs prioritaires (plan spécifique de professionnalisation des acteurs du tourisme, modules « compétence climat » dans la commande publique, FIF mobilisé sur la silver économie, le sanitaire et le social, les métiers de l’environnement…).
Deuxième objectif w: soutenir les entreprises dans chaque phase de leur vie pour renforcer le dynamisme du tissu régional au travers de trois outils, soit un parcours d’accompagnement et un dispositif de financement renforcés (MPE, FIER avec une offre permettant de répondre à tous les besoins des entreprises) ; la promotion de l’entrepreneuriat des femmes, des jeunes et des personnes en situation de handicap (dispositifs CEDRE et Coach Digital pour favoriser la croissance des TPE/PME et leur structuration face aux transitions digitale, environnementale et écologique, Région Sud Investissement – un fonds de co-investissement doté de 134 M€ qui fait partie du Fonds d’Investissement pour les Entreprises de la Région, créé par la Région Sud) ; enfin, 50 % de financements du volet économie consacrés aux enjeux du Plan Climat.

Troisième objectif : aider les entreprises à potentiel à grandir, changer d’échelle et à s’internationaliser. Cela implique d’identifier ces entreprises et de favoriser leur
croissance (Communauté des entreprises à haut potentiel, Accélérateur Sud…), d’appuyer une diplomatie économique structurée (partenariats stratégiques institutionnels et économiques) et d’agir via la Team France Export Région Sud et sa plateforme de solutions, le Parcours Sud Export - un accompagnement sur mesure de PME/TPE engagées dans un développement à l’international qui a permis, depuis sa création, d’accélérer près de 300 entreprises pour plus de 5 M€ -, une présence renforcée sur des salons internationaux, des feuilles de route dédiées sur des destinations stratégiques (Méditerranée, Afrique, Europe…), de grands évènements tels que « Méditerranée du futur »…

Soutenir les filières stratégiques
La Région a placé l’industrie au cœur de ses priorités. Le SDREII réaffirme une logique de concentration et de spécialisation au travers des 8 Opérations d’intérêt régional (OIR), pour soutenir les filières stratégiques avec l’appui des pôles de compétitivité et clusters. La Région ambitionne de faire du territoire un modèle européen de développement économique durable et résilient. Au travers de ses OIR, elle vise d’ici 2028, à mobiliser 2 millions d’euros publics-privés sur les filières stratégiques, à attirer 500 investissements directs étrangers générant 2 millions d’investissements exogènes, et à créer ou pérenniser 80 000 emplois. Autant de gages de rayonnement pour ce territoire en pleine effervescence1
8 Opérations d’intérêt régional
Les 8 Opérations d’intérêt régional (OIR) s’adressent aux entreprises et aux acteurs économiques des territoires de la Région Sud (collectivités, universités, pôles de compétitivité, clusters, agences de développement, chambres consulaires), qui portent un projet structurant ou participent à la structuration d’une filière. Chaque OIR dans son domaine soutient des projets et porte une ambition.



Naturalité : positionner Sud Provence-Alpes-Côte d’Azur comme leader en matière de naturalité et d’alimentation de qualité.
Thérapies innovantes : faire de Provence-Alpes-Côte d’Azur l’un des leaders mondiaux des thérapies de demain.
Industries du futur : développer par l’inter-filières les modèles industriels de demain.
Énergie de demain : développer l’économie verte au service de la transition énergétique de ProvenceAlpes-Côte d’Azur.

Économie de la mer : structurer la filière navale et maritime pour conquérir de nouveaux marchés.
Silver économie : créer des solutions pour le maintien en bonne santé et à domicile de la population senior.
Tourisme et industries créatives : maximiser les potentiels économiques au croisement de la culture, du tourisme et du numérique.
Smart tech : bâtir la 1ère Smart Région d’Europe.
Chaque Opération est co-pilotée par un élu et un industriel afin de regrouper à la fois les intérêts publics et privés et concentrer les financements sur les projets retenus. Lorsqu’ils sont sélectionnés, les projets bénéficient d’un appui à la structuration et sont accompagnés en ingénierie (juridique, financière…) par RisingSUD et des experts dédiés.
113 April 2023
© risingSUD
1 Source : Conseil régional Sud - Provence-Alpes-Côte d’Azur.
PACA South Region: the industrial region of the 21st century
In June 2022, the Southern Region adopted a 100% Climate Plan economic strategy. Its ambition: to maintain a strong, innovative industry, committed to environmental transition and thus build the industrial region of the 21st century.
By adopting its new Regional Plan for Economic Development, Innovation and Internationalisation (SRDEII) for the period 2022-2028, the South PACA Regional Council is demonstrating its desire to respond to the major challenges facing the region: the demographic challenge, job creation, business development, the reduction of poverty and social and territorial inequalities and the fight against climate change. Five strategic axes have been defined with this in mind: towards 100% Climate Plan regional growth, towards a sovereign and resilient region in the face of crises, making the South region one of the most innovative regions in Europe, accelerating business growth (skills, international, development and transmission), a simpler, closer and more legible Region at the service of balanced growth in the territories.
Towards 100% Climate Plan regional growth
Promoting economic growth that is more respectful of the environment and achieving carbon neutrality by 2050: this is the dual ambition of the Southern Region. It must be said that the region relies on a rich and varied renewable energy potential: the largest solar deposit, the second largest forestry and hydraulic region in France, as yet untapped marine energy resources, etc. An ecosystem supported by strong partnerships between R&D centres, innovative companies and major groups...

Four objectives have been set within this framework. The first objective is to produce low-carbon energy and change the energy mix. This involves a threefold action, namely innovating and producing renewable energy locally and on a massive
scale by taking advantage of local natural resources such as photovoltaic solar energy and floating offshore wind power, by optimising energy systems to decarbonise industry, mobility and buildings; produce green hydrogen and massively increase its use in industry and mobility by supporting structuring projects to make the region the hydrogen hub of southern Europe; consolidate nuclear expertise to contribute to energy sovereignty by supporting territorial ecosystems on SMRs (small modular reactors), 4th generation reactors and nuclear fusion (ITER).
The second objective is to decarbonise industry and transport in order to reduce the energy footprint and build the industrial region of the 21st century by relying on innovative sectors. This involves two concomitant actions: supporting the transformation of indus-
114 Avril 2023
Port de la Joliette in Marseille / Port de la Joliette à Marseille
© Rama
try - large groups, ETIs, SMEs - towards decarbonisation (reducing greenhouse gas emissions by improving processes, reducing energy consumption, substituting fossil fuels and by financing projects - Terra Nea, Just Transition Fund, France 2030, Green Deal - and supporting them - Low Carbon Industrial Zone approach... ); reducing the carbon footprint linked to the mobility of people and goods and changing travel practices (Zero Smoke Stopover Programme, modal shift, Cycling Plan, optimisation of last mile logistics, promotion of short circuits and third places…).
Third objective: to support new models of economic development that are more virtuous in environmental terms and the circular economy. To this end, the Region intends to reduce the production of waste and recover it as a resource, i.e. to develop sites for reuse, recycling, sorting and transformation, to support a bio-waste sector as well as sectors for the recovery of natural resources (wood, eco-materials) and to mobilise sectors to adapt to climate issues (construction, transport, agriculture, etc.). The Region is also working to implement collaborative and resilient economic models: industrial and territorial ecology, functionality economy, REGAL’im, support for local demand (urban agriculture, local purchasing platform, etc.), circular economy platform (PRECI), etc.
Fourth objective: to involve all companies in the success of their ecological transition for a virtuous and responsible growth. Three actions are planned within this framework: to massify aid to cover the needs of companies (reinforcement of the CEDRE system, an accelerator course emblematic of the ecological transition with its support and financing solutions), to reinforce the eco-conditionality of regional aid to
encourage practices respectful of the ecological transition (targeted aid, environmental criteria, support for good CSR practices…) and enable companies to have the skills required by these transitions (develop public training orders so that 100% of the training offer includes «climate competence», improve awareness and guidance towards green jobs (www. orientation-regionsud.fr), create an environment campus...).
For a sovereign industrial region that is more resilient to crises Making the region a Euro-Mediterranean capital: a challenge within the reach of the Southern Region if we consider that the GPMM (Marseille’s major seaport) is France’s leading port and that the region is home to one of the main logistics and industrial port hubs in southern Europe, not to mention its two international airports. In addition, it is supported by a diversified, multi-sector network with more than 21,000 small and medium-sized industrial companies, major international groups, a high-performance ecosystem, and three of the most attractive cities in Europe...
Three objectives have been determined within the framework of this second axis. First objective: to strengthen the capacity of companies, sectors and territories to deal with crises in order to ensure sovereignty over essential needs. The Region is thus focusing on agriculture that is more resilient to climate change with the 2022-2027 agricultural strategy, aid for the ecological transition of farms, etc., and on strategic sectors that are sovereign in terms of essential needs: health and innovative therapies, energy, defence, new technologies and food.
Second objective: a strengthened and diversified value chain to secure supplies

and distribution. This implies a concentrated effort on sectors of excellence, strategic segments, companies with technological bricks or specific know-how to strengthen the regional fabric (with a regional task force to support projects with high stakes, a “premium” pathway for setting up and installing companies), a Team France Invest Région Sud and Southern Ambassadors to strengthen the attractiveness of the region, a strategy for the Mediterranean to promote exchanges with neighbouring territories and secure supply and distribution chains (Pack Sud Relocalisation) and a regional logistics plan to rationalise flows, make intermodal connections more fluid, develop mutualisation, short circuits and cooperation between producers and distributors.
Third objective: industrial reconquest in order to build the industry of the 21st century. In this perspective, the Region envisages reinforced support for industrial companies through the mobilisation of regional, national and European funding (Région Sud Investissement, Terra Neawith a target of €100 million to finance ecological and energy transition projects and to invest in greentech -, a regionalised Programme d’Investissement d’Avenir 4 in connection with France 2030), support for growth and the scaling up of industries for more scale-ups and ETIs with a view to taking the step towards 4.0 industry (French Tech, clusters, Sud Place, PRACCIS acceleration platform, Accélérateur Sud), a training offer adapted to the needs of companies (CPRDFOP to adapt training systems to the economic realities of today and tomorrow, Campus des métiers et qualifications) as well as a partnership land strategy based on 4 pillars: identify, optimise, reinforce and promote to reconcile attractiveness, economic development and sobriety.
115 April 2023
The four industrial revolutions / Les quatre révolutions industrielles
© Christoph Roser AllAboutLean.com
Making PACA one of the most innovative regions in Europe
With 4 universities, cutting-edge research centres and infrastructures (ITER, 3IA, IDEX...), 8 competitiveness clusters, sectors of excellence and a structured regional innovation network, the Southern Region is one of the three French regions labelled «European Entrepreneurial Region». Four objectives have been set to go even further.

The first objective aims to bring together the players in research and innovation and businesses to strengthen the innovation dynamic and respond to societal challenges. This involves two concrete actions: attracting and retaining talent to boost the region’s innovation, promoting its visibility and influence (international mobility programmes, «Skills and Talent Engineering» with risingSUD, mobilisation on national and European projects, support for training establishments, new training courses adapted to needs); consolidating research and transfer infrastructures of excellence (support for structuring projects, research-company partnerships, new equipment, open innovation challenges, service vouchers, etc., and ensuring better readability for companies).
The second objective targets the creation of innovative companies through three areas of intervention: promoting a flexible and innovative ecosystem (Pepite clusters, European Business and Innovation Centre, incubators); reinforcing the articulation between actors to accelerate the incubation of projects, disseminate innovation, facilitate access to infrastructures, help with feasibility and proof of concept; promoting service innovation in all sectors (tourism, agriculture, on site economy, etc.) to better differentiate.
The third objective is to support the acceleration of companies and the industrialisation of innovations through two axes: consolidating and strengthening the development potential of companies, startups and SMEs, increasing the number of TPEs and conquering new markets with strengthened innovation financing engineering tools to support the seed, acceleration, growth and industrialisation phases (FIER, France Relance 2030, mobilisation of major private, public and sectoral investment funds on the Region’s priority themes); facilitate collaboration between start-ups, innovative SMEs and
principals with the Sud Place platform, bring together and coordinate financing players within Sud Place financière, which was officially launched in October 2022, support demonstrator projects, attract European funds, and protect intellectual property and innovations with the INPI (National Institute of Intellectual Property).
Finally, the fourth objective aims to accelerate the digital transformation of businesses via 2 major actions: Promote the digital transition of the territories to strengthen their competitiveness and attractiveness (deployment of very highspeed broadband by 2025 and support for projects led by the intercommunalities within the framework of the Parcours Sud Smart Territoires, intensification of the methodological and financial support for companies in their digital transformation process with a unique aid system, the «Digital Coach», and access to an adjusted training offer thanks to «E-Dih»); protect them from cyber threats with a structured regional service offer on cyber security, a cyber emergency and warning centre (CSIRT), and the creation of a regional cyber campus.
To boost innovation and contribute to the economic development of the region’s players, a solution has also been developed by the Region: a platform for putting providers of innovative solutions - startups and SMEs - in contact with those who need these solutions, namely large companies, ETIs, SMEs and public administrations. https://sudplace.maregionsud.fr
Accelerating business growth
The third richest region in France in terms of regional GDP per capita, a member of the top 3 in terms of business creation, PACA boasts 11,000 exporting companies and relies on key partners such as risingSUD, development agencies, the Regional Chamber of the Social and Solidarity Economy, consular chambers, Business France, BPIfrance, the Banque des Territoires and many others. A strong ecosystem, committed alongside the State and the metropolises to meet the 3 objectives set by the Region.
First objective: to win the battle for employment and promote sustainable growth by improving the match between the supply of training and the skills needs of companies through 2 key actions, namely strengthening interactions between the business and training worlds (providing information on jobs and career paths, providing guidance with «Cartosud», adjusting the content of initial/continuing training and promoting bridges or basic skills (AFEST), Fonds d’Innovation pour la Formation or FIF, Second Chance Schools, promoting jobs and facilitating recruitment with Fonds Sud Compétences... ); and prioritising training linked to priority sectors (specific plan for professionalisation of those involved in tourism, «climate competence» modules in public orders, FIF mobilised for the silver economy, health and social services, environmental professions, etc.).
Second objective: to support businesses at every stage of their lives in order to strengthen the dynamism of the regional
116 Avril 2023
The University of Avignon / L’Université d’Avignon © Marind
fabric through three tools, i.e. a support path and a reinforced financing system (MPE, FIER with an offer that makes it possible to meet all the needs of businesses); the promotion of entrepreneurship among women, young people and people with disabilities (CEDRE and Coach Digital schemes to encourage the growth of VSEs/ SMEs and their structuring in the face of digital, environmental and ecological transitions, Région Sud Investissement - a co-investment fund endowed with €134 million which is part of the Fonds d’Investissement pour les Entreprises de la Région, created by the Sud Region); and finally, 50% of the financing of the economy section devoted to the challenges of the Climate Plan.
Third objective: to help companies with high potential to grow, change scale and go international. This involves identifying these companies and encouraging their growth (Community of high-potential companies, South Accelerator, etc.), supporting structured economic diplomacy (strategic institutional and economic partnerships) and taking action via Team France Export


Région Sud and its solutions platform, the Parcours Sud Export - tailor-made support for SMEs/SMBs engaged in international development which, since its creation, has helped to accelerate nearly 300 companies for more than €5m -, a stronger presence at international trade fairs, dedicated roadmaps for strategic destinations (Mediterranean, Africa, Europe, etc.), major events such as «Mediterranean of the Future», etc.

Supporting strategic sectors
The Region has placed industry at the heart of its priorities. The SDREII reaffirms a logic of concentration and specialisation through the 8 Operations of Regional Interest (OIR), to support strategic sectors with the support of competitiveness clusters. The Region’s ambition is to make the territory a European model of sustainable and resilient economic development. Through its OIRs, it aims to mobilise 2 million euros of public-private investment in strategic sectors by 2028, to attract 500 foreign direct investments generating 2 million foreign investments, and to create or maintain 80,000 jobs. These are all guarantees of influence for this booming region2
8 Operations of Regional Interest
The 8 Operations of Regional Interest (OIR) are aimed at companies and economic players in the Southern Region (local authorities, universities, competitiveness clusters, development agencies, consular chambers), who are carrying out a structuring project or participating in the structuring of a sector. Each OIR in its field supports projects and has an ambition.
Naturalness: to position Sud Provence-Alpes-Côte d’Azur as a leader in naturalness and quality food. Innovative therapies: make ProvenceAlpes-Côte d’Azur one of the world leaders in the therapies of tomorrow. Industries of the future: develop tomorrow’s industrial models through inter-sectoral cooperation. Energy of tomorrow: develop the green economy to serve the energy transition of Provence-Alpes-Côte d’Azur.
Sea economy: structure the naval and maritime sector to conquer new markets.
Silver economy: create solutions for keeping the senior population healthy and at home.

Tourism and creative industries: maximise the economic potential of culture, tourism and digital technology. Smart tech: building the 1st Smart Region in Europe.
Each Operation is co-piloted by an elected official and an industrialist in order to bring together both public and private interests and concentrate funding on the selected projects. Once selected, projects receive structuring support and engineering assistance (legal, financial, etc.) from RisingSUD and dedicated experts.


117 April 2023
2 Source : Regional Council South PACA.
ITER exhibits at the International Fusion Energy Days, Monaco / Stand d’ITER aux International Fusion Energy Days à Monaco © Conleth Brady / IAEA
Créer des liens plus forts et durables entre le monde académique et l’industrie
Un entretien avec M. Jean-Luc PARRAIN, Délégué régional académique à la recherche et à l’innovation - région Provence-Alpes-Côte d’Azur, Et Mme Fabienne BLAISE, Rectrice déléguée pour l’enseignement supérieur, la recherche et l’innovation de la région académique Provence-Alpes-Côte d’Azur
Pourriez-vous nous rappeler les missions et les modalités de collaboration de la DRARI et du rectorat délégué de la région académique PACA ?
Fabienne Blaise (F.B.). La DRARI est intégrée au rectorat de la région académique PACA et Jean-Luc Parrain, DRARI en exercice, apporte son expertise sur les dossiers spécifiques liés à la recherche et l’innovation. Les DRARI sont placés sous l’autorité hiérarchique du recteur délégué pour l’enseignement supérieur, la recherche et l’innovation (ESRI) et l’autorité fonctionnelle du préfet de région. La région Sud est très riche en matière d’ESRI puisqu’elle est la seule en dehors de l’Îlede-France à compter deux IdEx (initiative d’excellence) portées par Aix-Marseille Université, l’Université Côte d’Azur et l’ensemble des organismes nationaux de recherche implantés localement.
Jean-Luc Parrain (J.-L.P.). La rectrice ESRI et le DRARI travaillent à multiplier les possibilités de collaboration entre établissements d’enseignement supérieur et entreprises. Le ministère de l’enseignement supérieur et de la recherche finance des dispositifs labellisés tels que les platesformes technologiques et les centres de diffusion technique. Dans notre région les filières chimie-matériaux, industrie 4.0 et agro-alimentaire sont particulièrement accompagnées. Nous avons aussi stimulé le dispositif « Rapprochement université-entreprise » porté par une association active sur quatre départements de la région. Cette association va à la rencontre des entreprises pour les aider dans leur définition de leur R&D (mise en relation avec un laboratoire académique régional, aide au montage de dossiers…). Plus globalement, la chaine de l’innovation publique est accélérée par la SATT Sud-Est et trois incubateurs publics qui accompagnent les laboratoires académiques (propriété industrielle et création de start-ups innovantes).

F.B. Il convient de préciser que les relations entre la région académique et le conseil
régional sont particulièrement fluides. Par exemple, le volet « vie étudiante » du SRESRI et le schéma directeur « vie étudiante » de la région académique ont été élaborés conjointement.
Pourriez-vous nous donner quelques exemples d’actions de valorisation de la recherche publique vers les entreprises ? J.-L.P. Nos trois incubateurs publics régionaux accompagnent entre 40 et 45 projets de start-ups innovantes chaque année. On peut citer deux start-ups issues des travaux du Centre de Recherche en Cancérologie de Marseille (INSERM - IPC - AMU - CNRS) qui développent des candidats médicaments pour des pathologies en impasse thérapeutique et qui ont fait des levées de fonds très importantes cette année. En nous basant sur la force de notre secteur académique, nous espérons aussi créer deux « Pôles Universitaires d’Innovation » (PUI) régionaux pour significativement augmenter la valorisation des résultats de la recherche publique, répondant en cela à l’objectif national de créer 500 start-ups deeptech par an à l’horizon 2030.
F.B. Nous nous impliquons aussi dans l’appel à projets de France 2030 « Compétences et métiers d’avenir » et souhai-
tons travailler sur une cartographie des formations du secondaire et du supérieur. L’objectif est d’établir un état des lieux tout en travaillant avec la Région et les autres services de l’État sur les besoins de formation des entreprises. Il s’agit de concilier l’intérêt des étudiants et les besoins du territoire. Un observatoire des parcours est également à l’étude afin de suivre des cohortes de lycéens, leur devenir dans l’enseignement supérieur et leur insertion professionnelle. Ces données sont précieuses pour améliorer l’insertion des étudiants.
J.-L.P. L’intelligence collective est, à ce stade, indispensable pour anticiper l’évolution de la carte des formations et dresser un bilan de l’enseignement secondaire : ce qui existe, ce qui fonctionne et vers où doit-on orienter nos forces…
Comment encourager davantage la recherche et l’innovation en interaction avec le monde socio-économique ?
J.-L.P. La formation est un élément-clé : nous manquons de docteurs et d’ingénieurs en PACA. Nous devons en former plus mais aussi accroître le taux de poursuite en doctorat des étudiants ingénieurs – qui est beaucoup trop faible dans notre pays. Cela favoriserait des liens plus forts et durables entre le monde académique et l’industrie tout en offrant à cette dernière des cadres de très haut niveau scientifique.
F.B. La loi de programmation de la recherche 2021-2030 donne la possibilité aux doctorants de faire leur thèse en entreprise. En accédant aux réponses des entreprises aux appels à projets de France 2030, nous pourrions en outre les orienter vers des acteurs de la recherche pour accroître leurs chances de succès. De plus, nous devons communiquer sur le rôle des universités et des organismes de recherche dans le développement du territoire. Il est temps de redonner confiance dans l’enseignement supérieur et la recherche !
118 Avril 2023
©
DRARI PACA
Creating stronger and more sustainable links between the academic world and industry

Could you remind us of the missions and collaboration methods of the DRARI and the delegated rectorate of the PACA academic region?
Fabienne Blaise (F.B.). The DRARI is integrated into the PACA academic region’s rectorate and Jean-Luc Parrain, the current DRARI, provides his expertise on specific issues related to research and innovation. The DRARIs are placed under the hierarchical authority of the rector delegate for higher education, research and innovation (ESRI) and the functional authority of the regional prefect. The South region is very rich in terms of ESRI, since it is the only region outside of Ile-de-France to have two IdEx (initiatives of excellence), led by Aix-Marseille University, the Côte d’Azur University and all the national research organisations based locally.

Jean-Luc Parrain (J.-L.P.). The ESRI rector and the DRARI are working to increase the possibilities of collaboration between higher education institutions and companies. The Ministry of Higher Education and Research finances labelled schemes such as technology platforms and technical dissemination centres. In our region, the chemical-materials, industry 4.0 and agri-food sectors are particularly supported. We have also stimulated the «University-Company Rapprochement» scheme, which is run by an association active in four departments of the region. This association meets with companies to help them define their R&D (by putting them in touch with a regional academic laboratory, helping them put together files, etc.). More globally, the public innovation chain is accelerated by the SATT Sud-Est and three public incubators that support academic laboratories (industrial property and creation of innovative start-ups).
F.B. It should be pointed out that relations between the academic region and the regional council are particularly fluid. For example, the ‘student life’ section of the
SRESRI and the ‘student life’ master plan of the academic region were drawn up jointly.
Could you give us some examples of actions to promote public research towards companies?
J.-L.P. Our three regional public incubators support between 40 and 45 innovative start-up projects each year. We can mention two start-ups resulting from the work of the Marseille Cancer Research Centre (INSERM - IPC - AMU - CNRS) that are developing drug candidates for pathologies that have reached a therapeutic dead end and that have raised very substantial funds this year. Based on the strength of our academic sector, we also hope to create two regional «University Innovation Poles» (PUI) to significantly increase the value of public research results, thus meeting the national objective of creating 500 deeptech start-ups per year by 2030.
F.B. We are also involved in the France 2030 call for projects «Skills and professions of the future» and would like to work on a mapping of secondary and higher education training. The objective is to establish an inventory while working with the Region and other State services on the training needs of companies. The aim is to reconcile the interests of students and
the needs of the region. A pathway observatory is also being studied in order to monitor cohorts of high school students, their progress in higher education and their professional integration. This data is invaluable for improving the integration of students.
J.-L.P. Collective intelligence is, at this stage, essential to anticipate the evolution of the training map and to draw up an assessment of secondary education: what exists, what works and where we should direct our forces...
How can we encourage more research and innovation in interaction with the socio-economic world?
J.-L.P. Training is a key element: we lack doctors and engineers in PACA. We need to train more of them, but also increase the rate of doctoral studies for engineering students - which is far too low in our country. This would favour stronger and more durable links between the academic world and industry while offering the latter very high-level scientific executives.
F.B. The 2021-2030 research programming law gives doctoral students the opportunity to do their thesis in a company. By accessing companies’ responses to the France 2030 calls for projects, we could also direct them towards research players to increase their chances of success. In addition, we must communicate on the role of universities and research organisations in the development of the territory. It is time to restore confidence in higher education and research!
119 April 2023
An interview with Mr. Jean-Luc PARRAIN, Regional Academic Delegate for Research and Innovation - Provence-Alpes-Côte d’Azur region, And Mrs Fabienne BLAISE, Rector Delegate for Higher Education, Research and Innovation of the Provence-Alpes-Côte d’Azur Academic Region
©
Académie d’Aix-Marseille © Académie d’Aix-Marseille
Valoriser l’attractivité économique d’une région qui fait rêver la terre entière

Un entretien avec M. Bernard KLEYNHOFF, Conseiller régional Président de la Commission Développement Économique et Digital, Industrie, Export, Attractivité et Cybersécurité de la Région Sud Président de risingSUD, agence d’attractivité et de développement économique de la région Sud

Quelles sont les filières d’excellence de l’écosystème économique régional ?
Nous avons identifié 8 filières d’excellence à accélérer en priorité grâce aux Opérations d’Intérêt Régional (OIR) coprésidées par un élu régional et un chef d’entreprise du secteur concerné. Ce sont de véritables outils d’animation de proximité et d’aménagement du territoire sur l’industrie du futur, la naturalité, l’économie de la mer, les thérapies innovantes, la silver économie, les smart tech, les énergies de demain, le tourisme et les industries créatives. Ces filières sont les plus génératrices d’innovations et donc d’emplois et d’attractivité pour le territoire.
Pourriez-vous nous présenter les missions de risingSUD ?
risingSUD est l’agence d’attractivité et de développement économique de la région Sud. Nous avons 3 missions principales :
1- Nous accompagnons les entreprises implantées en région dans leurs projets de croissance, de recrutement, d’exportation, de transition écologique, de recherche de fonds ou de foncier ; 2- Nous soutenons les territoires régionaux dans leur développement ; 3- Nous attirons des entreprises et investisseurs internationaux dans la région. Pour cela, nous construisons les feuilles de route des OIR et les animons avec la Région. Dans le cadre de l’OIR Industries du futur, nous avons accompagné, depuis 2019, 500 entreprises industrielles pour mettre en œuvre leur digitalisation grâce à un parcours incluant un état des lieux, un programme d’actions et une aide à l’investissement assumée par la Région. Nous pilotons aussi SUD Accélérateur, qui a servi de
modèle à l’accélérateur de Bpifrance. Nous identifions des entreprises à fort potentiel de croissance et les accompagnons dans la structuration et l’accélération de leur développement. Les entreprises en levée de fonds ont également accès à notre comité de financeurs (COFI) et risingSUD opère un plateau d’accélération de projets structurants pour notre territoire qui sont présentés à ce même COFI. Plus d’1 milliard d’euros a déjà été débloqué et notre prochain objectif est d’atteindre les 2 milliards d’euros. Enfin, nous œuvrons sur le volet international, à la fois pour l’attractivité du territoire et de nouvelles implantations d’entreprises en partenariat avec le Comité d’Orientation et de Suivi des Projets Etrangers de Business France, et pour l’accompagnement de nos entreprises régionales à l’export sur des destinations prioritaires. En 2022, la région Sud a d’ailleurs réalisé une année record d’investissements étrangers puisque 124 entreprises issues de 30 pays sont venues s’implanter et ont permis de créer 4 147 emplois sur le territoire régional.
Pourriez-vous nous donner quelques exemples d’entreprises innovantes accompagnées par risingSUD ? Je commencerai avec Nawatechnologies : dirigée par Pascal Boulanger, cette entreprise développe, avec le CEA, une nouvelle génération d’électrodes pour batteries qui permet une recharge plus rapide et plus durable. L’entreprise a pu faire une démonstration de son innovation sur une moto électrique lors de l’édition 2022 de Vivatech. Autre entreprise prometteuse : HySiLabs. Dirigée par Pierre-Emmanuel Casanova, elle commercialise une solution, développée à Aix-Marseille Université, facilitant le transport de
l’hydrogène. Elle prendra tout son essor avec la mise en place de grands réseaux de distribution d’hydrogène vert au service de la mobilité de demain. Nous soutenons également une entreprise, OvinAlp, qui produit des engrais à partir des déjections de moutons en moyenne montagne. Notre objectif est de permettre à cette PME de réussir sa transition vers le statut d’ETI – des entreprises dont la France manque.
Quels sont selon vous les principaux défis à relever pour accroître l’attractivité économique régionale auprès des investisseurs potentiels ?
Nous sommes très fortement impliqués dans la promotion de l’attractivité territoriale avec un enjeu majeur : celui de la gestion foncière. Un appel à candidatures a été lancé au niveau national pour recenser les terrains « clés en main » pour les entreprises industrielles désireuses de s’implanter dans la région. Dix sites ont été retenus mais c’est insuffisant. Nous travaillons avec les métropoles et intercommunalités pour aménager des réserves foncières supplémentaires. Au-delà du foncier, nous travaillons au développement de l’écosystème régional et de ses maillons manquants : sous-traitants, sociétés de services aux entreprises, emploi, formation des employés et solutions éducatives pour les enfants des cadres expatriés. C’est tout l’enjeu du projet de la Nouvelle cité internationale à Marseille. In fine, c’est une réponse globale que nous devons fournir aux entreprises. Cela implique une collaboration étroite entre les équipes de risingSUD, des métropoles, des intercommunalités, des agences de développement économique, des CCI, et des services de l’État. Cette mobilisation nous a permis récemment de concrétiser deux nouvelles implantations d’entreprises industrielles alors que les offres concurrentes pouvaient sembler plus intéressantes de prime abord. Nous avons su faire valoir la qualité de vie, l’attractivité de l’écosystème en termes de logistique et d’emploi, et bien entendu la qualité du territoire lui-même : la région Provence-Alpes-Côte d’Azur fait rêver la terre entière ! Nous ambitionnons d’ailleurs de faire de la région Sud la région du bonheur d’ici 2028. Or, le bonheur inclut aussi le développement économique.
120 Avril 2023
Mission découverte de l’écosystème hydrogène en région Sud organisée les 9 et 10 mai 2022 par risingSUD, EEN France Méditerranée et le pôle de compétitivité Capenergies – Jupiter 1000 / Mission to discover the hydrogen ecosystem in the South of France organised on 9 and 10 May 2022 by risingSUD, EEN France Méditerranée and the Capenergies competitiveness cluster - Jupiter 1000
© risingSUD
© Sunmade pour GRTgaz
Enhancing the economic attractiveness of a region that is a dream for the whole world
interview with Mr.
What are the sectors of excellence in the regional economic ecosystem?
We have identified 8 sectors of excellence to be accelerated as a priority thanks to the Regional Interest Operations (RIO) co-chaired by a regional elected official and a company director from the sector concerned. These are real tools for local animation and regional development in the industry of the future, naturalness, the economy of the sea, innovative therapies, the silver economy, smart tech, the energies of tomorrow, tourism and creative industries. These sectors are the ones that generate the most innovation and therefore jobs and attractiveness for the region.
Could you present the missions of risingSUD?
risingSUD is the attractiveness and economic development agency of the South region. We have 3 main missions: 1- We support companies established in the region in their growth, recruitment, export, ecological transition, fundraising and land search projects; 2- We

support regional territories in their development; 3- We attract international companies and investors to the region. To do this, we draw up the roadmaps for the RIOs and coordinate them with the Region. Within the framework of the RIO Industries of the Future, we have accompanied, since 2019, 500 industrial companies to implement their digitalisation thanks to a pathway including an inventory, an action programme and investment aid assumed by the Region. We are also piloting the SUD Accelerator, which served as a model for the Bpifrance accelerator. We identify companies with strong growth potential and support them in structuring and accelerating their development. Companies raising funds also have access to our committee of funders (COFI) and risingSUD operates an acceleration platform for structuring projects for our territory that are presented to this same COFI. More than €1 billion has already been released and our next objective is to reach €2 billion. Finally, we are working on the international aspect, both for the attractiveness of the territory and for new business establishments in partnership with the Business France Committee for the Orientation and Follow-up of Foreign Projects, and for the accompaniment of our regional companies in exporting to priority destinations. In 2022, the Southern Region achieved a record year for foreign investment, with 124 companies from 30 countries setting up operations and creating 4,147 jobs in the region.
Could you give us some examples of innovative companies supported by risingSUD?
I’ll start with Nawatechnologies: headed by Pascal Boulanger, this company is developing, with the CEA, a new generation of electrodes for batteries that allow for faster and more

durable recharging. The company was able to demonstrate its innovation on an electric motorbike at the 2022 Vivatech show. Another promising company is HySiLabs. Headed by Pierre-Emmanuel Casanova, it markets a solution developed at Aix-Marseille University that facilitates the transport of hydrogen. It will take off with the implementation of large green hydrogen distribution networks for tomorrow’s mobility. We are also supporting a company, OvinAlp, which produces fertilisers from sheep droppings at medium altitude. Our objective is to enable this SME to make a successful transition to the status of ETI - medium-sized companies with between 250 and 4,999 employees that France lacks.
In your opinion, what are the main challenges to be met in order to increase the economic attractiveness of the region for potential investors?
We are very strongly involved in the promotion of territorial attractiveness with a major challenge: that of land management. A call for applications was launched at the national level to identify «turnkey» sites for industrial companies wishing to set up in the region. Ten sites have been selected, but this is not enough. We are working with the metropolises and inter-municipalities to develop additional land reserves. Beyond the land, we are working on the development of the regional ecosystem and its missing links: subcontractors, business services companies, employment, employee training and educational solutions for the children of expatriate executives. This is what the New International City project in Marseille is all about. Ultimately, it is a global response that we must provide to companies. This implies close collaboration between the teams of risingSUD, the metropolises, the intercommunities, the economic development agencies, the CCIs, and the State services. This mobilisation has recently enabled us to secure two new locations for industrial companies when competing offers might have seemed more interesting at first glance. We were able to promote the quality of life, the attractiveness of the ecosystem in terms of logistics and employment, and of course the quality of the territory itself: the ProvenceAlpes-Côte d’Azur region is the dream of the whole world! Our ambition is to make the South region the region of happiness by 2028. But happiness also includes economic development.
121 April 2023
An
Bernard KLEYNHOFF, Regional Councillor, President of the Economic and Digital Development, Industry, Export, Attractiveness and Cybersecurity Commission of the Southern Region, President of risingSUD, the attractiveness and economic development agency of the Southern Region
Inauguration of the new SFF Satinox factory in La Garde on 28 April 2022
Inauguration le 28 avril 2022 de la nouvelle usine de l’entreprise SFF Satinox à La Garde
© CCI Var © risingSUD
Launch of SUD Accelerator Class 5 (2021-2023) / Lancement de la promotion 5 de SUD Accélérateur (2021-2023)
Des actions partenariales pour favoriser la détection et l’émulation de projets innovants
Un entretien avec M. Philippe RENAUDI, Président de la CCI Provence-Alpes-Côte

en tension (industrie, commerce, hôtellerie-restaurant, numérique, construction) : le réseau CCI Provence-Alpes-Côte d’Azur a opéré 5 000 sensibilisations de TPE/PME et près de 1 000 d’entre elles ont accepté d’être référencées sur la plateforme « immersion facile » de Pôle emploi. De plus, l’offre de formation, initiale et continue, sur la vingtaine de campus CCI dans les territoires s’adapte en fonction des besoins exprimés par les entreprises comme sur les métiers CHR (cafés - hôtellerie - restauration), santé, numérique, industrie décarbonée… Notre réseau développe aussi des actions facilitant l’employabilité via le mentorat et l’inclusion.
Quels sont les points forts du tissu économique régional ?
Deuxième région la plus touristique de France, Provence-Alpes-Côte d’Azur bénéficie d’une industrie diversifiée essentiellement composée de TPE et PME mais aussi de grands donneurs d’ordre internationaux. Pour l’année 2022, le chiffre d’affaires des entreprises régionales a atteint 331 Mds €, en évolution de + 18 %, ce qui illustre un réel dynamisme économique.
Quels sont les dispositifs d’aide de votre réseau CCI aux entreprises innovantes ?
Notre réseau CCI déploie divers dispositifs et s’associe à des actions partenariales qui favorisent la détection et l’émulation de projets, à l’instar du dispositif RUE qui rapproche le monde de la recherche avec celui de l’entreprise. Au niveau international, CCI International Provence-Alpes-Côte d’Azur (Team France Export Sud) a lancé une première Learning Expedition sur le CES Las Vegas 2023 : 10 entreprises innovantes dans les secteurs santé, mobilité, green tech et smart city sont parties s’immerger sur le salon en janvier, s’inspirer et réseauter dans des conditions optimales avec une préparation sur mesure en amont. Dans le secteur du tourisme, notre réseau CCI s’est associé pour la 3e année à TravelCamp Sud de la Région : un appel à projets lancé au second semestre 2022 aux startups qui ont un projet différenciant. Et c’est un quart de la promotion 2023 qui a été détecté par notre CCI dans les territoires : 4 lauréats sur les
16 dévoilés en mars dont les innovations partent maintenant chez les incubateurs partenaires. Et n’oublions pas les fonds européens ! Sur la précédente programmation (2014-2020) notre réseau CCI a capté 14 M€ de financements pour 92 projets dont de l’aide à l’innovation pour les acteurs du tourisme, des startups en phase de scale-up, la filière agroalimentaire, les territoires et ports connectés. L’innovation est à nouveau au cœur de la programmation européenne 2021-2027 avec EULEP (Erasmus +) qui vise à développer des formations innovantes en matière de réalité augmentée, d’intelligence artificielle et d’innovation sociale. Eurochambres est chef de file et notre réseau CCI parmi les 20 partenaires.
Quelle est l’offre des CCI Provence-AlpesCôte d’Azur en matière de formation pour relever le défi de la pénurie de maind’œuvre ?
Sur les quelque 2 700 entrepreneurs interrogés chaque trimestre pour notre baromètre de conjoncture, les PME de plus de 50 salariés prévoient une activité et des effectifs stables, voire à la hausse . Notre force pour relever le défi du recrutement réside dans notre ancrage territorial et notre capacité à fédérer. Outre les formations en alternance sur nos campus, notre réseau CCI établit des partenariats avec les organismes qui s’occupent de l’emploi, de la formation et des compétences. Un exemple récent est la campagne nationale d’immersion professionnelle en entreprise dans les secteurs
Comment la CCI Provence-Alpes-Côte d’Azur contribue-t-elle à la politique régionale de réindustrialisation du territoire ?
Faire grandir l’industrie est l’un des 46 objectifs de notre contribution au SRDEII de la Région Sud : un objectif bâti sur 10 propositions telles que « Accélérer la constitution de sites industriels clés en main », avec a minima 2 nouveaux sites par an. À ce jour, il y a une centaine de sites labellisés en France dont une dizaine en Provence-Alpes-Côte d’Azur : de la disponibilité foncière que les PMI ne connaissent hélas pas toujours. Nous avons la chance d’avoir un membre du Bureau de la CCI de région, mon premier vice-président Daniel Margot, président de la CCI des Alpes-de-Haute-Provence, qui copilote la mission réindustrialisation de CCI France. Cette mission doit livrer sous peu une boîte à outils. Des livrables concrets incitant et aidant les PMI à s’implanter ou se réimplanter sur nos territoires car si l’entreprise n’a pas son terrain sous 6 mois, elle ira voir ailleurs ! Nous allons renforcer l’information sur le foncier économique disponible, nouer des conventions avec des partenaires influents en matière d’accompagnement, développer le mentorat, adapter plus encore la formation initiale et continue…
1 https://www.calameo.com/cci-provence-alpes-cote-dazur/ subscriptions/5125265
2 165 propositions répondant à 46 objectifs sur 10 thématiques jugées prioritaires.
https://fr.calameo.com/cci-provence-alpes-cote-dazur/ read/004852100394d5f5e4af0
122 Avril 2023
d’Azur
© CCI Provence-Alpes-Côte d’Azur
Partnership actions to encourage the detection and emulation of innovative projects
What are the strong points of the regional economic fabric?
As the second most touristic region in France, Provence-Alpes-Côte d’Azur benefits from a diversified industry essentially composed of small and medium-sized companies, but also of large international contractors. For the year 2022, the turnover of regional companies reached €331 billion, an increase of 18%, which illustrates a real economic dynamism.

What support mechanisms does your CCI network offer to innovative companies?
Our CCI network deploys various schemes and is involved in partnership actions that encourage the detection and emulation of projects, such as the RUE scheme, which brings the world of research closer to that of business. At the international level, CCI International Provence-Alpes-Côte d’Azur (Team France Export Sud) has launched a first Learning Expedition to CES Las Vegas 2023: 10 innovative companies in the health, mobility, green tech and smart city sectors will be immersed in the trade show in January, to gain inspiration and network in optimal conditions, with tailor-made preparation upstream. In the tourism and events sector, our CCI network has joined for the 3rd year the TravelCamp Sud of
the Region: a call for projects launched in the second half of 2022 to startups with a differentiating project. And it is a quarter of the class of 2023 that has been detected by our CCI in the territories: 4 winners out of the 16 unveiled in March whose innovations are now going to partner incubators. And let’s not forget the European funds! During the previous programming period (2014-2020), our CCI network received €14 million in funding for 92 projects, including aid for innovation for tourism players, start-ups in the scale-up phase, the agri-food sector, and connected territories and ports. Innovation is again at the heart of the 2021-2027 European programme with EULEP (Erasmus +) which aims to develop innovative training in augmented reality, artificial intelligence and social innovation. Eurochambres is the lead partner and our CCI network is one of the 20 partners.
What does the Provence-Alpes-Côte d’Azur CCI offer in terms of training to meet the challenge of the labour shortage?
Of the 2,700 entrepreneurs surveyed each quarter for our business barometer, SMEs with more than 50 employees expect business and employment to be stable or even increase. Our strength in meeting this challenge lies in our territorial anchorage and
our ability to federate. In addition to the work-study programmes on our campuses, our CCI network establishes partnerships with organisations that deal with employment, training and skills. A recent example is the national campaign of professional immersion in companies in sectors in tension (industry, commerce, hotels and restaurants, digital, construction). The Provence-AlpesCôte d’Azur CCI network has carried out 5,000 awareness-raising campaigns among VSEs/SMEs, and nearly 1,000 of them have agreed to be listed on the Pôle Emploi «easy immersion» platform. In addition, our own training offer, both initial and continuing, is adapted to the needs expressed by the companies, such as in the CHR (cafés - hotels - restaurants), health, digital, decarbonised industry, etc. Our network is also developing actions to facilitate employability via mentoring and inclusion.
How does the Provence-Alpes-Côte d’Azur CCI contribute to the regional policy of reindustrialisation of the territory?
Growing industry is one of the 46 objectives of our contribution to the SRDEII (Regional Economic Development, Innovation and Internationalisation Plan) of the Southern Region: an objective built on 10 proposals such as «Accelerate the creation of turnkey industrial sites», with at least 2 new sites per year. To date, there are about a hundred labelled sites in France, including about ten in Provence-Alpes-Côte d’Azur: land availability that SMIs are unfortunately not always aware of. We are fortunate to have a member of the Bureau of the regional CCI, my first vice-president Daniel Margot, president of the CCI of Alpes-de-Haute-Provence, who co-pilots the CCI France reindustrialisation mission. This mission should soon deliver a toolbox. Concrete deliverables encouraging and helping SMIs to set up or relocate to our territories, because if the company doesn’t have its land within 6 months, it will go elsewhere! We are going to strengthen information on available economic land, establish agreements with influential partners in terms of support, develop mentoring, and further adapt initial and ongoing training...
123 April 2023
An interview with Mr. Philippe RENAUDI, President of the Provence-Alpes-Côte d’Azur CCI
© CCI
Philippe Renaudi and Renaud Muselier, President of the Southern Region, guest speaker at the General Assembly on 24 February 2022 / Philippe Renaudi et Renaud Muselier, président de la Région Sud, invité en tribune de l’Assemblée générale le 24 février 2022
Provence-Alpes-Côte d’Azur
La société civile, un acteur-clé du territoire
Vous fêtez cette année le 50ème anniversaire du CESER Région Sud. Quel bilan dressez-vous de votre activité ?
Ce cinquantième anniversaire est l’occasion de faire prendre conscience de l’importance du CESER au monde politique et aux médias. Le CESER représente en effet la société civile organisée, dans le territoire, avec l’ensemble des corps intermédiaires et une parité hommefemme exemplaire. Il s’agit d’une Assemblée représentative, d’avant-garde où les acteurs du monde Patronal, Syndicats de salariés, Economie Sociale et Solidaire, Mouvements Associatif et environnementaux travaillent de concert pour rendre des avis communs. J’ai envie de dire aux politiques : « Arrêtez d’inventer l’eau chaude, utilisez-là ! ». Il serait souhaitable que l’État dote les CESER de ressources propres afin d’être plus autonomes vis-à-vis du Conseil Régional. De même, la Région devrait avoir l’obligation de répondre aux avis émis par le CESER, véritablement représentatif grâce aux élections professionnelles qui régissent le recrutement de ses membres par le Préfet de Région.
Quelle contribution avez-vous apporté à l’élaboration du SRESRI 2023-2028 ?
De par la loi, le Conseil régional est tenu de saisir le CESER quinze jours seulement avant la réunion plénière de décembre prochain qui votera le SRESRI. Heureusement nous avons d’excellentes relations avec la Région, ce qui nous a valu d’être associés dès le début à l’élaboration du SRESRI 2017-2021 : nous avions alors abordé les dysfonctionnements, les attentes et les points d’amélioration à apporter.

Cette fois aussi nous participons à la réflexion pour 2023/2028 très en amont et avons dégagé plusieurs recommandations. La première concerne le rapprochement vital des divers outils de formation vers les besoins du monde du travail : les entreprises ont des difficultés à recruter des ingénieurs venant du territoire, les étudiants hors zone métropolitaine ont du mal à se rapprocher des zones universitaires en raison du coût des transports et du logement et la trop grande centralisation sur le site d’Aix-Marseille risque de rendre les autres universités (Avignon, Toulon…) moins attractives aux yeux des étudiants ingénieurs. De plus, il importe d’améliorer l’insertion professionnelle des jeunes diplômés, et pas seulement celle des jeunes non qualifiés. Le développement de l’apprentissage

dans l’enseignement supérieur devrait être davantage encouragé. Enfin, nous invitons le Conseil régional à soutenir les formations en lien avec l’intelligence artificielle et les filières qu’il considère comme stratégiques.
Quels avis avez-vous récemment votés et quels avis prévoyez-vous de voter d’ici la fin 2022 ?
Nous avons travaillé sur le SRADDET (schéma régional d’aménagement, de développement durable et d’égalité des territoires) et émis de sérieuses réserves vis-à-vis de la politique « zéro artificialisation des sols agricoles ». C’est un problème car l’arrière-pays notamment a des besoins élevés de foncier pour se développer. Comment, dès lors, accueillir les travailleurs saisonniers ? Comment faciliter l’implantation de nouvelles activités ou le retour d’activités traditionnelles ?
Deux autres points d’attention pour le CESER : - 1) la vision prospective pour la région à l’horizon 2050. Tout comme le chef d’entreprise qui fait rêver ses employés avec un plan à 20 ans, fût-il trop ambitieux, nous avons besoin de créer une ambition partagée. Dans cette optique, la volonté du Conseil régional d’avoir une COP d’avance est porteuse de sens car elle rassemble les citoyens et les politiques. – 2) restaurer la confiance : il faut mettre en place une vraie dynamique de l’évaluation des dépenses publiques ! Quel objectif avec quel moyen pour quel résultat… Un vaste chantier… Il faut convaincre les élus… Nous y travaillons !
Quels sont selon vous les grands défis à relever pour accroître encore l’attractivité de la Région Sud en matière d’économie et d’éducation ?
Avoir une vraie ambition et faire entendre la voix de la société civile : tel est mon credo ! L’attractivité du territoire passe notamment par un CESER vivant, une structure d’intermédiation et d’interface dynamique entre les citoyens et les politiques. L’État n’ose pas donner davantage de responsabilité aux territoires or c’est là que les habitants vivent et développent un regard commun sur les grands enjeux d’aménagement. Nous partageons un gène commun : le gène territorial. Il est temps de redonner du sens au territoire à l’échelle régionale qui est la bonne maille, où peuvent être prises des décisions de proximité. Du sur-mesure avec les besoins en somme !
124 Avril 2023
©
Sud © CESER Région Sud
Un entretien avec M. Marc POUZET, Président du CESER Région Sud Séance plénière / Plenary session
CESER Région
Civil society, a key player in the territory
This year you are celebrating the 50th anniversary of CESER Région Sud. What is your assessment of your activity?

This fiftieth anniversary is an opportunity to make the political world and the media aware of the importance of CESER. CESER represents organised civil society in the region, with all the intermediary bodies and an exemplary gender balance. It is a representative, avant-garde Assembly where the actors of the business world, the employees’ unions, the Social and Solidarity Economy, and the associative and environmental movements work together to issue common opinions. I would like to say to politicians: «Stop inventing hot water, use it!” It would be desirable for the State to provide the CESERs with their own resources in order to be more autonomous vis-à-vis the Regional Council. Similarly, the Region should be obliged to respond to the opinions issued by the CESER, which is truly representative thanks to the professional elections that govern the recruitment of its members by the Prefect of the Region.
What contribution did you make to the development of the SRESRI 2023-2028?
By law, the Regional Council is obliged to refer to CESER only two weeks before the plenary meeting in December that will vote on the SRESRI. Fortunately, we have excellent relations with the Region, which meant that we were involved from the outset in drawing up the SRESRI 20172021: we then discussed the dysfunctions, expectations and points for improvement.
This time too we are participating in the reflection for 2023/2028 at a very early stage and have drawn up several recommendations. The first concerns the vital need to bring the various training tools closer to the needs of the world of work: companies have difficulty recruiting engineers from the region, students from outside the metropolitan area have difficulty moving closer to university areas because of the cost of transport and accommodation, and the excessive centralisation on the Aix-Marseille site risks making the other universities (Avignon, Toulon, etc.) less attractive to engineering students. Moreover, it is important to improve the professional integration of young graduates, and not only that of unqualified young people. The development of
apprenticeships in higher education should be further encouraged. Finally, we invite the Regional Council to support training related to artificial intelligence and the sectors it considers strategic.

What opinions have you voted on recently and what opinions do you plan to vote on by the end of 2022?
We worked on the SRADDET (regional plan for land use planning, sustainable development and equality) and expressed serious reservations about the policy of «zero artificialisation of agricultural land». This is a problem because the hinterland in particular has a high need for land to develop. How, therefore, can seasonal workers be accommodated? How to facilitate the establishment of new activities or the return of traditional activities?
Two other points of attention for the CESER: - 1) the prospective vision for the region by
2050. Just as a company director makes his employees dream with a 20-year plan, even if it is too ambitious, we need to create a shared ambition. From this perspective, the Regional Council’s desire to be one COP ahead is meaningful because it brings citizens and politicians together. - 2) Restore confidence: we need to put in place a real dynamic for the evaluation of public spending! What objective with what means for what result... A vast undertaking... We must convince the elected representatives... We are working on it!
In your opinion, what are the major challenges to be met in order to further increase the attractiveness of the Southern Region in terms of economy and education?
Having a real ambition and making the voice of civil society heard: that’s my credo! The attractiveness of the territory depends in particular on a living CESER, a structure of intermediation and dynamic interface between citizens and politicians. The State does not dare to give more responsibility to the territories, yet it is there that the inhabitants live and develop a common view of the major development issues. We share a common gene: the territorial gene. It is time to give meaning back to the territory at the regional level, which is the right level, where decisions can be taken locally. Tailor-made to the needs, in short!
125 April 2023
An interview with Mr. Marc POUZET, President of CESER Région Sud
Marc Pouzet and Renaud Muselier inaugurated the plaque commemorating CESER’s fiftieth anniversary in the presence of CESER Vice-Presidents / Marc Pouzet et Renaud Muselier ont inauguré la plaque commémorative du cinquantième anniversaire du CESER en présence des Vice-présidents du CESER
Signature of an agreement with the President of the Southern Region Renaud Muselier / Signature d’une convention avec le président de la Région Sud Renaud Muselier
© CESER Région Sud
© CESER Région Sud


126 Avril 2023 © Aix-Marseille Université © ENIT
127 April 2023 A Pôle Aqua-Valley 48 Aqua-Valley Cluster 49 C Institut Carnot Chimie Balard Cirimat 65 CHU de Nîmes 84-85 Nîmes University Hospital 85-86 CRCM - Centre de Recherche en Cancérologie de Marseille 82 CRCM - Marseille Cancer Research Centre 83 D Docaposte 34-37 E ENIT - École nationale d’ingénieurs de Tarbes 53, 62, 94 ENIT - National Engineering School of Tarbes 63 F Pierre Fabre
12-13 H Horus Pharma 87 Index des annonceurs • Advertisers’ index
Cover 2,
128 Avril 2023 I IRCAN - Institute of Research on Cancer and Aging in Nice 88-89 M Mipih 38 Mipih 39 N NXP Semiconductors Cover 4, 30-31 P École d’ingénieurs de PURPAN 54 PURPAN School of Engineering 55 S Labex SIGNALIFE 90-91 T Therapixel 92 Toulouse INP 50-52 Index des annonceurs • Advertisers’ index
arlementaires de rance



L’information des élus et des acteurs économiques




Eau et Environnement, Recherche, Transports, Sécurité alimentaire, Sécurité intérieure, Architecture et Urbanisme, Intercommunalité…





Parlementaires de France Magazine aborde des thèmes de dimensions locale, régionale, nationale, européenne et internationale.



Water and Environment, Research, Transport, Food Security, Homeland Security, Architecture and Urban planning, Groupings of towns...
Parlementaires de France Magazine adresses themes of local, regional, national, European and internation dimensions.

arlementaires de rance SEPTEMBRE / SEPTEMBER 2021 Unsplash Fusion Medical Animation Recherche et innovation en santé à l’ère post-Covid-19 L’information des élus et des acteurs économiques arlementaires de rance MAGAZINE MAI / MAY 2020 Therapixel AdobeStock Recherche et Innovation en France : IA et santé au service de la compétitivité Research and Innovation in France: AI and health at the service of competitiveness Institut interdisciplinaire d’intelligence artificielle hybride de Toulouse Toulouse interdisciplinary institute in hybrid artificial intelligence https://aniti.univ-toulouse.fr Recherche, formation, innovation et développement économique Research, education, innovation, and economic development 24 CHAIRES 24 RESEARCH CHAIRS 200 CHERCHEURS 200 RESEARCHERS +50 PARTENAIRES INDUSTRIELS ET ACADÉMIQUES 50+ INDUSTRIAL AND ECONOMIC PARTNERS 30 FORMATIONS EN IA 30 TRAINING TRACKS IN AI ANITI, Artificial and Natural Intelligence Toulouse Institute, est l’institut interdisciplinaire d’intelligence artificielle de Toulouse. Sa spécificité est de développer une nouvelle génération d’intelligence artificielle dite hybride, associant de façon intégrée des techniques d’apprentissage automatique à partir de données et des modèles permettant d’exprimer des contraintes et d’effectuer des raisonnements logiques. ANITI est porté par l’Université fédérale Toulouse Midi-Pyrénées, dans le cadre du programme d’investissements d’avenir PIA3 (Plan Villani). The Artificial and Natural Intelligence Toulouse Institute (ANITI) has been selected to be one of four institutes spearheading research on AI in France. The ambition of the institute is to develop a new generation of artificial intelligence called hybrid AI, combining data-driven machine learning techniques with symbolic and formal methods for expressing properties and constraints and carrying out logical reasoning ANITI is coordinated by the University of Toulouse «Université fédérale Toulouse Midi-Pyrénées» within the framework of France «lnvesting for the Future PIA3» program. 2 secteurs stratégiques d’application : transports et mobilité industry 4.0 2 Strategic application sectors targeted: Mobility and transportation Industry 4.0 L’information des élus et des acteurs économiques arlementaires de rance MAGAZINE MARS / MARCH 2019 © CHU de Toulouse © Institut Carnot unsplash CNES/ill./SATTLER Oliver, 2017
MAGAZINE